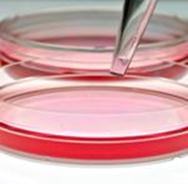

UNITED
STATES
SECURITIES AND EXCHANGE COMMISSION
WASHINGTON, D.C. 20549
FORM 10-K
(Mark One)
☒
ANNUAL REPORT PURSUANT TO SECTION 13 OR 15(d) OF THE SECURITIES EXCHANGE ACT OF 1934
For the
fiscal year ended April 30, 2019
or
☐
TRANSITION REPORT PURSUANT TO SECTION 13 OR 15(d) OF THE SECURITIES EXCHANGE ACT OF 1934
For the
transition period from __________ to __________
Commission
file number 333-68008
PHARMACYTE
BIOTECH, INC.
(Exact name
of registrant as specified in its charter)
| Nevada |
62-1772151 |
| (State
or other jurisdiction of incorporation or organization) |
(I.R.S.
Employer Identification No.) |
23046
Avenida de la Carlota, Suite 600, Laguna Hills, CA 92653
(Address
of principal executive offices)
(917)
595-2850
(Registrant’s telephone number, including area code)
Securities
registered pursuant to Section 12(b) of the Act: None
| Title of each class |
Name of each exchange on which
registered |
| N/A |
N/A |
| Securities
registered pursuant to Section 12(g) of the Act: |
None |
Indicate
by check mark if the registrant is a well-known seasoned issuer, as defined in Rule 405 of the Securities Act. Yes ☐ No ☒
Indicate
by check mark if the registrant is not required to file reports pursuant to Section 13 or Section 15(d) of the Act. Yes ☐
No ☒
Indicate
by check mark whether the registrant (1) has filed all reports required to be filed by Section 13 or 15(d) of the Securities Exchange
Act of 1934 during the preceding 12 months (or for such shorter period that the registrant was required to file such reports),
and (2) has been subject to such filing requirements for the past 90 days. Yes ☒ No ☐
Indicate
by check mark whether the registrant has submitted electronically every Interactive Data File required to be submitted pursuant
to Rule 405 of Regulation S-T (§ 232.405) during the precedent 12 months (or for such shorter period that the registrant
was required to submit such files). Yes ☒ No ☐
Indicate
by check mark if disclosure of delinquent filers pursuant to Item 405 of Regulation S-K (§ 229.405) is not contained herein,
and will not be contained, to the best of registrant’s knowledge, in definitive proxy or information statements incorporated
by reference in Part III of this Form 10-K or any amendment to this Form 10-K. ☒
Indicate
by check mark whether the registrant is a large accelerated filer, an accelerated filer, a non-accelerated filer, a smaller reporting
company or an emerging growth company. See the definitions of “large accelerated filer,” “accelerated filer,”
“smaller reporting company and emerging growth company” in Rule 12b-2 of the Exchange Act.
| Large
accelerated filer |
|
☐ |
|
Accelerated
filer |
|
☐ |
| Non-accelerated
filer |
|
☐ |
|
Smaller reporting
company |
|
☒ |
| Emerging growth
company |
|
☐ |
|
|
|
|
If an
emerging growth company, indicate by check mark if the registrant has elected not to use the extended transition period for complying
with any new or revised financial accounting standards provided pursuant to Section 13(a) of the Exchange Act. ☐
Indicate
by check mark whether the registrant is a shell company (as defined in Rule 12b-2 of the Exchange Act). Yes ☐ No ☒
State
the aggregate market value of the voting and non-voting common equity held by non-affiliates computed by reference to the price
at which the common equity was last sold, or the average bid and asked price of such common equity, as of October 31, 2018: $58,830,398.
As of August 12, 2019, the registrant
had 1,328,171,172 outstanding shares of common stock.
DOCUMENTS INCORPORATED BY REFERENCE
None.
Cautionary Note Regarding Forward-Looking
Statements
This Report on Form 10-K (“Report”)
includes “forward-looking statements” within the meaning of the federal securities laws. All statements other than
statements of historical fact are “forward-looking statements” for purposes of this Report, including any projections
of earnings, revenue or other financial items, any statements regarding the plans and objectives of management for future operations,
any statements concerning proposed new products or services, any statements regarding future economic conditions or performance,
any statements regarding expected benefits from any transactions and any statements of assumptions underlying any of the foregoing.
In some cases, forward-looking statements can be identified by use of terminology such as “may,” “will,”
“should,” “believes,” “intends,” “expects,” “plans,” “anticipates,”
“estimates,” “goal,” “aim,” “potential” or “continue,” or the negative
thereof or other comparable terminology. Although we believe that the expectations reflected in the forward-looking statements
contained in this Report are reasonable, there can be no assurance that such expectations or any of the forward-looking statements
will prove to be correct, and actual results could differ materially from those projected or assumed in the forward-looking statements.
Thus, investors should refer to and carefully review information in future documents we file with the United States Securities
and Exchange Commission (“Commission”). Our future financial condition and results of operations, as well as any forward-looking
statements, are subject to inherent risk and uncertainties, including, but not limited to, the risk factors set forth in “Part
I, Item 1A – Risk Factors” set forth in this Report and for the reasons described elsewhere in this Report, among others,
our estimates regarding expenses, future revenues, capital requirements and needs for additional financing; whether the United
States Food and Drug Administration (“FDA”) approves our Investigational New Drug Application (“IND”) after
it has been submitted to, and reviewed by the FDA so that we can commence our planned clinical trial involving locally advanced,
inoperable, non-metastatic pancreatic cancer; the success and timing of our preclinical studies and clinical trials; the potential
that results of preclinical studies and clinical trials may indicate that any of our technologies and product candidates are unsafe
or ineffective; our dependence on third parties in the conduct of our preclinical studies and clinical trials; the difficulties
and expenses associated with obtaining and maintaining regulatory approval of our product candidates; and whether the FDA will
approve our product candidates. All forward- looking statements and reasons why results may differ included in this Report are
made as of the date hereof, and we do not intend to update any forward-looking statements except as required by law or applicable
regulations. Except where the context otherwise requires, in this Report, the “Company,” “we,” “us”
and “our” refer to PharmaCyte Biotech, Inc., a Nevada corporation, and, where appropriate, its subsidiaries.
PART I
ITEM 1. BUSINESS.
Overview
We are a clinical stage biotechnology company
focused on developing and preparing to commercialize cellular therapies for cancer and diabetes based upon a proprietary cellulose-based
live cell encapsulation technology known as “Cell-in-a-Box®.” The Cell-in-a-Box® technology
is intended to be used as a platform upon which therapies for several types of cancer, including locally advanced, inoperable non-metastatic
pancreatic cancer (“LAPC”) and Type 1 and insulin dependent Type 2 diabetes will be developed.
We are developing therapies for pancreatic
and other solid cancerous tumors by using genetically engineered live human cells that are capable of converting a cancer prodrug
into its cancer-killing form, encapsulating those cells using the Cell-in-a-Box® technology and placing those capsules
in the body as close as possible to the tumor. In this way, when the cancer prodrug is administered to a patient with a particular
type of cancer that may be affected by the prodrug, the killing of the patient’s tumor may be optimized.
We are also examining ways to exploit the
benefits of the Cell-in-a-Box® technology to develop therapies for cancer that involve prodrugs based upon certain
constituents of the Cannabis plant; these constituents are of the class of compounds known as “cannabinoids”.
In addition, we are involved in preclinical
studies to determine if our cancer therapy can slow the production and/or accumulation of malignant ascites fluid in the abdomen
that accompanies the growth of several types of abdominal cancers.
Finally, we are developing a therapy for
Type 1 diabetes and insulin-dependent Type 2 diabetes based upon the encapsulation of a human liver cell line that has been genetically
engineered to produce, store and secrete insulin at levels in proportion to the levels of blood sugar in the human body. We are
also considering an alternative route to bringing a biological treatment for diabetes into human clinical trials. We are exploring
the possibility of encapsulating human insulin-producing stem cells and islet cells and then transplanting them into a diabetic
patient.
The encapsulation for each type of cell
will be done using the Cell-in-a-Box® technology. Each approach is designed to function as a bio-artificial pancreas
for the purpose of insulin production.
The Cell-in-a-Box® encapsulation
technology potentially enables genetically engineered live human cells to be used as miniature factories. The technology results
in the formation of pin-head sized cellulose-based porous capsules in which genetically modified live human cells can be encapsulated
and maintained. In the laboratory setting, which involves the large-scale amplification and production of useful biotech products
outside the body of a person or animal, the proprietary live cell encapsulation technology has been shown to create a micro-environment
in which these encapsulated cells survive and flourish. They are protected from environmental challenges, such as the sheer forces
associated with bioreactors, passage through catheters and needles, etc., enabling greater growth and production of the end-product.
The capsules are largely composed of cellulose (cotton) and are bio-inert.
Cancer Therapy
Targeted Chemotherapy
Our live-cell encapsulation technology-based
therapies consist of encapsulating different types of genetically modified living cells depending on the disease being treated.
For our leading product candidate, a therapy for pancreatic cancer, approximately 20,000 genetically modified live cells that produce
an enzyme (an isoform of cytochrome P450) which we believe will convert the chemotherapy prodrug ifosfamide into its cancer-killing
form are encapsulated in porous, spherical, pinhead-sized capsules, composed largely of cellulose. Then approximately 300 of these
capsules will be placed in the patients’ blood supply and guided into place using interventional radiography so that they
finally reside as close to the tumor in the pancreas as possible. Low doses (one gram per square meter of body surface area of
the patient) of the chemotherapy prodrug ifosfamide will then be given to the patient intravenously.
The prodrug ifosfamide is normally activated
in the patient’s liver. By activating the prodrug near the tumor using the Cell-in-a-Box® capsules, our cellular
therapy acts as a type of “bio-artificial liver.” Using this “targeted chemotherapy,” we are seeking to
create an environment that enables optimal concentrations of the “cancer-killing” form of ifosfamide at the site of
the tumor. Because the cancer-killing form of ifosfamide has a short biological half-life, we believe that this approach results
in little to no collateral damage to other organs in the body. We also believe this treatment will significantly reduce tumor size
with no treatment-related side effects.
Figure 1: Proposed treatment for pancreatic
cancer by targeted deployment and activation of chemotherapy using Cell-in-a-Box® encapsulated cells.
|
Note: Charts A and B are generalized
graphic depictions of the principal mechanisms of our proposed treatment for pancreatic cancer using our product candidate, the
combination of Cell-in-a-Box® encapsulated cells plus low-doses of ifosfamide, under expected conditions. This combination
therapy will be the subject of a Phase 2b clinical trial we plan to conduct, subject to FDA approval. No regulatory authority has
granted marketing approval for the Cell-in-a-Box® technology, the related encapsulated cells, or Cell-in-a-Box®
and encapsulated cells plus low-dose ifosfamide combination. |
|
 |
|
Chart (A)
Cell-in-a-Box® capsules containing live ifosfamide-activating
cells (shown in white) are implanted in the blood vessels leading to the tumor in the pancreas. Then low-dose ifosfamide is given
intravenously.
|
|
Chart (B)
Chart B shows the human pancreas and generalized
depictions of two pancreatic cancer tumors (shown in pink) as examples. In this chart, ifosfamide is converted to its cancer-killing
form by the encapsulated live cells implanted near the tumors (shown in maroon).
Legend
Blue Arrows: Ifosfamide enters capsules
Red Arrows: Conversion to active
form
White Arrows: Activated ifosfamide
targets tumors |
Figure 2: Mechanism of action of treatment
for pancreatic cancer by targeted deployment of the encapsulated live cells and activation of the chemotherapy prodrug drug ifosfamide.

Pancreatic Cancer Therapy
A critical unmet medical need exists for
patients with LAPC whose pancreas tumor no longer responds after 4-6 months of treatment with either Abraxane® plus
gemcitabine or the 4-drug combination known as FOLFIRINOX (both combinations are the current standards of care for pancreatic cancer).
We believe that these patients have no effective treatment alternative once their tumors no longer respond to these therapies.
Two of the most commonly used treatments for these patients are 5-fluorouiracil (“5-FU”) or capecitabine (a prodrug
of 5-FU) plus radiation (chemoradiation therapy). We believe that both treatments are only marginally effective in treating the
tumor and both result in serious side effects. More recently, radiation treatment alone is being used at some cancer centers in
the United States (“U.S.”).
We believe that all of these treatments
are only marginally effective in treating the tumor and all can result in serious side effects. Other treatments are being tried
in an attempt to address this problem, but their success is far from certain. Therefore, we are developing a therapy comprised
of Cell-in-a-Box® encapsulated live cells implanted near the pancreas tumor followed by the infusion of low doses
of the cancer prodrug ifosfamide. We believe that our therapy can serve as a “consolidation therapy” that can be used
with the current standards of care for LAPC and thus address this critical unmet medical need.
Subject to the FDA approval, we plan to
commence a clinical trial involving patients with LAPC whose tumors have ceased to respond to either Abraxane® plus
gemcitabine or FOLFIRINOX after 4-6 months. We had a Pre-Investigational New Drug Application meeting (“Pre-IND meeting”)
with the Center for Biologics Evaluation and Research of the FDA (“CBER”) in January 2017. At that Pre-IND meeting,
the FDA communicated its agreement with certain aspects of our clinical development plan, charged us with completing numerous tasks
and provided us with the guidance on the tasks we believe we need to complete for a successful IND, although no assurance could
be given whether the FDA will approve our IND once it is submitted. The trial would initially take place in the U.S. with possible
study sites in Europe at a later date.
Preparation of the Investigational New
Drug Application
Before we can begin our clinical trial,
we must submit an IND to the FDA. The IND consists of a submission of all available preclinical information (e.g. animal toxicity
studies), Chemistry, Manufacturing and Controls (“CMC”) information and other pre-clinical information about our product
candidate to treat LAPC, as well as clinical information and other information and documentation required by the FDA. Facet Life
Sciences (“Facet”) has been retained by us as our FDA regulatory affairs consultant and is leading the preparation
of the IND.
During fiscal year 2019, we have focused
our research and development (“R&D”) efforts at completing Cell-in-a-Box® encapsulation engineering
runs and production runs successfully using cells from our Master Cell Bank (“MCB”) that contain the genetically transformed
human cells that can activate the prodrug ifosfamide into its cancer killing form. The MCB encapsulated cells from the final manufacturing
run will be used for our planned clinical trial in LAPC. Several tests and experiments have been completed this past year
to optimize the growth properties of the cells in the capsules. The data from these tests and experiments will be included in our
IND.
In addition to the MCB work, we have completed
a series of tests and studies on cells from the MCB and the capsules into which they will be placed. These tests and studies are
required by the FDA. The data from these tests and studies will be included in our IND. The tests and studies consist of the following:
Completed Tests:
Polymerase
Chain Reaction (“PCR”) Assay as Identity Test for Clinical Product: A PCR -based identity test
as quality control of the 22P1G encapsulated cell product was developed by Austrianova. This assay was transferred from Austrianova
to a certified service provider in Thailand who provided the assay to Austrianova Thailand.
Characterization Studies of the 22P1G
Cell Line: These 22P1G studies consisted of pre-existing data and other data generated in experimental plans developed by Austrianova.
These studies focused on: (i) the characterization of the 22P1G original cell line, including the subcloning, testing of PrestoBlue
(cell viability) and resorufin (enzymatic) activities of the different clones and subclones, testing of PrestoBlue and resorufin
activities of the different clones and subclones, southern blots and growth analysis of the subclones; (ii) adaption to serum free
medium and testing of the best growth conditions prior to and after encapsulation; and (iii) genetic and phenotypic stability of
the 22P1G cell line. The purpose of these studies is to document the key characteristics of the parental 22P1G cell line and the
clones and subclones in order to demonstrate the stability of the 22P1G cell line before, during and after the encapsulation process.
The data will be used in the IND submission to the FDA.
Cell Culture Medium Comparison Study:
Due to availability concerns with the cell culture medium in which the 22P1G cells were developed, Austrianova undertook a cell
culture medium comparison study. The study was undertaken in order to source and check a backup cell culture medium. The study
concurrently tested a new serum free medium and the existing SFM4HEK293 (the medium in which the cell line was developed) in parallel
under the same conditions to establish equivalency for supporting cell growth of the 22P1G cells in capsules.
Certificate of Analysis: The Certificate
of Analysis (“COA”) for the preparation of the MCB from Eurofins Lancaster Laboratories, Inc. (“Eurofins”)
has been accepted by Austrianova Singapore Pte Ltd (“Austrianova”), who will perform the Cell-in-a-Box®
encapsulation in the manufacturing facility located Bangkok, Thailand and owned by Austrianova Thailand Pte Ltd (“Austrianova
Thailand”). The COA was issued following a series of tests required before the cells could be accepted by Austrianova Thailand
into its manufacturing facility.
Pig Study Report: This study report
on the safety of instillation of the capsules in pigs has been completed and approved by Facet. The report is a summary of information
and data from preclinical work completed by Dr. Matthias Löhr (“Dr. Löhr”) in preparation for the first clinical
trial using our therapy for pancreatic cancer.
Site of Integration Study: This
FDA required study characterized the site of integration and the structure of the integrated CMV CYP2B1 plasmid (hence CYP therapeutic
transgene) into the genome of the 22P1G cell line being used for our planned clinical trial. The cell line is referred to as 22P1GSF
because it can be grown in serum-free cell culture medium. The goal of the study was to show that the site of integration is not
near to a cancer-causing gene as well as to identify and characterize PCR primers that could be used as an identity test for release
of the product.
Next Generation Sequencing (“NGS”)
followed by a robust and multi-faceted analysis of the data yielded could confirm that the cytochrome P450-2B1 transgene from the
CMV-CYP plasmid transfection of HEK293 cells (to create the 22P1G cell line) resulted in the stable integration of plasmid sequences
into a non-gene-coding region of human chromosome 9. Using the NGS sequence data, a Capture PCR protocol was tested in an attempt
to fish-out products with identified chromosome 9 and plasmid sequences but this was not successful. Instead, a parallel strategy
using PCR, designing of several rounds of primers and nested primers followed by primer walking sequencing was undertaken. After
several progressive rounds of work, it was possible to obtain sequences confirming the integration site of the CMV-CYP plasmid
in chromosome 9. The NGS data showed that all of the CMV-CYP plasmid sequences are present between positions 93,691,754 and 93,691,785
of chromosome 9 in the 22P1G genome but it was not possible to elucidate the entire structure (number and orientation of repeats)
of the plasmid sequences in complete detail, most likely due to the plasmid being concatemerized in various orientations. Nevertheless,
the CMV promotor region and the CYP2B1 gene was confirmed to be present at this location in chromosome 9 by the PCR work here and
previous work by Austrianova with enzymatic assays and Southern blotting confirms this by also showing that the CYP gene is biologically
functional.
Initial Two Testing of Alternative Methods
and Reagents for Measuring Cell Numbers: This involved the required testing of various new assays, especially those directed
at new DNA synthesis, to validate or modify Austrianova’s existing cell number metabolic activity assays. This testing was
done at the request of the FDA to demonstrate cell numbers in the capsules and to determine cell viability. This testing program
focused on developing several assays as appropriate and quantitative assays that are effective even at high cell densities.
Bench Thawing Study. The purpose
of this study was to assess the stability of encapsulated 22P1G cells after hand thawing and subsequent exposure to room temperature.
It involves testing the metabolic activity of the cells in the capsules after hand-unfreezing and placement at room temperature
for varying lengths of time.
Capsule Cell Count Study:
This study is part of a larger
objective (which also included a previous PrestoBlue study) aimed at testing alternative methods and reagents for measuring
cell division and determining the numbers of cells in capsules. This involved the testing of various new assays, especially
those aimed at new DNA synthesis, to validate or modify existing metabolic activity assays which indirectly determines cell
number. This study is a consequence of the request of the FDA to demonstrate cell number in capsules as well as cell
viability. The program focused on developing the Celltox Green and Decapsulation Cell Count assays as appropriate
quantitative assays.
After extensive investigations it was concluded
that the best method of estimating cell numbers inside the capsule is the Decapsulation Cell Count. Several issues remain unresolved
with the Celltox Green assay, such as: (i) the disparity in peak cell numbers when compared with the Direct Cell count method;
(ii) the plateauing of total cell numbers and drop in live cell numbers; (iii) the high standard error due to the low signal window
required to keep within the linear range of the cell standard; and (iv) the large day-by-day fluctuation inherent in the method.
In contrast, the direct cell count method
provided stable, consistent results with comparatively low standard errors and fluctuation. It also has the advantage of being
a direct visualization method, which gives more confidence in the interpretation of the raw input data than either Celltox Green
or Prestoblue assays. As a result of this project, not only the best method to be used was determined but also simultaneously allowed
the creation of a final and robust standard operating procedure (“SOP”) which will now be transferred into an SOP for
integration into the documentation system for use during the manufacturing procedure for quality control.
Final Testing of Alternative Methods
and Reagents for Measuring Cell Numbers: A third testing alternative method and testing for reagents for measuring cell division
were completed. This involved the testing of additional new assays directed at new DNA synthesis to validate or modify our existing
cell number metabolic activity assays.
Manufacturing Process Testing: Following
an initial manufacturing run, changes were made to parts of the manufacturing process being performed under current Good Manufacturing
Practice (“cGMP”) conditions at Austrianova’s manufacturing facility in Bangkok, Thailand. The data obtained
from the encapsulation parameters of the manufacturing process itself indicated that the encapsulation portion of the process is
fault-free and reproducible, which is a fundamental requirement of the FDA.
Experiments to Optimize the Growth of
the Encapsulated Cells from the MCB: The cells from the MCB produced by Eurofins showed slightly different growth properties
when compared to the cells from our Research Cell Bank (“RCB”) that were previously tested by Austrianova’s laboratories,
a finding that is not unusual when a new cell bank is established. Although minor in nature, these different growth characteristics
of the MCB cells initially affected many of the steps required for the overall production process of our clinical trial material
called “CypCaps™,” necessitating counter-measures to re-align and restructure part of the production process.
Several independent tests were conducted by Austrianova to test the effects of possible changes to the production process.
Experiments by Austrianova and Eurofins.
Several experiments were conducted by Austrianova in its laboratory in Singapore. Based upon the results of those experiments,
changes were incorporated into the manufacturing process at the manufacturing facility in Bangkok, Thailand. Those changes led
to Austrianova’s successful encapsulation and growth of the live cells from the MCB which will be used in our therapy for
pancreatic cancer. The growth components of the experiments that were done to see what changes should be made to the pre-encapsulation
portion of the production process were conducted by Eurofins as well.
Completion of Technology Transfer: All of the manufacturing
technology developed by Austrianova was documented according to cGMP standards and successfully transferred to Austrianova’s
Thailand facility where the encapsulation of our clinical trial material will be done.
Encapsulation and Further Testing
We are in the process of conducting two
additional and staggered manufacturing runs in order to maximize the chances for a successful IND submission, given the novelty
and complexity of the manufacturing process. These runs are also required by cGMP Validation, Inc, the company who is taking responsibility
for “releasing” the clinical trial material into the U.S.
Following the encapsulation process, numerous
tests will be conducted by Austrianova to generate the data necessary to satisfy regulatory requirements for the IND. When Austrianova
finishes its work, it will issue a COA for our encapsulated cell product that we believe will comply with the FDA requirements
Revised Trial Design
We have completed a redesign of our planned
clinical trial from a registrational trial to a Phase 2b trial. To help with the redesign of our clinical trial in patients with
LAPC we formed an Oncology Advisory Board (“Advisory Board”) with leading oncologists in the U.S. Members include Dr.
James Abbruzzese (Duke University Medical Center), Dr. Alok Khorana (The Cleveland Clinic Lerner College of Medicine), Dr. Eileen
O’Reilly (Memorial Sloan Kettering Cancer Center), Dr. Vincent Picozzi (Virginia Mason Medical Center), Dr. Margaret Tempero
(University of California, San Francisco), Dr. Syma Iqbal (USC Keck School of Medicine, Norris Cancer Center) and Dr. Robert McWilliams
(The May Clinic Rochester). Dr. Manuel Hidalgo (“Dr. Hidalgo”), the Principal Investigator for the LAPC trial and a
consultant to our company, led these individuals in working with us to finalize the new trial design
Study Synopsis and Schedule of Assessments
The Study Synopsis and Schedule of Assessments
for the Phase 2b trial have been revised by our Clinical Trial Leadership Team (“CTLT”). The CTLT meets on a regular
basis to advance our clinical development program for pancreatic cancer.
Members of the CTLT include Kenneth L.
Waggoner (“Mr. Waggoner”), our Chief Executive Officer, President and General Counsel, Dr. Gerald W. Crabtree (‘Dr.
Crabtree”), our Chief Operating Officer, Dr. Linda Sher (“Dr. Sher”), our Chief Medical Officer, Dr. Löhr,
the Chairman of our Medical and Scientific Advisory Board and a consultant to us, Dr. Hidalgo, a consultant to us and the Principal
Investigator for the clinical trial in LAPC, Dr. Leonard Makowka, our Senior Strategic Advisor to the Chief Executive Officer and
our Board of Directors (“Board”), Lisa Guttman of Practical Clinical (a company specializing in clinical trial planning
and execution) who is our Director of Clinical Operations and Jason Mercer and then Maria Osaka, the Project Managers from Facet.
The purpose of the new study design is
to investigate the efficacy and safety of CypCaps™ (genetically engineered human cells encapsulated using the
Cell-in-a-Box® technology) in combination with low doses (1g/m2) ifosfamide as compared to chemoradiation
therapy with capecitabine plus external beam radiation therapy (“EBRT”) or stereotactic body radiation therapy (“SBRT”)
alone. The study population has been finalized and will consist of approximately 100 patients with LAPC.
CRO Selection Process Completed
The CTLT concluded its selection process
for a Contract Research Organization (“CRO”) to conduct our clinical trial in LAPC. We selected Medpace, Inc. (“Medpace”)
as our CRO. Medpace is an established and highly regarded full-service CRO with expertise in numerous therapeutic areas focused
on supporting the biotech sector. It is a scientifically-driven organization with a dedicated in-house study team supported by
outstanding experts to lead the way. Medpace has an extensive portfolio of successfully completed clinical trials, including those
involving pancreatic cancer. In 2018, Medpace was ranked among the top 10 CROs in the world.
Cannabinoids to Treat Cancer
Numerous studies have demonstrated the
anti-cancer effects of certain cannabinoids (constituents of Cannabis). Two of the most widely studied cannabinoids in this
regard are tetrahydrocannabinol (“THC”) and cannabidiol (“CBD”). Cannabinoids are: (i) anti-proliferative
(slow tumor growth); (ii) anti-metastatic (slow tumor spread); (iii) anti-angiogenic (slowing blood vessel development); and (iv)
pro-apoptotic initiate programed cell death). In in vitro and in vivo models, the anti-cancer effects of cannabinoids
are broad. They have been shown to apply to lung, brain, thyroid, lymphoma, liver, skin, pancreas, uterus breast and prostate cancers.
In a review of 51 scientific studies, among other properties, it was observed that cannabinoids can regulate cellular signaling
pathways critical for cell growth and survival. These properties indicate that cannabinoids could be useful in the treatment of
cancer.
As of May 2019, 33 states and the District
of Columbia have approved the use of Cannabis for medical purposes. A plethora of medical marijuana companies have emerged.
Most of them are involved in the production and distribution of Cannabis in its various forms, such as liquid extracts and
pills, and in Cannabis delivery systems, such as vapor pens. We believe we are one of the few companies that are focused
on using cannabinoids for the treatment of specific diseases.
We have several competitors that are developing
Cannabis-based treatments for cancer. GW Pharmaceuticals, PLC has an approved cannabinoid product for the treatment of multiple
sclerosis spasticity and is developing a product portfolio to treat a variety of illnesses, including glioblastoma (brain cancer).
Cannabis Science, Inc. is developing topical cannabinoid treatments for basal and squamous cell skin cancers and Kaposi’s
sarcoma, and is exploring pre-clinical development of cannabinoid-based anti-cancer drugs in a collaborative agreement with the
Dana Farber/Harvard Cancer Center. OWC Pharmaceutical Research Corp. is developing Cannabis-based products targeting a variety
of indications and has a collaborative agreement with an academic medical center in Israel to study the effects of cannabinoids
on multiple myeloma (a cancer of plasma cells). Cannabis Pharmaceuticals, Inc. is developing personalized anti-cancer and palliative
Cannabis-based treatments aimed mainly at improving the cachexia, anorexia syndrome and quality-of-life issues that are
often characteristic of patients with devastating diseases like cancer.
In contrast to the work being done by these
companies, we plan to focus on developing specific therapies based on carefully chosen molecules rather than using complex Cannabis
extracts. Our therapy will use the Cell-in-a-Box® technology in combination with genetically modified cell lines
designed to activate cannabinoid molecules for the treatment of diseases and their related symptoms. Our initial target will be
glioblastoma – a very difficult-to treat form of brain cancer.
Cannabis-derived
cannabinoids
“prodrugs” |
+ |
Bio-engineered cell line
encapsulated using Cell-in-a-Box® produces activating enzyme |
+ |
Targeted chemotherapy using activated cannabinoids
☐
☐
cancer cell death |
In May 2014, we entered into a Research
Agreement with the University of Northern Colorado (“UNC”). The goal of the ongoing research is to develop methods
for the identification, separation and quantification of constituents of Cannabis, some of which are prodrugs, which may
be used in combination with the Cell-in-a-Box® technology to treat cancer. Significant effort has been expended
to establish accurate analytical methods to separate, identify and quantitate various cannabinoids; these methods have now been
identified. Studies have also been undertaken using cannabinoids to identify the appropriate cell type that can best convert the
selected cannabinoid prodrugs into metabolites with anticancer activity. Once identified, the genetically modified cells which
are expected to produce the appropriate enzyme to convert that cannabinoid prodrug will be encapsulated using the Cell-in-a-Box®
technology. The encapsulated cells and cannabinoid prodrugs identified by these studies will then be combined and used for future
studies to evaluate their anticancer effectiveness.
In January 2017, we entered into a second
Research Agreement with UNC. The goal of this ongoing research is to assess the synthesis of the patG gene and its incorporation
into a vector, transfection of human embryonic kidney cells using this vector and assessment of cannabinoic acid decarboxylase
activity.
During 2017, UNC identified an organism
whose genome contains the genetic code for production of an enzyme capable of activating a cannabinoid prodrug into its active
cancer-killing form. Our Cannabis Program now has two primary areas of focus. The first is confirming the anti-cancer activity
of cannabinoids, such as THC and CBD, particularly in our main “target” tumor – glioblastoma. UNC’s research
has confirmed that a purified cannabinoid showed a potent dose-dependent decrease in cell viability for various cancers, suggesting
that this cannabinoid exhibits significant anti-proliferative effects (stops the growth of cancer cells). This activity has been
demonstrated in brain (glioblastoma), pancreas, breast, lung, colon and melanoma cancer cells. The second area of focus is in finding
an enzyme capable of converting an inactive, side-effect-free, cannabinoid prodrug into its active cancer-killing form. The research
team at UNC has screened numerous cell lines and numerous enzymes. As result of this extensive work, an organism has been identified
that has been confirmed to produce an enzyme capable of catalyzing the desired cannabinoid-prodrug-activating reaction.
The next step is to test the efficiency
of the transfected cells in converting cannabinoid prodrugs into their active cancer-fighting forms. If the cells are suitably
active, they would then be propagated to the point that they can be encapsulated using the Cell-in-a-Box® technology.
Also, we will continue our analysis of other genes of interest that could be used in a similar way.
Clinically, targeted cannabinoid-based
chemotherapy would be accomplished by implanting the encapsulated bio-engineered cells near the site of a tumor, along with administration
of a cannabinoid prodrug which would become activated at the site of the tumor by an enzyme produced by the encapsulated cells.
The end goal is better efficacy than existing therapies with few, if any, treatment related side effects.
Malignant Ascites Fluid Therapy
We are studying the development of a possible
therapy to delay the production and accumulation of malignant ascites fluid that results from many types of abdominal tumors. Malignant
ascites fluid is secreted by an abdominal tumor into the abdomen after the tumor reaches a certain stage of growth. This fluid
contains cancer cells that can seed and form new tumors throughout the abdomen. As this ascites fluid accumulates in the abdominal
cavity, it can cause gross swelling of the abdomen, severe breathing difficulties and extreme pain.
Once an abdominal tumor reaches a certain
stage of development, it secretes malignant ascites fluid into the abdominal cavity. When that occurs, malignant ascites fluid
must be removed by paracentesis on a periodic basis. This procedure is painful and costly. We know of no available therapy that
prevents or delays the production and accumulation of malignant ascites fluid. We have been involved in eight preclinical studies
conducted by Translational Drug Development (“TD2”), an early stage CRO specializing in oncology, to determine if the
combination of Cell-in-a-Box® encapsulated cells plus low doses of ifosfamide can delay the production and
accumulation of malignant ascites fluid. The data from these eight studies indicated that the treatment might play a role in malignant
ascites fluid production and accumulation, but the conclusions were difficult to interpret with certainty. As a result, we plan
to conduct another preclinical study in Germany to determine if our conclusions from the TD2 studies are valid. If the ninth study
is successful, we plan to seek approval from the FDA to conduct a Phase 1 clinical trial in the U.S.
Diabetes Therapy
Diabetes
Diabetes is caused by insufficient availability
of, or resistance to, insulin. Insulin is produced by the beta islet cells of the pancreas. Its function is to assist in the transport
of sugar (glucose) in the blood to the inside of most types of cells in the body where it is used as a source of energy for those
cells. In Type 1 diabetes, the islet cells of the pancreas have been destroyed, usually by an autoimmune reaction. Type 1 diabetics
require daily insulin administration through injection or by use of an insulin pump. In Type 2 diabetes, the body does not use
properly insulin that is produced by the pancreas. This means the body has become resistant to insulin produced by the pancreas.
Type 2 diabetes can generally be controlled by diet and exercise in its early stages. But as time goes by, it may be necessary
to use antidiabetic drugs to control the disease. However, over time these too may lose their effectiveness. Thus, even Type 2
diabetics may become insulin-dependent.
Diabetes Epidemic
Diabetes is one of the largest health problems
in the world. In its 2016 Global Report on Diabetes, the World Health Organization (“WHO”) estimated that, by the end
of 2014, 422 million people worldwide had the disease – 314 million more than in 1980. Approximately 8.5% of adults worldwide
have diabetes. Approximately $825 billion is spent annually in the treatment of diabetes and related healthcare. Nearly 30 million
people in the U.S. have diabetes. Diabetes and prediabetes cost the U.S. more than $32 billion per year. The worldwide market for
diabetes treatment drugs alone is over $70 billion.
Efforts to Cure Diabetes
In an attempt to “cure” Type
1 diabetes, replacement of damaged pancreatic beta islet cells has been attempted. This involves transplantation of the entire
pancreas or of its beta islet insulin-producing cells. In 2000, islet cells from human cadavers were transplanted into insulin-dependent
diabetics in a clinical trial. In this clinical trial involving seven patients in Edmonton, Canada, each patient remained insulin-independent
for one year. But high doses of immune-suppressive drugs were needed to accompany the transplantations to avoid rejection of the
transplanted islet cells. Without immunosuppressive drugs, these patients would be at a high risk of infection by bacteria, viruses
and fungi and open to the growth of cancerous tumors. Therefore, the administration of these immunosuppressive drugs was necessary
throughout the remaining lifespan of the patients in the trial. Unfortunately, these drugs are not only expensive, but they are
also associated with serious side effects that have required patients to cease long-term treatment with them. Worldwide, less than
1,000 people with Type 1 diabetes are known to have been transplanted with pancreatic islet cells from another human being.
To avoid the use of islet cells from human
donors, encapsulated islet cells from pigs have been used. This type of interspecies transplantation is known as “xenotransplantation”.
Drug regulatory authorities have been reluctant to approve the use of such interspecies transplantations. Also, other challenges
with this approach include the potential for the body’s immune system to attack the transplanted cells. To protect the non-human
cells from attack by the immune system of the human being, they have been encapsulated using forms of encapsulation technology
that are different than the encapsulation technology we use. In those studies, the transplanted islet cells from pigs were surrounded
by a porous capsule, typically made of alginate - a derivative of seaweed.
Efforts to translate this concept into
a viable treatment for Type 1 diabetes have been plagued by poor survival of the transplanted islet cells. Furthermore, the integrity
of capsules composed of alginate has been shown to degrade over time. This degradation allows for immune system cells to attack
the transplanted pig islet cells and this, in turn, necessitates additional transplantations. Also, as the alginate “capsules”
degrade, they themselves can elicit an immune response.
Different tubular and planar “chamber-type”
immune-protective devices that contain islet cells are under development by several companies. Such devices are placed in the body
where they can be retrieved and replaced if necessary. Tubular chambers have shown good biocompatibility, but they are subject
to rupture, exposing the islets to immune system attack. They also require large numbers of islet cells. Planar chambers are more
stable, but they can cause extensive foreign body reactions in the host resulting in fibrotic overgrowth of the chambers which
can cause “death” of the encapsulated islet cells and thus overall transplant failure.
Among the most extensively researched immune-protective
strategy is that which employs micro-capsules. They are relatively simple to manufacture, can be implanted into the body without
major surgery and, depending on the nature of the encapsulation material, micro-encapsulated cells can be cryopreserved. Micro-encapsulated
islet cells first appeared in 1994 when a diabetic patient, already receiving immunosuppressive drugs, was transplanted with these
cells encapsulated in alginate and remained insulin-independent for nine months. However, 23 years and numerous clinical trials
later, there are still no publicly reported cases of long-term insulin-independence in non-immune-suppressed diabetic patients
receiving encapsulated pancreatic islet transplants.
A Bio-Artificial Pancreas for Diabetes
We are developing a therapy for Type 1
diabetes and insulin-dependent Type 2 diabetes based upon the encapsulation of a human liver cell line genetically engineered to
produce, store and secrete insulin at levels in proportion to the levels of blood sugar in the human body. We are also considering
an alternative route to bringing a biological treatment for diabetes into the clinic. We are exploring the possibility of encapsulating
human insulin-producing stem cells and islet cells and then transplanting them into a diabetic patient.
All three types of cells will be encapsulated
using the Cell-in-a-Box® encapsulation technology. After appropriate animal testing has been completed successfully,
we will seek the FDA’s approval to transplant encapsulated insulin-producing cells into diabetic patients. The goal for these
approaches is to develop a bio-artificial pancreas for purposes of insulin production for diabetics who are insulin-dependent.
Austrianova has already successfully encapsulated
live pig pancreas islet insulin-producing cells using the Cell-in-a-Box® technology. We understand that the encapsulated
cells were then given to the University of Graz and implanted into diabetic rats. In this one-time experiment, it was reported
in a poster presentation that the rats’ blood glucose levels normalized by day seven and remained normal throughout the study
period of approximately 150 days. However, when attempts were made at the University of Graz to repeat this study on its own (including
the encapsulation process), those at the University of Graz were unsuccessful. It is believed that this lack of reproducibility
was due to a lack of knowledge of Austrianova’s encapsulation technology and trade secrets that reside with the Cell-in-a-Box®
encapsulation technology.
We believe that encapsulating genetically
engineered human cells, genetically engineered stem cells and beta islet cells using the Cell-in-a-Box® cellulose-based
encapsulation technology has numerous advantages over encapsulation of cells with other materials, such as alginate. The Cell-in-a-Box®
capsules are composed largely of cellulose, which is a bio-inert material in the human body. Also, these capsules are robust
and do not trigger any sort of immune or inflammatory response from the body. This allows the capsules to remain intact for long
periods of time in the body, all the while protecting the living cells inside them from immune system attack. In earlier clinical
studies, these capsules and the cells inside them have not caused any immune or inflammatory responses like those seen with alginate-encapsulated
cells, and any fibrotic overgrowth that occurs with the Cell-in-a-Box® capsules is minimal to none.
Our Diabetes Program began with two of
the most critical components of a biological diabetes therapy - a line of human cells which release insulin in response to the
blood glucose level in their environment and a technology to protect the cells from an attack by the immune system once they are
transplanted into a patient’s body to replace his or her own destroyed insulin-producing cells. This technology is the Cell-in-a-Box®
encapsulation technology. The cells used are called Melligen cells. They are patent-protected and have been licensed to us
by the University of Technology, Sydney (“UTS”).
Melligen cells are no ordinary insulin-producing
cells. They stand out from the array of cells used and newly created cells to serve as a replacement for insulin-producing cells
in diabetics. We believe Melligen cells are much more robust than intrinsic insulin-producing cells and withstand an attack by
cell-toxic molecules that typically lead to the destruction of insulin-producing cells.
Regulations for the use of living cells
as a medical product require that the potential of the cells to grow and form a tumor in a patient be assessed. This so-called
“tumorigenicity study” has been completed successfully by our International Diabetes Consortium. Melligen cells showed
very low tumorigenicity – the level one would expect to pass regulatory scrutiny.
Putting Melligen cells and the Cell-in-a-Box®
technology together, we conducted the first functional study in diabetic mice. The results did not meet our expectations. We discovered
that, contrary to what we had expected and what we had read in published scientific papers on the Melligen cells published by UTS,
the cells are not stable. With extensive testing and experiments, we discovered that the Melligen cells lose some of their specific
beneficial properties over time.
Because of the advantages we felt the Melligen
cells have over other competing therapies for diabetes, we made the decision to recreate the Melligen cells and to include a few
needed improvements. To minimize the delay in the development of our Diabetes Program caused by the challenges encountered from
the Melligen cells, we opened an additional, alternative route to bring a biological treatment for diabetes into the clinic. Concurrently
with the recreation of functioning Melligen cells, we are exploring the possibility of encapsulating genetically modified stem
cells and human insulin-producing pancreatic beta islet cells and then transplanting them into diabetic patients.
The first step in examining the feasibility
of such an approach is an animal experiment using insulin-producing islet cells from one animal -- encapsulating them -- and then
transplanting them into another animal. We plan to conduct preclinical studies at the University of Veterinary Medicine (“VetMed”),
Vienna, Austria where Dr. Günzburg is a Professor. An encapsulation machine has been put into place at the VetMed, and the
first live-cell encapsulation at the site was conducted successfully.
Recently we reached an agreement with UTS
to enter into a new research agreement to create an advanced version of the Melligen cells for the treatment of diabetes. Under
the new research agreement, which is in the process of being prepared, improvements will be made to the Melligen cells that we
expect will increase their stability, increase their insulin production and increase the bioactivity of the produced insulin.
Prof. Ann Simpson, who created the Melligen
cells, and her team of research scientists at UTS will be conducting this new research project. Dr. Eva Marie Brandtner (“Dr.
Brandtner”), our Director of Diabetes Program Development, will also be involved in the research project.
International Diabetes Consortium
We have established an international Diabetes
Consortium (“Consortium”). The Consortium consists of world-renowned physicians and scientists from several countries
around the globe, all of whom share the same goal of developing a therapy for Type 1 and insulin-dependent Type 2 diabetes.
In addition to our Chief Executive Officer,
Chief Operating Officer, Chief Medical Officer and Chief Scientific Officer, the Consortium is made up of well-known physicians
and scientists from leading Universities in Munich, Germany, Mannheim, Germany, Vienna, Austria, Barcelona, Spain, Copenhagen,
Denmark and Sydney, Australia. It also includes members from the Karolinska Institute in Stockholm, Sweden, the Vorarlberg Institute
for Vascular Investigation and Treatment (“VIVIT”) in Feldkirch, Austria and Austrianova in Singapore.
Dr. Brandtner, Head of the Bioencapsulation
Unit at VIVIT, leads the Consortium and is our Director of Diabetes Program Development. Dr. Brandtner previously served as the
Chief Scientist with Austrianova and is an expert in the use of the Cell-in-a-Box® encapsulation technology.
`
Relationship between PharmaCyte, S.G.
Austria and Austrianova
The principal developers of the Cell-in-a-Box®
technology are Prof. Dr. Walter H. Günzburg (“Prof. Günzburg”) and Dr. Brian Salmons (“Dr. Salmons”).
Both are officers of SG Austria Pte. Ltd. (“SG Austria”) and its wholly-owned subsidiary Austrianova. The success of
SG Austria and Austrianova, on the one hand, and our success, on the other hand, are co-dependent in almost every respect. SG Austria
and Austrianova benefit from our success. If we sublicense our encapsulation technology for the development of therapies for cancer
and diabetes, payments are owed by us to SG Austria or Austrianova. In turn, we are dependent upon SG Austria and Austrianova because
of the knowledge and expertise of Prof. Günzburg and Dr. Salmons concerning the Cell-in-a-Box® technology and
the actual process of cell encapsulation. This technology serves as the basis for all our efforts in developing treatments for
both cancer and diabetes. In addition, we own a 14.5% equity interest in SG Austria and have contractual relationships, including
license agreements, with SG Austria and Austrianova.
Key Consultants
Prof. Günzburg and Dr. Salmons are
involved in numerous aspects of the scientific endeavors relating to our Cancer and Diabetes Programs, having initially commenced
work for us as consultants at the beginning of 2014 under an oral agreement. They provide services to us as consultants through
their consulting company, Vin-de-Bona Trading Company Pte Ltd (“Vin-de-Bona”). This arrangement was formalized in writing
as of April 1, 2014, when we entered a Consulting Agreement with Vin-de-Bona (“Vin-de-Bona Consulting Agreement”).
The Vin-de-Bona Consulting Agreement had an initial term of 12 months, with additional terms of 12 months automatically renewing
unless either party terminates an additional term upon 30 days’ prior written notice. The professional services rendered
to us by Prof. Günzburg and Dr. Salmons are charged at a negotiated and confidential hourly rate.
The Vin-de-Bona Consulting Agreement requires
that Prof. Günzburg and Dr. Salmons not disclose or use our confidential information for any purpose, other than performing
services under the Consulting Agreement, without our prior written consent. Also, during the term of the Vin-de-Bona Consulting
Agreement and for a period of twelve months after termination or expiration of the agreement, Dr. Günzburg and Dr. Salmons
are prohibited from soliciting any of our customers, employees, suppliers or other persons with whom they had dealings during the
tenure of their consultancy for us.
In September 2014, Dr. Günzburg was
appointed as our Chief Scientific Officer. Dr. Günzburg is compensated for being our Chief Scientific Officer by us issuing
Vin-de-Bona 500,000 restricted shares of our common stock. Dr. Günzburg is compensated in the same way and in the same amount
for each succeeding year during which he serves as our Chief Scientific Officer.
Dr. Löhr, a noted European oncologist
and gastroenterologist, also participates in the development of our Cancer Program. Dr. Löhr, currently with the Karolinska
Institute in Stockholm, Sweden, served as Principal Investigator of the earlier Phase 1/2 and Phase 2 clinical trials (discussed
below) of the combination of CapCell® with low-dose ifosfamide in patients with advanced, inoperable pancreatic
cancer. CapCell® is now known as and hereinafter referred to as CypCaps™ denoting encapsulated
cells using the Cell-in-a-Box® technology that will be used in our LAPC trial. Like Dr. Günzburg and Dr. Salmons,
Dr. Löhr is involved in planning and overseeing much of our planned clinical trial in LAPC. Dr. Löhr is the Chairman
of our Medical and Scientific Advisory Board and a consultant to us. Dr. Löhr received 500,000 shares of our restricted common
stock to serve as the Chairman of our Medical and Scientific Advisory Board. Since April 15, 2014, Dr. Löhr also receives
fees to provide professional consulting services to us through his consulting company based upon a confidential hourly rate.
History of the Business
We were incorporated in 1996. In 2013,
we restructured our operations to focus on biotechnology, having been a nutraceutical products company before then. The restructuring
occurred so we could develop a unique, effective and safe way to treat cancer and diabetes. On January 6, 2015, we changed our
name from “Nuvilex, Inc.” to “PharmaCyte Biotech, Inc.” to reflect the nature of our business.
As mentioned above, we are now a clinical
stage biotechnology company focused on developing and preparing to commercialize cellular therapies for cancer and diabetes using
our live cell encapsulation technology. This resulted from entering into the following agreements.
On May 26, 2011, we entered an Asset Purchase
Agreement with SG Austria (“SG Austria APA”) to purchase 100% of the assets and liabilities of SG Austria. Under the
SG Austria APA, Austrianova and Bio Blue Bird AG ("Bio Blue Bird"), then wholly-owned subsidiaries of SG Austria, were
to become wholly-owned subsidiaries of ours on the condition that we pay SG Austria $2.5 million and 100,000,000 shares of our
common stock. We were to receive 100,000 shares of common stock of Austrianova and nine bearer shares of Bio Blue Bird representing
100% of the ownership of Bio Blue Bird.
Through two addenda to the SG Austria APA,
the closing date of the SG Austria APA was extended twice by agreement between the parties.
In June 2013, we and SG Austria entered
a Third Addendum to the SG Austria APA (“Third Addendum”). The Third Addendum materially changed the transaction contemplated
by the SG Austria APA. Under the Third Addendum, we acquired 100% of the equity interests in Bio Blue Bird and received a 14.5%
equity interest in SG Austria. We paid: (i) $500,000 to retire all outstanding debt of Bio Blue Bird; and (ii) $1.0 million to
SG Austria. We also paid SG Austria $1,572,193 in exchange for the 14.5% equity interest of SG Austria. The transaction required
SG Austria to return to us the 100,000,000 shares of our common stock held by SG Austria and for us to return to SG Austria the
100,000 shares of common stock of Austrianova we held.
Effective as of the same date we entered
the Third Addendum, we and SG Austria also entered a Clarification Agreement to the Third Addendum (“Clarification Agreement”)
to clarify and include certain language that was inadvertently left out of the Third Addendum. Among other things, the Clarification
Agreement confirmed that the Third Addendum granted us an exclusive, worldwide license to use, with a right to sublicense, the
Cell-in-a-Box® technology and trademark for the development of therapies for cancer.
With respect to Bio Blue Bird, Bavarian
Nordic A/S (“Bavarian Nordic”) and GSF-Forschungszentrum für Umwelt u. Gesundheit GmbH (collectively, “Bavarian
Nordic/GSF”) and Bio Blue Bird entered into a non-exclusive License Agreement (“Bavarian Nordic/GSF License Agreement”)
in July 2005, whereby Bio Blue Bird was granted a non-exclusive license to further develop, make, have made (including services
under contract for Bio Blue Bird or a sub-licensee, by Contract Manufacturing Organizations, Contract Research Organizations, Consultants,
Logistics Companies or others), obtain marketing approval, sell and offer for sale the clinical data generated from the pancreatic
cancer clinical trials that used the cells and capsules developed by Bavarian Nordic/GSF (then known as “CapCells”)
or otherwise use the licensed patent rights related thereto in the countries in which patents had been granted. Bio Blue Bird was
required to pay Bavarian Nordic a royalty of 3% of the net sales value of each licensed product sold by Bio Blue Bird and/or its
Affiliates and/or its sub-licensees to a buyer. The term of the Bavarian Nordic/GSF License Agreement continued on a country by
country basis until the expiration of the last valid claim of the licensed patent rights.
Bavarian Nordic/GSF and Bio Blue Bird amended
the Bavarian Nordic License Agreement in December 2006 (“First Amendment to Bavarian Nordic/GSF License Agreement”)
to reflect that: (i) the license granted was exclusive; (ii) a royalty rate increased from 3% to 4.5%; (iii) Bio Blue Bird assumed
the patent prosecution expenses for the existing patents; and (iv) to make clear that the license will survive as a license granted
by one of the licensors if the other licensor rejects performance under the Bavarian Nordic License Agreement due to any actions
or declarations of insolvency.
In June 2013, we acquired from Austrianova
an exclusive, worldwide license to use the Cell-in-a-Box® technology and trademark for the development of a therapy
for Type 1 and insulin-dependent Type 2 diabetes (“Diabetes Licensing Agreement”). This allows us to develop a therapy
to treat diabetes through encapsulation of a human cell line that has been genetically modified to produce, store and release insulin
in response to the levels of blood sugar in the human body.
In October 2014, we entered into an exclusive,
worldwide license agreement with the UTS (“Melligen Cell License Agreement”) in Australia to use insulin-producing
genetically engineered human liver cells developed by UTS to treat Type 1 diabetes and insulin-dependent Type 2 diabetes. These
cells, named “Melligen”, were tested by UTS in mice and shown to produce insulin in direct proportion to the amount
of glucose in their surroundings. In those studies, when Melligen cells were transplanted into immunosuppressed diabetic mice,
the blood glucose levels of the mice became normal. In other words, the Melligen cells reportedly reversed the diabetic condition.
In December 2014, we acquired from Austrianova
an exclusive, worldwide license to use the Cell-in-a-Box® technology and trademark in combination with genetically
modified non-stem cell lines which are designed to activate cannabinoid prodrug molecules for development of therapies for diseases
and their related symptoms using of the Cell-in-a-Box® technology and trademark (“Cannabis Licensing Agreement”).
This allows us to develop a therapy to treat cancer and other diseases and symptoms through encapsulation of genetically modified
cells designed to convert cannabinoids to their active form using the Cell-in-a-Box® technology and trademark.
In July 2016, we entered into a Binding
Memorandum of Understanding with Austrianova (“Austrianova MOU”). Pursuant to the Austrianova MOU, Austrianova will
actively work with us to seek an investment partner or partners who will finance clinical trials and further develop products for
our therapy for cancer, in exchange for which we, Austrianova and any future investment partner will each receive a portion of
the net revenue from the sale of cancer products.
In October 2016, Bavarian Nordic/GSF and
Bio Blue Bird further amended the Bavarian Nordic License Agreement (“Second Amendment to Bavarian Nordic/GSF License Agreement”)
in order to: (i) include the right to import in the scope of the license; (ii) reflect ownership and notification of improvements;
(iii) clarify which provisions survive expiration or termination of the Bavarian Nordic License Agreement; (iv) provide rights
to Bio Blue Bird to the clinical data after the expiration of the licensed patent rights; and (v) change the notice address and
recipients of Bio Blue Bird.
In August 2017, we entered into a Binding
Term Sheet (“Binding Term Sheet”) with SG Austria and Austrianova pursuant to which the parties reached an agreement
to amend certain provisions in the SG Austria APA, the Diabetes Licensing Agreement, the Cannabis Licensing Agreement and the Vin-de-Bona
Consulting Agreement.
In May 2018, the Company entered into the
amendments contemplated by the Binding Term Sheet (“Binding Term Sheet Amendments”). The Binding Term Sheet Amendments
provide that our obligation to make milestone payments to Austrianova is eliminated in their entirety under the: (i) Cannabis License
Agreement; and (ii) the Diabetes License Agreement, as amended. The Binding Term Sheet Amendments also provide that our obligation
to make milestone payments to SG Austria pursuant to the SG Austria APA, as amended and clarified, is eliminated in their entirety.
One of the Binding Term Sheet Amendments also provides that the scope of the Diabetes License Agreement is expanded to include
all cell types and cell lines of any kind or description now or later identified, including, but not limited to, primary cells,
mortal cells, immortal cells and stem cells at all stages of differentiation and from any source specifically designed to produce
insulin for the treatment of diabetes.
In addition, one of the Binding Term Sheet
Amendments provides that we will have a 5-year right of first refusal from August 30, 2017 in the event that Austrianova chooses
to sell, transfer or assign at any time during this period the Cell-in-a-Box® technology, tradename and Associated
Technologies (defined below), intellectual property, trade secrets and know-how, which includes the right to purchase any manufacturing
facility used for the Cell-in-a-Box® encapsulation process and a non-exclusive license to use the special cellulose
sulfate utilized with the Cell-in-a-Box® encapsulation process (collectively, “Associated Technologies”);
provided, however, that the Associated Technologies subject to the right of first refusal do not include Bac-in-a-Box®.
Additionally, for a period of one year from August 30, 2017 one of the Binding Term Sheet Amendments provides that Austrianova
will not solicit, negotiate or entertain any inquiry regarding the potential acquisition of the Cell-in-a-Box® and
its Associated Technologies.
The Binding Term Sheet Amendments further
provide that: (i) the royalty payments on gross sales as specified in the SG Austria APA, the Cannabis License Agreement and the
Diabetes License Agreement are changed to 4%; and (ii) the royalty payments on amounts received by us from sublicensees on sublicensees’
gross sales under the same agreements are changed to 20% of the amount received us from our sublicensees, provided, however,
that in the event the amounts received by us from sublicensees is 4% or less of sublicensees’ gross sales, Austrianova
will receive 50% of what we receive (up to 2%) and then additionally 20% of any amount we receive over that 4%.
One of the Binding Term Sheet Amendments
requires that we pay $900,000 to Austrianova ratably over a nine-month period in the amount of two $50,000 payments each month
during the nine-month period on the days of the month to be agreed upon between the parties, with a cure period of 20 calendar
days after receipt by us of written notice from Austrianova that we have failed to pay timely a monthly payment. As of April 30,
2019, the $900,000 amount has been paid in full.
The Binding Term Sheet Amendments also
provide that Austrianova receives 50% of any other financial and non-financial consideration received from our sublicensees of
the Cell-in-a-Box® technology.
Finally, one of the Binding Term Sheet
Amendments provides that Dr. Günzburg will not receive any cash compensation from us for services rendered as our Chief Scientific
Officer under the Vin-de-Bona Consulting Agreement for a period of six months beginning September 1, 2017.
Goal and Strategies to Implement
Our goal is to become an industry-leading
biotechnology company using the Cell-in-a-Box® technology as a platform upon which therapies for cancer and diabetes
are developed and obtain marketing approval for these therapies from regulatory agencies in the U.S., the European Union (“E.U.”),
Australia and Canada.
Our strategies to implement our goal consist
of the following:
| • | Submission of our IND to the FDA and for the FDA to allow us to commence a clinical trial for LAPC; |
| • | Completion of preclinical studies and clinical trials that demonstrate the effectiveness of our
cancer therapy in reducing the production and accumulation of malignant ascites fluid in the abdomen that is characteristic of
pancreas and other abdominal cancers; |
| • | Completion of preclinical studies and clinical trials that involve the encapsulation of the Melligen
cells, genetically modified stem cells and beta islet or islet-like cells using the Cell-in-a-Box® technology to develop a
therapy for Type 1 and insulin-dependent Type 2 diabetes; |
| • | Enhancement of our ability to expand into the biotechnology arena through further research and
partnering agreements with one or more third parties involved in the development of cancer and diabetes therapies; |
| • | Acquisition of contracts that generate revenue or provide research and development capital utilizing
our sublicensing rights; |
| • | Further development of uses of the Cell-in-a-Box® technology platform through contracts, licensing
agreements and joint ventures with other companies; and |
| • | Completion of testing, expansion and marketing of existing and newly derived product candidates. |
Cell Therapy Product Development
In our efforts to bring potential treatments
to bear on pancreatic and other solid tumor cancers, we acquired Bio Blue Bird. This subsidiary holds our exclusive license, as
amended, to a certain type of genetically modified cell line we use with the Cell-in-a-Box® live cell encapsulation
technology for use in oncology. We have also entered into license agreements (discussed above and below) to use Cell-in-a-Box®
technology to develop a therapy for Type 1 and insulin-dependent Type 2 diabetes, as well as cancer therapies where the Cell-in-a-Box®
technology is combined with certain cannabinoids.
Our focus is currently placed on the preparations
for our planned Phase 2b clinical trial in LAPC. These preparations include the live cell encapsulation of cancer prodrug-activating
cells – the cells that convert the prodrug ifosfamide into its cancer-killing form. For our trial, as in the earlier Phase
1/2 and Phase 2 clinical trials that were done using live cell encapsulation plus ifosfamide, live cells expressing a cytochrome
P450 isozyme will be encapsulated using the Cell-in-a-Box® technology. These capsulated cells will be implanted
as close to the patient’s tumor as possible. Once implanted, ifosfamide, a chemotherapy drug that is normally activated in
the liver, will be given intravenously at approximately one-third (1 g/m2) of the normal dose. The ifosfamide will be
carried by the circulatory system to where the encapsulated cells have been implanted. When the ifosfamide flows through the porous
capsules with the live cells inside, they act as a “bio-artificial liver” and convert the inactive form of the chemotherapy
prodrug ifosfamide to its active form at or near the cancerous tumor. The results of this “targeted chemotherapy” are
discussed in more detail above and below.
The Cell-in-a-Box® encapsulation
technology potentially enables genetically engineered live human cells to be used as miniature factories. The technology results
in the formation of pin-head sized cellulose-based porous capsules in which genetically modified live human cells can be encapsulated
and maintained. In the laboratory setting, which involves the large-scale amplification and production of useful biotech products
outside the body of a person or animal, the proprietary live cell encapsulation technology has been shown to create a micro-environment
in which these encapsulated cells survive and flourish. They are protected from environmental challenges, such as the sheer forces
associated with bioreactors, passage through catheters and needles, etc., enabling greater growth and production of the end-product.
The capsules are largely composed of cellulose (cotton) and are bio-inert.
Our encapsulation technology has the potential
to enable live cells to survive in the human host and function like any other living cell in the body. The capsules contain small
pores. The pores are big enough to allow nutrients in and waste products out of the capsules and small enough to keep the cells
inside. Small molecules (such as ifosfamide, nutrients, oxygen and waste products) can pass through the pores of the capsules easily.
The cells of the human’s immune system cannot. The live cells inside the capsules do not protrude through the pores of the
capsules, for if they did so, they would be subject to immune system attack. The encapsulated cells live in the body and behave
like a miniature organ of the body without any inflammatory response or rejection. Furthermore, the cellulose-based capsules do
not appear to irritate or inflame nearby tissues. Nor do they cause fibrous overgrowth in the area where the capsules are
implanted.
Market Opportunity and the Competitive
Landscape
The two areas we are currently developing
for live cell encapsulation-based therapies are cancer and diabetes.
The Cell-in-a-Box® capsules
are comprised of cotton’s natural component - cellulose. Other materials used by competitors include alginate, collagen,
chitosan, gelatin and agarose. Alginate appears to be the most widely used of these. We believe the inherent strength and durability
of our cellulose-based capsules provides us with advantages over the competition. For example, the Cell-in-a-Box®
capsules have remained intact for approximately two years in humans and for several months in animals during clinical trials and
preclinical studies, respectively. They do so with no evidence of rupture, damage, degradation, fibrous overgrowth or immune system
response. The cells within the capsules also remained alive and functioning during these studies. Other encapsulating materials
degrade in the human body over time, leaving the encapsulated cells open to immune system attack. Damage to surrounding tissues
has also been reported to occur over time when other types of encapsulation materials begin to degrade
Studies have also shown that cells encapsulated
using the Cell-in-a-Box® technology can be frozen for extended periods of time. When thawed, the cells are recovered
with approximately 90% viability. We are unaware of any other cell encapsulation material that is capable of protecting their encapsulated
cells to this degree. The implications of this property of the Cell-in-a-Box® technology are obvious - long-term
storage of encapsulated cells and shipment of encapsulated cells over long distances.
We believe our live cell encapsulation
technology may have significant new advantages and opportunities for us in numerous and developing ways. For example:
| • | Cancerous diseases may be treated by placing encapsulated drug-converting cells that convert a
chemotherapy prodrug near the cancerous tumor; |
| • | Confinement and maintenance of therapeutic cells that activate a chemotherapy prodrug may be placed
at the site of implantation in a blood vessel near the cancerous tumor results in “targeted chemotherapy;” |
| • | Increased efficacy of a chemotherapy prodrug may allow for lower doses of the drug to be given
to a patient, significantly reducing or even eliminating side effects from the chemotherapy; |
| • | Encapsulating genetically modified live cells has the potential for the treatment of systemic diseases
of various types, including diabetes; |
| • | Multi-layered patent and trade secret protection and marketing exclusivity for our technology exists
and is being expanded; |
| • | Cell-in-a-Box® capsules can prevent immune system attack of functional cells inside them without
the need for immunosuppressive drug therapy; and |
| • | Safety and effectiveness of the Cell-in-a-Box® technology and the cells used with
our technology have already been shown in both human clinical trials and animal studies. |
The field of diabetes cell therapy development
is competitive. There are numerous companies developing cell-based therapies for diabetes. These competitors include companies
such as Viacyte, Inc. (“Viacyte”) in collaboration with Gore, Semma Therapeutics, Inc. in collaboration with Defymed,
SAS, Diabetes Research Institute Foundation, Beta-O2 Technologies Ltd., Diatranz Otsuka Ltd., Sernova Corp. and BetaCell NV. All
these entities are developing some form of encapsulation-based disease therapies. Although such competition exists, we believe
these other companies are developing encapsulation-based therapies using encapsulation materials and methodologies that produce
capsules or devices that are far less robust than ours or that are associated with other problems, such as extremely short shelf-life
of the product and/or fibrotic overgrowth of their encapsulation products when implanted in the body. These properties are not
characteristic of the Cell-in-a-Box® capsules.
Pancreatic cancer is increasing in most
industrialized countries. The American Cancer Society estimates that in 2019 there will be 56,770 people in the U.S. diagnosed
with pancreatic cancer. It estimates 45,750 patients with pancreatic cancer will die in 2019.
The
International Agency for Research on Cancer (“IARC”) released new global cancer statistics in September 2018.
Of the 18 million cancer diagnoses predicted worldwide in 2018, nearly half 500,000 will be pancreatic cancer. The World
Pancreatic Cancer Coalition (“WPCC”) predicts that more than 430,000 pancreatic cancer deaths worldwide will occur
in 2018. A diagnosis of pancreatic cancer is associated with poor prognosis due to early micrometastatic spread. The five-year
survival rate for metastatic pancreatic cancer is approximately 7% according to the American Cancer Society.
Even with the best available therapy, patients
with advanced pancreatic cancer can only expect median survival times of about 8.5 months. The percentage of one-year survivors
is in the order of approximately 20%. The disease is operable in about only 10% of patients after being diagnosed. This is largely
because pancreatic cancer shows no symptoms until it is at an advanced stage (stage 3 or 4) of development. However, over the past
few years, radiologic techniques have advanced to the point where some pancreatic cancers may be detectable somewhat sooner. A
new definition of “borderline operable” has been coined, and a greater number of pancreatic cancers are now being detected
when they are “locally advanced” rather than after they have metastasized and spread to other organs in the body.
Our goal is to satisfy a clear unmet medical
need for patients with LAPC whose tumors no longer respond after 4-6 months of treatment with the chemotherapy combination of Abraxane®
plus gemcitabine or FOLFIRINOX. For these patients, there is currently no effective therapy. We believe there will be no
therapy comparable to our Cell-in-a-Box® plus low dose of ifosfamide combination therapy when it is used in these
patients.
We face intense competition in the field
of treating pancreatic cancer. In addition to commercial entities such as Halozyme, Inc., OncoMed Pharmaceuticals, Inc., and Boston
Biomedical, Inc., to name a few of the smaller companies, several academic institutions and cancer centers are trying to improve
the outcome for pancreatic cancer patients. There are several drugs already available and in the pipelines of pharmaceutical companies
worldwide, not the least of which is the combination of the drugs of Abraxane® and gemcitabine. This is the primary
FDA-approved combination of drugs for treating advanced pancreatic cancer. In Europe, and more recently in the U.S., the 4-drug
combination known as FOLFIRINOX has also found use as a first-line treatment for advanced pancreatic cancer. Some of our competitive
strengths include the Orphan Drug Designation we have been granted by the FDA and the European Medicines Agency (“EMA”)
for our pancreatic cancer therapy, our trade secrets, the patents we are seeking and the licensing agreements we have that are
described in this Report. Yet many of our competitors have substantially greater financial and marketing resources than we do.
They also have stronger name recognition, better brand loyalty and long-standing relationships with customers and suppliers. Our
future success will be dependent upon our ability to compete.
We believe our therapy for pancreatic cancer
has already shown promise through the completion of a Phase 1/2 and a Phase 2 clinical trial in advanced, inoperable pancreatic
cancer. Our therapy for diabetes has also shown promise. Completed research studies have resulted in positive responses in animal
models using the Melligen cells. We believe we are in a strong competitive position considering our unique encapsulation technology
and the genetically modified cells that we have the exclusive worldwide license to use in most industrialized countries.
As discussed above in the section on cannabinoids,
PharmaCyte has several major competitors developing Cannabis-based therapies for cancer.
Previous Clinical Trials Using Our Encapsulation
Technology
Two previous clinical trials using what
is now our encapsulation technology were carried out in Europe in 1998-1999 and 2000, respectively. Both employed the combination
of the cellulose-based live cell encapsulation technology with low doses of the anticancer drug ifosfamide. The results of the
two clinical trials have appeared in the peer-reviewed scientific literature and are summarized as follows:
Phase 1/2 Clinical Trial
Dates of Trial and Location: This
clinical trial was opened on July 28, 1998 and closed on September 20, 1999. It was carried out at the Division of Gastroenterology,
University of Rostock, Germany.
Identity of Trial Sponsors: The
clinical trial was sponsored by Bavarian Nordic.
Trial Design: The clinical trial
was an open-label, prospective, single-arm and single center trial.
Patient Information: A total of
17 patients were enrolled in the clinical trial (51 were screened). A total of 14 patients were treated because two of the original
17 patients developed severe infections before the start of the clinical trial and had to be treated by other means. For the other
patient, angiography was not successful, causing the patient to be disqualified from participating in the clinical trial.
Trial Criteria: Criteria for enrolling
in the clinical trial included inoperable pancreatic adenocarcinoma Stage 3-4 (according to IUCC criteria) as determined by histology
and measured by computerized tomography (“CT”) scan and the patients must not have had any prior chemotherapy for their
disease.
Duration of Treatment and Dosage Information:
On day 0, celiac angiography was performed and 300 (in 13 patients, 250 in one) of the capsules containing the ifosfamide-activating
cells were placed by supraselective catheterization of an artery leading to the tumor. Each capsule (~0.7 mm in diameter) contained
about 20,000 cells. The cells overexpressed CYP2B1 (a cytochrome P450 isoform), which catalyzed the conversion of the anticancer
prodrug ifosfamide into its “cancer-killing” form.
On day 1, patients were monitored for evidence
of any clinically relevant adverse reactions, e.g. allergy and/or pancreatitis. On days 2-4, each patient received low-dose (1
g/m2 body surface area) ifosfamide in 250 ml of normal saline administered systemically as a 1-hour infusion. This was
accompanied by a 60% dose equivalent of the uroprotective drug Mesna, which is used to reduce the side effects of ifosfamide chemotherapy,
given as three intravenous injections. This regimen was repeated on days 23-25 for all but two patients who received only one round
of ifosfamide. A total of only two cycles of ifosfamide were given to the remainder of the patients.
Specific Clinical Endpoints: Median
survival time from the time of diagnosis, the percentage of patients who survived one year or more and the quality of life of each
patient were examined in the clinical trial.
Observational Metrics Utilized and Actual
Results Observed: Standard National Cancer Institute (“NCI”) criteria for evaluating tumor growth were used
to assess results:
| • | stable disease (tumors 50-125% of initial size) (“SD”); |
| • | partial remission (more than 50% reduction in tumor volume) (“PR”); and |
| • | minor response (tumor reduction of between 25% and 50%) (“MR”). |
Effects of the treatment on tumor size
were measured by CT scans. Control CT scans were scheduled for weeks 10 and 20, respectively. During the final visit a control
angiography was performed. On the initial CT scan, the scan demonstrating the largest diameter of the primary tumor was identified
and the area measured. Using appropriate landmarks, an identical scan was used for comparison. CT scans were evaluated by two unrelated
radiologists, one of whom was not involved in the clinical trial. After formally finishing the clinical trial, patients were followed
on an ambulatory basis with visits once every three months.
Toxicity was measured based on WHO/NCI
guidelines on common toxicity criteria. The WHO and the NCI use standardized classifications of the adverse events associated with
the use of cancer drugs. In cancer clinical trials, these are used to determine if a drug or treatment causes unwanted side effects
(“Adverse Events”) when used under specific conditions. For example, the most commonly used classification is known
as the “Common Terminology Criteria for Adverse Events” developed by the NCI in the U.S. Most clinical trials carried
out in the U.S. and the United Kingdom code their Adverse Event. This system consists of five grades. These are: 1 = mild; 2 =
moderate; 3 = severe; 4 = life-threatening; 5 = death. In the studies reported for Cell-in-a-Box® plus low-dose
ifosfamide combination in pancreatic cancer patients, the study investigators noted 11 Serious Adverse Events (“SAEs”)
in 7 patients, none of which were believed to be treatment-related.
Each patient’s need for pain medication
and the quality of life (“QOL”) was monitored using a questionnaire established for diseases of the pancreas. A QOL
questionnaire for cancer patients, QLQ-C30, had been validated in several languages, but the module for pancreatic cancer per
se was still under development at the time of the study with respect to reliability, sensibility against changes and multicultural
validation. Accordingly, a version of the core questionnaire and a German QOL scale (published in 1995) for pancreatic cancer patients
was used. QOL data were documented independently from safety and efficacy data by having patients complete an independent questionnaire.
Assessment of QOL data did not interfere with routine documentation of Adverse Events reported by the patients. QOL questionnaires
were analyzed according to the criteria developed by the European Organization for Research and Treatment of Cancer (“EORTC”).
As used in the description of the QOL results discussed in the published report of the Phase 1/2 trial of the Cell-in-a-Box®
plus low-dose ifosfamide combination in pancreatic cancer patients, the questionnaire was used to assess the QOL of patients undergoing
treatment. The QOL was analyzed in a similar manner to the way that a QOL questionnaire developed by the EORTC is usually analyzed.
This latter questionnaire is known as EORTC QLQ-C30. QOL data were available from the baseline evaluation for 14 patients and for
analysis of change for 8 patients.
A clinical benefit score based on variables,
including the “Karnofsky Score” and body weight, was determined. Pain and analgesic consumption were calculated from
the QOL questionnaires. The Karnofsky Score is a scale that is used to attempt to quantify a cancer patient’s general well-being
and activities of daily life. It is often used to judge the suitability of patients for inclusion into clinical trials. As a clinical
trial progresses, a patient’s Karnofsky Score can change. It is also used to assess a patient’s QOL as a clinical trial
progresses. The scale starts at 100 (normal, no complaints, no evidence of disease) and decreases in decrements of 10 down through
50 (requires considerable assistance and frequent medical care) all the way to 10 (moribund, fatal processes progressing rapidly)
and finally to 0 (deceased). Pain intensity was measured on a visual analog scale ranging from 0 (no pain) to 100 (the most intensive
pain imaginable) in increments of 10. Analgesic consumption was assessed using a separate scale in which 0 indicated no regular
consumption of analgesics and 25, 50 and 100 indicated administration of non-steroidal anti-inflammatory drugs or opiates several
times per year, per month or per week, respectively.
The primary tumor did not grow in any of
the 14 patients. Two patients had a PR; 12 patients exhibited SD; and two patients showed an MR.
Median survival time of patients in this
clinical trial was 39 weeks. The one-year survival rate was 36%.
Within the 20-week study period, three
patients died from disease progression (on days 9, 85 and 132). Upon postmortem examination, the patient who died on day 9 from
recurrent pulmonary embolism was found to have extensive tumor necrosis.
The chemotherapy regimen was well tolerated.
No toxicity beyond Grade 2 (moderate adverse effect) was detected in any of the 14 patients.
Eleven SAEs were seen in 7 patients during
the study period. None of them were treatment-related (due to capsule implantation or ifosfamide administration). These SAEs were
attributed to underlying disease and/or the effects associated with the disease.
Implanting the capsules did not result
in any obvious allergic or inflammatory response, and no patients developed pancreatitis during the trial. Some patients exhibited
elevated amylase levels, presumably due to tumor infiltration of the pancreas and limited obstructive chronic pancreatitis. However,
no further increase in amylase levels was seen after angiography and capsule implantation.
In accordance with the report of the study,
only one Adverse Event (increased lipase activity on day 15 after installation of the capsules), which was a Grade 1 Adverse Event,
“may” have been linked to implanting the capsules.
Ten of 14 patients experienced a “clinical
benefit” which means either no increase or a decrease in pain intensity. For 7 of the patients, this was confirmed by their
analgesic consumption. None of these “benefited” patients registered an increased analgesic usage either in terms of
dosage or WHO levels.
None of the patients showed an increased
Karnofsky Score after treatment. However, 7 of the 14 patients had stable Karnofsky Scores at the week 10 assessment. For 4 of
these patients, their indices were still stable at the week 20 assessment.
One patient’s body weight increased
at both weeks 10 and 20 and another patient showed increased weight at week 10 (this patient withdrew from the clinical trial and
no week 20 weight was obtained). Two patients showed stable body weights at week 10, one of whom dropped out of the clinical trial
and the other showed weight loss at week 20.
Two scenarios were used to establish the
overall integrative clinical benefit response, where each patient was given a +2 score for an improved value, a +1 score for a
stable value and a -1 score for a worsened value for each of four criteria (pain, analgesic consumption, Karnofsky Score and body
weight) as compared to the relevant week 0 values.
The “worst case scenario” required
a pain relief score of 20 points or more to be judged an improvement and a decrease in the Karnofsky Score of 10 points or more
to indicate worsening. Using this scenario, 50% or 7 of the treated patients experienced clinical benefit; 21.4% or 3 patients
were neutral (benefits were offset by impairments); and 28.6% or 4 patients had no clinical benefit. The latter included those
passing away before the median survival time.
In the “best case scenario,”
a pain relief score of 10 points or more was an improvement. A decrease in Karnofsky Score of 20 points or more was considered
a worsening. In this scenario, 71.4% or 10 patients had clinical benefit, 14.2% of patients showed neither benefit nor deterioration
and 14.3% patients had no benefit.
Standard of Care: At the time this
clinical trial was conducted, only one FDA-approved treatment for advanced, inoperable pancreatic cancer was available. That was
the drug gemcitabine, first approved by the FDA in 1996.
An examination of the prescribing information
for gemcitabine reflects that the median survival seen in the Phase 3 pancreatic cancer clinical trial for gemcitabine was approximately
23 weeks (5.7 months). The percentage of one-year survivors was approximately 18%. In a Phase 3 clinical trial of Celgene’s
Abraxane® plus gemcitabine combination that was approved by the FDA in September 2013, the median survival time
for patients was about 8.5 months and the percentage of one-year survivors was approximately 35%.
The treatment with gemcitabine of patients
with pancreatic cancer is often associated with severe side effects. According to the prescribing information for gemcitabine,
for use to treat pancreatic cancer the recommended dose is 1000 mg/m2 given intravenously over 30 minutes. The schedule
of administration is: weeks 1-8, weekly dosing for 7 weeks followed by one-week rest and then after week 8, weekly dosing on days
1, 8 and 15 of 28-day cycles.
Reductions in the doses of gemcitabine
are necessitated by the occurrence of myelosuppression. Permanent discontinuation of gemcitabine is necessary for any of the following:
| • | unexplained dyspnea or other evidence of severe pulmonary toxicity; |
| • | hemolytic-uremic syndrome; |
| • | capillary leak syndrome; and |
| • | posterior reversible encephalopathy syndrome. |
Gemcitabine should be withheld, or its
dose reduced by 50% for other severe (Grade 3 or 4) non-hematologic toxicity until that toxicity is resolved.
Conclusions: In the opinion of the
trial’s investigators, in this Phase 1/2 clinical trial the use of the combination of Cell-in-a-Box® capsules
plus low-dose ifosfamide was both safe and effective. This assessment was not based on the opinion of any drug regulatory authority
and does not guarantee that that this assessment will be maintained in any late-phase clinical trial or that any drug regulatory
authority will ultimately determine that the Cell-in-a-Box® plus low-dose ifosfamide combination is safe and effective
for the purposes of granting marketing approval.
In the Phase 1/2 clinical trial only a
small number of patients were evaluated. Statistical parameters were not used in the published reports of the Phase 1/2 trial to
validate the anticancer efficacy of the Cell-in-a-Box® plus low-dose ifosfamide combination in patients with advanced,
inoperable pancreatic cancer. In the opinion of the investigators, the results indicate a trend towards efficacy; accordingly,
the results should not be viewed as absolute numbers. It should be noted, however, that because the results were not statistically
significant, any observations of efficacy must be weighed against the possibility that the results were due to chance alone. The
purpose of the clinical trial was not to obtain data so that marketing approval could be obtained from regulatory authorities.
Rather, the clinical trial allowed the investigators to determine whether the Cell-in-a- Box® capsules plus low-dose
ifosfamide combination holds promise as a therapy for advanced pancreatic cancer. In the cancer arena, Phase 1/2 clinical trials
are used to: (i) establish the safety of the drug or treatment being investigated; and (ii) determine if a trend towards efficacy
exists. In accordance with FDA guidance, as well as similar guidance from other regulatory authorities in countries other than
the U.S., we realize that a large, multicenter, randomized, comparative study needs to be conducted and the results from such a
trial would have to confirm the results from this previous Phase 1/2 trial before an application for marketing approval could be
filed with the FDA or EMA. We are currently engaged in preparing an IND for submission to the FDA to conduct a new clinical trial.
If our cancer therapy is approved by the
regulatory agencies, we believe it could provide a significant benefit to those with this devastating and deadly disease, not only
in terms of life-span but also in terms of increased quality of life. Also, we believe that success of the live cell encapsulation
technology in the pancreatic cancer setting may lead to its successful use in developing therapies for other forms of solid cancerous
tumors after preclinical studies and clinical trials have been completed.
Phase 2 Clinical Trial
Location of Trial: The clinical
trial was opened on November 16, 1999 and closed on December 1, 2000. This clinical trial was carried out at four centers in two
countries in Europe. These were in Berne, Switzerland, and in Rostock, Munich and Berlin, Germany.
Trial Sponsor: The clinical trial
was sponsored by Bavarian Nordic.
Trial Design: This was an open-label,
prospective, single-arm multi-site study.
Patient Information: All 13 patients
enrolled in the trial were treated. Twelve patients exhibited Stage 4 disease. The remaining patient had Stage 3 disease. Ten of
the 13 patients exhibited metastases.
Duration of Treatment and Dosage Information:
The number of capsules implanted varied from 221 to 300 with a mean of 244. On day 1, patients were monitored for any allergic
reactions to capsule implantation and/or pancreatitis. The administration schedule of the treatment was the same as in the earlier
Phase 1/2 trial, except that in this Phase 2 trial the dose of ifosfamide was doubled to 2 g/m2. In the Phase1/2 trial,
it was 1g/m2. On days 2-4, patients received 2 g/m2 in normal saline as a one-hour infusion. The urinary
tract protector Mesna was also given as 3 intravenous injections. This regimen was repeated on days 23-25.
Specific Clinical Endpoints: The
primary endpoint of the trial was to determine response rate as defined by SD, PR and MR as well as the clinical benefit (Karnofsky
score) of the treatment. The timing of the tumor size measurements and determination of tumor sizes by CT scans were done by independent
radiologists. A secondary endpoint was to determine time to progression, tumor response, duration of partial or complete remission,
length of symptom-free survival, survival time and quality of life. Another secondary endpoint was to evaluate the safety and tolerability
of the treatment regimen, with attention being paid to the appearance of pancreatitis or immediate allergic reactions.
Safety Analysis of Angiography, Capsule
Implantation and Chemotherapy: On average, angiography took approximately 40 minutes. For 5 of the patients in this clinical
trial, more than one blood vessel had to be used for placement of the capsules. The administration of the capsules was well tolerated.
There were no signs of allergic reactions or hemorrhagic cystitis after implantation of the capsules. Two patients had increased
levels of serum lipase at baseline. After additional measurements, these were not considered to be clinically relevant. The dose
of ifosfamide (2 g/m2) used was found to be toxic in most patients. This resulted in one patient having to reduce the
ifosfamide dose in the second of the two cycles of treatment with the drug. The most common toxic effects were nausea, vomiting,
malaise, anorexia and mild hematuria.
Serious Adverse Events: A total
of 16 SAEs were documented in eight patients, including 3 SAEs leading to death. None of these SAEs were attributed to placement
of the encapsulated cells. One patient experienced neurological impairment (drowsiness, nocturnal enuresis, mild somnolence) which
was attributed to treatment with the 2 g/m2 dose of ifosfamide. All patients experienced between 5 and 19 SAEs. Six
SAEs were rated as life-threatening; 10.2% were rated as severe; 28.7% were rated as moderate; and 53.7% were rated as mild. None
of the SAEs was thought to be related to placement of the encapsulated cells, but 44% were related to the administration of ifosfamide
at the elevated dose given. Most frequent SAEs were alopecia, anemia, leucopenia, nausea and vomiting or encephalopathy. Other
SAEs were new or worse symptoms of the patients’ underlying disease. A total of 65 events met the NCI’s common toxicity
criteria. Of these, 46.2% had Grade 1, 40% had Grade 2, 9.2% had Grade 3 and 4.6% had Grade 4 toxicities.
Tumor Reductions and Patient Survival
Results: The size of the primary tumor was measured before starting the live cell encapsulation plus ifosfamide therapy and
at weeks 10 and 20 post-treatment. No PRs were observed, but 4 patients exhibited tumor size reductions, 4 patients showed tumor
growth and the remaining 5 patients had SD over the “follow-up” period after chemotherapy.
The median survival of patients was 40
weeks. Most the survival benefit was shown early during the entire observation period. However, as time progressed, these patients
succumbed at the same rate as historical controls. This observation suggested to the investigators that prolongation of the survival
benefit might be achieved if additional courses of ifosfamide chemotherapy were given. The one-year survival rate was 23%. It was
thought that this may be attributable to the higher dose of ifosfamide used in this clinical trial.
Quality of Life: An assessment of
the quality of life of the patients was performed in this clinical trial. Quality of life data were available for all the patients.
According to this quality of life assessment, although pain during the night decreased, patients felt themselves to be less attractive
and lost interest in sex. No additional improvements in patients’ quality of life were observed.
Conclusions: The opinions of the
investigators were as follows: (i) the lack of “problems” associated with the implanted encapsulated cells was noted
as in the Phase 1/2 trial; (ii) administering more than two courses of treatment with ifosfamide might have beneficial effects
on survival; and (iii) since doubling the dose of ifosfamide from that used in the Phase 1/2 trial had no beneficial antitumor
or survival effect but was associated with increased side effects from the treatment, the dose of ifosfamide to be used in combination
with the encapsulated cells for all future trials should be 1 g/m2.
Manufacturing
We are outsourcing all cell growth, processing
and encapsulation services needed for our future clinical trials of the encapsulated cell-based cancer and diabetes therapies.
The Cell-in-a-Box® encapsulation will be done by Austrianova at its cGMP-compliant manufacturing facility in Bangkok,
Thailand.
We initially engaged ViruSure GmbH (“ViruSure”),
a professional cell growing and adventitious agent testing company that has had extensive experience with the CYP2B1-expressing
cancer prodrug-activating cells that will be needed for our pancreatic cancer therapy. We did so to recover them from frozen stocks
of similar cells developed by Bavarian Nordic and regenerate new stocks for use by us in our preclinical studies and clinical trials.
ViruSure cloned new cells from one selected clone. We planned to use the clones to populate a Master Cell Bank (“MCB”)
and a Working Cell Bank (“WCB”) for our future clinical trials.
In March 2014, we entered a Manufacturing
Framework Agreement with Austrianova (“Manufacturing Framework Agreement”) pursuant to which Austrianova will encapsulate
the genetically engineered live cells that will be used for our cancer therapy. We have also contracted with Austrianova to provide
encapsulated insulin-producing cells for our preclinical studies in diabetes. At the appropriate time, we intend to enter into
a similar manufacturing framework agreement with Austrianova for the encapsulated cells we will need for our diabetes therapy.
In April 2014, we entered an agreement
with ViruSure pursuant to which ViruSure agreed to clone cells from the 22P1G cell line (the cells that express the CYP2B1 isoform
of cytochrome P450 that converts ifosfamide into its cancer-killing form). In August 2014, we entered into a revised proposal with
ViruSure pursuant to which ViruSure modified certain testing recommendations and cell banking procedures. ViruSure was engaged
in the process of cloning cells for some time and conducted various tests of the cells it had grown for us.
In June 2017, we entered into an agreement
with Eurofins for the preparation and characterization of a cGMP quality MCB for use in our therapy for pancreatic cancer. The
agreement includes pre-bank testing, MCB preparation, MCB characterization, Working Cell Bank (“WCB”) preparation,
WCB characterization, end of production characterization and related analyses, as well as optional testing. The MCB was initially
planned to be used as a “safe” repository of the cloned cells that we would use in our cancer therapy. The WCB was
planned to be used to supply the large numbers of cells needed for our preclinical studies, clinical trials and other purposes
related to the development of our therapy for LAPC and other forms of solid tumor cancers.
In January 2018, we modified our agreement
with Eurofins to exclude the WCB preparation and characterization, as well as the end of production characterization and related
analysis. We did so to expedite the availability of the cells needed for encapsulation by Austrianova to conduct our planned clinical
trial in LAPC and to save the costs.
Pursuant to the terms of the Austrianova
MOU, Austrianova and we have agreed to negotiate a new Manufacturing Framework Agreement pursuant to which Austrianova will provide
us with Phase 3 clinical material utilizing the genetically engineered cells designed to activate ifosfamide that have been encapsulated
using the Cell-in-a-Box® technology to conduct a late phase clinical trial in the U.S. with possible study sites
in Europe.
Government Regulation and Product Approval
As a development stage biotechnology company
that operates in the U.S., we are subject to extensive regulation by the FDA and other federal, state, and local regulatory agencies.
The federal Food, Drug, and Cosmetic Act (“FDCA”) and its implementing regulations set forth, among other things, requirements
for the research, testing, development, manufacture, quality control, safety, effectiveness, approval, labeling, storage, record
keeping, reporting, distribution, import, export, advertising and promotion of our product candidates. Although the discussion
below focuses on regulation in the U.S., we anticipate seeking approval for, and marketing of, our product candidates in other
countries. Generally, our activities in other countries will also be the subject of extensive regulation, although there can be
important differences with the U.S. The process of obtaining regulatory marketing approvals and the subsequent compliance with
appropriate federal, state, local and foreign statutes and regulations will require the expenditure of substantial time and financial
resources and may not be successful.
Regulatory approval, when obtained, may
be limited in scope which may significantly limit the uses for which a product may be placed into the market. Further, approved
drugs or biologic products, as well as their manufacturers, are subject to ongoing post-marketing review, inspection and discovery
of previously unknown problems with such products or the manufacturing or quality control procedures used in their production.
These may result in restrictions on their manufacture, sale or use or in their withdrawal from the market. Any failure or delay
by us, our suppliers of manufactured drug product, collaborators or licensees in obtaining regulatory approvals could adversely
affect the marketing of our product candidates and our ability to receive product revenue, license revenue or profit-sharing payments.
For more information, see Item 1A. “Risk Factors.”
U.S. Government Regulation
The FDA is the main regulatory body that
controls pharmaceuticals and biologics in the U.S. Its regulatory authority is based in the FDCA and the Public Health Service
Act (“PHSA”). Pharmaceutical products and biologics are also subject to other federal, state and local statutes. A
failure to comply explicitly with any requirements during the product development, approval, or post-approval periods, may lead
to administrative or judicial sanctions. These sanctions could include the imposition by the FDA or by an Institutional Review
Board (“IRB”) of a hold on clinical trials, refusal to approve pending marketing applications or supplements, withdrawal
of approval, warning letters, product recalls, product seizures, total or partial suspension of production or distribution, injunctions,
fines, civil penalties or criminal prosecution.
The steps required before a new drug or
biologic may be marketed in the U.S. generally include:
| • | completion of preclinical studies and formulation studies in compliance with the FDA’s Good
Laboratory Practices (“GLP”) protocols and regulations; |
| • | satisfactory completion of an FDA inspection of the manufacturing facilities at which the investigational
product candidate is produced to assess compliance with cGMP and proof that the facilities, methods and controls are adequate; |
| • | submission to the FDA of an IND to support human clinical testing in the U.S.; |
| • | approval by an IRB at each clinical site before a trial may be initiated at that site; |
| • | performance of adequate and well-controlled clinical trials in accordance with federal regulations
and with Good Clinical Practices (“GCPs”) standards to establish the safety and efficacy of the investigational product
candidate for each target indication; |
| • | Submission to the FDA of a New Drug Application (“NDA”) for a drug or Biologics
License Application (“BLA”) for a biologic such as the therapies we are developing; |
| • | satisfactory completion of an FDA Advisory Committee review, if applicable; and |
FDA review and approval of the NDA or BLA.
Clinical Development
Before a drug or biologic product may be
given to humans, it must undergo preclinical testing. Preclinical tests include laboratory evaluation of a product candidate’s
chemical and biological activities and animal studies to assess potential safety and efficacy in humans. The results of these studies
must be submitted to the FDA as part of an IND which must be reviewed by the FDA for safety and other considerations before even
an initial (Phase 1) clinical trial in humans can begin.
An IND is a request for authorization from
the FDA to administer an investigational product candidate to humans. This authorization is required before interstate shipping
and administration can commence of any new drug or biologic product destined for use in humans in the U.S. A 30-day
waiting period after the submission of each IND is required before commencement of clinical testing in humans. If the FDA has neither
commented on nor questioned the IND within this 30-day period after submission of the IND, the clinical trial proposed in the IND
may begin. A clinical trial involves the administration of the investigational product candidate to patients under the supervision
of qualified investigators following GCP standards. These international standards are meant to protect the rights and health of
patients and to define the roles of clinical trial sponsors, administrators and monitors. A clinical trial is conducted under protocols
that detail the parameters to be used in monitoring safety, and the efficacy criteria to be evaluated. Each protocol involving
testing on U.S. patients and subsequent protocol amendments must be submitted to the FDA as part of the IND.
We devote significant resources to research
and development programs to discover and develop potential future product candidates. The product candidates in our pipeline are
at various stages of preclinical and clinical development. The path to regulatory approval includes three phases of clinical trials
in which we collect data to support an application to regulatory agencies to allow us to ultimately market a product for treatment
of a specified disease. There are many difficulties and uncertainties inherent in research and development of new products, and
these can conceivably result in a high rate of failure. To bring a drug from the discovery phase to regulatory approval, and ultimately
to market, takes years and the costs to do so are significant. Failure can occur at any point in the process, including after the
product is approved, based on post-marketing factors. New product candidates that appear promising in development may fail to reach
the market or may have only limited commercial success because of efficacy or safety concerns, inability to obtain necessary regulatory
approvals, limited scope of approved uses, reimbursement challenges, difficulty or excessive costs of manufacture, alternative
therapies or infringement of the patents or intellectual property rights of others. Uncertainties in the approval process of the
regulatory agencies can result in delays in product launches and lost market opportunities. Consequently, it is very difficult
to predict which products will ultimately be submitted for approval, which have the highest likelihood of obtaining approval and
which will be commercially viable and generate profits. Successful results in preclinical or clinical studies may not be an accurate
predictor of the ultimate safety or effectiveness of a product candidate.
Phase 1 Clinical Trial: A Phase 1
clinical trial begins when a regulatory agency, such as the FDA, allows initiation of the clinical investigation of a new product
candidate. The clinical trial studies a product candidate’s safety profile and may include a preliminary determination of
a product candidate’s safe dosage range. The Phase 1 clinical trial can also determine how a drug is absorbed, distributed,
metabolized and excreted by the body and, therefore, the potential duration of its action.
Phase 2 Clinical Trial: A Phase 2
clinical trial is conducted on a limited number of patients; these patients can have a specific targeted disease. An initial evaluation
of the product candidate’s effectiveness on patients is performed. Additional information on the product candidate’s
safety and dosage range is obtained. For many diseases, a Phase 2 clinical trial can include up to several hundred patients.
Phase 3 Clinical Trial: A Phase 3
clinical trial is typically rigorously controlled, conducted in multiple centers and involves a larger target patient population
that can consist of from several hundred to thousands of patients (depending on the disease being studied) to ensure that study
results are statistically significant. During a Phase 3 clinical trial, physicians monitor patients to determine efficacy
and to gather further information on safety. A Phase 3 clinical trial is designed to generate all the clinical data necessary to
apply for marketing approval to a regulatory agency.
The decision to terminate development of
an investigational product candidate may be made by either a health authority body, such as the FDA, by IRB/ethics committees,
or by a company for various reasons. The FDA may order the temporary or permanent discontinuation of a clinical trial at any time,
or impose other sanctions, if it believes that the clinical trial either is not being conducted in accordance with FDA requirements
or presents an unacceptable risk to the patients enrolled in the trial. In some cases, a clinical trial is overseen by an independent
group of qualified experts organized by the trial sponsor, or the clinical monitoring board. This group provides authorization
for whether a trial may move forward at designated checkpoints. These decisions are based on the limited access to data from the
ongoing trial. The suspension or termination of development can occur during any phase of a clinical trial if it is determined
that the patients are being exposed to an unacceptable health risk. There are also requirements for the registration of an ongoing
clinical trial of a product candidate on public registries and the disclosure of certain information pertaining to the trial, as
well as clinical trial results after completion.
A sponsor may be able to request a special
protocol assessment (“SPA”), the purpose of which is to reach agreement with the FDA on the Phase 3 clinical trial
protocol design and analysis that will form the primary basis of an efficacy claim. A sponsor meeting the regulatory criteria may
make a specific request for a SPA and provide information regarding the design and size of the proposed clinical trial. A SPA request
must be made before the proposed trial begins. All open issues must be resolved before the trial begins. If a written agreement
is reached, it will be documented and made part of the record. The agreement will be binding on the FDA and may not be changed
by the sponsor or the FDA after the trial begins, except with the written agreement of the sponsor and the FDA or if the FDA determines
that a substantial scientific issue essential to determining the safety or efficacy of the product candidate was identified after
the testing began. A SPA is not binding if new circumstances arise, and there is no guarantee that a study will ultimately be adequate
to support an approval even if the study is subject to a SPA. Having a SPA does not guarantee that a product candidate will receive
FDA approval.
Assuming successful completion of all required
testing in accordance with all applicable regulatory requirements, detailed investigational product candidate information is submitted
to the FDA in the form of an NDA or BLA to request regulatory approval for the product in the specified indications.
New Drug Applications and Biologic Licensing
Applications
To obtain approval to market a drug or
biologic in the U.S., a marketing application must be submitted to the FDA that provides data establishing the safety and effectiveness
of the product candidate for the proposed indication. The application includes all relevant data available from pertinent preclinical
studies and clinical trials, including negative or ambiguous results as well as positive findings, together with detailed information
relating to the product’s chemistry, manufacturing and controls, as well as the proposed labeling for the product, among
other things. Data can come from company-sponsored clinical trials intended to test the safety and effectiveness of a product,
or from several alternative sources, including studies initiated by investigators. To support marketing approval, the data submitted
must be sufficient in quality and quantity to establish the safety and effectiveness of the investigational product candidate to
the satisfaction of the FDA.
In most cases, the NDA, in the case of
a drug, or BLA, in the case of a biologic, must be accompanied by a substantial user fee. There may be some instances in which
the user fee is waived. The FDA will initially review the NDA or BLA for completeness before it accepts the application for filing.
The FDA has 60 days from its receipt of an NDA or BLA to determine whether the application will be accepted for filing based
on the agency’s threshold determination that it is sufficiently complete to permit substantive review. After the NDA or BLA
submission is accepted for filing, the FDA begins an in-depth review. The FDA has agreed to certain performance goals in the review
of NDAs and BLAs. During a normal review cycle, a product is given an FDA action or Prescription
Drug User Fee Act (“PDUFA”) date within 12 months of the submission, if the submission is accepted. The FDA
can extend this review by three months to consider certain late-submitted information or information intended to clarify information
already provided in the submission. The FDA may also issue a complete response, which may delay approval for several months or
even years. The FDA reviews the NDA or BLA to determine, among other things, whether the proposed product is safe and effective
for its intended use, and whether the product is being manufactured in accordance with cGMP standards. The FDA may refer applications
for novel product candidates which present difficult questions of safety or efficacy to an advisory committee. This is typically
a panel that includes clinicians and other experts for review, evaluation and a recommendation as to whether the application should
be approved and under what conditions. The FDA is not bound by the recommendations of an advisory committee, but it considers such
recommendations carefully when making decisions.
Before approving a NDA or a BLA, the FDA
will inspect the facilities at which the product is manufactured. The FDA will not approve the product candidate unless it determines
that the manufacturing processes and facilities follow cGMP requirements and are adequate to assure consistent production of the
product within required specifications. Also, before approving an NDA or BLA, the FDA will typically inspect one or more clinical
sites to assure compliance with cGMP standards. Manufacturers of human cellular or tissue-based biologics also must comply with
the FDA’s Good Tissue Practices (“GTPs”), as applicable, and with the general biological product standards. After
the FDA evaluates the NDA or BLA and the sponsor company’s manufacturing facilities, it issues either an approval letter
or a complete response letter. A complete response letter generally outlines the deficiencies in the submission and may require
substantial additional testing or information for the FDA to reconsider the application. If, or when, those deficiencies have been
addressed to the FDA’s satisfaction in a resubmission of the NDA or BLA, the FDA will issue an approval letter. Notwithstanding
the submission of any requested additional information, the FDA ultimately may decide that the application does not satisfy the
regulatory criteria for approval.
An approval letter authorizes commercial
marketing of the product with specific prescribing information for specific indications. As a condition of NDA or BLA approval,
the FDA may require risk evaluation and mitigation strategies (“REMS”) to help ensure that the benefits of the product
outweigh the potential risks. REMS can include medication guides, communication plans for healthcare professionals, and elements
to assure safe use (“ETASU”). ETASU can include, but are not limited to, special training or certification for prescribing
or dispensing, dispensing only under certain circumstances, special monitoring and the use of patient registries. The requirement
for REMS can materially affect the potential market and profitability of the product. Moreover, product approval may require substantial
post-approval testing and surveillance to monitor the drug’s safety or efficacy. Once granted, product approvals may be withdrawn
if compliance with regulatory standards is not maintained or problems are identified following initial marketing.
Changes to some of the conditions established
in an approved application, including changes in indications, labeling, or manufacturing processes or facilities, require submission
and FDA approval of a new NDA/BLA or a NDA/BLA supplement before the change can be implemented. An NDA or BLA supplement for a
new indication typically requires clinical data like that in the original application, and the FDA uses the same procedures and
actions in reviewing NDA or BLA supplements as it does in reviewing NDAs or BLAs.
Disclosure of Clinical Trial Information
A sponsor of a clinical trial of certain
FDA-regulated products, including prescription drugs and biologics, is required to register and disclose certain clinical trial
information on a public website. Information related to the product, patient population, phase of investigation, study sites and
investigator involved, and other aspects of the clinical trial are made public as part of the registration. A sponsor is also obligated
to disclose the results of a clinical trial after completion. Disclosure of the results can be delayed until the product or new
indication being studied has been approved. Competitors may use this publicly-available information to gain knowledge regarding
the design and progress of our development programs.
Advertising and Promotion
The FDA and other federal regulatory agencies
closely regulate the marketing and promotion of drugs and biologics through, among other things, standards and regulations for
direct-to-consumer advertising, communications regarding unapproved uses, industry-sponsored scientific and educational activities,
and promotional activities involving the internet. A product cannot be commercially promoted before it is approved. After approval,
product promotion can include only those claims relating to safety and effectiveness that are consistent with the labeling approved
by the FDA. Healthcare providers are permitted to prescribe drugs or biologics for “off-label” uses (uses not approved
by the FDA and therefore not described in the drug’s labeling) because the FDA does not regulate the practice of medicine.
However, FDA regulations impose stringent restrictions on manufacturers’ communications regarding off-label uses. Broadly
speaking, a manufacturer may not promote a product for off-label use, but may engage in non-promotional, balanced communication
regarding off-label use under specified conditions. Failure to comply with applicable FDA requirements and restrictions in this
area may subject a company to adverse publicity and enforcement action by the FDA, the U.S. Department of Justice (“DOJ”),
the Office of the Inspector General of Health & Human Services (“HHS”) and state authorities. This could subject
a company to a range of penalties that could have a significant commercial impact, including civil and criminal fines and/or agreements
that materially restrict the manner in which a company promotes or distributes drug products.
Post Approval Regulations
After regulatory approval of a drug or
biologic is obtained, a company is required to comply with certain post-approval requirements. For example, as a condition of approval
of an NDA or BLA, the FDA may require post-marketing testing, including a Phase 4 clinical trial and surveillance to further
assess and monitor the product’s safety and effectiveness after commercialization has begun. Also, as a holder of an approved
NDA or BLA, a company is required to: (i) report adverse reactions and production problems to the FDA; (ii) provide updated safety
and efficacy information; and (iii) comply with requirements concerning advertising and promotional labeling for any of its products.
Also, quality control and manufacturing procedures must continue to conform to cGMP standards after approval to assure and preserve
the long-term stability of the drug or biological product. The FDA periodically inspects manufacturing facilities to assess compliance
with cGMP standards, which imposes extensive procedural and substantive record keeping requirements. Also, changes to the manufacturing
process are strictly regulated, and, depending on the significance of the change, may require prior FDA approval before being implemented.
In addition, FDA regulations require investigation and correction of any deviations from cGMP standards and impose reporting and
documentation requirements upon a company and any third-party manufacturers that a company may decide to use. Manufacturers must
continue to expend time, money and effort in production and quality control to maintain compliance with cGMP standards and other
aspects of regulatory compliance.
U.S. Patent Extension and Marketing
Exclusivity
The Biologics Price Competition and Innovation
Act (“BPCIA”) amended the PHSA to authorize the FDA to approve similar versions of innovative biologics, commonly known
as biosimilars. A competitor seeking approval of a biosimilar must file an application to establish its product as highly like
an approved innovator biologic, among other requirements. The BPCIA bars the FDA from approving biosimilar applications for 12
years after an innovator biological product receives initial marketing approval.
Depending upon the timing, duration and
specifics of the FDA approval of the use of our product candidates, some of our U.S. patents, if granted, may be eligible for limited
patent term extension under the Drug Price Competition and Patent Term Restoration Act of 1984 (“Hatch-Waxman Act”).
The Hatch-Waxman Act permits a patent extension term of up to five years, as compensation for patent term lost during product development
and the FDA regulatory review process. However, patent term extension cannot extend the remaining term of a patent beyond a total
of 14 years from the product’s approval date. The length of the patent term extension is related to the length of time the
drug, biologic or medical device is under regulatory review. It is calculated as half of the testing phase (the time between the
IND submission becoming effective and the NDA, BLA or premarket approval (“PMA”) submission) and all the review phase
(the time between NDA, BLA or PMA submission and approval) up to a maximum extension of five years. The time can be shortened if
the FDA determines that the applicant did not pursue approval with due diligence. Only one patent applicable to an approved product
is eligible for the extension and the application for the extension must be submitted prior to the expiration of the patent. The
U.S. Patent and Trademark Office (“USPTO”), in consultation with the FDA, reviews and approves the application for
any patent term extension. Similar provisions are available in Europe and other foreign jurisdictions to extend the term of a patent
that covers an approved drug, biologic or medical device. In the future, if any of our product candidates receive FDA approval,
we expect to apply for patent term extension on patents covering those products that may be eligible for such patent term restoration.
Foreign Corrupt Practices Act
The Foreign Corrupt Practices Act (“FCPA”)
prohibits any U.S. individual or business from paying, offering, or authorizing payment or offering of anything of value, directly
or indirectly, to any foreign official, political party or candidate for influencing any act or decision of the foreign entity
to assist the individual or business in obtaining or retaining business. The FCPA also obligates companies whose securities are
listed in the U.S. to comply with accounting provisions requiring such companies to maintain books and records that accurately
and fairly reflect all transactions of the corporation, including international subsidiaries, and to devise and maintain an adequate
system of internal accounting controls for international operations.
European and Other International Government
Regulation
In addition to regulations in the U.S.,
we will be subject to a variety of regulations in other jurisdictions governing, among other things, clinical trials and any commercial
sales and distribution of our product candidates. Whether or not we obtain FDA approval for a product, we must obtain the requisite
approvals from regulatory authorities in foreign countries prior to the commencement of clinical trials or marketing of the product
in those countries. Some countries outside of the U.S. have a similar process to that of the FDA in that such countries require
the submission of a clinical trial application (“CTA”) much like the IND prior to the commencement of human clinical
trials. In Europe, for example, a CTA must be submitted to each country’s national health authority and an independent ethics
committee, much like the FDA and an IRB. Once the CTA is approved in accordance with a country’s requirements, a clinical
trial may proceed in that particular country.
To obtain regulatory approval to commercialize
a new drug or biologic under the E.U. regulatory systems, we must submit a marketing authorization application (“MAA”)
with the EMA, the E.U.’s counterpart to the U.S. FDA. It is like the NDA or the BLA, except for, among other things, country-specific
document requirements.
Outside of the E.U. the requirements governing
the conduct of clinical trials, product licensing, pricing and reimbursement vary from country to country. Internationally, clinical
trials are generally required to be conducted in accordance with cGMP standards - applicable regulatory requirements of each jurisdiction
and the medical ethics principles that have their origin in the Declaration of Helsinki.
Regulatory Review
If a product candidate successfully completes
a Phase 3 clinical trial and is submitted to regulatory agencies, such as the FDA in the U.S. and the EMA in Europe, the time
to final marketing approval can vary from months to years, depending on several variables. These variables can include such things
as the disease type, the strength and complexity of the data presented, the novelty of the target or compound, risk-management
approval and whether multiple rounds of review are required for the agency to evaluate the submission. There is no guarantee that
a potential treatment will receive marketing approval or that decisions on marketing approvals or treatment indications will be
consistent across geographic areas. In some cases, further studies beyond the three-phase clinical trial process described above
are required as a condition for approval of a NDA, a MAA or a BLA. Each country-specific regulatory agency requires monitoring
of all aspects of a clinical trial and reporting all adverse events in the trial. A regulatory agency may also require the conduct
of pediatric studies for the product and indication either before or after submission of a NDA or a BLA.
Approval by Regulatory Agencies
The results of the preclinical testing,
production parameters and a clinical trial are submitted to the regulatory agency as part of a NDA, a MAA or a BLA for evaluation
to determine if there is substantial evidence that the product is sufficiently safe and effective to warrant approval. In responding
to a NDA, a MAA or a BLA, the regulatory agency may grant market approval, deny approval or request additional information.
Compliance
During all phases of development (pre-
and post-marketing), failure to comply with applicable regulatory requirements may result in administrative or judicial sanctions.
These sanctions could include the FDA’s imposition of a clinical hold on a trial, refusal to approve pending applications,
withdrawal of an approval, warning letters, product recalls, product seizures, total or partial suspension of production or distribution,
product detention or refusal to permit the import or export of products, injunctions, fines, civil penalties or criminal prosecution.
Any agency or judicial enforcement action could have a material adverse effect on us.
Special Regulatory Procedures
The FDA has developed distinct approaches
to make new drugs and biologics available as rapidly as possible in cases where there is no available treatment or there are advantages
over existing treatments. For example, the FDA may grant “Accelerated Approval” to products that have been studied
for their safety and effectiveness in treating serious or life-threatening illnesses and that provide meaningful therapeutic benefit
to patients over existing treatments. For Accelerated Approval, the product must influence a surrogate endpoint or an intermediate
clinical endpoint that is considered reasonably likely to predict the clinical benefit of a product candidate, such as an effect
on irreversible morbidity and mortality. When approval is based on surrogate endpoints or clinical endpoints, other than survival
or morbidity, the sponsor will be required to conduct additional post-approval clinical studies to verify and describe clinical
benefit. These studies are known in as confirmatory trials. Accelerated Approval of a product may be withdrawn, or the labeled
indication of the drug changed if these trials fail to verify clinical benefit or do not demonstrate sufficient clinical benefit
to justify the risks associated with the product candidate.
The FDA may grant “Fast Track”
status to products that treat serious diseases or conditions and fill an unmet medical need. Fast Track is a process designed to
facilitate the development and expedite the review of such products by providing, among other things, more frequent meetings with
the FDA to discuss the product’s development plan, more frequent written correspondence from the FDA about trial design,
eligibility for Accelerated Approval if relevant criteria are met and rolling review, which allows submission of individually completed
sections of a NDA or a BLA for regulatory agency review before the entire submission is completed. Fast Track status does not ensure
that a product will be developed more quickly or receive regulatory agency approval.
The FDA’s “Breakthrough Therapy”
designation for a product candidate is designed to expedite the development and review of drugs and biologics that are intended
to treat a serious condition and preliminary clinical evidence indicates that the product candidate may demonstrate substantial
improvement over available therapies in terms of a clinically significant endpoint. For drugs and biologics that have been designated
as Breakthrough Therapies, robust FDA-sponsor interaction and communication can help to identify the most efficient and expeditious
path for clinical development while minimizing the number of patients placed in ineffective “control” regimens.
The FDA may grant “Priority Review”
status to product candidates that, if approved, would provide significant improvement in the safety or effectiveness of the treatment,
diagnosis or prevention of serious conditions. Priority Review is intended to reduce the time it takes for the FDA to review a
NDA or a BLA, with the goal to act on the application within six months.
Orphan Drug Status
In accordance with laws and regulations
pertaining to regulatory agencies, a sponsor may request that the regulatory agencies designate a drug or biologic intended to
treat a “Rare Disease or Condition” as an “Orphan Drug.” For example, in the U.S., a “Rare Disease
or Condition” is defined as one which affects less than 200,000 people in the U.S., or which affects more than 200,000 people
but for which the cost of developing and making available the product is not expected to be recovered from sales of the product
in the U.S. Upon the approval of the first NDA or BLA for a drug or biologic designated as an Orphan Drug for a specified indication,
the sponsor of that NDA or BLA is entitled to 7 years of exclusive marketing rights in the U.S. for the drug or biologic for the
particular indication unless the sponsor cannot assure the availability of sufficient quantities to meet the needs of persons with
the disease. In Europe, this exclusivity is 10 years. However, Orphan Drug status for an approved indication does not prevent another
company from seeking approval of a drug that has other labeled indications that are not under orphan or other exclusivities. An
Orphan Drug may also be eligible for federal income tax credits for costs associated with the disease state, the strength and complexity
of the data presented, the novelty of the target or compound, the risk-management approval and whether multiple rounds of review
are required for the agency to evaluate the submission. There is no guarantee that a potential treatment will receive marketing
approval or that decisions on marketing approvals or treatment indications will be consistent across geographic areas.
Priority Review and Accelerated Review
Based on results of a Phase 3 clinical
trial submitted in a NDA or a BLA, upon the request of an applicant, a priority review designation may be granted to a product
by the FDA, which sets the target date for FDA action on the application at six months from the FDA’s decision on priority
review application, or eight months from the NDA filing. Priority review is given where preliminary estimates indicate that a product,
if approved, has the potential to provide a safe and effective therapy where no satisfactory alternative therapy exists, or a significant
improvement compared to marketed products is possible. If criteria are not met for priority review, the standard FDA review period
is ten months from the FDA’s decision on priority review application, or 12 months from the NDA or BLA filing. Priority
review designation does not change the scientific/medical standard for approval or the quality of evidence necessary to support
approval.
Under a centralized procedure in the European
Union, the maximum timeframe for the evaluation of a MAA is 210 days (excluding “clock stops,” when additional
written or oral information is to be provided by the applicant in response to questions asked by the Committee for Medicinal Products
for Human Use (“CHMP”)). Accelerated evaluation might be granted by the CHMP in exceptional cases, for example, when
a medicinal product is expected to be of a major public health interest, which takes into consideration: (i) the seriousness of
the disease (e.g., heavy disabling or life-threatening diseases) to be treated; (ii) the absence or insufficiency of an appropriate
alternative therapeutic approach; and (iii) anticipation of high therapeutic benefit. In this circumstance, the EMA ensures that
the opinion of the CHMP is given within 150 days.
Healthcare Reform
In March 2010, former President Obama signed
into law the Patient Protection and Affordable Care Act, as amended by the Health Care and Education Reconciliation Act of 2010
(collectively, “Affordable Care Act”). The Affordable Care Act substantially changes the way healthcare will be delivered
and financed by both governmental and private insurers and significantly impacts the pharmaceutical and biotechnology industries.
The Affordable Care Act is a sweeping law intended to broaden access to health insurance, reduce or constrain the growth of healthcare
spending, enhance remedies against fraud and abuse, add new transparency requirements for healthcare and health insurance industries,
impose new taxes and fees on the health industry and impose additional health policy reforms. Among the Affordable Care Act’s
provisions of importance to the pharmaceutical industry are the following:
| • | an annual, nondeductible fee on any covered entity engaged in manufacturing or importing certain
branded prescription drugs and biological products, apportioned among such entities in accordance with their respective market
share in certain government healthcare programs; |
| • | an increase in the statutory minimum rebates a manufacturer must pay under the Medicaid Drug Rebate
Program, to 23.1% and 13.0% of the Average Manufacturer Price (“AMP”), for most branded and generic drugs, respectively; |
| • | expansion of the scope of healthcare fraud and abuse laws, including the False Claims Act and the
Anti-Kickback Statute, new government investigative powers and enhanced penalties for noncompliance; |
| • | a partial prescription drug benefit for Medicare recipients, or Medicare Part D, coverage gap discount
program in which manufacturers must agree to offer 50.0% point of sale discounts off negotiated prices of applicable brand drugs
to eligible beneficiaries during their coverage gap period, as a condition for the manufacturers’ outpatient drugs to be
covered under Medicare Part D; |
| • | extension of manufacturers’ Medicaid rebate liability to covered drugs dispensed to individuals
who are enrolled in Medicaid managed care organizations; |
| • | expansion of eligibility criteria for Medicaid programs by, among other things, allowing states
to offer Medicaid coverage to additional individuals and by adding new mandatory eligibility categories for individuals with income
at or below 133.0% of the Federal Poverty Level, thereby potentially increasing manufacturers’ Medicaid rebate liability; |
| • | expansion of the entities eligible for discounts under the Public Health Service pharmaceutical
pricing program; |
| • | requirements to report annually specified financial arrangements with physicians and teaching hospitals,
as defined in the Affordable Care Act and its implementing regulations, including reporting any “payments or transfers of
value” made or distributed to prescribers, teaching hospitals, and other healthcare providers and reporting any ownership
and investment interests held by physicians and other healthcare providers and their immediate family members and applicable group
purchasing organizations during the preceding calendar year, with data collection required beginning August 1, 2013 and reporting
to the Centers for Medicare and Medicaid Services (“CMS”) required beginning March 31, 2014 and by the 90th day of
each subsequent calendar year; |
| • | a requirement to annually report drug samples that manufacturers and distributors provide to physicians; |
| • | a Patient-Centered Outcomes Research Institute to oversee, identify priorities in, and conduct
comparative clinical effectiveness research, along with funding for such research; and |
| • | a mandatory nondeductible payment for employers with 50 or more full time employees (or equivalents)
who fail to provide certain minimum health insurance coverage for such employees and their dependents, beginning in 2015 (pursuant
to relief enacted by the Treasury Department). |
The Affordable Care Act also established
an Independent Payment Advisory Board (“IPAB”) to reduce the per capita rate of growth in Medicare spending. Beginning
in 2014, the IPAB was mandated to propose changes in Medicare payments if it determines that the rate of growth of Medicare expenditures
exceeds target growth rates. The IPAB has broad discretion to propose policies to reduce expenditures that may have a negative
impact on payment rates for pharmaceutical and biologic products. A proposal made by the IPAB is required to be implemented by
the CMS unless Congress adopts a proposal with savings greater than those proposed by the IPAB. The IPAB has not yet been called
upon to act as the annual determinations by the CMS Office of the Actuary have not identified a savings target for implementation.
In addition, other legislative changes
have been proposed and adopted since passage of the Affordable Care Act. The Budget Control Act of 2011, among other things, created
the Joint Select Committee on Deficit Reduction (“Joint Select Committee”) to recommend proposals for spending reductions
to Congress. The Joint Select Committee did not achieve its targeted deficit reduction of an amount greater than $1.2 trillion
for the fiscal years 2012 through 2021, triggering the legislation’s automatic reductions to several government programs.
These reductions included aggregate reductions to Medicare payments to healthcare providers of up to 2.0% per fiscal year, which
went into effect in April 2013. In January 2013, former President Obama signed into law the American Taxpayer Relief Act of 2012,
which, among other things, reduced Medicare payments to several categories of healthcare providers and increased the statute of
limitations period for the government to recover overpayments to providers from three to five years. These laws may result in additional
reductions in Medicare and other healthcare funding, which could have a material adverse effect on our future customers, patients
and third-party payors and, accordingly, our financial operations.
In January 2016, the CMS issued a final rule regarding the Medicaid
drug rebate program. The final rule, effective April 1, 2016, among other things, revises the way the “average manufacturer
price” is to be calculated by manufacturers participating in the program and implements certain amendments to the Medicaid
rebate statute created under the Affordable Care Act. Also, there has been significant negative publicity and increasing legislative
and enforcement interest in the U.S. with respect to drug pricing practices. Specifically, there have been several recent U.S.
Congressional inquiries and proposed bills designed to, among other things, bring more transparency to drug pricing, review the
relationship between pricing and manufacturer patient programs and reform government program reimbursement methodologies for drugs.
It is possible that there will be further legislation or regulation that could harm our business, products financial condition
and results of operations.
We anticipate that the Affordable Care
Act and other legislative reforms will result in additional downward pressure on the price that we receive for any approved product,
if covered, and could seriously harm our business, though we are still unsure what its full impact will be. There have been judicial
and Congressional challenges to certain aspects of the Affordable Care Act, and we expect such challenges and amendments to continue
in the future. Any reduction in reimbursement from Medicare and other government programs may result in a similar reduction in
payments from private payors. The implementation of cost containment measures or other healthcare reforms may prevent us from being
able to generate revenue, attain profitability, or commercialize our products.
Any reduction in reimbursement from Medicare
or other government programs may result in a similar reduction in payments from private payors. The implementation of cost containment
measures or other healthcare reforms may compromise our ability to generate revenue, attain profitability or commercialize our
products. At the same time, there have been significant ongoing efforts to modify or eliminate the Affordable Care Act. For example,
the “Tax Cuts and Jobs Act” (“Tax Act”), enacted on December 22, 2017, repealed the shared responsibility
payment for individuals who fail to maintain minimum essential coverage under section 5000A of the Internal Revenue Code, commonly
referred to as the individual mandate, beginning in 2019.
The Joint Committee on Taxation estimates
that the repeal will result in over 13 million Americans losing their health insurance coverage over the next ten years and is
likely to lead to increases in insurance premiums. Further legislative changes to and regulatory changes under the Affordable Care
Act remain possible. It is unknown what form any such changes or any law proposed to replace the Affordable Care Act would take,
and how or whether it may affect our business in the future. Newly enacted FDA regulations may require us to expend additional
resources to obtain or maintain regulatory approval. For example, in August 2017 President Trump signed into law the Food &
Drug Administration Reauthorization Act (“FDARA”). This legislation imposes significant new requirements for clinical
trial sponsors which will affect, among other things, the development of drugs and biological products for pediatric use. This
legislation may result in new regulations, which may affect future options or timelines for regulatory approval.
Coverage and Reimbursement
Significant uncertainty exists as to the
coverage and reimbursement status of any drug products for which we obtain regulatory approval. In the U.S. and markets in other
countries, sales of any products for which we receive regulatory approval for commercial sale will depend in part on the availability
of reimbursement from third-party payors. Third-party payors include government health administrative authorities, managed care
providers, private health insurers and other organizations. The process for determining whether a payor will provide coverage for
a drug product may be separate from the process for setting the price or reimbursement rate that the payor will pay for the drug
product. Third-party payors may limit coverage to specific drug products on an approved list, or formulary, which might not include
all the FDA-approved drugs for a certain indication. Third-party payors are increasingly challenging the price and examining the
medical necessity and cost-effectiveness of medical products and services, in addition to their safety and efficacy. We may need
to conduct expensive pharmacoeconomic studies in to demonstrate the medical necessity and cost-effectiveness of our product candidates,
in addition to the costs required to obtain FDA approvals. Our product candidates, if approved, may not be considered medically
necessary or cost-effective. A payor’s decision to provide coverage for a drug product does not imply that an adequate reimbursement
rate will be approved. Adequate third-party reimbursement may not be available to enable us to maintain price levels sufficient
to realize an appropriate return on our investment in product development.
Existing federal law requires pharmaceutical
manufacturers to pay rebates to state governments, based on a statutory formula, on covered outpatient drugs reimbursed by the
Medicaid program as a condition of having their drugs paid for by AMP. AMP is determined by a statutory formula that is based on
prices defined in the statute. AMP must be calculated for all products that are covered outpatient drugs under the Medicaid program
and be the “best price.” Best price must be calculated only for those covered outpatient drugs that are a single source
drug or innovator multiple source drug, such as biologic products. Manufacturers are required to report AMP and best price for
each of their covered outpatient drugs to the government on a regular basis. Additionally, some state Medicaid programs have imposed
a requirement for supplemental rebates over and above the formula set forth in federal law as a condition for coverage. In addition
to the Medicaid rebate program, federal law also requires that if a pharmaceutical manufacturer wishes to have its outpatient drugs
covered under Medicaid as well as under Medicare Part B, it must sign a “Master Agreement” obligating it to provide
a formulaic discount of approximately 24%, known as the federal ceiling price for drugs sold to the U.S. Departments of Defense,
Veterans Affairs, the Public Health Service and the Coast Guard, and also provide discounts through a drug pricing agreement meeting
the requirements of Section 340B of the PHSA for outpatient drugs sold to certain specified eligible healthcare organizations.
The formula for determining the discounted purchase price under the 340B drug pricing program is defined by statute and is based
on the AMP and rebate amount for a product as calculated under the Medicaid drug rebate program discussed above.
Different pricing and reimbursement schemes
exist in other countries. In the E.U. governments influence the price of pharmaceutical products through their pricing and reimbursement
rules and control of national healthcare systems that fund a large part of the cost of those products to consumers. Some jurisdictions
operate positive and negative list systems under which products may only be marketed once a reimbursement price has been agreed
upon. To obtain reimbursement or pricing approval, some of these countries may require the completion of clinical trials that compare
the cost-effectiveness of a product candidate to currently available therapies. Other member states allow companies to fix their
own prices for medicines but monitor and control company profits. The downward pressure on healthcare costs in general, particularly
prescription drugs, has become more intense.
Thus, increasingly high barriers are being
erected to the entry of new products. The E.U. provides options for its member states to restrict the range of medicinal products
for which their national health insurance systems provide reimbursement and to control the prices of medicinal products for human
use. A member state may approve a specific price for the medicinal product, or it may instead adopt a system of direct or indirect
controls on the profitability of the company placing the medicinal product on the market. We may face competition for our product
candidates from lower-priced products in foreign countries that have placed price controls on pharmaceutical products. In addition,
in some countries, cross-border imports from low-priced markets exert a commercial pressure on pricing within a country.
The marketability of any product for which
we receive regulatory approval for commercial sale may suffer if the government and third-party payors fail to provide adequate
coverage and reimbursement. Also, an increasing emphasis on managed care in the U.S. has increased and will continue to increase
the pressure on pharmaceutical pricing. Coverage policies and third-party reimbursement rates may change at any time.
Even if favorable coverage and reimbursement
status is attained for one or more products for which we receive regulatory approval, less favorable coverage policies and reimbursement
rates may be implemented in the future.
Other U.S. Healthcare Laws and Compliance
Requirements
In the U.S., our activities are potentially
subject to additional regulation by various federal, state and local authorities in addition to the FDA, including the CMS, other
divisions of the HHS and its Office of Inspector General, the Office for Civil Rights that has jurisdiction over matters relating
to individuals’ privacy and protected health information, the DOJ, individual U.S. Attorney offices within the DOJ and state
and local governments.
The federal Anti-Kickback Statute prohibits,
among other things, knowingly and willfully offering, paying, soliciting or receiving any remuneration, directly or indirectly,
to induce or in return for purchasing, leasing, ordering or arranging for the purchase, lease or order of any healthcare item or
service reimbursable under Medicare, Medicaid or other federally financed healthcare program. The Anti-Kickback Statute has been
interpreted broadly to proscribe arrangements and conduct where only one purpose of the remuneration between the parties was to
induce or reward referrals. The term remuneration has been interpreted broadly to include anything of value. This statute has been
interpreted to apply to arrangements between pharmaceutical manufacturers, on one hand, and prescribers, purchasers and formulary
managers on the other. Although there are several statutory exemptions and regulatory safe harbors protecting some business arrangements
from prosecution, the exemptions and safe harbors are drawn narrowly and practices that involve remuneration intended to induce
prescribing, purchasing or recommending may be subject to scrutiny if they do not qualify for an exemption or safe harbor. Our
practices may not in all cases meet all the criteria for safe harbor protection from federal Anti-Kickback Statute liability. Failure
to meet all the requirements of an applicable safe harbor or statutory exemption, however, does not make the arrangement or conduct
per se unlawful under the Anti-Kickback Statute; instead, in such cases, the legality of the arrangement would be evaluated
on a case-by-case basis based on a consideration of all the facts and circumstances to ascertain the parties’ intent.
Moreover, the intent standard under the
Anti-Kickback Statute was amended by the Affordable Care Act to a stricter standard such that a person or entity no longer needs
to have actual knowledge of the statute or specific intent to violate it to have committed a violation. In addition, the Affordable
Care Act codified case law that a claim including items or services resulting from a violation of the federal Anti-Kickback Statute
constitutes a false or fraudulent claim for purposes of the federal False Claims Act, as discussed below.
The federal Civil Monetary Penalties Law
imposes penalties against any person or entity that, among other things, is determined to have presented or caused to be presented
a claim to a federal health program that the person knows or should know is for an item or service that was not provided as claimed
or is false or fraudulent.
The federal False Claims Act prohibits
any person from knowingly presenting, or causing to be presented, a false claim for payment to the federal government or knowingly
making, using or causing to be made or used a false record or statement material to a false or fraudulent claim to the federal
government. Through a modification made to the Fraud Enforcement and Recovery Act of 2009, a claim includes “any request
or demand” for money or property presented to the U.S. government. Pharmaceutical and other healthcare companies have been
prosecuted under these laws for allegedly providing free product to customers with the expectation that the customers would bill
federal programs for the product. Other companies have been prosecuted for causing false claims to be submitted because of the
companies’ marketing of the product for unapproved—and thus non-reimbursable—uses. The Federal Health Insurance
Portability and Accountability Act of 1996 (“HIPAA”) created additional federal criminal statutes that prohibit knowingly
and willfully executing a scheme to defraud any healthcare benefit program, including private third-party payors and knowingly
and willfully falsifying, concealing or covering up a material fact or making any materially false, fictitious or fraudulent statement
in connection with the delivery of or payment for healthcare benefits, items or services. Also, many states have additional similar
fraud and abuse statutes or regulations that apply to items and services reimbursed under Medicaid and other state programs, or,
in several states, apply regardless of the type of payor.
In addition, we may be subject to data
privacy and security regulation by both the federal government and the states in which we conduct our business. HIPAA, as amended
by the Health Information Technology for Economic and Clinical Health Act (“HITECH”) and its implementing regulations,
imposes requirements relating to the privacy, security and transmission of individually identifiable health information. Among
other things, HITECH makes HIPAA’s privacy and security standards directly applicable to “business associates,”
such as independent contractors or agents of covered entities that receive or obtain protected health information with providing
a service on behalf of a covered entity. HITECH also increased the civil and criminal penalties that may be imposed against covered
entities, business associates and possibly other persons. It also gave state attorneys general new authority to file civil actions
for damages or injunctions in federal courts to enforce the federal HIPAA laws and seek attorney’s fees and costs associated
with pursuing these actions. In addition, state laws govern the privacy and security of health information in specified circumstances,
many of which differ from each other in significant ways and may not have the same effect - thus complicating compliance efforts.
The federal Physician Payments Sunshine
Act under the Affordable Care Act and its implementing regulations also require that certain manufacturers of drugs, devices, biologics
and medical supplies for which payment is available under Medicare, Medicaid or the Children’s Health Insurance Program,
with certain exceptions, to report information related to certain payments or other transfers of value made or distributed to physicians
and teaching hospitals, or to entities or individuals at the request of, or designated on behalf of, the physicians and teaching
hospitals. It also requires reporting annually certain ownership and investment interests held by physicians and their immediate
family members and payments or other “transfers of value” made to such physician owners. Failure to submit timely,
accurately and completely the required information may result in civil monetary penalties of up to an aggregate of $150,000 per
year and up to an aggregate of $1 million per year for “knowing failures”. Manufacturers were required to begin collecting
data on August 1, 2013 and submit reports on aggregate payment data to the government for the first reporting period of August 1,
2013 to December 31, 2013, by March 31, 2014. They are also required to report detailed payment data for the first reporting
period and submit legal attestation to the accuracy of such data by June 30, 2014. Thereafter, manufacturers must submit reports
by the 90th day of each subsequent calendar year. The CMS made all reported data publicly available starting on September 30,
2014. Certain states also mandate implementation of compliance programs, impose additional restrictions on pharmaceutical manufacturer
marketing practices and/ or require the tracking and reporting of gifts, compensation and other remuneration to healthcare providers
and entities.
To distribute products commercially, we
must comply with state laws that require the registration of manufacturers and wholesale distributors of pharmaceutical products
in a state, including, in some states, manufacturers and distributors who ship products into the state even if such manufacturers
or distributors have no place of business within the state. Some states also impose requirements on manufacturers and distributors
to establish the pedigree of product in the chain of distribution, including some states that require manufacturers and others
to adopt new technology capable of tracking and tracing products as they move through the distribution chain. Several states have
enacted legislation requiring pharmaceutical companies to, among other things, establish marketing compliance programs, file periodic
reports with the state, make periodic public disclosures on sales, marketing, pricing, clinical trials and other activities, and/or
register their sales representatives. They also prohibit pharmacies and other healthcare entities from providing specified physician
prescribing data to pharmaceutical companies for use in sales and marketing, and to prohibit other specified sales and marketing
practices. All our activities are potentially subject to federal and state consumer protection and unfair competition laws.
Because of the breadth of these laws and
the narrowness of available statutory and regulatory exemptions, it is possible that some of our business activities could be subject
to challenge under one or more of such laws. If our operations are found to be in violation of any of the federal and state laws
described above or any other governmental regulations that apply to us, we may be subject to penalties. These include criminal
and civil monetary penalties, damages, fines, imprisonment, exclusion from participation in government programs, injunctions, recall
or seizure of products, total or partial suspension of production, denial or withdrawal of pre-marketing product approvals, private
“qui tam” actions brought by individual whistleblowers in the name of the government or refusal to allow us to enter
supply contracts and the curtailment or restructuring of our operations. Any of these could adversely affect our ability to operate
our business and our results of operations. To the extent any of our products are sold in a foreign country, we may be subject
to similar foreign laws and regulations, which may include, for instance, applicable post-marketing requirements, including safety
surveillance, anti-fraud and abuse laws, and implementation of corporate compliance programs and reporting of payments or transfers
of value to healthcare professionals.
Controlled Substances Regulation
Our product candidates involving Cannabis
contain controlled substances, as defined in the federal Controlled Substances Act of 1970 (“CSA”). The CSA and its
implementing regulations establish a “closed system” of regulations for controlled substances. The CSA imposes registration,
security, recordkeeping and reporting, storage, manufacturing, distribution, importation and other requirements under the oversight
of the U.S. Drug Enforcement Administration (“DEA”). The DEA is the federal agency responsible for regulating controlled
substances. It requires those individuals or entities that manufacture, import, export, distribute, research, or dispense controlled
substances to comply with the regulatory requirements to prevent the diversion of controlled substances to illicit channels of
commerce.
The DEA categorizes controlled substances
into one of five schedules—Schedule I, II, III, IV or V—with varying qualifications for listing in each schedule. Schedule
I substances have a high potential for abuse, have no currently accepted medical use in treatment in the U.S. and lack accepted
safety for use under medical supervision. They may be used only in federally approved research programs and may not be marketed
or sold for dispensing to patients in the U.S. Pharmaceutical products having a currently accepted medical use that are otherwise
approved for marketing may be listed as Schedule II, III, IV or V substances, with Schedule I substances presenting the highest
potential for abuse and physical or psychological dependence. Schedule V substances present the lowest relative potential for abuse
and dependence. The regulatory requirements are more restrictive for Schedule II substances than Schedule III substances. For example,
all Schedule II drug prescriptions must be signed by a physician, physically presented to a pharmacist in most situations and cannot
be refilled.
Following NDA approval of a drug containing
a Schedule I controlled substance, that substance must be rescheduled as a Schedule II, III, IV or V substance before it can be
marketed. On November 17, 2015, H.R. 639, Improving Regulatory Transparency for New Medical Therapies Act, passed through both
houses of Congress. On November 25, 2015, the bill was signed into law. The law removes uncertainty associated with timing of the
DEA rescheduling process after NDA approval. Specifically, it requires DEA to issue an “interim final rule,” pursuant
to which a manufacturer may market its product within 90 days of FDA approval. The law also preserves the period of orphan marketing
exclusivity for the full seven years such that this period only begins after DEA scheduling. This contrasts with the previous situation
whereby the orphan “clock” began to tick upon FDA approval, even though the product could not be marketed until DEA
scheduling was complete.
Facilities that manufacture, distribute,
import or export any controlled substance must register annually with the DEA. The DEA registration is specific to the location,
activity and controlled substance schedule. For example, separate registrations are required for importation and manufacturing
activities, and each registration authorizes which schedules of controlled substances the registrant may handle. However, certain
coincident activities are permitted without obtaining a separate DEA registration, such as distribution of controlled substances
by the manufacturer that produces them.
The DEA inspects all manufacturing facilities
to review security, recordkeeping, reporting and handling prior to issuing a controlled substance registration. The specific security
requirements vary by the type of business activity and the schedule and quantity of controlled substances handled. The most stringent
requirements apply to manufacturers of Schedule I and Schedule II substances. Required security measures commonly include background
checks on employees and physical control of controlled substances through storage in approved vaults, safes and cages, and through
use of alarm systems and surveillance cameras. An application for a manufacturing registration as a bulk manufacturer for a Schedule
I or II substance must be published in the Federal Register and is open for 30 days to permit interested persons to submit comments,
objections or requests for a hearing. A copy of the notice of the Federal Register publication is forwarded by DEA to all those
registered, or applicants for registration, as bulk manufacturers of that substance. Once registered, manufacturing facilities
must maintain records documenting the manufacture, receipt and distribution of all controlled substances. Manufacturers must submit
periodic reports to the DEA of the distribution of Schedule I and II controlled substances, Schedule III narcotic substances and
other designated substances. Registrants must also report any controlled substance thefts or significant losses and must obtain
authorization to destroy or dispose of controlled substances. As with applications for registration as a bulk manufacturer, an
application for an importer registration for a Schedule I or II substance must also be published in the Federal Register, which
remains open for 30 days for comments. Imports of Schedule I and II controlled substances for commercial purposes are generally
restricted to substances not already available from domestic supplier or where there is not adequate competition among domestic
suppliers. In addition to an importer or exporter registration, importers and exporters must obtain a permit for every import or
export of a Schedule I and II substance or Schedule III, IV and V narcotic, and submit import or export declarations for Schedule
III, IV and V non-narcotics. In some cases, Schedule III non-narcotic substances may be subject to the import/export permit requirement,
if necessary, to ensure that the U.S. complies with its obligations under international drug control treaties.
For drugs manufactured in the U.S., the
DEA establishes annually an aggregate quota for substances within Schedules I and II that may be manufactured or produced in the
U.S. based on the DEA’s estimate of the quantity needed to meet legitimate medical, scientific research and industrial needs.
This limited aggregate amount of Cannabis that the DEA allows to be produced in the U.S. each year is allocated among individual
companies, which, in turn, must annually apply to the DEA for individual manufacturing and procurement quotas. The quotas apply
equally to the manufacturing of the active pharmaceutical ingredient and production of dosage forms. The DEA may adjust aggregate
production quotas a few times per year and individual manufacturing or procurement quotas from time to time during the year, although
the DEA has substantial discretion in whether to make such adjustments for individual companies.
The states also maintain separate controlled
substance laws and regulations, including licensing, recordkeeping, security, distribution and dispensing requirements. State authorities,
including boards of pharmacy, regulate use of controlled substances in each state. Failure to maintain compliance with applicable
requirements, particularly as manifested in the loss or diversion of controlled substances, can result in enforcement action that
could have a material adverse effect on our business, operations and financial condition. The DEA may seek civil penalties, refuse
to renew necessary registrations, or initiate proceedings to revoke those registrations. In certain circumstances, violations could
lead to criminal prosecution.
Patents, Intellectual Property and Trade
Secrets
Intellectual property (“IP”)
and patent protection are of paramount importance to our business, as are the trade secrets and other strategies we have employed
with Austrianova to protect the proprietary Cell-in-a-Box® technology. Although we believe we take reasonable measures
to protect our IP and trade secrets and those of Austrianova, we cannot guarantee we will be able to protect and enforce our IP
or obtain international patent protection for our product candidates as needed. We license technology and trademarks relating to
three areas: (i) live cell encapsulation with cells that express cytochrome P450 where the capsule is permeable to prodrug molecules
and the cells are retained within the capsules; (ii) treatment of solid cancerous tumors and (ii) encapsulation of cells for producing
retroviral particles for gene therapy. We also have exclusive worldwide licensing rights to patents, trademarks and know-how using
Cell-in-a-Box® technology in the diabetes field and in the treatment of diseases and related conditions using cannabinoids.
Litigation may be required to protect our
product candidates, IP rights and trade secrets or to determine the validity and scope of the proprietary rights of others. Maintenance
of our IP utilizes financial and operational resources. In addition, the possibility exists that our IP could be discovered to
be owned by others, be invalid or be unenforceable - potentially bringing unforeseen challenges to us.
Intellectual Property Agreements and
Patent Applications
The following patents and agreements constitute
our material IP:
| • | We are a party to the Bavarian Nordic/GSF License Agreement pursuant to which Bavarian Nordic/GSF
are the licensors and Bio Blue Bird, our wholly owned subsidiary, is the licensee. The Bavarian Nordic/GSF License Agreement was
signed in July 2005 and amended in December 2006. Pursuant to the Bavarian Nordic/GSF License, the licensee is granted an exclusive
license to use Bavarian Nordic’s clinical data and know-how for encapsulating genetically modified human cells to treat cancer.
The licensors have rights to terminate the license if the annuity and upkeep fees are not paid to Bavarian Nordic, there is not
proper reporting or there is not a clearly documented effort to commercialize this technology. The term of the Bavarian Nordic/GSF
License Agreement expired on March 27, 2017. |
| • | In October 2016, Bavarian Nordic/GSF and Bio Blue Bird amended the Bavarian Nordic License Agreement
to include, among other things, the right to import within the scope of the license, reflect ownership and notification of improvements,
clarify which provisions survive expiration or termination of the Bavarian Nordic License Agreement and provide rights to Bio Blue
Bird to the clinical data and know-how after the expiration of the licensed patent rights. |
| • | The Third Addendum and the Clarification Agreement provides us with an exclusive worldwide license,
with a right to sublicense, to use Austrianova’s Cell-in-a-Box® encapsulation technology and associated technologies
for the development of treatments for cancer and use of Austrianova’s Cell-in-a-Box® trademark and its associated technology
using genetically modified HEK293 cells overexpressing the cytochrome P450 2B1 gene that are encapsulated using the licensed technology. |
| • | The Diabetes Licensing Agreement provides us with an exclusive worldwide license, with a right
to sublicense, to use the Cell-in-a-Box® trademark and its associated technology with genetically modified or non-modified
non-stem cell lines and induced pluripotent stem (“iPS”) cells designed to produce insulin or other critical components
for the treatment of diabetes. |
| • | The Cannabis Licensing Agreement provides us with an exclusive worldwide license, with a right
to sublicense, to use the Cell-in-a-Box® trademark and its associated technology with genetically modified non-stem cell lines
which are designed to convert cannabinoids to their active form to develop therapies for diseases and their related symptoms. |
| • | We entered into a Binding Term Sheet (“Binding Term Sheet”) with SG Austria and Austrianova
pursuant to which the parties reached an agreement to amend certain provisions in the SG Austria APA, the Diabetes Licensing Agreement,
the Cannabis Licensing Agreement and the Vin-de-Bona Consulting Agreement. |
We entered into the amendments contemplated by the Binding Term
Sheet (“Binding Term Sheet Amendments”). The Binding Term Sheet Amendments provide that our obligation to make milestone
payments to Austrianova will be eliminated in their entirety under the: (i) Cannabis License Agreement; and (ii) the Diabetes License
Agreement, as amended. The Binding Term Sheet Amendments also provides that our obligation to make milestone payments to SG Austria
pursuant to the SG Austria APA, as amended and clarified, is eliminated in their entirety. One of the Binding Term Sheet Amendments
also provides that the scope of the Diabetes License Agreement is expanded to include all cell types and cell lines of any kind
or description now or later identified, including, but not limited to, primary cells, mortal cells, immortal cells and stem cells
at all stages of differentiation and from any source specifically designed to produce insulin for the treatment of diabetes.
In addition, one of the Binding Term Sheet Amendments provides
that we have a 5-year right of first refusal from August 30, 2017 in the event that Austrianova chooses to sell, transfer or assign
at any time during this period the Cell-in-a-Box® technology, tradename and Associated Technologies; provided, however, that
the Associated Technologies subject to the right of first refusal do not include Bac-in-a-Box
The Binding Term Sheet Amendments further provide that: (i)
the royalty payments on gross sales as specified in the SG Austria APA, the Cannabis License Agreement and the Diabetes License
Agreement are changed to 4%; and (ii) the royalty payments on amounts received by us from sublicensees on sublicensees’ gross
sales under the same agreements are changed to 20% of the amount received by us from our sublicensees, provided, however, that
in the event the amounts received by us from sublicensees is 4% or less of sublicensees’ gross sales, Austrianova will receive
50% of what we receive (up to 2%) and then additionally 20% of any amount we receive over that 4%.
The Binding Term Sheet Amendments also provide that Austrianova
will receive 50% of any other financial and non-financial consideration received from our sublicensees of the Cell-in-a-Box®
technology.
The Melligen Cell License Agreement provides us with an exclusive
worldwide license, with a right to sublicense, to use genetically modified human cells that have been modified to comprise pancreas
islet cell glucokinase for use in developing a therapy for diabetes. The Melligen cells are patent protected in the U.S. and Europe.
Patent Applications
On March 21, 2018, we filed a U.S. patent
application and a Patent Cooperation Treaty (“PCT”) application directed at methods of treating cancerous tumors, such
as those of the pancreas, liver, breast and colon, using the live-cell encapsulation of genetically modified human cells that overexpress
a form of the cytochrome P450 enzyme system normally found in the liver. The methods involve administering encapsulated cells expressing
the cytochrome P450 enzyme system along with a prodrug, such as an oxazaphosphorine or ifosfamide, which gets converted to an active
form by the cytochrome P450 enzyme system. These applications, if approved, will expire on March 21, 2038, subject to any applicable
patent term adjustment or extension that may be available. We plan to prosecute both patent applications.
Details of Our Material Agreements
Third Addendum to the SG Austria APA
In June 2013, we and SG Austria entered
the Third Addendum and the Clarification Agreement. The Third Addendum requires us to make the following payments for the purchased
assets; these payments were timely made in full under the payment deadlines set forth in the Third Addendum:
| • | A $60,000 payment due under the SG Austria APA; |
| • | A payment of Stamp Duty estimated to be $10,000-17,000 to the Singapore Government; |
| • | $500,000 to be used to pay off the existing debt of Bio Blue Bird; and |
Pursuant to the Third Addendum, we agreed
to and have entered a manufacturing agreement with SG Austria for the manufacture of the pancreatic cancer clinical trial material
we will need. The Manufacturing Framework Agreement requires us to pay Austrianova a one-time manufacturing setup fee in the amount
of $647,000, of which 50% is required to be paid on the effective date of the Manufacturing Framework Agreement and 50% is required
to be paid three months later. We have paid the full amount of the manufacturing setup fee. The Manufacturing Framework Agreement
also requires us to pay a fee for producing the final encapsulated cell product of $647 per vial of 300 capsules after production,
with a minimum purchased batch size of 400 vials of any Cell-in-a-Box® product. The fees under the Manufacturing
Framework Agreement are subject to annual increases according to the annual inflation rate in the country in which the encapsulated
cell products are manufactured. We have placed an order to produce 400 vials for our pancreatic cancer studies and have paid Austrianova
$172,533 of the total cost of $258,800 for the order.
The Third Addendum also requires the Company
to make future royalty and milestone payments as follows:
| • | Two percent royalty on all gross sales received by us or our affiliates; |
| • | Ten percent royalty on gross revenues received by us or our affiliates from a sublicense or right
to use the patents or the licenses granted by us or our affiliates; |
| • | Milestone payments of $100,000 within 30 days after enrollment of the first human patient in the
first clinical trial for each product; $300,000 within 30 days after enrollment of the first human patient in the first Phase 3
clinical trial for each product; and $800,000 within 60 days after having a NDA or a BLA approved by the FDA or a MAA approved
by the EMA in Europe or its equivalent based on the country in which it is accepted for each product; and |
| • | Milestone payments of $50,000 due 30 days after enrollment of the first veterinary patient in the
first trial for each product and $300,000 due 60 days after having a BLA, a NDA or a MAA or its equivalent approved based on the
country in which it is accepted for each veterinary product. |
On May 14, 2018, we entered into amendments
to the Third Addendum. See “—Details of the Company’s Material Agreements” discussed above.
Diabetes Licensing Agreement
Under the Diabetes Licensing Agreement,
we are required to make a payment of $2,000,000 in two equal payments of $1,000,000 each. We made our first $1,000,000 payment
on October 30, 2013. Our second payment of $1,000,000 was made on February 25, 2014.
The Diabetes Licensing Agreement requires
us to pay Austrianova, pursuant to a manufacturing agreement to be entered between the parties, a one-time manufacturing setup
fee in the amount of approximately $600,000, of which 50% is required to be paid on the signing of a manufacturing agreement for
a product and 50% is required to be paid three months later. In addition, the Diabetes Licensing Agreement requires us to pay a
manufacturing production fee, which is to be defined in the manufacturing agreement, for producing the final encapsulated cell
product of approximately $600.00 per vial of 300 capsules after production, with a minimum purchased batch size of 400 vials of
any Cell-in-a-Box® encapsulation-based product. All costs for encapsulated cell products will be subject to an annual
increase equal to the published rate of inflation in the country of manufacture of the vials.
The Diabetes Licensing Agreement requires
us to make future royalty and milestone payments as follows:
| • | Ten percent royalty of gross sales of all products we sell; |
| • | Twenty percent royalty of the amount received by us from a sub-licensee on its gross sales; and |
| • | Milestone payments of $100,000 within 30 days of beginning the first pre-clinical experiments using
the encapsulated cells; $500,000 within 30 days after enrollment of the first human patient in the first clinical trial; $800,000
within 30 days after enrollment of the first human patient in the first Phase 3 clinical trial; and $1,000,000 within 90 days after
having a NDA or a BLA approved by the FDA or a MAA approved by the EMA in Europe or its equivalent based on the country in which
it is accepted for each product. |
The license under the Diabetes Licensing
Agreement, as amended, may be terminated and all rights will revert to Austrianova if any of the following milestone events do
not occur within the following timeframes, subject to all the necessary and required research having been successful and the relevant
product being sufficiently prepared to enter a clinical trial:
| • | If we fail to enter a research program with the technology in the scope of the license providing
a total funding equal to or greater than $400,000 within three years of June 25, 2013, the effective date of the Diabetes Licensing
Agreement (we have met this requirement); or |
| • | If we fail to enter a clinical trial or its equivalent for a product within seven years of the
effective date of the Diabetes Licensing Agreement. |
In May 2018, we entered into amendments
to the Diabetes Licensing Agreement. See “—Details of the Company’s Material Agreements” discussed above.
Cannabis Licensing Agreement
Pursuant to the Cannabis Licensing Agreement,
we acquired from Austrianova an exclusive worldwide license to use the Cell-in-a-Box® trademark and its associated
technology with genetically modified non-stem cell lines which are designed to activate cannabinoids to develop therapies involving
Cannabis with a right to sublicense.
Under the Cannabis Licensing Agreement,
we are required to pay Austrianova an initial upfront payment of $2,000,000 (“Upfront Payment”). We have the right
to make periodic monthly partial payments of the Upfront Payment in amounts to be agreed upon between the parties prior to each
such payment being made. Under the Cannabis Licensing Agreement, the Upfront Payment must be paid in full by no later than June
30, 2015. The parties amended the Cannabis Licensing Agreement twice pursuant to which the balance of the Upfront Payment is to
be paid by June 30, 2016. We have paid the Upfront Payment of $2,000,000 in full.
The Cannabis Licensing Agreement requires
us to pay Austrianova, pursuant to a manufacturing agreement to be entered between the parties, a one-time manufacturing setup
fee in the amount of $800,000, of which 50% is required to be paid on the signing of a manufacturing agreement for a product and
50% is required to be paid three months later. In addition, the Cannabis Licensing Agreement requires us to pay a manufacturing
production fee, which is to be defined in the manufacturing agreement, for producing the final encapsulated cell product of $800
per vial of 300 capsules after production with a minimum purchased batch size of 400 vials of any Cell-in-a-Box® product.
All costs for encapsulated cell products, the manufacturing setup fee and the manufacturing production fee will be subject to annual
increases, in accordance with the inflation rate in the country in which the encapsulated cell products are manufactured.
The Cannabis Licensing Agreement requires
us to make future royalty and milestone payments as follows:
| • | Ten percent royalty of the gross sale of all products sold by us; |
| • | Twenty percent royalty of the amount received by us from a sublicense on its gross sales; and |
| • | Milestone payments of $100,000 within 30 days of beginning the first pre-clinical experiments using
the encapsulated cells; $500,000 within 30 days after enrollment of the first human patient in the first clinical trial; $800,000
within 30 days after enrollment of the first human patient in the first Phase 3 clinical trial; and $1,000,000 within 90 days after
having a NDA or a BLA approved by the FDA or a MAA approved by the EMA or its equivalent based on the country in which it is accepted
for each product. |
The license under the Cannabis Licensing
Agreement, as amended, may be terminated and all rights will revert to Austrianova if any of the following milestone events do
not occur within the following timeframes:
If we do not enter a research program involving the scope of
the license within three years of December 1, 2014, the effective date of the Cannabis Licensing Agreement (we have met this requirement);
or
If we do not enter a clinical trial or its equivalent
for a product within 7 years of the effective date of the Cannabis Licensing Agreement
In May 2018, we entered into amendments
to the Cannabis Licensing Agreement. See “—Details of the Company’s Material Agreements” discussed above.
Melligen Cell License Agreement
The Melligen Cell License Agreement requires
that we pay royalty, milestone and patent costs to UTS as follows:
| • | Six percent of gross exploitation revenue on product sales; |
| • | Twenty-five percent of gross revenues if the product is sublicensed by us; |
| • | Milestone payments of AU$ 50,000 at the successful conclusion of a preclinical study, AU$ 100,000
at the successful conclusion of a Phase 1 clinical trial, AU$ 450,000 at the successful conclusion of a Phase 2 clinical trial,
and AU$ 3,000,000 at the successful conclusion of a Phase 3 clinical trial; and |
| • | Patent costs of fifteen percent of the costs paid by UTS to prosecute and maintain patents related
to the licensed intellectual property. |
In the event of a default under the Melligen
Cell License Agreement, the non-defaulting party may immediately terminate the agreement by notice in writing to the defaulting
party if: (i) the default has continued for not less than 14 days or occurred more than 14 days earlier and has not been remedied;
(ii) the non-defaulting party serves upon the defaulting party notice in writing requiring the default to be remedied within 30
days of such notice, or such greater number of days as the non-defaulting party may in its discretion allow, and (iii) the defaulting
party has failed to comply with the notice referred to in (ii) above.
The Melligen Cell License Agreement was
amended in April 2016 to change the name of the license to our current name and clarify certain ambiguities in the agreement. We
are required to pay the Melligen cell patent prosecution costs and to pay to UTS a patent administration fee equal to 15% of all
amounts paid by UTS to prosecute and maintain patents related to the Melligen cells.
In August 2017, we entered into the Binding
Term Sheet pursuant to which the parties reached an agreement to amend certain provisions in the SG Austria APA, the Diabetes Licensing
Agreement the Cannabis Licensing Agreement and the Vin-de-Bona Consulting Agreement.
In May 2018, we entered into agreements
with SG Austria and Austrianova to amend certain provisions of the SG Austria APA, the Diabetes Licensing Agreement, the Cannabis
Licensing Agreement and the Vin-de-Bona Consulting Agreement pursuant to the Binding Term Sheet. For a full description of these
amendments , see Item 1. “History of the Business.”
Sources and Availability of Raw Materials
The entire encapsulation process relating
to the encapsulation of the cells for the oncology and diabetes-based therapies we are developing is to be carried out by Austrianova.
Austrianova is responsible for acquiring all of the necessary raw materials used in this process, including the cellulose sulfate
necessary for encapsulating the live cells. As mentioned above, we engaged ViruSure to clone new cells from a selected clone. Those
cells have been grown by Eurofins to populate a MCB for our future clinical trials. See also “—Manufacturing”
in this Item 1. “Business.”
Employees
As of April 30, 2019, we had four full-time
employees and eight consultants who devote substantial time to us. They function as our Chief Scientific Officer, Director of Diabetes
Program Development, Director of Cannabis Program Development, Chairman of our Medical and Advisory Board, Members of our Medical
and Scientific Advisory Board, a Senior Strategic Advisor to our Chief Executive Officer and the Board and a business development
consultant. We use several other consulting scientists, physicians and academics for a great deal of our R&D.
Medical and Scientific Advisory Board
We regularly seek advice and input from
the members of our Medical and Scientific Advisory Board on matters related to our R&D programs. The members of our Medical
and Scientific Advisory Board consist of experts across a wide range of key disciplines relevant to our clinical development programs.
We intend to continue to leverage the broad expertise of our advisors by seeking their counsel on important topics relating to
our product development and clinical development programs. The members of our Medical and Scientific Advisory Board are not our
employees and may have commitments to, or consulting or advisory contracts with, other entities that may limit their availability
to us. In addition, our advisors may have arrangements with other companies to assist those companies in developing products or
other technologies. All the members of our Medical and Scientific Advisory Board are affiliated with other entities and devote
only a portion of their time to us. The members of our Medical and Scientific Advisory Board are not officers or directors of our
company. Our current advisors are:
| • | Dr. Matthias Löhr – Professor of Gastroenterology & Hepatology, Karolinska Institute,
Stockholm, Sweden |
| • | Dr. Manuel Hidalgo – Chief of the Division of Hematology and Medical Oncology at Weill Cornell
Medicine and New York-Presbyterian/Weill Cornell Medical Center in New York, New York. |
| • | Prof. Dr. Hans-Peter Hammes – Professor of Internal Medicine and Endocrinology, Faculty of
Clinical Medicine Mannheim of Heidelberg University and Section Leader for Endocrinology and Diabetology, Mannheim, Germany |
| • | Dr. Brian Salmons – Chief Executive Officer and President of Austrianova Pte Ltd and Co-Developer
of Cell-in-a-Box® and its Associated Technologies. |
| • | Dr. Mark L. Rabe – Chief Executive Officer of Rabe Medical Solutions, San Diego, California |
| • | David A. Judd - cellular biologist of 35 years and a long-term employee of the Grand Island Biological
Company with experience in culturing various types of human cells, including the cells that were transfected with the gene that
activates the prodrug ifosfamide and that are encapsulated for our LAPC clinical trial. |
Financial Information Concerning Geographic
Areas
We had no revenues in the fiscal years
ended April 30, 2019 and 2018, including no revenues from foreign countries. We have long-lived assets, other than financial instruments,
located in the following geographical areas:
| | |
FY 2019 | | |
FY 2018 | |
| United States: | |
$ | 5,128,992 | | |
$ | 5,128,992 | |
| All foreign countries, in total: | |
$ | 0 | | |
$ | 0 | |
We operate globally and are attempting
to develop products in multiple countries. Consequently, we face complex legal and regulatory requirements in multiple jurisdictions,
which may expose us to certain financial and other risks. International operations are subject to a variety of risks, including:
| • | foreign currency exchange rate fluctuations; |
| • | greater difficulty in overseeing foreign operations; |
| • | logistical and communications challenges; |
| • | potential adverse changes in laws and regulatory practices, including export license requirements,
trade barriers, tariffs and tax laws; |
| • | burdens and costs of compliance with a variety of foreign laws; |
| • | political and economic instability; |
| • | increases in duties and taxation; |
| • | foreign tax laws and potential increased costs associated with overlapping tax structures; |
| • | greater difficulty in protecting intellectual property; |
| • | the risk of third-party disputes over ownership of intellectual property and infringement of third-party
intellectual property by our product candidates; and |
| • | general social, economic and political conditions in these foreign markets. |
We are dependent on business relationships
with parties in multiple countries, as disclosed in Item 1A. “Risk Factors—Risks Related to Our Dependence on Third
Parties.”
ITEM 1A. RISK FACTORS
You should carefully consider these
factors that may affect future results, together with all the other information included in this Report in evaluating our business.
The risks and uncertainties described below are those that we currently believe may materially affect our business and results
of operations. Additional risks and uncertainties that we are unaware of or that we currently deem immaterial also may become
important factors that affect our business and results of operations. Our shares of common stock involve a high degree of
risk and should be purchased only by investors who can afford a loss of their entire investment. Prospective investors should carefully
consider the following risk factors concerning our business before making an investment.
In addition, you should carefully consider
these risks when you read “forward-looking” statements elsewhere in this Report. These are statements that relate to
our expectations for future events and time periods. Generally, the words “anticipate,” “expect,” “intend,”
and similar expressions identify forward-looking statements. Forward-looking statements involve risks and uncertainties, and future
events and circumstances could differ significantly from those anticipated in the forward-looking statements. For additional information,
see “Cautionary Note Regarding Forward-Looking Statements.”
Risks Related to Our Financial Position,
Need for Additional Capital and Overall Business
We have a short operating history,
a relatively new business model and have not produced any revenues in our current business model. This makes it difficult to evaluate
our prospects and increases the risk that we will not be successful.
We have a short operating history with
our current business model. Our current operations have produced no revenues and may not produce revenues in the near term
or at all, which may harm our ability to obtain additional financing and may require us to reduce or discontinue our operations.
If we create revenues in the future, we will derive most of these revenues from the sale of product candidates. You must consider
our business and prospects considering the risks and difficulties we will encounter as an early-stage biotech company in a new
and rapidly evolving biotech sector. We may not be able to successfully address these risks and difficulties, which could significantly
harm our business, operating results and financial condition.
We have incurred significant losses
since our inception and anticipate that we will continue to incur losses in the future.
We are a clinical stage biotechnology company
focused on developing and preparing to commercialize cellular therapies for cancer and diabetes based upon a proprietary cellulose-based
live cell encapsulation technology known as “Cell-in-a-Box®.” In recent years, we have devoted substantially all
our resources to the development of our product candidates. We have generated significant operating losses since our inception.
Our net losses for the years ended April 30, 2019 and 2018 were approximately $4.1 million and $6.8 million, respectively. As of
April 30, 2019, we had an accumulated deficit of approximately $100 million. Substantially all our losses have resulted from expenses
incurred relating to our research and development programs and from general and administrative expenses and operating losses associated
with our business.
We expect to continue to incur significant
expenses and operating losses for the foreseeable future. We anticipate these losses will increase as we continue the research
and development of, and clinical trials for, our product candidates. In addition to budgeted expenses, we may encounter unforeseen
expenses, difficulties, complications, delays and other unknown factors that may adversely affect our business. If either any of
our product candidates fail in clinical trials or do not gain regulatory approval, or even if approved, fail to achieve market
acceptance, we may never become profitable. Even if we achieve profitability in the future, we may not be able to sustain profitability
in subsequent periods.
We currently have no commercial revenue
and may never become profitable.
Even if we can successfully achieve regulatory
approval for our product candidates, we do not know what the reimbursement status of our product candidates will be or when any
of these products will generate revenue for us, if at all. We have not generated, and do not expect to generate, any product revenue
for the foreseeable future. We expect to continue to incur significant operating losses for the foreseeable future due to the cost
of research and development, preclinical studies and clinical trials and the regulatory approval process for our product candidates.
The amount of future losses is uncertain and will depend, in part, on the rate of growth of our expenses.
Our ability to generate revenue from our
product candidates also depends on numerous additional factors, including our ability to:
| • | successfully complete development activities, including the remaining preclinical studies and planned
clinical trials for our product candidates; |
| • | complete and submit NDAs to the FDA and MAAs to the EMA, and obtain regulatory approval for indications
for which there is a commercial market; |
| • | complete and submit applications to, and obtain regulatory approval from, other foreign regulatory
authorities; |
| • | manufacture any approved products in commercial quantities and on commercially reasonable terms; |
| • | develop a commercial organization, or find suitable partners, to market, sell and distribute approved
products in the markets in which we have retained commercialization rights; |
| • | achieve acceptance among patients, clinicians and advocacy groups for any products we develop; |
| • | obtain coverage and adequate reimbursement from third parties, including government payors; and |
| • | set a commercially viable price for any products for which we may receive approval. |
We are unable to predict the timing or
amount of increased expenses, or when or if we will be able to achieve or maintain profitability. Even if we can complete the processes
described above, we anticipate incurring significant costs associated with commercializing our product candidates.
To date, we have generated no revenue.
Our ability to generate revenue and become profitable depends upon our ability to obtain regulatory approval for, and successfully
commercialize our product candidates that we may develop, in-license or acquire in the future.
We will need additional capital to
continue our business plans.
We will need additional capital to continue
our operations. As of April 30, 2019, we had approximately $515,000 in our bank accounts. There can be no assurance that we will
obtain sufficient capital on acceptable terms, if at all. Failure to obtain such capital would have an adverse impact on our financial
position, operations and ability to continue as a going concern. Our operating and capital requirements during the next fiscal
year and thereafter will vary based on several factors, including whether the FDA approves our IND when submitted allowing us to
commence our clinical trial, how quickly enrollment of patients in our planned clinical trial in LAPC can be commenced, the duration
of the clinical trial and any change in the clinical development plans for our product candidates and the outcome, timing and cost
of meeting regulatory requirements established by the FDA and the EMA or other comparable foreign regulatory authorities. There
can be no assurance that additional private or public financing, including debt or equity financing, will be available as needed
or if available, on terms favorable to us. Additionally, any future equity financing may be dilutive to stockholders’ present
ownership levels. It may also have rights, preferences, or privileges that are senior to those of our existing common stock.
Furthermore, debt financing, if available,
may require payment of interest and potentially involve restrictive covenants that could impose limitations on our flexibility
to operate. Any difficulty or failure to successfully obtain additional funding may jeopardize our ability to continue the business
and our operations.
Our future revenues are unpredictable
which causes potential fluctuations in operating results.
Because of our limited operating history
as a biotech company; we are currently unable to accurately forecast our revenues. Future expense levels will likely be based largely
on our marketing and development plans and estimates of future revenue. Any sales or operating results will likely generally depend
on volume and timing of orders, which may not occur and on our ability to fulfill such orders, which we may not be able to do.
We may be unable to adjust spending in a timely manner to compensate for any unexpected revenue shortfall. Accordingly, any significant
shortfall in revenues in relation to planned expenditures could have an immediate adverse effect on our business, prospects, financial
condition and results of operations. Further, as a strategic response to changes in the competitive environment, we may from time
to time make certain pricing, service or marketing decisions that could have a material adverse effect on our business, prospects,
financial condition and results of operations.
We may experience significant fluctuations
in future operating results due to a variety of factors, many of which are outside of our control. Factors that may affect operating
results include: (i) the ability to obtain and retain customers; (ii) our ability to attract new customers at a steady rate
and maintain customer satisfaction with products; (iii) our announcement or introduction of new products by us or our competitors;
(iv) price competition; (v) the level of use and consumer acceptance of its products; (vi) the amount and timing of operating
costs and capital expenditures relating to expansion of the business, operations and infrastructure; (vii) governmental regulations;
and (viii) general economic conditions.
We face substantial competition,
which may result in others discovering, developing or commercializing competing products before or more successfully than we do.
The development and commercialization of
new drug products is highly competitive. We face competition with respect to our current product candidates. We will face competition
with respect to any product candidates that we may seek to develop or commercialize in the future. Such competition may arise from
major pharmaceutical companies, specialty pharmaceutical companies and biotechnology companies worldwide. There are several large
pharmaceutical and biotechnology companies that currently market products or are pursuing the development of products for the treatment
of the disease indications for which we are developing our product candidates. Some of these competitive products and therapies
are based on scientific approaches that are the same as or are like our approach, and others are based on entirely different approaches.
Potential competitors also include academic institutions, government agencies and other public and private research organizations
that conduct research, seek patent protection and establish collaborative arrangements for research, development, manufacturing
and commercialization.
Specifically, there are numerous companies
developing or marketing therapies for cancer and diabetes, including many major pharmaceutical and biotechnology companies. Our
commercial opportunity could be reduced or eliminated if our competitors develop and commercialize products that are safer, more
effective, have fewer or less severe side effects, are more convenient or are less expensive than any products that we may develop.
Our competitors also may obtain regulatory approval for their products more rapidly than we may obtain approval for ours, which
could result in our competitors establishing a strong market position before we can enter the market.
Many of the companies against which we
are competing or against which we may compete in the future have significantly greater financial resources and expertise in research
and development, manufacturing, preclinical testing, conducting clinical trials, obtaining regulatory approvals and marketing approved
products than we do. Mergers and acquisitions in the pharmaceutical and biotechnology sectors may result in even more resources
being concentrated among a smaller number of our competitors. Smaller and other early-stage companies may also prove to be significant
competitors, particularly through collaborative arrangements with large and established companies. These third parties compete
with us in recruiting and retaining qualified scientific and management personnel, establishing clinical trial sites and patient
registration for clinical trials, as well as in acquiring technologies complementary to, or necessary for, our programs.
Risks Related to FDA Approval of Our
Planned Clinical Trial, Approval of Our Product Candidates and Other Legal Compliance Matters
If the FDA does not approve our IND
to begin a trial in LAPC once we submit it to the FDA or places us on clinical hold, we will not be able to commence a Phase 2b
clinical trial for LAPC in the U.S. which would likely have a material adverse effect on us.
Subject to FDA approval, we plan to commence
a Phase 2b clinical trial in LAPC. A Pre-IND meeting with CBER was held on January 17, 2017, at which the FDA provided us with
guidance to complete the IND process and communicated its agreement with certain aspects of our clinical development plan. We have
been delayed in submitting our IND to the FDA, due to guidance provided by the FDA and due to delays in preparing the materials
necessary to submit our IND. No assurance can be given whether the FDA will approve our IND once we submit it to the FDA. The FDA
may put us on a clinical hold until we satisfy its requirements to commence our clinical trial involving LAPC, which may never
occur. We cannot provide assurance as to the timing of our IND submission to the FDA and the FDA’s reaction to it. In the
event the FDA does not approve our IND, we will not be able to commence our clinical trial in LAPC which would likely have a material
adverse effect on us.
Our plan to first pursue a Phase
2b clinical trial before a pivotal Phase 3 trial will likely result in additional costs to us and resultant delays in the FDA review
process and any future commercialization and marketing, if regulatory approval is obtained.
If we can submit an IND, and that IND is
approved, we have determined that the data contained in previous clinical trial reports using the Cell-in-a-Box®
and its Associated Technologies are not enough to advance the program next to a Phase 3 pivotal trial. Therefore, we are designing
a Phase 2b clinical trial that, if successful, we believe will provide the information necessary to plan a Phase 3 pivotal trial.
Our determination to first conduct a Phase 2b clinical trial before conducting a pivotal Phase 3 clinical trial will likely result
in additional costs to us and resultant delays in the regulatory review process and any future commercialization and marketing,
if regulatory approval is obtained.
Our ability to timely submit an IND
to the FDA may depend on circumstances outside of our control.
Our ability to execute our current plan
for the completion of all activities and submission of an IND to the FDA depends on a variety of factors, some of which are
outside of our control, such as the manufacturing of our clinical trial product for our plan clinical trial for LAPC. We must submit
the results of various preclinical tests, together with manufacturing information, analytical data, any available clinical data
or literature and a proposed clinical protocol to the FDA as part of the IND. Preclinical tests include laboratory evaluations
of product chemistry and formulation, as well as other studies to assess the potential safety and activity of the pharmaceutical
product candidate. The conduct of the preclinical tests must comply with federal regulations and requirements. The FDA may require
that we conduct additional preclinical testing for any product candidate before it allows us to initiate the clinical testing under
any IND, which may lead to additional delays and increase the costs of our preclinical development. The preparation of the IND
will also involve considerable work from our employees and advisors. Should our employees and advisors not be able to complete
the preparation of the IND in a timely manner, the submission of the IND to the FDA could be delayed.
If we are unable to obtain, or if
there are delays in obtaining, required approval from the regulatory agencies, we will not be able to commercialize our product
candidates and our ability to generate revenue will be materially impaired.
Our product candidates must obtain marketing
approval from the FDA and other regulatory agencies. The process of obtaining marketing approvals in the countries in which we
intend to sell and distribute our product candidates is expensive and can take several years, if approval is obtained at all. This
process can vary substantially based upon a variety of factors, including the type, complexity and novelty of the product candidates
involved. Failure to obtain marketing approval for a product candidate will prevent us from commercializing that product candidate.
To date, we have not received approval to market any of our product candidates from regulatory agencies in any jurisdiction. We
have no experience in filing and supporting the applications necessary to gain marketing approvals and expect to rely on third-party
contract research organizations to assist us in this process. Securing marketing approval requires the submission of extensive
preclinical and clinical data and supporting information to the regulatory agencies for each product candidate to establish the
product candidate’s safety and efficacy. Securing marketing approval also requires the submission of information about the
product manufacturing process to, and inspection of manufacturing facilities by, the regulatory agencies.
Our product candidates may not be effective,
may be only moderately effective or may prove to have undesirable or unintended side effects, toxicities or other characteristics
that may preclude our obtaining marketing approval or prevent or limit commercial use. Regulatory agencies have substantial discretion
in the approval process and may refuse to accept any application or may decide that our data are insufficient for approval and
require additional preclinical, clinical or other studies. In addition, varying interpretations of the data obtained from preclinical
and clinical testing could delay, limit or prevent marketing approval of a product candidate. Changes in marketing approval policies
during the development period, changes in or the enactment of additional statutes or regulations, or changes in regulatory review
for each submitted product application, may also cause delays in or prevent the approval of an application. New cancer drugs frequently
are indicated only for patient populations that have not responded to an existing therapy or have relapsed after such therapies.
If we experience delays in obtaining approval or if we fail to obtain approval of our product candidates, the commercial prospects
for our product candidates may be harmed and our ability to generate revenues will be materially impaired.
Clinical drug development involves
a lengthy and expensive process with an uncertain outcome. We may incur additional costs or experience delays in completing or
be unable to complete the development and commercialization of our product candidates.
Our Cell-in-a-Box® and ifosfamide
combination product candidate is in clinical development, and, like others’ candidates in a similar phase of development,
the risk of failure is high. It is impossible to predict when or if this product candidate or any other product candidate will
prove effective or safe in humans or will receive regulatory approval. Before obtaining marketing approval from regulatory agencies
for the sale of any product candidate, we must complete preclinical development and then conduct extensive clinical trials to demonstrate
the safety and efficacy of our product candidates in humans. Clinical trials are expensive, difficult to design and implement,
can take several years to complete and are uncertain as to their outcome. A failure of one or more clinical trials can occur at
any stage of a clinical trial. The clinical development of our product candidates is susceptible to the risk of failure inherent
at any stage of drug development, including failure to demonstrate efficacy in a clinical trial or across a broad population of
patients, the occurrence of severe or medically or commercially unacceptable adverse events, failure to comply with protocols or
applicable regulatory requirements or determination by the regulatory agencies that a drug or biologic product is not approvable.
It is possible that even if one or more of our product candidates has a beneficial effect, that effect will not be detected during
clinical evaluation because of one or more of a variety of factors, including the size, duration, design, measurements, conduct
or analysis of our clinical trials. Conversely, because of the same factors, our clinical trials may indicate an apparent positive
effect of a product candidate that is greater than the actual positive effect, if any. Similarly, in our clinical trials we may
fail to detect toxicity of, or intolerability caused by, our product candidates, or mistakenly believe that our product candidates
are toxic or not well tolerated when that is not, in fact, the case.
The outcome of preclinical studies and
early and mid-phase clinical trials may not be predictive of the success of later clinical trials, and interim results of a clinical
trial do not necessarily predict overall results. Many companies in the pharmaceutical and biotechnology sectors have suffered
significant setbacks in late-stage clinical trials after achieving positive results in earlier stages of development, and we cannot
be certain that we will not face similar setbacks.
The design of a clinical trial can determine
whether its results will support approval of a product; however, flaws in the design of a clinical trial may not become apparent
until the clinical trial is well advanced or completed. We have limited experience in designing clinical trials and may be unable
to design and execute a clinical trial to support marketing approval. In addition, preclinical and clinical data are often susceptible
to varying interpretations and analyses. Many companies that believed their product candidates performed satisfactorily in preclinical
studies and clinical trials have nonetheless failed to obtain marketing approval for their product candidates. Even if we believe
that the results of clinical trials for our product candidates warrant marketing approval, the regulatory agencies may disagree
and may not grant marketing approval of our product candidates or may require that we conduct initial clinical studies; the latter
would require that we incur significantly increased costs and would significantly extend the clinical development timeline for
our product candidates.
In some instances, there can be significant
variability in safety or efficacy results between different clinical trials of the same product candidate due to numerous factors,
including changes in trial procedures set forth in protocols, differences in the size and type of the patient populations, changes
in and adherence to the clinical trial protocols and the rate of dropout among clinical trial participants. Any Phase 1, Phase
2 or Phase 3 clinical trial we may conduct may not demonstrate the efficacy and safety necessary to obtain regulatory approval
to market our product candidates.
We intend to seek FDA approval to
commence clinical trials in the U.S. of certain of our product candidates based on clinical data that was obtained in trials conducted
outside the U.S., and it is possible that the FDA may not accept data from trials conducted in such locations or conducted nearly
20 years ago.
We intend to seek FDA acceptance of
an IND to commence a Phase 2b clinical trial in LAPC using genetically engineered live human cells encapsulated using our
Cell-in-a-Box® technology in combination with ifosfamide. A Phase 1/2 clinical trial and a Phase 2 clinical
trial were previously conducted using the same technology in combination with ifosfamide between 1998 and 1999 and between
1999 and 2000, respectively. The Phase 1/2 clinical trial was carried out at the Division of Gastroenterology, University of
Rostock, Germany, and the Phase 2 clinical trial was carried out at four centers in two countries in Europe: Berne,
Switzerland, and in Rostock, Munich and Berlin, Germany.
Although the FDA may accept data from clinical
trials conducted outside the U.S., acceptance of this data is subject to certain conditions imposed by the FDA. There is a risk
that the FDA may not accept the data from the two previous trials. In that case, we may be required to conduct a Phase 1 or a Phase
1/2b clinical trial rather than the planned Phase 2b clinical trial in LAPC. This may result in additional costs to us and resultant
delays in the regulatory review process and any future commercialization and marketing, if regulatory approval is obtained. It
is not known whether the FDA would be likely to reject the use of such clinical data due to the significant time that has elapsed
since the earlier clinical trials were conducted or because the clinical trial material for our proposed Phase 2b clinical trial
is different from that used in the earlier clinical trials because of cloning the cells used in the earlier trials and certain
other modifications and improvements that have been made to the Cell-in-a-Box® technology since the time of the
earlier trials.
We intend to conduct clinical trials
for certain of our product candidates at sites outside of the U.S., and the U.S. regulatory agencies may not accept data from trials
conducted in such locations.
Although the FDA may accept data from clinical
trials conducted outside the U.S., acceptance of this data is subject to certain conditions imposed by the regulatory agencies
outside of the U.S. For example, the clinical trial must be well designed and conducted and performed by qualified investigators
in accordance with ethical principles. The trial population must also adequately represent the population in the country in which
the clinical trial is being conducted. The data must be applicable to the U.S. population and medical practice in the U.S. in ways
that the FDA deems clinically meaningful. Generally, the patient population for any clinical trial conducted outside of the U.S.
must be representative of the population for whom we intend to seek approval in the U.S.
In addition, while these clinical trials
are subject to the applicable local laws, the FDA acceptance of the data will be dependent upon its determination that the trials
also complied with all applicable U.S. laws and regulations. There can be no assurance that the FDA will accept data from trials
conducted outside of the U.S. If the FDA does not accept the data from any of our clinical trials that we determine to conduct
outside the U.S., it would likely result in the need for additional trials that would be costly and time-consuming and delay or
permanently halt the development of our product candidate.
In addition, the conduct of clinical trials
outside the U.S. could have a significant impact on us. Risks inherent in conducting international clinical trials include:
| • | Foreign regulatory requirements that could restrict or limit our ability to conduct our clinical
trials; |
| • | Administrative burdens of conducting clinical trials under multiple foreign regulatory schemes; |
| • | Foreign exchange fluctuations; and |
| • | Diminished protection of intellectual property in some countries. |
If clinical trials of our product
candidates fail to demonstrate safety and efficacy to the satisfaction of the regulatory agencies, we may incur additional costs
or experience delays in completing or be unable to complete the development and commercialization of these product candidates.
We are not permitted to commercialize,
market, promote or sell any product candidate in the U.S. without obtaining marketing approval from the FDA. Comparable regulatory
agencies outside of the U.S., such as the EMA in the European Union, impose similar restrictions. We may never receive such approvals.
We may be required to complete additional preclinical development and clinical trials to demonstrate the safety and efficacy of
our product candidates in humans before we will be able to obtain these approvals.
Clinical testing is expensive, difficult
to design and implement, can take many years to complete and is inherently uncertain as to outcome. We have not previously submitted
an NDA, a BLA or a MAA to regulatory agencies for any of our product candidates.
Any inability to successfully complete
preclinical and clinical development could result in additional costs to us and impair our ability to generate revenues from product
sales, regulatory and commercialization milestones and royalties. In addition, if: (i) we are required to conduct additional clinical
trials or other testing of our product candidates beyond the trials and testing that we contemplate; (ii) we are unable to successfully
complete our planned clinical trials of our product candidates or other testing; (iii) the results of these trials or tests are
unfavorable, uncertain or are only modestly favorable; or (iv) there are unacceptable safety concerns associated with our product
candidates, we, in addition to incurring additional costs, may:
| · | Be delayed in obtaining marketing approval for our product candidates; |
| · | Not obtain marketing approval at all; |
| · | Obtain approval for indications or patient populations that are not
as broad as we intended or desired; |
| · | Obtain approval with labeling that includes significant use or distribution
restrictions or significant safety warnings, including “black-box” warnings; |
| · | Be subject to additional post-marketing testing or other requirements;
or |
| · | Be required to remove the product from the market after obtaining
marketing approval. |
Promising results in previous clinical
trials of our encapsulated live cell and ifosfamide combination for pancreatic cancer may not be replicated in future clinical
trials which could result in development delays or a failure to obtain marketing approval.
Positive results in the previous Phase
1/2 and Phase 2 clinical trials of the encapsulated live cell and ifosfamide combination product may not be predictive of similar
results in future clinical trials such as our planned Phase 2b clinical trial in LAPC. The previous Phase 1/2 and Phase 2 clinical
trials had a relatively limited number of patients in each trial. These trials resulted in outcomes that were not statistically
significant and may not be representative of future results. In addition, interim results obtained after a clinical trial has commenced
do not necessarily predict results. Numerous companies in the pharmaceutical and biotechnology industries have suffered significant
setbacks in late-stage clinical trials even after achieving promising results in early-stage clinical development. Our clinical
trials may produce negative or inconclusive results and we may decide, or regulatory agencies may require us, to conduct additional
clinical trials. Moreover, clinical data are often susceptible to varying interpretations and analyses, and many companies that
believed their product candidates performed satisfactorily in preclinical studies and clinical trials have nonetheless failed to
obtain the approval for their products by the regulatory agencies.
If we experience any unforeseen events
in the clinical trials of our product candidates, potential marketing approval or commercialization of our product candidates could
be delayed or prevented.
We may experience numerous unforeseen events
during our clinical trials that could delay or prevent marketing approval of our product candidates, including:
| · | Clinical trials of our product candidates
may produce unfavorable or inconclusive results; |
| · | We may decide, or regulators may require
us, to conduct additional clinical trials or abandon product development programs or candidates; |
| · | The number of patients required for clinical
trials of our product candidates may be larger than we anticipate, patient enrollment in these clinical trials may be slower than
we anticipate, or participants may drop out of these clinical trials at a higher rate than we anticipate; |
| · | Our third-party contractors, including
those manufacturing our product candidates or components or ingredients thereof or conducting clinical trials on our behalf, may
fail to comply with regulatory requirements or meet their contractual obligations to us in a timely manner or at all; |
| · | Regulators or IRBs may not authorize us
or our investigators to commence a clinical trial or conduct a clinical trial at a prospective trial site; |
| · | We may experience delays in reaching or
may fail to reach agreement on acceptable clinical trial contracts or clinical trial protocols with prospective trial sites; |
| · | Patients who enroll in a clinical trial
may misrepresent their eligibility to do so or may otherwise not comply with the clinical trial protocol, resulting in the need
to drop the patients from the clinical trial, increase the needed enrollment size for the clinical trial or extend the clinical
trial’s duration; |
| · | We may have to suspend or terminate clinical
trials of our product candidates for various reasons, including a finding that the participants are being exposed to unacceptable
health risks, undesirable side effects or other unexpected characteristics of a product candidate; |
| · | Regulatory agencies or IRBs may require
that we or our investigators suspend or terminate clinical research for various reasons, including noncompliance with regulatory
requirements or their respective standards of conduct, a finding that the participants are being exposed to unacceptable health
risks, undesirable side effects or other unexpected characteristics of the product candidate or findings of undesirable effects
caused by a chemically or mechanistically similar drug or drug candidate; |
| · | Regulatory agencies may disagree with
our clinical trial design or our interpretation of data from preclinical studies and clinical trials; |
| · | Regulatory agencies may fail to approve
or subsequently find fault with the manufacturing processes or facilities of third-party manufacturers with which we enter agreements
for clinical and commercial supplies; |
| · | The supply or quality of raw materials
or manufactured product candidates or other materials necessary to conduct clinical trials of our product candidates may be insufficient,
inadequate, delayed, or not available at an acceptable cost, or we may experience interruptions in supply; and |
| · | The approval policies or regulations of
the regulatory agencies may significantly change in a manner rendering our clinical data insufficient to obtain marketing approval. |
Product development costs for us will increase
if we experience delays in testing or pursuing marketing approvals. We may also be required to obtain additional funds to complete
clinical trials and prepare for possible commercialization of our product candidates. We do not know whether any preclinical studies
or clinical trials will begin as planned, will need to be restructured or will be completed on schedule or at all. Significant
preclinical study or clinical trial delays also could shorten any periods during which we may have the exclusive right to commercialize
our product candidates or allow our competitors to bring products to market before we do and impair our ability to successfully
commercialize our product candidates and may harm our business and results of operations. In addition, many of the factors that
cause, or lead to, clinical trial delays may ultimately lead to the denial of marketing approval of any of our product candidates.
If we experience delays or difficulties
in the enrollment of patients in clinical trials, we may not achieve our clinical development timeline and our receipt of necessary
regulatory approvals could be delayed or prevented.
We may not be able to initiate or continue
clinical trials for our product candidates if we are unable to locate and enroll enough eligible patients to participate in our
clinical trials. Patient enrollment is a significant factor in the overall duration of a clinical trial and is affected by many
factors, including:
The size and nature of the patient population;
| • | The severity of the disease under investigation; |
| • | The proximity of patients to clinical sites; |
| • | The eligibility criteria for the trial; |
| • | The design of the clinical trial; |
| • | Efforts to facilitate timely enrollment; |
| • | Competing clinical trials for the same patient population; and |
| • | Clinicians’ and patients’ perceptions as to the potential advantages and risks of the
drug being studied in relation to other available therapies, including any new drugs that may be approved for the indications we
are investigating. |
Our inability to enroll enough patients
for our clinical trials could result in significant delays or may require us to abandon one or more clinical trials altogether.
Enrollment delays in our clinical trials may result in increased development costs for our product candidates, delay or halt the
development of and approval processes for our product candidates and jeopardize our ability to achieve our clinical development
timeline and goals, including the dates by which we will commence, complete and receive results from clinical trials. Enrollment
delays may also delay or jeopardize our ability to commence sales and generate revenues from our product candidates. Any of the
foregoing could cause the value of our company to decline and limit our ability to obtain additional financing, if needed.
We may request priority review for
our product candidates in the future. The regulatory agencies may not grant priority review for any of our product candidates.
Moreover, even if the regulatory agencies designated such products for priority review, that designation may not lead to a faster
regulatory review or approval process and, in any event, may not assure approval by the regulatory agencies.
We may be eligible for priority review
designation for our product candidates if the regulatory agencies determine such product candidates offer major advances in treatment
or provide a treatment where no adequate therapy exists. A priority review designation means that the time required for the regulatory
agencies to review an application is less than the standard review period. The regulatory agencies have broad discretion with respect
to whether to grant priority review status to a product candidate, so even if we believe a product candidate is eligible for such
designation or status, the regulatory agencies may decide not to grant it. Thus, while the regulatory agencies have granted priority
review to other oncology and diabetes products, our product candidates, should we determine to seek priority review of them, may
not receive similar designation. Moreover, even if one of our product candidates is designated for priority review, such a designation
does not necessarily mean a faster overall regulatory review process or necessarily confer any advantage with respect to approval
compared to conventional procedures of the regulatory agencies. Receiving priority review from the regulatory agencies does not
guarantee approval within an accelerated timeline or thereafter.
In some instances, we believe we
may be able to secure approval from the regulatory agencies to use accelerated development pathways. If we are unable to obtain
such approval, we may be required to conduct additional preclinical studies or clinical trials beyond those that we contemplate
which could increase the expense of obtaining and delay the receipt of necessary marketing approvals.
We anticipate that we may seek an accelerated
approval pathway for certain of our product candidates. Under the accelerated approval provisions or their implementing regulations
of the regulatory agencies, they may grant accelerated approval to a product designed to treat a serious or life-threatening condition
that provides meaningful therapeutic benefit over available therapies upon a determination that the product influences a surrogate
endpoint or intermediate clinical endpoint that is reasonably likely to predict clinical benefit. Regulatory agencies consider
a clinical benefit to be a positive therapeutic effect that is clinically meaningful in the context of a given disease, such as
irreversible morbidity or mortality. For the purposes of accelerated approval, a surrogate endpoint is a marker, such as a laboratory
measurement, radiographic image, physical sign or other measure that is thought to predict clinical benefit but is not itself a
measure of clinical benefit. An intermediate clinical endpoint is a clinical endpoint that can be measured earlier than an effect
on irreversible morbidity or mortality that is reasonably likely to predict an effect on irreversible morbidity or mortality or
other clinical benefit. The accelerated approval pathway may be used in cases in which the advantage of a new drug over available
therapy may not be a direct therapeutic advantage but is a clinically important improvement from a patient and public health perspective.
If granted, accelerated approval is usually contingent on the sponsor’s agreement to conduct, in a diligent manner, additional
post-approval confirmatory studies to verify and describe the drug’s clinical benefit. If such post-approval studies fail
to confirm the drug’s clinical benefit, regulatory agencies may withdraw their approval of the drug.
Prior to seeking such accelerated approval,
we will seek feedback from the regulatory agencies and will otherwise evaluate our ability to seek and receive such accelerated
approval. There can also be no assurance that after our evaluation of the feedback and other factors we will decide to pursue or
submit an NDA, a BLA or an MAA for accelerated approval or any other form of expedited development, review or approval. Similarly,
there can be no assurance that after subsequent feedback from regulatory agencies that we will continue to pursue or apply for
accelerated approval or any other form of expedited development, review or approval, even if we initially decide to do so. Furthermore,
if we decide to apply for accelerated approval or under another expedited regulatory designation (such as the Breakthrough Therapy
designation or Fast Track designation), there can be no assurance that such submission or application will be accepted or that
any expedited development, review or approval will be granted on a timely basis or at all. Regulatory agencies could also require
us to conduct further studies prior to considering our application or granting approval of any type. A failure to obtain accelerated
approval or any other form of expedited development, review or approval for any of our product candidates that we determine to
seek accelerated approval for would result in a longer time to commercialization of such product candidate, could increase the
cost of development of such product candidate and could harm our competitive position in the marketplace.
We may seek Orphan Drug designation
for some of our product candidates, and we may be unsuccessful.
Regulatory agencies may designate drugs
for relatively small patient populations as Orphan Drugs. Under the standards and requirements of regulatory agencies, they may
designate a product as an Orphan Drug if it is a drug intended to treat a rare disease or condition. In the U.S., this is generally
defined as a disease with a patient population of fewer than 200,000 individuals. If a product with an Orphan Drug designation
subsequently receives the first marketing approval for the indication for which it has such designation, the product is entitled
to a period of marketing exclusivity, which precludes the EMA or FDA from approving another marketing application for the same
drug for the same indication during the period of exclusivity. The applicable period is seven years in the U.S. and ten years in
Europe. The European exclusivity period can be reduced to six years if a drug no longer meets the criteria for Orphan Drug designation
or if the drug is sufficiently profitable so that market exclusivity is no longer justified.
We have been granted Orphan Drug designation
for our pancreatic cancer therapy in the U.S. and European Union. Orphan Drug exclusivity may be lost if a regulatory agency determines
that the request for designation was materially defective or if the manufacturer is unable to assure sufficient quantity of the
drug to meet the needs of patients with the rare disease or condition. Marketing exclusivity for a product designated as an Orphan
Drug may not effectively protect the product candidate from competition because different drugs can be approved for the same condition.
Even after an Orphan Drug is approved, the regulatory agency can subsequently approve a different drug for the same condition if
they conclude that the later drug is clinically superior in that it is shown to be safer, more effective or makes a major contribution
to patient care.
A Fast Track by the FDA or similar
designation by another regulatory agency, even if granted for any of our product candidates, may not lead to a faster development
or regulatory review or approval process and does not increase the likelihood that our product candidates will receive marketing
approval.
We do not currently have Fast Track designation
by the FDA or similar designation by another regulatory agency for any of our product candidates but intend to seek such designation
based upon the data generated from our clinical trials, if successful. If a drug or biologic is intended for the treatment of a
serious or life-threatening condition and the product candidate demonstrates the potential to address unmet medical needs for this
condition, the sponsor may apply for Fast Track designation by the FDA or similar designation by another regulatory agency. Regulatory
agencies have broad discretion whether to grant this designation by the FDA or similar designation by another regulatory agency.
Even if we believe a product candidate is eligible for this designation, we cannot assure you that a regulatory agency would decide
to grant it. Even if we do receive Fast Track or similar designation, we may not experience a faster development process, review
or approval compared to conventional procedures adopted by a regulatory agency. In addition, a regulatory agency may withdraw Fast
Track designation if it believes that the designation is no longer supported by data from our clinical development program. Many
product candidates that have received Fast Track designation have failed to obtain marketing approval.
A Breakthrough Therapy designation
by the FDA or similar designation by another regulatory agency, even if granted for any of our product candidates, may not lead
to a faster development or regulatory review or approval process and does not increase the likelihood that our product candidates
will receive marketing approval.
We do not currently have Breakthrough Therapy
designation by the FDA or similar designation by another regulatory agency for any of our product candidates but intend seek such
designation based upon the data we generate during our clinical trials, if successful.
A Breakthrough Therapy or similar designation
is within the discretion of the FDA and other regulatory agencies. Accordingly, even if we believe, after completing early clinical
trials, that one of our product candidates meets the criteria for designation as a Breakthrough Therapy or other similar designation,
a regulatory agency may disagree and instead determine not to make such designation. In any event, the receipt of a Breakthrough
Therapy or other similar designation for a product candidate may not result in a faster development process, review or approval
compared to drugs or biologics considered for approval under conventional procedures of a regulatory agency and does not assure
their ultimate approval. In addition, even if one or more of our product candidates receives Breakthrough Therapy designation or
other similar designations, a regulatory agency may later decide that such product candidates no longer meet the conditions for
the designation.
\
Failure to obtain marketing approval
in international jurisdictions would prevent our product candidates from being marketed abroad.
To market and sell our product candidates
in Europe and many other jurisdictions outside the U.S., we or our third-party collaborators must obtain separate marketing approvals
and comply with numerous and varying regulatory requirements. The approval procedure varies among countries and can involve additional
testing. The time required to obtain approval may differ substantially from that required to obtain FDA approval in the U.S. The
regulatory approval process outside the U.S. generally includes all the risks associated with obtaining FDA approval. In addition,
in many countries outside the U.S., it is required that the product be approved for reimbursement before the product can be approved
for sale in that country. We or these third parties may not obtain approval from a regulatory agency outside the U.S. on a timely
basis, if at all. Approval by FDA does not ensure approval by a regulatory agency in other countries or jurisdictions, and approval
by one regulatory agency outside the U.S. does not ensure approval by a regulatory agency in other countries or jurisdictions or
by the FDA. We may not be able to file for marketing approvals and may not receive necessary approvals to commercialize our product
candidates in any market.
Any product candidate for which we
obtain marketing approval will be subject to extensive post-marketing regulatory requirements and could be subject to post-marketing
restrictions or withdrawal from the market. We may be subject to penalties if we fail to comply with regulatory requirements or
if we experience unanticipated problems with our products, when and if any of our product candidates are approved.
Our product candidates and the activities
associated with their development and commercialization, including their testing, manufacture, recordkeeping, labeling, storage,
approval, advertising, promotion, sale and distribution, are subject to comprehensive regulation by regulatory agencies. The requirements
that result from such regulations include submissions of safety and other post-marketing information and reports, registration
and listing requirements, cGMP requirements relating to manufacturing, quality control, quality assurance and corresponding maintenance
of records and documents, including periodic inspections by regulatory agencies, requirements regarding the distribution of samples
to physicians and recordkeeping.
In addition, regulatory agencies may impose
requirements for costly post-marketing studies or clinical trials and surveillance to monitor the safety or efficacy of a product
candidate. Regulatory agencies closely regulate the post-approval marketing and promotion of drugs to ensure drugs are marketed
only for the approved indications and in accordance with the provisions of the approved labeling. They also impose stringent restrictions
on manufacturers’ communications regarding use of their products. If we promote our product candidates beyond their approved
indications, we may be subject to enforcement action for off-label promotion. Violations of the laws relating to the promotion
of prescription drugs may lead to investigations alleging violations of federal and state healthcare fraud and abuse laws, as well
as state consumer protection laws.
Also, later discovery of previously unknown
adverse events or other problems with our product candidates, manufacturers or manufacturing processes, or failure to comply with
regulatory requirements, may yield various results, including:
| • | Restrictions on such products, manufacturers or manufacturing processes; |
| • | Restrictions on the labeling or marketing of a product; |
| • | Restrictions on product distribution or use; |
| • | Requirements to conduct post-marketing studies or clinical trials; |
| • | Warning or untitled letters; |
| • | Withdrawal of the products from the market; |
| • | Refusal to approve pending applications or supplements to approved applications that we submit; |
| • | Fines, restitution or disgorgement of profits or revenues; |
| • | Suspension or withdrawal of marketing approvals; |
| • | Refusal to permit the import or export of our product candidates; |
| • | Injunctions or the imposition of civil or criminal penalties |
Non-compliance with European requirements
regarding safety monitoring or pharmacovigilance, and with requirements related to the development of products for the pediatric
population, can also result in significant financial penalties. Similarly, failure to comply with the Europe’s requirements
regarding the protection of personal information can also lead to significant penalties and sanctions.
Our relationships with customers
and third-party payors will be subject to applicable anti-kickback, fraud and abuse and other healthcare laws and regulations,
which could expose us to criminal sanctions, substantial civil penalties, contractual damages, reputational harm and diminished
profits and future earnings.
Healthcare providers, physicians and third-party
payors will play a primary role in the recommendation and prescription of any product candidates for which we obtain marketing
approval. Our future arrangements with third-party payors and customers may expose us to broadly applicable federal and state fraud
and abuse and other healthcare laws and regulations that may constrain the business or financial arrangements and relationships
through which we market, sell and distribute any products for which we obtain marketing approval. Restrictions under applicable
healthcare laws and regulations include the following:
The Anti-Kickback Statute prohibits, among other things,
persons from knowingly and willfully soliciting, offering, receiving or providing any remuneration, directly or indirectly, in
cash or in kind, to induce or reward, or in return for, either the referral of an individual for, or the purchase, order or recommendation
of, any good or service, for which payment may be made under a federal healthcare program such as Medicare and Medicaid;
The False Claims Act imposes criminal and civil penalties, including
civil whistleblower or qui tam actions, against individuals or entities for knowingly presenting, or causing to be presented,
to the federal government, claims for payment that are false or fraudulent or making a false statement to avoid, decrease or conceal
an obligation to pay money to the Federal governments; and
HIPAA imposes criminal and civil liability for executing
a scheme to defraud any healthcare benefit program or making false statements relating to healthcare matters. HIPAA, as amended
by HITECH and its implementing regulations, also imposes obligations, including mandatory contractual terms, with respect to safeguarding
the privacy, security and transmission of individually identifiable health information. Federal law requires applicable manufacturers
of covered drugs to report payments and other transfers of value to physicians and teaching hospitals, which includes data collection
and reporting obligations. The information is to be made publicly available on a searchable website. Analogous state and foreign
laws and regulations, such as state anti-kickback and false claims laws, may apply to sales or marketing arrangements and claims
involving healthcare items or services reimbursed by non-governmental third-party payors, including private insurers.
Some state laws require pharmaceutical
companies to comply with the pharmaceutical industry’s voluntary compliance guidelines and the relevant compliance guidance
promulgated by the federal government and may require drug manufacturers to report information related to payments and other transfers
of value to physicians and other healthcare providers or marketing expenditures. State and foreign laws also govern the privacy
and security of health information in some circumstances, many of which differ from each other in significant ways and often are
not preempted by HIPAA, thus complicating compliance efforts.
Efforts to ensure that our business arrangements
with third parties will comply with applicable healthcare laws and regulations will involve substantial costs. It is possible that
governmental authorities will conclude that our business practices may not comply with current or future statutes, regulations
or case law involving applicable fraud and abuse or other healthcare laws and regulations. If our operations are found to be in
violation of any of these laws or any other governmental regulations that may apply to us, we may be subject to significant civil,
criminal and administrative penalties, damages, fines, imprisonment, exclusion of our product candidates from government funded
healthcare programs, such as Medicare and Medicaid, and the curtailment or restructuring of our operations. If any of the physicians
or other healthcare providers or entities with whom we expect to do business is found to be not in compliance with applicable laws,
they may be subject to criminal, civil or administrative sanctions, including exclusions from government funded healthcare programs.
Recently enacted and future legislation
could increase the difficulty and cost for us to obtain marketing approval of and commercialize our product candidates and affect
the prices we may obtain.
In the U.S. and some foreign jurisdictions,
there have been a several legislative and regulatory changes and proposed changes regarding the healthcare system that could prevent
or delay marketing approval of our product candidates, restrict or regulate post-approval activities and affect our ability to
profitably sell any product candidates for which we obtain marketing approval.
In March 2010, former President Obama signed
into law the Affordable Care Act, a sweeping law intended to broaden access to health insurance, reduce or constrain the growth
of healthcare spending, enhance remedies against fraud and abuse, add new transparency requirements for the healthcare and health
insurance industries, impose new taxes and fees on the health industry and impose additional health policy reforms. Among the provisions
of the Affordable Care Act of importance to our potential product candidates are the following:
| • | An annual, nondeductible fee on any entity that manufactures, or imports specified branded prescription
drugs and biologic agents; |
| • | An increase in the statutory minimum rebates a manufacturer must pay under the Medicaid Drug Rebate
Program; |
| • | Expansion of healthcare fraud and abuse laws, including the False Claims Act and the Anti-Kickback
Statute, new government investigative powers and enhanced penalties for noncompliance; |
| • | A new Medicare Part D coverage gap discount program in which manufacturers must agree to offer
50% point-of-sale discounts off negotiated prices; |
| • | Extension of manufacturers’ Medicaid rebate liability; |
| • | Expansion of eligibility criteria for Medicaid programs; |
| • | Expansion of the entities eligible for discounts under the Public Health Service pharmaceutical
pricing program; |
| • | New requirements to report financial arrangements with physicians and teaching hospitals; |
| • | A new requirement to annually report drug samples that manufacturers and distributors provide to
physicians; and |
| • | A new Patient-Centered Outcomes Research Institute to oversee, identify priorities in and conduct
comparative clinical effectiveness research, along with funding for such research. |
In addition, other legislative changes
have been proposed and adopted since the Affordable Care Act was enacted. These changes included aggregate reductions to Medicare
payments to providers of up to 2% per fiscal year, starting in 2013. In January 2013, former President Obama signed into law the
American Taxpayer Relief Act of 2012, which, among other things, reduced Medicare payments to several providers and increased the
statute of limitations period for the government to recover overpayments to providers from three to five years. These laws may
result in additional reductions in Medicare and other healthcare funding.
We expect that the Affordable Care Act,
as well as other healthcare reform measures that may be adopted in the future, may result in more rigorous coverage criteria and
in additional downward pressure on the price that we receive for any approved product. Any reduction in reimbursement from Medicare
or other government programs may result in a similar reduction in payments from private payors. The implementation of cost containment
measures or other healthcare reforms may prevent us from being able to generate revenue, attain profitability or commercialize
our product candidates.
Any reduction in reimbursement from Medicare
or other government programs may result in a similar reduction in payments from private payors. The implementation of cost containment
measures or other healthcare reforms may compromise our ability to generate revenue, attain profitability or commercialize our
products. At the same time, there have been significant ongoing efforts to modify or eliminate the Affordable Care Act. For example,
the Tax Act, enacted on December 22, 2017, repealed the shared responsibility payment for individuals who fail to maintain minimum
essential coverage under section 5000A of the Internal Revenue Code, commonly referred to as the individual mandate, beginning
in 2019. The Joint Committee on Taxation estimates that the repeal will result in over 13 million Americans losing their health
insurance coverage over the next ten years and is likely to lead to increases in insurance premiums. Further legislative changes
to and regulatory changes under the Affordable Care Act remain possible. It is unknown what form any such changes or any law proposed
to replace the Affordable Care Act would take, and how or whether it may affect our business in the future.
Newly enacted FDA regulations may require
us to expend additional resources to obtain or maintain regulatory approval. For example, in August 2017 President Trump signed
into law the FDARA. This legislation imposes significant new requirements for clinical trial sponsors which will affect, among
other things, the development of drugs and biological products for pediatric use. This legislation may result in new regulations,
which may affect future options or timelines for regulatory approval.
Legislative and regulatory proposals have
been made to expand post-approval requirements and restrict sales and promotional activities for pharmaceutical products. We cannot
be sure whether additional legislative changes will be enacted, or whether FDA regulations, guidance or interpretations will be
changed, or what the impact of such changes on the marketing approvals of our product candidates, if any, may be. In addition,
increased scrutiny by the U.S. Congress of FDA’s approval process may significantly delay or prevent marketing approval in
the U.S., as well as subject us to more stringent product labeling and post-marketing testing and other requirements.
Governments outside the U.S. tend
to impose strict price controls, which may adversely affect our revenues, if any.
In some countries, particularly the countries
of the European Union, the pricing of prescription pharmaceuticals is subject to governmental control. In these countries, pricing
negotiations with governmental authorities can take considerable time after the receipt of marketing approval for a product. To
obtain reimbursement or pricing approval in some countries, we may be required to conduct a clinical trial that compares the cost-effectiveness
of our product candidate to other available therapies. If reimbursement of our product candidates is unavailable or limited in
scope or amount, or if pricing is set at unsatisfactory levels, our business could be materially harmed.
Risks Related to the Commercialization
of Our Product Candidates
Serious adverse events or undesirable
side effects or other unexpected properties of our encapsulated live cell plus ifosfamide product candidate or any of our other
product candidates may be identified during development that could delay or prevent the product candidates’ marketing approval.
Serious adverse events or undesirable side
effects caused by, or other unexpected properties of, our product candidates could cause us, an IRB or a regulatory agency to interrupt,
delay or halt clinical trials of one or more of our product candidates and could result in a more restrictive label or the delay
or denial of marketing approval by a regulatory agency. If any of our product candidates is associated with serious adverse events
or undesirable side effects or has properties that are unexpected, we may need to abandon development or limit development of that
product candidate to certain uses or subpopulations in which the undesirable side effects or other characteristics are less prevalent,
less severe or more acceptable from a risk-benefit perspective. Many compounds that initially showed promise in clinical or earlier
stage testing have later been found to cause undesirable or unexpected side effects that prevented further development of the compound.
Even if one of our product candidates
receives marketing approval, it may fail to achieve the degree of market acceptance by physicians, patients, third party payors
and others in the medical community necessary for commercial success and the market opportunity for the product candidate may be
smaller than we anticipated.
We have never commercialized a drug product.
Even if one of our product candidates is approved by a regulatory agency for marketing and sale, it may nonetheless fail to gain
sufficient market acceptance by physicians, patients, third party payors and others in the medical community. For example, physicians
are often reluctant to switch their patients from existing therapies even when new and potentially more effective or convenient
treatments enter the market. Further, patients often acclimate to the therapy that they are currently taking and do not want to
switch unless their physicians recommend switching products or they are required to switch therapies due to lack of reimbursement
for existing therapies.
Efforts to educate the medical community
and third-party payors on the benefits of our product candidates may require significant resources and may not be successful. If
any of our product candidates is approved but does not achieve an adequate level of market acceptance, we may not generate significant
revenues and we may not become profitable.
The degree of market acceptance of our
encapsulated live cell plus ifosfamide product candidate or any of our other product candidates, if approved for commercial sale,
will depend on several factors, including:
| • | The efficacy and safety of the product; |
| • | The potential advantages of the product compared to alternative treatments; |
| • | The prevalence and severity of any side effects; |
| • | The clinical indications for which the product is approved; |
| • | Whether the product is designated under physician treatment guidelines as a first-line therapy
or as a second- or third-line therapy; |
| • | Limitations or warnings, including distribution or use restrictions, contained in the product’s
approved labeling; |
| • | Our ability to offer the product for sale at competitive prices; |
| • | Our ability to establish and maintain pricing sufficient to realize a meaningful return on our
investment; |
| • | The product’s convenience and ease of administration compared to alternative treatments; |
| • | The willingness of the target patient population to try, and of physicians to prescribe, the product; |
| • | The strength of sales, marketing and distribution support; |
| • | The approval of other new products for the same indications; |
| • | Changes in the standard of care for the targeted indications for the product; |
| • | The timing of market introduction of our approved products as well as competitive products and
other therapies; |
| • | Availability and amount of reimbursement from government payors, managed care plans and other third-party
payors; |
| • | Adverse publicity about the product or favorable publicity about competitive products; and |
| • | Potential product liability claims. |
The potential market opportunities for
our product candidates are difficult to estimate precisely. Our estimates of the potential market opportunities are predicated
on many assumptions, including industry knowledge and publications, third party research reports and other surveys. While we believe
that our internal assumptions are reasonable, these assumptions involve the exercise of significant judgment on the part of our
management, are inherently uncertain and the reasonableness of these assumptions has not been assessed by an independent source.
If any of the assumptions proves to be inaccurate, the actual markets for our product candidates could be smaller than our estimates
of the potential market opportunities.
If any of our product candidates
receives marketing approval and we or others later discover that the therapy is less effective than previously believed or causes
undesirable side effects that were not previously identified, our ability to market the therapy could be compromised.
Clinical trials of our product candidates
are conducted in carefully defined subsets of patients who have agreed to enter a clinical trial. Consequently, it is possible
that our clinical trials may indicate an apparent positive effect of a product candidate that is greater than the actual positive
effect, if any, or alternatively fail to identify undesirable side effects. If, following approval of a product candidate, we or
others discover that the product candidate is less effective than previously believed or causes undesirable side effects that were
not previously identified, any of the following adverse events could occur:
| • | A regulatory agency may withdraw its approval of the product candidate or seize the product candidate; |
| • | We may be required to recall the product candidate or change the way the product is administered; |
| • | Additional restrictions may be imposed on the marketing of, or the manufacturing processes for,
the product candidate; |
| • | We may be subject to fines, injunctions or the imposition of civil or criminal penalties; |
| • | A regulatory agency may require the addition of labeling statements, such as a “black box”
warning or a contraindication; |
| • | We may be required to create a Medication Guide outlining the risks of the previously unidentified
side effects for distribution of our product candidate to patients; |
| • | We could be sued and held liable for harm caused to patients; |
| • | The product candidate may become less competitive; and |
| • | Our reputation may suffer. |
Any of these events could have a material
and adverse effect on our operations and business and could adversely impact our stock price.
If we are unable to establish sales,
marketing and distribution capabilities or enter acceptable sales, marketing and distribution arrangements with third parties,
we may not be successful in commercializing any product candidate that we develop when a product candidate is approved.
We do not have any sales, marketing or
distribution infrastructure and have no experience in the sale, marketing or distribution of pharmaceutical products. To achieve
commercial success for any approved product candidate, we must either develop a sales and marketing organization, outsource these
functions to third parties or license our product candidates to others. If approved by the FDA, the EMA or comparable foreign regulatory
agencies, we expect to license our encapsulated live cell plus ifosfamide product candidate for pancreatic cancer to a large pharmaceutical
company with greater resources and experience than us.
We may not be able to license our encapsulated
live cell plus ifosfamide product candidate on reasonable terms, if at all. If other product candidates are approved for smaller
or easily targeted markets, we expect to commercialize them in the U.S. directly with a small and highly focused commercialization
organization. The development of sales, marketing and distribution capabilities will require substantial resources and will be
time-consuming, which could delay any product candidate launch.
We expect that we will commence the development
of these capabilities prior to receiving approval of any of our product candidates. If the commercial launch of a product candidate
for which we recruit a sales force and establish marketing and distribution capabilities is delayed or does not occur for any reason,
we could have prematurely or unnecessarily incurred these commercialization costs. Such a delay may be costly, and our investment
could be lost if we cannot retain or reposition our sales and marketing personnel.
In addition, we may not be able to hire
or retain a sales force in the U.S. that is sufficient in size or has adequate expertise in the medical markets that we plan to
target. If we are unable to establish or retain a sales force and marketing and distribution capabilities, our operating results
may be adversely affected. If a potential partner has development or commercialization expertise that we believe is particularly
relevant to one of our product candidates, then we may seek to collaborate with that potential partner even if we believe we could
otherwise develop and commercialize the product candidate independently.
We expect to seek one or more strategic
partners for commercialization of our product candidates outside the U.S. Because of entering arrangements with third parties to
perform sales, marketing and distribution services, our product revenues or the profitability of these product revenues may be
lower, perhaps substantially lower, than if we were to directly market and sell products in those markets. Furthermore, we may
be unsuccessful in entering the necessary arrangements with third parties or may be unable to do so on terms that are favorable
to us. In addition, we may have little or no control over such third parties and any of them may fail to devote the necessary resources
and attention to sell and market our product candidates effectively.
If we do not establish sales and marketing
capabilities, either on our own or in collaboration with third parties, we will not be successful in commercializing any of our
product candidates that receive marketing approval.
Risks Related to Our Dependence on Third
Parties
We rely and expect to continue to
rely heavily on third parties to conduct our preclinical studies and clinical trials, and those third parties may not perform satisfactorily,
including failing to meet deadlines for the completion of such studies and trials.
We currently rely on third parties to conduct
the planning for our clinical trials. We expect to continue to rely heavily on third parties, such as a CRO, a clinical data management
organization, a medical institution, a clinical investigator and others to plan for and conduct our clinical trials. Our agreements
with these third parties generally allow the third party to terminate our agreement with them at any time. If we are required to
enter alternative arrangements because of any such termination, the introduction of our product candidates to market could be delayed.
Our reliance on these third parties for
research and development activities will reduce our control over these activities but will not relieve us of our responsibilities.
For example, we design our clinical trials and will remain responsible for ensuring that each is conducted in accordance with the
general investigational plan and protocol for the trial. Moreover, regulatory agencies require us to comply with cGMP standards
for conducting, recording and reporting the results of clinical trials to assure that data and reported results are credible and
accurate and that the rights, integrity and confidentiality of trial participants are protected. Our reliance on third parties
that we do not control does not relieve us of these responsibilities and requirements. We also are required to register ongoing
clinical trials and post the results of completed clinical trials on a government-sponsored database of regulatory agencies within
specified timeframes. Failure to do so can result in fines, adverse publicity and civil and criminal sanctions.
Furthermore, these third parties may also
have relationships with other entities, some of which may be our competitors. If these third parties do not successfully carry
out their contractual duties, meet expected deadlines or conduct our clinical trials in accordance with the requirements of a regulatory
agency or our protocols, we will not be able to obtain, or may be delayed in obtaining, marketing approvals for our product candidates
and will not be able to, or may be delayed in our efforts to, successfully commercialize our product candidates.
We expect to rely on third parties
to store and distribute our product candidates for our clinical trials. Any performance failure on the part of such third parties
could delay clinical development or marketing approval of our product candidates or commercialization of our products, producing
additional losses and depriving us of potential product candidate revenue. Our existing collaboration with universities and institutions
is important to our business. If we are unable to maintain these collaborations, or if these collaborations are not successful,
our business could be adversely affected.
We rely on the University of Veterinary
Medicine Vienna, UTS, the University of Barcelona, University of Copenhagen, Ludwig Maximilian University, Heidelberg University,
VIVIT, Austrianova, Vin-de-Bona and University of Northern Colorado for a substantial portion of our research and development,
including reliance on their employees whom we fund to conduct preclinical development of our product candidates. If there are delays
or failures to perform their obligations, our product candidates would be adversely affected. If our collaboration with these universities
and institutions is unsuccessful or is terminated, we would need to identify new research and collaboration partners for our preclinical
and clinical development. If we are unsuccessful or significantly delayed in identifying new collaboration and research partners,
or unable to reach an agreement with such a partner on commercially reasonable terms, development of our product candidates will
suffer, and our business would be materially harmed.
Furthermore, if any of these universities
or institutions change their strategic focus, or if external factors cause any one of them to divert resources from our collaboration,
or if any one of them independently develops products that compete directly or indirectly with our product candidates using resources
or information it acquires from our collaboration, our business and results of operations could suffer.
Future preclinical and clinical development
collaborations may be important to us. If we are unable to maintain these collaborations, or if these collaborations are not successful,
our business could be adversely affected.
For some of our product candidates, we
may in the future determine to collaborate with pharmaceutical and biotechnology companies for development of our product candidates.
We face significant competition in seeking appropriate collaborators. Our ability to reach a definitive agreement for any collaboration
will depend, among other things, upon our assessment of the collaborator’s resources and expertise, the terms and conditions
of the proposed collaboration and the proposed collaborator’s evaluation of several factors. If we are unable to reach agreements
with suitable collaborators on a timely basis, on acceptable terms, or at all, we may have to curtail the development of a product
candidate, reduce or delay its development program or one or more of our other development programs, delay our potential development
schedule or increase our expenditures and undertake preclinical and clinical development activities at our own expense. If we fail
to enter collaborations and do not have sufficient funds or expertise to undertake the necessary development activities, we may
not be able to further develop our product candidates or continue to develop our product candidates and our business may be materially
and adversely affected.
Future collaborations we may enter may
involve the following risks:
| • | Collaborators may have significant discretion in determining the efforts and resources that they
will apply to these collaborations; |
| • | Collaborators may not perform their obligations as expected; |
| • | Changes in the collaborators’ strategic focus or available funding, or external factors,
such as an acquisition, may divert resources or create competing priorities; |
| • | Collaborators may delay discovery and preclinical development, provide insufficient funding for
product development of targets selected by us, stop or abandon preclinical or clinical development of a product candidate or must
repeat or conduct new preclinical and clinical development of a product candidate; |
| • | Collaborators could independently develop, or develop with third parties, products that compete
directly or indirectly with our products or product candidates if the collaborators believe that competitive products are more
likely to be successfully developed than ours; |
| • | Product candidates may be viewed by our collaborators as competitive with their own product candidates
or products, which may cause collaborators to cease to devote resources to the development of our product candidates; |
| • | Disagreements with collaborators, including disagreements over proprietary rights, contract interpretation
or the preferred course of development might cause delays or termination of the preclinical or clinical development or commercialization
of product candidates. This might lead to additional responsibilities for us with respect to product candidates, or might result
in litigation or arbitration, any of which would be time-consuming and expensive; |
| • | Collaborators may not properly maintain or defend our intellectual property rights or intellectual
property rights licensed to us or may use our proprietary information in such a way as to invite litigation that could jeopardize
or invalidate our intellectual property or proprietary information or expose us to potential litigation; |
| • | Collaborators may infringe the intellectual property rights of third parties, which may expose
us to litigation and potential liability; and |
| • | Collaborations may be terminated at the convenience of the collaborator and, if terminated, we
could be required to raise additional capital to pursue further development or commercialization of our product candidates. |
In addition, subject to its contractual
obligations to us, if a collaborator of ours is involved in a business combination, the collaborator might deemphasize or terminate
the development of any of our product candidates. If one of our collaborators terminates its agreement with us, we may find it
more difficult to attract new collaborators and our perception in the business and financial communities could be adversely affected.
If we are unable to maintain our collaborations, development of our product candidates could be delayed, and we may need additional
resources to develop them.
We rely on Dr. Günzburg, Dr.
Salmons and Dr. Löhr for the development of our product candidates. If they decide to terminate their relationship with us,
we may not be successful in the development of our product candidates.
Dr. Günzburg, Dr. Salmons and Dr.
Löhr are involved in almost all our scientific endeavors underway and being planned by us. These endeavors include preclinical
and clinical studies involving our cancer therapy to be conducted in the U.S. and elsewhere on our behalf. In addition, they will
be assisting us in the development of a treatment for diabetes. Dr. Günzburg, Dr. Salmons and Dr. Löhr are fulfilling
prominent roles in our Diabetes Consortium. They provide professional consulting services to us through the respective consulting
agreements we have entered with the consulting companies through which they provide services. The consulting agreements may be
terminated for any reason at any time upon one party giving the other a written notice prior to the effective date of the termination.
If that occurs, we may not be successful in the development of our product candidates which could have a material adverse effect
on us.
We contract with third parties for
the manufacture of our product candidates for preclinical studies and clinical trials and expect to continue to do so for commercialization.
This reliance on third parties increases the risk that we will not have sufficient quantities of our product candidates or such
quantities at an acceptable cost, which could delay, prevent or impair our development or commercialization efforts.
We do not currently own or operate manufacturing
facilities to produce clinical quantities of our encapsulated live cell and ifosfamide product for pancreatic cancer and other
encapsulated product candidates and have limited personnel with manufacturing experience. We currently rely on and expect to continue
to rely on third party contract manufacturers to manufacture supplies of our product candidates for preclinical studies and clinical
trials, as well as for commercial manufacture of our product candidates, and these must be maintained for us to receive marketing
approval for our product candidates.
Our encapsulated live cell and ifosfamide
product and our other product candidates must be manufactured through complex, multi-step synthetic processes that are time-consuming
and involve special conditions at certain stages. Biologics and drug substance manufacture requires high potency containment, and
containment under aseptic conditions. Any performance failures on the part of our existing or future manufacturers could delay
clinical development or marketing approval of our product candidates. Moreover, the facilities that produce our Cell-in-a-Box®
capsules are unique to us and would not be replicable or replaceable promptly, if at all, if those facilities become unavailable
or are damaged or destroyed through an accident, natural disaster, labor disturbance or otherwise.
Our agreements with our third-party manufacturers
can be terminated by us or such manufacturers on short notice. If any of our manufacturers should become unavailable to us for
any reason, we may incur additional cost or delay in identifying or qualifying replacements. In addition, while we believe that
our existing manufacturer, Austrianova, can produce our product candidates, if approved, in commercial quantities, we may also
need to identify a third-party manufacturer capable of providing commercial quantities of our product candidates. If we are unable
to arrange for such a third-party manufacturing source or fail to do so on commercially reasonable terms and in a timely manner,
we may not be able to successfully produce and market our encapsulated live cell and ifosfamide product or any other product candidate
or may be delayed in doing so.
Even if we can establish such arrangements
with third party manufacturers, reliance on third party manufacturers entails additional risks, including:
| • | Reliance on the third party for regulatory compliance and quality assurance; |
| • | The possible breach of the manufacturing agreement by the third party; |
| • | The possible misappropriation of our proprietary information, including our trade secrets and know-how;
and |
| • | The possible termination or nonrenewal of the agreement by the third party at a time that is costly
or inconvenient for us. |
Third-party manufacturers may not be able
to comply with cGMP standards or the requirements of a regulatory agency. Our failure, or the failure of our third-party manufacturers,
to comply with these practices or requirements could result in sanctions being imposed on us, including clinical holds, fines,
injunctions, civil penalties, delays, suspension or withdrawal of approvals, license revocation, seizures or recalls of product
candidates or products, operating restrictions and criminal prosecutions, any of which could significantly and adversely affect
supplies of our product candidates.
Delays in the cGMP certification of the
Austrianova manufacturing facility in Bangkok, Thailand could affect its ability to manufacture encapsulated live cells on a timely
basis and could adversely affect supplies of our product candidates for clinical trials and to market.
Our product candidates that we may develop
may compete with other product candidates and products for access to manufacturing facilities. There are a limited number of manufacturers
that operate under cGMP regulations and that might be capable of manufacturing for us.
In addition, we expect to rely on our manufacturers
to purchase from third-party suppliers the materials necessary to produce our product candidates for our clinical studies. There
are a small number of suppliers for certain equipment and raw materials that are used in the manufacture of our product candidates.
Such suppliers may not sell these raw materials to our manufacturers at the times we need them or on commercially reasonable terms.
For example, there is from time to time a limited supply of acceptable cell media for production of our MCB and WCB. We do not
have any control over the process or timing of the acquisition of these raw materials by Eurofins or Austrianova. Moreover, we
currently do not have any agreements for the commercial production of these raw materials. Any significant delay in the supply
of a product candidate or the raw material components thereof for an ongoing clinical trial due to the need to replace a third-party
supplier of these raw materials could considerably delay completion of our clinical studies, product testing and potential regulatory
approval of our product candidates. If Eurofins, Austrianova or we are unable to purchase these raw materials after regulatory
approval has been obtained for our product candidates, the commercial launch of our product candidates would be delayed or there
would be a shortage in supply, which would impair our ability to generate revenues from the sale of our product candidates.
Our current and anticipated future dependence
upon Austrianova and others for the manufacture of our product candidates may adversely affect our future profit margins and our
ability to commercialize any products that receive marketing approval on a timely and competitive basis.
Risks Related to Our Intellectual Property
If we are unable to obtain and maintain
intellectual property protection for our technology and products, or if the scope of the intellectual property protection obtained
is not sufficiently broad, our competitors could develop and commercialize technology and products similar or identical to ours,
and our ability to commercialize successfully our technology and products may be impaired.
Our success depends in large part on our
ability to obtain and maintain patent protection in the U.S. and other countries with respect to our proprietary technology and
products. We seek to protect our proprietary position by filing patents in the U.S. and abroad related to our product candidates.
Our patent portfolio relating to the Cell-in-the-Box® technology was formerly licensed from Bavarian Nordic/GSF.
The Bavarian Nordic/GSF patents covered capsules encapsulating cells expressing cytochrome P450 and treatment methods using the
same. These patents expired on March 27, 2017. We exclusively license from UTS patented Melligen cells, which cover our product
candidate for the treatment of diabetes. Currently, we do not have any issued patents in any countries covering our product candidate
for the treatment of cancer, and we only have one pending U.S. provisional application, one patent application and one PCT application
relating to our product candidate for the treatment of cancer.
We filed a provisional patent application
with the USPTO on March 21, 2017 to protect our therapy to treat cancer. The application is designed to cover the same countries
in which Bavarian Nordic obtained patent protection, with a relation back date of March 21, 2017. On March 21, 2018, we filed a
U.S. patent application and a PCT application to protect our therapy to treat cancer. We do not know if any of the claims set forth
in our patent applications will be granted patent protection by the USPTO or by any other regulatory authority in other countries
in which we seek patent protection.
We cannot estimate the financial or other
impact of the expiration of the Bavarian Nordic/GSF patents or the failure of the USPTO or similar regulatory authorities in other
countries denying the claims we pursue in the U.S. and other countries.
The patent prosecution and/or patent maintenance
process is expensive and time-consuming. We may not be able to file and prosecute or maintain all necessary or desirable patent
applications or maintain the existing patents at a reasonable cost or in a timely manner. We may choose not to seek patent protection
for certain innovations and may choose not to pursue patent protection in certain jurisdictions. Under the laws of certain jurisdictions,
patents or other intellectual property rights may be unavailable or limited in scope. It is also possible that we will fail to
identify patentable aspects of our discovery and preclinical development output before it is too late to obtain patent protection.
Moreover, in some circumstances, we do
not have the right to control the preparation, filing and prosecution of patent applications, or to maintain the patents, covering
technology that we license from third parties. Therefore, these patents and applications may not be prosecuted and enforced in
a manner consistent with the best interests of our business.
The patent position of biotechnology and
pharmaceutical companies generally is highly uncertain, involves complex legal and factual questions and has in recent years been
the subject of much litigation. In addition, the laws of foreign countries may not protect our rights to the same extent as the
laws of the U.S. For example, India does not allow patents for methods of treating the human body. Publications of discoveries
in the scientific literature often lag the actual discoveries, and patent applications in the U.S. and other jurisdictions are
typically not published until 18 or more months after filing, or in some cases not at all. Therefore, we cannot know with
certainty whether we were the first to make the inventions claimed in our licensed patents or pending patent applications, or that
we were the first to file for patent protection of such inventions. Consequently, the issuance, scope, validity, enforceability
and commercial value of our patent rights are highly uncertain. Any future patent applications may not result in patents being
issued which protect our technology or products, in whole or in part, or which effectively prevent others from commercializing
competitive technologies and products. Changes in either the patent laws or interpretation of the patent laws in the U.S. and other
countries may diminish the value of our patents or narrow the scope of our patent protection.
Patent reform legislation could increase
the uncertainties and costs surrounding the prosecution of our owned or licensed patent applications and the enforcement or defense
of our owned or licensed patents. On September 16, 2011, the Leahy-Smith America Invents Act (“Leahy-Smith Act”)
was signed into law. The Leahy-Smith Act includes several significant changes to patent law in the U.S. These include provisions
that affect the way patent applications are prosecuted and may also affect patent litigation. The USPTO recently developed new
regulations and procedures to govern administration of the Leahy-Smith Act. Many of the substantive changes to patent law associated
with the Leahy-Smith Act, such as the first to file provisions, only became effective on March 16, 2013. Accordingly, it is
not clear what, if any, impact the Leahy-Smith Act will have on the operation of our business. However, the Leahy-Smith Act and
its implementation could increase the uncertainties and costs surrounding the prosecution of our owned or licensed patent applications
and the enforcement or defense of our owned or licensed patents, all of which could have a material adverse effect on our business
and financial condition.
Also, we may be subject to a third-party
pre-issuance submission of prior art to the USPTO, or become involved in opposition, derivation, reexamination, inter-party review,
post-grant review or interference proceedings challenging our patent rights or the patent rights of others. An adverse determination
in any such submission, proceeding or litigation could reduce the scope of, or invalidate, our patent rights, allow third parties
to commercialize our technology or products and compete directly with us, without payment to us, or result in our inability to
manufacture or commercialize products without infringing third-party patent rights. In addition, if the breadth or strength of
protection provided by our patents and patent applications is threatened, it could dissuade companies from collaborating with us
to license, develop or commercialize current our future product candidates.
Even if our owned and licensed patent applications
issue as patents, they may not issue in a form that will provide us with any meaningful protection, prevent competitors from competing
with us or otherwise provide us with any competitive advantage. Our competitors may be able to circumvent our owned or licensed
patents by developing similar or alternative technologies or products in a non-infringing manner.
The issuance of a patent is not conclusive
as to its inventorship, scope, validity or enforceability, and our owned and licensed patents may be challenged in the courts or
patent offices in the U.S. and abroad. Such challenges may result in loss of exclusivity or freedom to operate or in patent claims
being narrowed, invalidated or held unenforceable, in whole or in part, which could limit our ability to stop others from using
or commercializing similar or identical technology and products, or limit the duration of the patent protection of our technology
and products. Given the amount of time required for the development, testing and regulatory review of new product candidates, patents
protecting such candidates might expire before or shortly after such candidates are commercialized. Thus, our owned and licensed
patent portfolio may not provide us with sufficient rights to exclude others from commercializing products similar or identical
to ours.
The risks described elsewhere pertaining
to our patents and other intellectual property rights also apply to the intellectual property rights that we license, and any failure
to obtain, maintain and enforce these rights could have a material adverse effect on our business. In some cases, we may not have
control over the prosecution, maintenance or enforcement of the patents that we license. Moreover, our licensors may fail to take
the steps that we believe are necessary or desirable in to obtain, maintain and enforce the licensed patents. Any inability on
our part to protect adequately our intellectual property may have a material adverse effect on our business, operating results
and financial position.
If we do not obtain patent and/or data exclusivity for
our product candidates, our business may be materially harmed.
Our commercial success will largely depend
on our ability to obtain and maintain patent and other intellectual property protection and/or data exclusivity under the BPCIA
in the U.S. and other countries with respect to our proprietary technology, product candidates and our target indications.
If we are unable to obtain patents covering
our product candidates or obtain data and/or marketing exclusivity for our product candidates, our competitors may be able to take
advantage of our investment in development and clinical trials by referencing our clinical and preclinical data to obtain approval
of competing products, such as a biosimilar, earlier than might otherwise be the case.
Obtaining and maintaining our patent
protection depends on compliance with various procedural, document submission, fee payment and other requirements imposed by governmental
patent agencies. Our patent protection could be reduced or eliminated for non-compliance with these requirements.
Periodic maintenance fees, renewal fees,
annuity fees and various other governmental fees on patents and/or applications will be due to be paid to the USPTO and various
governmental patent agencies outside of the U.S. in several stages over the lifetime of the patents and/or applications. The USPTO
and various non-U.S. governmental patent agencies require compliance with numerous procedural, documentary, fee payment and other
similar provisions during the patent application process. We employ reputable law firms and other professionals to help us comply,
and in many cases, an inadvertent lapse can be cured by payment of a late fee or by other means in accordance with the applicable
rules. However, there are situations in which non-compliance can result in abandonment or lapse of the patent or patent application,
resulting in partial or complete loss of patent rights in the relevant jurisdiction. In such an event, our competitors might be
able to enter the market and this circumstance would have a material adverse effect on our business.
We may become involved in lawsuits
to protect or enforce our patents or other intellectual property, which could be expensive, time consuming and unsuccessful.
Because competition in our industry is
intense, competitors may infringe or otherwise violate our issued patents, patents of our licensors or other intellectual property.
To counter infringement or unauthorized use, we may be required to file infringement claims, which can be expensive and time-consuming.
Any claims we assert against perceived infringers could provoke these parties to assert counterclaims against us alleging that
we infringe their patents. In addition, in a patent infringement proceeding, a court may decide that a patent of ours is invalid
or unenforceable, in whole or in part, construe the patent’s claims narrowly or refuse to stop the other party from using
the technology at issue because our patents do not cover the technology in question. An adverse result in any litigation proceeding
could put one or more of the patents associated with our business at risk of being invalidated or interpreted narrowly. We may
also elect to enter license agreements to settle patent infringement claims or to resolve disputes prior to litigation, and any
such license agreements may require us to pay royalties and other fees that could be significant. Furthermore, because of the substantial
amount of discovery required in intellectual property litigation, there is a risk that some of our confidential information could
be compromised by disclosure.
If we breach any of our license or
collaboration agreements, it could compromise our development and commercialization efforts for our product candidates.
We have licensed rights to intellectual
property from third parties to commercialize our product candidates. If we materially breach or fail to perform any provision under
these license and collaboration agreements, including failure to make payments to a licensor or collaborator when due for royalties
and failure to use commercially reasonable efforts to develop and commercialize our product candidates, such licensors and collaborators
have the right to terminate our agreement, and upon the effective date of such termination, our right to practice the licensed
intellectual property would end. Any uncured, material breach under the agreements could result in our loss of rights to practice
the patent rights and other intellectual property licensed to us under the agreements.
We may need to license certain intellectual
property from third parties, and such licenses may not be available or may not be available on commercially reasonable terms.
A third party may hold intellectual property,
including patent rights, which are important or necessary to the development of our products. It may be necessary for us to use
the patented or proprietary technology of third parties to commercialize our products, in which case we would be required to obtain
a license from these third parties on commercially reasonable terms, or our business could be harmed, possibly materially. Although
we believe that licenses to these patents may be available from these third parties on commercially reasonable terms, if we were
not able to obtain a license, or are not able to obtain a license on commercially reasonable terms, our business could be harmed,
possibly materially.
Third parties may initiate legal
proceedings alleging that we are infringing their intellectual property rights, the outcome of which would be uncertain and could
have a material adverse effect on the success of our business.
Our commercial success depends upon our
ability, and the ability of our collaborators, to develop, manufacture, market and sell our product candidates and use our proprietary
technologies without infringing the proprietary rights of third parties. There is considerable intellectual property litigation
in the biotechnology and pharmaceutical industries. We may become party to, or threatened with, future adversarial proceedings
or litigation regarding intellectual property rights with respect to our products and technology, including interference or derivation
proceedings before the USPTO and various governmental patent agencies outside of the U.S. Third parties may assert infringement
claims against us based on existing patents or patents that may be granted in the future.
If we are found to infringe a third party’s
intellectual property rights, we could be required to obtain a license from such third party to continue developing and marketing
our product candidates and technology. However, we may not be able to obtain any required license on commercially reasonable terms
or at all. Even if we could obtain a license, it could be non-exclusive, thereby giving our competitors access to the same technologies
licensed to us. We could be forced, including by court order, to cease commercializing the infringing technology or product. In
addition, we could be found liable for monetary damages, including treble damages and attorneys’ fees if we are found to
have willfully infringed a patent. A finding of infringement could prevent us from commercializing our product candidates or force
us to cease some of our business operations, which could materially harm our business. Claims that we have misappropriated the
confidential information or trade secrets of third parties could have a similar negative impact on our business.
We may not be successful in obtaining
or maintaining necessary rights for its development pipeline through acquisitions and licenses from third parties.
Because our programs may involve additional
product candidates that may require the use of proprietary rights held by third parties, the growth of our business may depend
in part on our ability to acquire, in-license or use these proprietary rights. We may be unable to acquire or in-license any compositions,
methods of use or other third-party intellectual property rights from third parties that we identify. The licensing and acquisition
of third-party intellectual property rights is a competitive area, and numerous established companies are also pursuing strategies
to license or acquire third-party intellectual property rights that we may consider attractive. These established companies may
have a competitive advantage over us due to their size, cash resources and greater clinical development and commercialization capabilities.
In addition, companies that perceive us
to be a competitor may be unwilling to assign or license rights to us. We also may be unable to license or acquire third-party
intellectual property rights on terms that would allow us to make an appropriate return on our investment. If we are unable to
successfully obtain rights to required third-party intellectual property rights, our business, financial condition and prospects
for growth could suffer.
If we are unable to protect the confidentiality
of our trade secrets, our business and competitive position would be harmed.
In addition to seeking patents for some
of our technology and product candidates, we also rely on trade secrets, including unpatented know-how, technology and other proprietary
information, to maintain our competitive position. We seek to protect these trade secrets, in part, by entering non-disclosure
and confidentiality agreements with parties who have access to them, such as our employees, corporate collaborators, outside scientific
collaborators, contract manufacturers, consultants, advisors and other third parties. We seek to protect our confidential proprietary
information, in part, by entering confidentiality and invention or patent assignment agreements with our employees and consultants;
however, we cannot be certain that such agreements have been entered with all relevant parties.
Moreover, to the extent we enter such agreements,
any of these parties may breach the agreements and disclose our proprietary information, including our trade secrets to unaffiliated
third parties. We may not be able to obtain adequate remedies for such breaches. Enforcing a claim that a party illegally disclosed
or misappropriated a trade secret is difficult, expensive and time-consuming and the outcome is unpredictable. In addition, some
courts inside and outside the U.S. are less willing or unwilling to protect trade secrets. If any of our trade secrets were to
be lawfully obtained or independently developed by a competitor, we would have no right to prevent them, or those to whom they
communicate it, from using that technology or information to compete with us. If any of our trade secrets were to be disclosed
to or independently developed by a competitor, our competitive position would be harmed.
We may be subject to claims that
our employees, consultants or independent contractors have wrongfully used or disclosed confidential information of their former
employers or other third parties.
We employ individuals and use consultants
and independent contractors who were previously employed at other biotechnology or pharmaceutical companies. Although we seek to
ensure that our employees and our consultants and independent contractors do not use the proprietary information or know-how of
others in their work for us, we may be subject to claims that we or our employees, consultants or independent contractors have
inadvertently or otherwise used or disclosed trade secrets, or other confidential information of our employees’, consultants’
or independent contractors’ former employers, clients or other third parties. We may also be subject to claims that
former employers or other third parties have an ownership interest in our patents. Litigation may be necessary to defend against
these claims. There is no guarantee of success in defending these claims, and if we fail in defending any such claims, in
addition to paying monetary damages, we may lose valuable intellectual property rights, such as exclusive ownership of, or right
to use, valuable intellectual property. Even if we are successful, litigation could result in substantial cost and be a distraction
to our management and others working for us.
In addition, while it is our policy to
require our employees, consultants and independent contractors who may be involved in the development of intellectual property
to execute agreements assigning such intellectual property to us, we may be unsuccessful in executing such an agreement with each
party who in fact develops intellectual property that we regard as our own. Our and their assignment agreements may not be self-executing
or may be breached, and we may be forced to bring claims against third parties, or defend claims they may bring against us, to
determine the ownership of what we regard as our intellectual property.
If we or our licensors fail in prosecuting
or defending any such claims, in addition to paying monetary damages, we may lose valuable intellectual property rights or personnel.
Even if we and our licensors are successful in prosecuting or defending against such claims, litigation could result in substantial
costs and be a distraction to management.
Any trademarks we have obtained or
may obtain may be infringed or successfully challenged, resulting in harm to our business.
We expect to rely on trademarks as one
means to distinguish any of our drug candidates that are approved for marketing from the products of our competitors. Once we select
new trademarks and apply to register them, our trademark applications may not be approved. Third parties may oppose or attempt
to cancel our trademark applications or trademarks, or otherwise challenge our use of the trademarks. If our trademarks are successfully
challenged, we could be forced to rebrand our drugs, which could result in loss of brand recognition and could require us to devote
resources to advertising and marketing new brands. Our competitors may infringe our trademarks and we may not have adequate resources
to enforce our trademarks.
Intellectual property rights do not
necessarily address all potential threats to our competitive advantage.
The degree of future protection afforded
by our intellectual property rights is uncertain because intellectual property rights have limitations, and may not adequately
protect our business, or permit us to maintain our competitive advantage. The following examples are illustrative:
| • | others may be able to make formulations or compositions that are the same as or like our product
candidates, but that are not covered by the claims of any patents that we may own or exclusively license; |
| • | others may be able to make product that is like the product candidates we intend to commercialize
that is not covered by any patents that we might own or exclusively license and have the right to enforce; |
| • | we, our licensors or any collaborators might not have been the first to make the inventions covered
by issued patents or pending patent applications that we may own; |
| • | we, our licensors or any collaborators might not have been the first to file patent applications
covering certain of our inventions; |
| • | others may independently develop similar or alternative technologies or duplicate any of our technologies
without infringing our intellectual property rights; |
| • | it is possible that our pending patent applications will not lead to issued patents; |
| • | issued patents that we may own may not provide us with any competitive advantages, or may be held
invalid or unenforceable because of legal challenges; |
| • | our competitors might conduct research and development activities in the U.S. and other countries
that provide a safe harbor from patent infringement claims for certain research and development activities, as well as in countries
where we do not have patent rights, and then use the information learned from such activities to develop competitive products for
sale in our major commercial markets; and |
| • | we may not develop additional proprietary technologies that are patentable. |
Additional Risks Related to Our Business
Model and Operations
Development of brand awareness is
critical to our success.
For certain market segments that we plan
to pursue, the development of our brand awareness is essential for us to reduce our marketing expenditures over time and realize
greater benefits from marketing expenditures. If our brand-marketing efforts are unsuccessful, growth prospects, financial condition
and results of operations would be adversely affected. Our brand awareness efforts have required, and will most likely continue
to require, additional expenses and time of the current senior management team.
Any weakness in our internal controls
could have a material adverse effect on us.
As discussed in Item 9A. “Controls
and Procedures,” the senior management has identified material weaknesses in our internal controls over financial reporting
and cannot assure you that additional material weaknesses will not be identified in the future. We cannot assure you that these
steps will be successful in preventing material weaknesses or significant deficiencies in our internal controls over financial
reporting in the future. In addition, any such failure could adversely affect our ability to report financial results on a timely
and accurate basis, which could have other material effects on our business, reputation, results of operations, financial condition
or liquidity. Material weaknesses in internal controls over financial reporting or disclosure controls and procedures could also
cause investors to lose confidence in our reported financial information which could have an adverse effect on the trading price
of our securities.
Our success depends on additional
states legalizing medical Cannabis.
Continued development of the medical Cannabis
market is dependent upon continued legislative authorization of Cannabis at the state level for medical purposes. Any number
of factors could slow or halt the progress. Further, progress, while encouraging, is not assured and the process normally encounters
set-backs before achieving success. While there may be ample public support for legislative proposal, key support must be created
in the legislative committee or a bill may never advance to a vote. Numerous factors impact the legislative process. Any one of
these factors could slow or halt the progress and adoption of Cannabis for medical purposes, which would limit the market
for our product candidates that are based on Cannabis constituents and negatively impact our business in this area.
Medicinal Cannabis faces strong opposition.
Certain well-funded and significant businesses
may have a strong economic opposition to the medical Cannabis industry. Lobbying by groups within the pharmaceutical industry
or changes in the regulation of Cannabis-based therapies could affect our ability to develop and market cannabinoid-based
cancer therapies.
Our product candidates involving
Cannabis will be subject to controlled substance laws and regulations. Failure to receive necessary approvals may delay the launch
of our products and failure to comply with these laws and regulations may adversely affect the results of our business operations.
Our product candidates involving Cannabis
contain controlled substances as defined in the CSA. Controlled substances that are pharmaceutical products are subject to a high
degree of regulation under the CSA, which establishes, among other things, certain registration, manufacturing quotas, security,
recordkeeping, reporting, import, export and other requirements administered by the DEA. The DEA classifies controlled substances
into five schedules: Schedule I, II, III, IV or V substances. Schedule I substances by definition have a high potential
for abuse, have no currently “accepted medical use” in the U.S., lack accepted safety for use under medical supervision,
and may not be prescribed, marketed or sold in the U.S. Pharmaceutical products approved for use in the U.S. may be listed as Schedule II,
III, IV or V, with Schedule II substances considered to present the highest potential for abuse or dependence and Schedule V
substances the lowest relative risk of abuse among such substances. Schedule I and II drugs are subject to the strictest controls
under the CSA, including manufacturing and procurement quotas, security requirements and criteria for importation. In addition,
dispensing of Schedule II drugs is further restricted. For example, they may not be refilled without a new prescription.
While Cannabis is a Schedule I
controlled substance, products approved for medical use in the U.S. that contain Cannabis or Cannabis extracts
must be placed in Schedules II - V, since approval by the FDA satisfies the “accepted medical use” requirement.
If we receive FDA approval for a product candidate involving Cannabis, the DEA will make a scheduling determination and
place it in a schedule other than Schedule I for it to be prescribed to patients in the U.S. If approved by the FDA, we expect
the product candidates to be listed by the DEA as a Schedule II or III controlled substance. Consequently, their manufacture,
importation, exportation, domestic distribution, storage, sale and legitimate use will be subject to a significant degree of regulation
by the DEA. The scheduling process may take one or more years beyond FDA approval, thereby significantly delaying the launch of
our product candidates involving Cannabis. Furthermore, if the FDA, DEA or any foreign regulatory authority determines that
our product candidates involving Cannabis may have potential for abuse, it may require us to generate more clinical data
than that which is currently anticipated, which could increase the cost and/or delay the launch of such products.
Because one or more of our product candidates
contain active ingredients of Cannabis, which are Schedule I substances, to conduct preclinical studies and clinical
trials with these product candidates in the U.S. prior to approval, each of our research sites must submit a research protocol
to the DEA and obtain and maintain a DEA researcher registration that will allow those sites to handle and dispense our product
candidates and to obtain the product from our manufacturer. If the DEA delays or denies the grant of a research registration to
one or more research sites, the preclinical studies or clinical trials could be significantly delayed, and we could lose and be
required to replace clinical trial sites, resulting in additional costs.
Individual states have also established
controlled substance laws and regulations. Though state-controlled substance laws often mirror federal law, because the states
are separate jurisdictions, they may separately schedule our product candidates involving Cannabis as well. While some states
automatically schedule a drug based on federal action, other states schedule drugs through rulemaking or a legislative action.
State scheduling may delay commercial sale of any product for which we obtain federal regulatory approval and adverse scheduling
could have a material adverse effect on the commercial attractiveness of such product. We or our partners must also obtain separate
state registrations, permits or licenses to be able to obtain, handle, and distribute controlled substances for clinical trials
or commercial sale, and failure to meet applicable regulatory requirements could lead to enforcement and sanctions by the states
in addition to those from the DEA or otherwise arising under federal law.
Because of these risks, no assurance can
be given that our Cannabis therapy under development will be successful.
The insurance coverage and reimbursement
status of newly-approved products are uncertain. Failure to obtain or maintain adequate coverage and reimbursement for new or current
products could limit our ability to market those products and decrease our ability to generate revenue.
The availability and extent of reimbursement
by governmental and private payors is essential for most patients to be able to afford expensive treatments. Sales of our product
candidates will depend substantially, both domestically and abroad, on the extent to which the costs of our product candidates
will be paid by health maintenance, managed care, pharmacy benefit and similar healthcare management organizations, or reimbursed
by government health administration authorities, private health coverage insurers and other third-party payors. If reimbursement
is not available, or is available only to limited levels, we may not be able to successfully commercialize our product candidates.
Even if coverage is provided, the approved reimbursement amount may not be high enough to allow us to establish or maintain pricing
sufficient to realize a sufficient return on our investment.
There is significant uncertainty related
to the insurance coverage and reimbursement of newly approved products. In the U.S., the principal decisions about reimbursement
for new medicines are typically made by the CMS, an agency within the HHS. CMS decides whether and to what extent a new medicine
will be covered and reimbursed under Medicare. Private payors tend to follow CMS to a substantial degree. It is difficult to predict
what CMS will decide with respect to reimbursement for fundamentally novel products such as ours, as there is no body of established
practices and precedents for these new products. Reimbursement agencies in Europe may be more conservative than CMS. For example,
several cancer drugs have been approved for reimbursement in the U.S. and have not been approved for reimbursement in certain European
countries. Outside the U.S., international operations are generally subject to extensive governmental price controls and other
market regulations, and we believe the increasing emphasis on cost-containment initiatives in Europe, Canada and other countries
has and will continue to put pressure on the pricing and usage of our product candidates. In many countries, the prices of medical
products are subject to varying price control mechanisms as part of national health systems. In general, the prices of medicines
under such systems are substantially lower than in the U.S. Other countries allow companies to fix their own prices for medicines
but monitor and control company profits. Additional foreign price controls or other changes in pricing regulation could restrict
the amount that we can charge for our product candidates. Accordingly, in markets outside the U.S., the reimbursement for our products
may be reduced compared with the U.S. and may be insufficient to generate commercially reasonable revenues and profits.
Moreover, increasing efforts by governmental
and third-party payors, in the U.S. and abroad, to cap or reduce healthcare costs may cause such organizations to limit both coverage
and level of reimbursement for new products approved and, thus, they may not cover or provide adequate payment for our product
candidates. We expect to experience pricing pressures with the sale of any of our product candidates, due to the trend toward managed
healthcare, the increasing influence of health maintenance organizations and additional legislative changes. The downward pressure
on healthcare costs in general, particularly prescription drugs and surgical procedures and other treatments, has become very intense.
Because of this, increasingly high barriers are being erected to the entry of new products into the healthcare market.
In addition to CMS and private payors,
professional organizations such as the National Comprehensive Cancer Network and the American Society of Clinical Oncology can
influence decisions about reimbursement for new medicines by determining standards for care. Many private payors may also contract
with commercial vendors who sell software that provide guidelines that attempt to limit utilization of, and therefore reimbursement
for, certain products deemed to provide limited benefit to existing alternatives. Such organizations may set guidelines that limit
reimbursement or utilization of our products.
Healthcare legislation, including
potentially unfavorable pricing regulations or other healthcare reform initiatives, may increase the difficulty and cost for us
to obtain marketing approval of and commercialize our product candidates.
In the U.S., there have been numerous legislative
and regulatory changes and proposed changes regarding the healthcare system that could prevent or delay marketing approval of our
product candidates, restrict or regulate post-approval activities or affect our ability to profitably sell any product candidates
for which we obtain marketing approval. The Affordable Care Act, among other things, imposes a significant annual fee on companies
that manufacture or import branded prescription drug products. It also contains substantial provisions intended to broaden access
to health insurance, reduce or constrain the growth of healthcare spending, enhance remedies against healthcare fraud and abuse,
add new transparency requirements for the healthcare and health insurance industries, impose new taxes and fees on pharmaceutical
and medical device manufacturers, and impose additional health policy reforms, any of which could negatively impact our business.
A significant number of provisions are not yet, or have only recently become effective, but the Affordable Care Act is likely to
continue the downward pressure on pharmaceutical and medical device pricing, especially under the Medicare program, and may also
increase our regulatory burdens and operating costs.
In addition, other legislative changes
have been proposed and adopted since passage of the Affordable Care Act. The Budget Control Act of 2011, among other things, created
the Joint Select Committee to recommend to Congress proposals in spending reductions. The Joint Select Committee did not achieve
a targeted deficit reduction of an amount greater than $1.2 trillion for the fiscal years 2012 through 2021, triggering the legislation’s
automatic reduction to several government programs. This included aggregate reductions to Medicare payments to healthcare providers
of up to 2.0% per fiscal year, which went into effect in April 2013. In January 2013, former President Obama signed into law the
American Taxpayer Relief Act of 2012, which, among other things, reduced Medicare payments to several categories of healthcare
providers and increased the statute of limitations period for the government to recover overpayments to providers from three to
five years. At the same time, there have been significant ongoing efforts to modify or eliminate the Affordable Care Act. For example,
the Tax Act, enacted on December 22, 2017, repealed the shared responsibility payment for individuals who fail to maintain minimum
essential coverage under section 5000A of the Internal Revenue Code, commonly referred to as the individual mandate, beginning
in 2019. The Joint Committee on Taxation estimates that the repeal will result in over 13 million Americans losing their health
insurance coverage over the next ten years and is likely to lead to increases in insurance premiums. Further legislative changes
to and regulatory changes under the Affordable Care Act remain possible. It is unknown what form any such changes or any law proposed
to replace the Affordable Care Act would take, and how or whether it may affect our business in the future.
Newly enacted FDA regulations may require
us to expend additional resources to obtain or maintain regulatory approval. For example, in August 2017 President Trump signed
into law the Food & Drug Administration Reauthorization Act. This legislation imposes significant new requirements for clinical
trial sponsors which will affect, among other things, the development of drugs and biological products for pediatric use. This
legislation may result in new regulations, which may affect future options or timelines for regulatory approval.
If we ever obtain regulatory approval and
successfully commercialize any of our product candidates, these laws may result in additional reductions in Medicare and other
healthcare funding, which could have a material adverse effect on our future customers, patients and third-party payors and, accordingly,
our financial operations.
We expect that the Affordable Care Act,
as well as other healthcare reform measures that have been and may be adopted in the future, may result in more rigorous coverage
criteria and in additional downward pressure on the price that we receive for any approved product, and could seriously harm our
future revenue. Any reduction in reimbursement from Medicare or other government programs may result in a similar reduction in
payments from private payors. The implementation of cost containment measures or other healthcare reforms may compromise our ability
to generate revenue, attain profitability or commercialize our products.
Our employees, consultants and independent
contractors may engage in misconduct or other improper activities, including noncompliance with regulatory standards and requirements,
which could subject us to significant liability and harm our reputation.
We are exposed to the risk of fraud and
other misconduct by those who work for us. Misconduct by employees, consultants or independent contractors could include failures
to comply with the FCPA or with the DEA, the FDA or the EMA regulations or similar regulations of other foreign regulatory authorities
or to provide accurate information to the DEA, the FDA, the EMA or other foreign regulatory authorities. In addition, misconduct
could include failures to comply with certain manufacturing standards, to comply with U.S. federal and state healthcare fraud and
abuse laws and regulations and similar laws and regulations established and enforced by comparable foreign regulatory authorities,
to report financial information or data accurately or to disclose unauthorized activities to us. Misconduct by those who work for
us could also involve the improper use of information obtained during our clinical trials, which could result in regulatory sanctions
and serious harm to our reputation. We have implemented and will enforce a Code of Business Conduct and Ethics, but it is not always
possible to identify and deter misconduct by those who work for us. The precautions we take to detect and prevent this activity
may not be effective in controlling unknown or unmanaged risks or losses or in protecting us from governmental investigations or
other actions or lawsuits stemming from a failure to comply with such laws or regulations. If any such actions are instituted against
us, and we are not successful in defending ourselves or asserting our rights, those actions could have a significant impact on
our business and results of operations, including the imposition of significant fines or other sanctions.
Our transactions and relationships
outside the U.S. will be subject to the FCPA and similar anti-bribery and anti-corruption laws.
As we pursue international clinical trials,
licensing and, in the future, sales arrangements outside the U.S., we will be heavily regulated and expect to have significant
interaction with foreign officials. Additionally, in many countries outside the U.S., the health care providers who prescribe pharmaceuticals
are employed by the government and the purchasers of pharmaceuticals are government entities; therefore, our interactions with
these prescribers and purchasers would be subject to regulation under the FCPA and similar anti-bribery or anti-corruption laws,
regulations or rules of other countries in which we operate. The FCPA generally prohibits paying, offering or authorizing payment
or offering of anything of value, directly or indirectly, to any foreign official, political party or candidate to influence official
action, or otherwise obtain or retain business. The FCPA also requires public companies to make and keep books and records that
accurately and fairly reflect the transactions of the corporation and to devise and maintain an adequate system of internal accounting
controls.
Compliance with these laws and regulations
may be costly and may limit our ability to expand into certain markets. There is no certainty that all our employees, agents, contractors,
or collaborators, or those of our affiliates, will comply with all applicable laws and regulations, particularly given the high
level of complexity of these laws and regulations. Violations of these laws and regulations could result in fines, criminal sanctions
against us, our officers, or our employees, the closing down of our facilities, requirements to obtain export licenses, cessation
of business activities in sanctioned countries, implementation of compliance programs and prohibitions on the conduct of our business.
Any such violations could include prohibitions on our ability to offer our products in one or more countries and could materially
damage our reputation, our brand, our international expansion efforts, our ability to attract and retain employees and our business,
prospects, operating results and financial condition.
Product liability lawsuits against
us could cause us to incur substantial liabilities and to limit commercialization of any products that we may develop.
We face an inherent risk of product liability
exposure related to the testing of our product candidates in human clinical trials and will face an even greater risk if we commercially
sell any products that we may develop. If we cannot successfully defend ourselves against claims that our product candidates or
products caused injuries, we will incur substantial liabilities. Regardless of merit or eventual outcome, liability claims may
result in:
| • | Decreased demand for any product candidates or products that we may develop; |
| • | Injury to our reputation and significant negative media attention; |
| • | Withdrawal of clinical trial participants; |
| • | Significant costs to defend the related litigation; |
| • | Substantial monetary awards to trial participants or patients; |
| • | Reduced resources of our management to pursue our business strategy; and |
| • | The inability to commercialize any products that we may develop. |
We currently do not have product liability
insurance because we do not have any products to market. We will need such insurance as we commence a clinical trial or if we commence
commercialization of our product candidates. Insurance coverage is increasingly expensive. We may not be able to maintain insurance
coverage at a reasonable cost or in an amount adequate to satisfy any liability that may arise.
We incur increased costs because
of operating as a public company, and our management is required to devote substantial time to new compliance initiatives.
As a public company, we have incurred and
are continuing to incur significant legal, accounting and other expenses. These expenses may increase. We are subject to, among
others, the reporting requirements of the Exchange Act of 1934, as amended (“Exchange Act”), the Sarbanes-Oxley Act,
the Dodd-Frank Wall Street Reform and Protection Act, as well as rules adopted, and to be adopted, by the Commission. Our management
and other personnel devote a substantial amount of time to these compliance initiatives.
Moreover, these rules and regulations have substantially
increased our legal and financial compliance costs and made some activities more time-consuming and costlier. The
increased costs have increased our net loss. These rules and regulations may make it more difficult and
more expensive for us to maintain sufficient director and officer liability insurance coverage. We cannot predict or
estimate the amount or timing of additional costs we may continue to incur to respond to these requirements. The ongoing impact
of these requirements could also make it more difficult for us to attract and retain qualified persons to serve on our Board, our
Board committees or as executive officers.
Risk Factors Related to Our Stock and
Financial Condition
We cannot predict the extent to which
a trading market for our common stock will develop or how liquid that market might become.
Our common stock is currently traded on
the OTC Link™ quotation platform of OTC Markets Group, Inc. We cannot predict the extent to which a trading market will develop
or how liquid that market might become. Accordingly, holders of our common stock may be required to retain their shares for an
indefinite period.
The OTC Link™ quotation system provides
significantly less liquidity than national stock exchanges. Quotes for stocks included on the OTC Link™ quotation system
are not listed in the financial sections of newspapers, as are those for the national stock exchanges. Therefore, prices for securities
traded solely on the OTC Link™ quotation system may be difficult to obtain, and holders of our common stock may be unable
to resell their shares at or near their original acquisition price or at any price. Market prices for our shares of common
stock will be influenced by several factors, including, but not limited to:
| • | The issuance of new shares pursuant to future offering; |
| • | Changes in interest rates; |
| • | New services or significant contracts and acquisitions; |
| • | Variations in quarterly operating results; |
| • | Change in financial estimates by securities analysts; |
| • | The depth and liquidity of the market for the shares; |
| • | Investor perceptions of us and of investments based in the countries where we do business or conduct
research; and |
| • | General economic and other national and international conditions. |
Our ability to access the capital
markets is limited by inability to use a short form registration statement on Form S-3.
A Registration Statement on Form S-3 permits
an eligible company to incorporate by reference in the registration statement its prior and subsequent filings and reports made
under the Exchange Act. In addition, Form S-3 enables eligible companies to conduct primary offerings "off the shelf"
under Rule 415 of the Securities Act of 1933, as amended (“Securities Act”). The shelf registration process under Form
S-3 combined with the ability to incorporate information on a prospective basis allows eligible companies to avoid additional delays
and interruptions in the offering process that would be associated with the filing of a registration statement and review by the
staff of the Commission and to access the capital markets in a more expeditious and efficient manner than raising capital in a
standard “long form” offering on Form S-1. Thus, our ability to raise, and the cost of raising, future capital could
be adversely affected by any inability to use a short form registration statement on Form S-3.
To be eligible to use Form S-3 for a registered
offering of our securities to investors, either: (i) the aggregate market value of our common stock held by non-affiliates must
exceed $75 million; or (ii) our common stock must be listed and registered on a national securities exchange. We do not currently
meet either of these eligibility requirements and are therefore precluded from conducting a registered offering of our securities
to investors by means of filing a Form S-3 or effecting a “shelf” offering until we meet one of these requirements.
Penny stock rules may have an adverse
effect on us.
Our securities sold as part of financing
provided to us are currently subject to “penny stock rules” that impose additional sales requirements on broker-dealers
who sell such securities to persons other than established customers and accredited investors, the latter of which are generally
people with assets more than $1,000,000 or annual income exceeding $200,000 (individually) or $300,000 (jointly with a spouse).
For transactions covered by these rules, we and/or broker-dealers must make a special suitability determination for the purchase
of such securities and have received the purchaser’s written consent to the transaction prior to the purchase. Additionally,
for any transaction involving a penny stock, unless exempt, the “penny stock rules” require the delivery, prior to
the transaction, of a disclosure schedule prescribed by the Commission relating to the penny stock market. The broker-dealer must
also disclose the commissions payable to both the broker-dealer and the registered representative and current quotations for the
securities. Finally, monthly statements must be sent disclosing recent price information on the limited market in penny stocks.
Consequently, the “penny stock rules” may restrict the ability of broker-dealers to sell our securities. The foregoing
required penny stock restrictions will not apply to our common stock if such securities maintain a market price of $5.00 or greater.
Therefore, the challenge for us is that the market price of our common stock may not reach or remain at such a level.
Shareholders should be aware that, according
to the Commission, the market for penny stocks continues to suffer from patterns of fraud and abuse. Such patterns include, but
are not limited to:
| • | Control of the market for the security by one or a few broker-dealers that are often related to
the promoter or issuer; |
| • | Manipulation of prices through prearranged matching of purchases and sales and false and misleading
press releases and paid promotions; |
| • | “Boiler room” practices involving high-pressure sales tactics and unrealistic price
projections by inexperienced sales persons; |
| • | Excessive and undisclosed bid-ask differentials and markups by selling broker-dealers; and |
| • | The wholesale dumping of the same securities by promoters and broker-dealers after prices have
been manipulated to a desired level, leaving investors with losses. |
Our executive officers are aware of these
abuses that have occurred historically in the penny stock market. Although we are in no position to dictate the behavior of the
market or of broker-dealers or others that may engage in such abuses, management will strive within the confines of practical limitations
to prevent the described patterns from being established with respect to our common stock.
We may experience volatility in our
stock price, which may adversely affect the trading price of our common stock.
We experience significant volatility from
time to time in the market price of our shares of common stock. Factors that may affect the market price include the following:
| • | Announcements of regulatory developments or technological innovations by us or our competitors; |
| • | Changes in our relationship with our licensors and other strategic partners; |
| • | Our quarterly operating results; |
| • | Litigation involving or affecting us; |
| • | Shortfalls in our actual financial results compared to our guidance or the forecasts of stock market
analysts; |
| • | Developments in patent or other technology ownership rights; |
| • | Acquisitions or strategic alliances by us or our competitors; |
| • | Public concern regarding the safety of our products; and |
| • | Government regulation of drug pricing. |
The price of our common stock is
volatile, which substantially increases the risk that our investors may not be able to sell their shares at or above the price
that the investors have paid for their shares.
Because of the price volatility in our
shares we have observed since its inception, investors in our common stock may not be able to sell their shares when they desire
to do so at a price the investors desire to attain. The inability to sell securities in a rapidly declining market may substantially
increase the risk of loss because the price of our common stock may suffer greater declines due to the historical price volatility
of our shares. Certain factors, some of which are beyond our control, that may cause our share price to fluctuate significantly
include, but are not limited to, the following:
| • | Variations in our quarterly operating results; |
| • | Loss of a key relationship or failure to complete significant product candidate milestones timely
or at all; |
| • | Additions or departures of key personnel; and |
| • | Fluctuations in the stock market price and volume. |
In addition, in recent years the stock
market in general, and the over-the-counter markets in particular, have experienced extreme price and volume fluctuations. In some
cases, these fluctuations are unrelated or disproportionate to the performance of the underlying company. These market and industry
factors may materially and adversely affect our share price, regardless of our performance or whether we meet our business objectives.
In the past, class action litigation often has been brought against companies following periods of volatility in the market price
of those companies’ common stock. If we become involved in this type of litigation in the future, it could result in
substantial costs and diversion of management attention and resources, which could have a material adverse effect on us and the
trading price of our common stock.
We have no plans to pay dividends
in the foreseeable future, and investors may not expect a dividend as a return of or on any investment in us.
We have not paid dividends on our shares
of common stock and do not anticipate paying such dividends in the foreseeable future.
Our investors may suffer future dilution
due to issuances of additional shares of our common stock in the future for various reasons.
There may be substantial dilution to our
shareholders because of future decisions of our Board to issue shares for cash transactions, services rendered, acquisitions, payment
of debt, sale of shares under our Form S-3 Registration Statement, if we are eligible to use Form S-3 or other public or private
offerings of our securities and other permissible reasons. We can give investors no assurance that they will be able to sell their
shares of our commons stock at or near the prices they ask or at all if they need money or otherwise desire to liquidate their
shares.
Risks Related to Employee and Tax Matters,
Managing Growth and Macroeconomic Conditions
We have a limited number of employees
and are highly dependent on our Chief Executive Officer, Chief Operating Officer and Chief Financial Officer. Our future success
depends on our ability to retain these officers and other key personnel and to attract, retain and motivate other needed qualified
personnel.
We are an early-stage clinical development
company with a limited operating history. As of April 30, 2019, we had four full-time employees and eight key consultants. We are
highly dependent on the research and development, clinical and business development expertise of the principal members of our management,
scientific and clinical teams, specifically, on our Chief Executive Officer, Chief Operating Officer and Chief Financial Officer.
Recruiting and retaining qualified scientific, clinical, manufacturing and sales and marketing personnel will also be critical
to our success. The loss of the services of our Chief Executive Officer, Chief Operating Officer and Chief Financial Officer or
other key employees or consultants could severely impede the achievement of our research, development and commercialization of
our product candidates and seriously harm our ability to successfully implement our business strategy.
Furthermore, replacing executive officers
and key employees and consultants may be difficult and may take an extended period because of the limited number of individuals
in our industry with the breadth of skills and experience required to successfully develop, gain regulatory approval of and commercialize
products. Competition to hire from this limited pool is intense, and we may be unable to hire, train, retain or motivate these
key personnel on acceptable terms given the competition among numerous pharmaceutical and biotechnology companies for similar personnel.
We also experience competition for the
hiring of scientific and clinical personnel from universities and research institutions. In addition, we rely on other consultants
and advisors, including scientific and clinical advisors, to assist us in formulating our discovery, preclinical and clinical development
and commercialization strategy. Our consultants and advisors may be employed by employers other than us and may have commitments
under consulting or advisory contracts with other entities that may limit their availability to us. If we are unable to continue
to attract and retain high quality personnel, our ability to pursue our growth strategy will be limited.
Our ability to use our net operating
loss carryforwards and certain other tax attributes may be limited.
Under Section 382 of the Internal Revenue
Code of 1986, as amended, if a corporation undergoes an “ownership change,” the corporation’s ability to use
its pre-change net operating loss carryforwards and other pre-change tax attributes (such as research and development tax credits)
to offset its post-change income and taxes may be limited. In general, an “ownership change” occurs if there is a cumulative
change in our ownership by “5% shareholders” that exceeds 50 percentage points over a rolling three-year period. Similar
rules may apply under state tax laws.
If it is determined that we have in the
past experienced an ownership change, or if we experience one or more ownership changes because of this offering or future transactions
in our stock, we may be limited in our ability to use our net operating loss carryforwards and other tax assets to reduce taxes
owed on the net taxable income that we earn. Any such limitations on the ability to use our net operating loss carryforwards and
other tax assets could potentially result in increased future tax liability to us.
We expect to expand our development
and regulatory capabilities and potentially implement sales, marketing and distribution capabilities. Thus, we may encounter difficulties
in managing our growth, which could disrupt our operations.
We expect to experience significant growth
in the number of our employees and the scope of our operations, particularly in the areas of drug development, regulatory affairs
and, if any of our product candidates receive marketing approval, sales, marketing and distribution. To manage our anticipated
future growth, we must continue to implement and improve our managerial, operational and financial systems, expand our facilities
and continue to recruit and train additional qualified personnel. Due to our limited financial resources and the limited experience
of our management team in managing a company with such anticipated growth, we may not be able to effectively manage the expansion
of our operations or recruit and train additional qualified personnel. The expansion of our operations may lead to significant
costs and may divert our management and business development resources. Any inability to manage growth could delay the execution
of our business plans or disrupt our operations.
Unfavorable global economic conditions
could adversely affect our business, financial condition or results of operations.
Our results of operations could be adversely
affected by general conditions in the global economy and in the global financial markets. The recent global financial crisis caused
extreme volatility and disruptions in the capital and credit markets. A severe or prolonged economic downturn, such as the recent
global financial crisis, could result in a variety of risks to our business, including our ability to raise additional capital
when needed on acceptable terms, if at all. This is particularly true in Europe, which is undergoing a continued severe economic
crisis. A weak or declining economy could also strain our suppliers, possibly resulting in supply disruption. Any of the foregoing
could adversely impact our business.
Our business and operations would
suffer in the event of system failures.
Despite the implementation of security
measures, our internal computer systems and those of our third-party service providers on whom we rely are vulnerable to damage
from computer viruses, unauthorized access, natural disasters, terrorism, war and telecommunication and electrical failures. Furthermore,
we have little or no control over the security measures and computer systems of our third-party service providers. While we and,
to our knowledge, our third-party service providers have not experienced any such system failure, accident or security breach to
date, if such an event were to occur and cause interruptions in our operations or the operations of our third-party service providers,
it could result in a material disruption of our drug development programs. If any disruptions occur, they could have a material
adverse effect on our business.
We are subject to legal, regulatory,
financial and other risks with our operations outside the U.S.
We operate globally and are attempting
to develop products in multiple countries. Consequently, we face complex legal and regulatory requirements in multiple jurisdictions,
which may expose us to certain financial and other risks. International operations are subject to a variety of risks, including:
| • | foreign currency exchange rate fluctuations; |
| • | greater difficulty in overseeing foreign operations; |
| • | logistical and communications challenges; |
| • | potential adverse changes in laws and regulatory practices, including export license requirements,
trade barriers, tariffs and tax laws; |
| • | burdens and costs of compliance with a variety of foreign laws; |
| • | political and economic instability; |
| • | increases in duties and taxation; |
| • | foreign tax laws and potential increased costs associated with overlapping tax structures; |
| • | greater difficulty in protecting intellectual property; |
| • | the risk of third-party disputes over ownership of intellectual property and infringement of third-party
intellectual property by our products; and |
| • | general social, economic and political conditions in these foreign markets. |
The comprehensive tax reform law
could adversely affect our business and financial condition.
On December 22, 2017, President Trump signed
into law the final version of the Tax Act. The Tax Act significantly reforms the Internal Revenue Code of 1986, as amended, with
many of its provisions effective for tax years beginning on or after January 1, 2018. The Tax Act, among other things, contains
significant changes to corporate taxation, including a permanent reduction of the corporate income tax rate, a partial limitation
on the deductibility of business interest expense, a limitation of the deduction for net operating loss carryforwards to 80% of
current year taxable income, an indefinite net operating loss carryforward and the elimination of the two-year net operating loss
carryback, temporary, immediate expensing for certain new investments and the modification or repeal of many business deductions
and credits. We continue to examine the impact this tax reform legislation may have on our business. Notwithstanding the reduction
in the corporate income tax rate, the overall impact of the Tax Act is uncertain and our business and financial condition could
be adversely affected. The impact of this reform on our stockholders is uncertain. Stockholders should consult with their tax advisors
regarding the effect of the Tax Act and other potential changes to the U.S. Federal tax laws on them.
ITEM 1B. UNRESOLVED STAFF COMMENTS
None.
ITEM 2. PROPERTIES
Our principal office is located at 20156
Avenida de la Carlota, Suite 600, Laguna Hills, California 92653. The offices we lease (“Leased Premises”) consist
of approximately 600 square feet plus the use of certain shared facilities, such as a lobby, conference rooms, a kitchen and open
work spaces. The term of our current lease agreement expires on August 31, 2019. On May 29, 2019, we entered into a new lease agreement
at our current location for an additional twelve-month term, expiring on August 31, 2020. The Leased Premises will consist of approximately
400 square feet plus the use of the same shared facilities and areas.
ITEM 3. LEGAL PROCEEDINGS
There is no material litigation currently
pending against us or any of our subsidiaries or to which any of our or our subsidiaries’ property is subject. To our knowledge,
there is no material litigation against any of our officers or directors in their capacity as such, and no such litigation is contemplated
by any governmental authorities.
ITEM 4. MINE SAFETY DISCLOSURES
Not applicable.
PART II
ITEM 5. MARKET FOR REGISTRANT’S
COMMON EQUITY, RELATED STOCKHOLDER MATTERS AND ISSUER PURCHASES OF EQUITY SECURITIES.
Shares of our common stock are quoted and
traded on the OTC Link™ quotation platform of OTC Markets Group, Inc. (“OTCQB”) as a fully reporting Over-The-Counter
Bulletin Board company under the classification of OTCQB utilizing the trading symbol “PMCB.”
The following table sets forth the high
and low bid quotations reported on the OTCQB for our shares for each quarter during the two fiscal years (“FYs”) ended
April 30, 2019 and 2018. The prices reflect inter-dealer prices, without retail mark-up, mark-down or commission and may not necessarily
represent actual transactions.
| Date | |
Bid Price | |
| FY 2019 | |
HIGH | | |
LOW | |
| First Quarter | |
$ | 0.11 | | |
| 0.05 | |
| Second Quarter | |
$ | 0.07 | | |
| 0.05 | |
| Third Quarter | |
$ | 0.06 | | |
| 0.04 | |
| Fourth Quarter | |
$ | 0.07 | | |
| 0.04 | |
| FY 2018 | |
| | | |
| | |
| First Quarter | |
$ | 0.10 | | |
| 0.05 | |
| Second Quarter | |
$ | 0.08 | | |
| 0.05 | |
| Third Quarter | |
$ | 0.08 | | |
| 0.03 | |
| Fourth Quarter | |
$ | 0.08 | | |
| 0.05 | |
As of April 30, 2019, there were 1,161,004,505
issued and outstanding shares of common stock. We are informed these shares are held by approximately 1,300 shareholders of record.
Dividend Policy
We have not paid and do not plan to pay
cash dividends now. Our Board will decide any future payment of dividends, depending on the results of operations, financial condition,
capital requirements and other relevant factors.
Issuer Purchases of Equity Securities
We did not repurchase any of our securities
registered under Section 12 of the Exchange Act during our fiscal year ended April 30, 2019.
Recent Issuance of Unregistered Securities
We issued Common Stock Purchase Warrants
(“Warrants”) to Aeon (defined below) in connection with our Block Trades (defined below). We issued Warrants to purchase
the number of shares of our restricted common stock listed below.
The Warrants have a five-year term and
represent 5% of the number of shares of common stock sold at an exercise price equal to the price per share at which the shares
were sold in the Block Trade. They are exercisable by the Holder at any time and from time to time from the Sale Date through and
including the expiration date set forth in the Warrant. Each Warrant has a specified Exercise Price as set forth below.
| Sale Date |
Warrants Issued |
Exercise Price |
| May 24, 2017 |
833,333 |
$0.03 |
| July 26, 2017 |
2,000,000 |
$0.025 |
| February 27, 2018 |
1,666,667 |
$0.03 |
| May 30, 2018 |
1,388,889 |
$0.018 |
| June 28, 2018 |
1,923,077 |
$0.026 |
| November 1, 2018 |
2,272,727 |
$0.011 |
| March 26, 2019 |
1,250,000 |
$0.01 |
| March 26, 2019 |
1,250,000 |
$0.01 |
In addition to issuances of unregistered
securities by us to our officers and directors previously disclosed in our Quarterly Reports on Form 10-Q, our Form 8-Ks and this
Report, on April 11, April 18 and April 21, 2019 we issued an aggregate of 2.5 million shares of restricted common stock to consultants
for services provided to us. The non-cash expense for these share issuances total $151,425.
All such shares were issued without registration
under the Securities Act in reliance upon the exemption afforded by Section 4(a)(2) of that Act based on the limited number of
investors, the sophistication of the individuals involved and the use of restrictive legends on the share certificates issued to
prevent a public distribution of the relevant securities. No underwriters were involved in any of these issuances.
ITEM 6. SELECTED FINANCIAL DATA
We are a smaller reporting company. Therefore,
we are not required to include information called for by this Item 6.
ITEM 7. MANAGEMENT’S DISCUSSION
AND ANALYSIS OF FINANCIAL CONDITION AND RESULTS OF OPERATIONS
The following discussion may contain
forward-looking statements that involve risks and uncertainties. As described under the caption “Cautionary Note Regarding
Forward-Looking Statements,” our actual results could differ materially from those discussed here. Factors that could cause
or contribute to such differences include, but are not limited to, any factors discussed in this section as well as factors described
in Part II, Item 1A. “Risk Factors” and under the caption “Cautionary Note Regarding Forward-Looking Statements.”
Overview
We are a clinical stage biotechnology company
focused on developing and preparing to commercialize cellular therapies for cancer and diabetes based upon our proprietary cellulose-based
live cell encapsulation technology we refer to as Cell-in-a-Box®. We are working to advance clinical research and
development of new cellular-based therapies in the oncology and diabetes arenas.
We are now actively engaged with Austrianova
and other entities in preparation for a Phase 2b clinical trial in LAPC using encapsulated live cells like those used in the previous
Phase 1/2 and Phase 2 clinical trials discussed above. A Pre-IND meeting with CBER of the FDA was held on January 17, 2017, at
which the FDA communicated its agreement with certain aspects of our development plan, charged us with completing numerous tasks
and provided us with the guidance we need to complete what we expect will be a successful IND process. However, no assurance can
be given that the FDA will approve our IND once it is submitted.
We are also conducting research relating
to the use of constituents of Cannabis, known as cannabinoids, in treating cancer and its symptoms.
In addition, we have been involved in preclinical
studies to determine if our cancer therapy can slow the production or accumulation of malignant ascites fluid in the abdomen that
accompanies the growth of several types of abdominal cancers. In regard to the latter, one final study remains to be completed.
Finally, we are developing a therapy for
Type 1 diabetes and insulin-dependent Type 2 diabetes based upon the encapsulation of a human liver cell line genetically engineered
to produce, store and secrete insulin at levels in proportion to the levels of blood sugar in the human body. We are also exploring
the possibility of encapsulating human insulin-producing stem cells and islet cells and then transplanting them into a diabetic
patient. All three types of cells will be encapsulated using the Cell-in-a-Box® encapsulation technology. Each approach
is designed to function as a bio-artificial pancreas for purposes of insulin production.
Performance Indicators
Non-financial performance indicators used
by management to manage and assess how the business is progressing will include, but are not limited to, the ability to: (i) acquire
appropriate funding for all aspects of our operations; (ii) acquire and complete necessary contracts; (iii) complete activities
for producing genetically modified human cells and having them encapsulated for our preclinical studies and the planned Phase 2b
clinical trial in LAPC; (iv) have regulatory work completed to enable studies and trials to be submitted to regulatory agencies;
(v) complete all required tests and studies on the cells and capsules we plan to use in our clinical trial in patients with LAPC;
and (vi) ensure completion of the production of encapsulated cells according to cGMP
regulations to use in our planned clinical trial.
There are numerous items required to be
completed successfully to ensure our final product candidates are ready for use in our planned clinical trial in LAPC and preclinical
studies. The effects of material transactions with related parties, and certain other parties to the extent necessary for such
an undertaking, may have substantial effects on both the timeliness and success of our current and prospective financial position
and operating results. Nonetheless, we are actively working to ensure strong ties and interactions to minimize the inherent risks
regarding success. We do not believe there are factors which will cause materially different amounts to be reported than those
presented in this Report. We aim to assess this regularly to provide accurate information to our shareholders.
Liquidity and Capital Resources
Our Consolidated Financial statements and
related Notes have been prepared on a going-concern basis, which contemplates the realization of assets and the satisfaction of
liabilities in the normal course of business. Therefore, the Consolidated Financial Statements do not include any adjustments that
might be necessary should we be unable to continue in existence. We have not generated any revenues and have not yet achieved profitable
operations. There is no assurance that profitable operations, if ever achieved, could be sustained on a continuing basis. Also,
development activities, preclinical studies, clinical trials and commercialization of our product candidates will require significant
additional financing. Our deficit accumulated through April 30, 2019 was $100,031,371. We expect to incur substantial and increasing
losses in future periods. Our total cash was $515,253 and $1,059,798 as of April 30, 2019 and 2018, respectively. Our net loss
was $4,067,228 and $6,828,841 for the years ended April 30, 2019 and 2018, respectively. Cash flows from investing activities were
$0 for the years ended April 30, 2019 and 2018. Net cash provided by financing activities was $2,342,500 and $2,681,409 for the
years ended April 30, 2019 and 2018, respectively. For more information, see the discussion under the caption “—Discussion
of Operating, Investing and Financing Activities” in this Item 7.
Our ability to successfully pursue our
business is subject to certain risks and uncertainties, including, among other things, uncertainty of product development, uncertainty
regarding the timing of our submission of our IND to the FDA, uncertainty of FDA approval of our IND once it is submitted to the
FDA, need to raise capital to fund our various studies and FDA submissions, competition from third parties, uncertainty of capital
availability, in particular, if we lost the ability to utilize our S-3 registration statement, uncertainty in our ability to enter
agreements with collaborative partners, dependence on third parties and dependence on key personnel. We plan to finance future
operations with a combination of proceeds from the issuance of equity, debt, licensing fees and revenues from future product sales,
if any. We have not generated positive cash flows from operations. There are no assurances that we will be successful in obtaining
an adequate level of financing for the development and commercialization of our product candidates.
We do not believe there are trends, events
or uncertainties that have, or are reasonably likely to have, a material effect on our short-term or long-term liquidity. Our research
and development activities are scalable. This means that we can increase or decrease the expenses associated with our planned preclinical
studies and clinical trials based on our available cash. We have no contractual obligations to perform preclinical studies or clinical
trials. For the time being, the principal source of our cash is the sale of our common stock in registered offerings and private
placements. However, there are no assurances that such sales will be sufficient to fund our planned clinical trial and other research
and development costs.
The Statement of Cash Flow is the focal
point for our liquidity, although the exercising of warrants and/or options at appropriate times by our investors, consultants,
officers and directors will have potentially important positive effects on our liquidity. We also believe that the relationship
between changes in operating results may induce changes in liquidity. For example, we may experience material changes in working
capital components due to the acquisition of new capital through the “at-the-market” facility described below and the
conversion of warrants and/or options by our investors, consultants, officers and directors. We rely solely on working capital
as our liquidity indicator, since we do not presently have any open credit lines; however, we may try to obtain credit lines or
other credit facility in the future. Further, as has often been a part of our mechanism to maintain overall liquidity, internal
sources of liquidity from others associated with us may be utilized when needed.
We do not utilize any advanced methodology
of cash management beyond paying our normal expenses.
On May 28, 2014, we entered a financial
advisory offering and an at the market offering engagement agreement (“Chardan Agreement”) with Chardan Capital Markets,
LLC (“Chardan”) pursuant to which Chardan agreed to use its reasonable best efforts to act as our sales agent for the
sale of our common stock in “at-the-market” or privately negotiated transactions of up to $50,000,000, depending upon
market conditions and at our discretion. In such transactions we agreed to pay to Chardan: (i) a cash fee of 3% of the gross proceeds
from the sale of any shares of common stock sold in an “at-the-market” offering; and (ii) a cash fee of 7% of the aggregate
sales price of any distinct blocks of common stock sold under the Chardan Agreement, plus five-year warrants representing 5% of
the number of shares of common stock sold. We also agreed to reimburse certain expenses of Chardan in an amount not to exceed $15,000.
The Chardan Agreement was amended December
15, 2016. The amendment provides for the termination of the Engagement Agreement for any reason, with or without cause on five
days’ written notice by either party. The amendment also provides that Chardan will be entitled to collect transaction fees
for common stock or other securities offered by us and sold to any parties introduced to us by Chardan within nine months following
expiration or termination of the Engagement Agreement.
On January 26, 2018, we and Chardan entered
into a Mutual Termination Agreement terminating the Chardan Agreement. We are not subject to any termination penalties related
to the mutual termination of the Chardan Agreement. We do not owe any further fees to Chardan under any provision of the Chardan
Agreement.
We raised approximately $13 million through
our initial Registration Statement on Form S-3 filed on October 17, 2014 (“First S-3”) pursuant to which Chardan was
our exclusive placement agent.
On February 22, 2018, we entered into a
financial advisory, offering and an “at the market offering” engagement agreement (“Aeon Agreement”) with
Aeon Capital, Inc. (“Aeon”) pursuant to which Aeon agreed to use its reasonable best efforts to act as our agent for
the sale of up to $25,000,000 of our common stock in “at-the-market,” or privately negotiated transactions, or transactions
structured as a public offering of a distinct block or blocks of the Shares (“Block Trades”). In connection with a
transaction deemed to be an “at the market offering”, we agreed to pay Aeon a cash fee of 3% of the aggregate sales
price from the sale of shares of our common stock. In connection with a transaction structured as a Block Trade, we agreed to pay
Aeon a cash fee of 7% of the aggregate sales price of any distinct blocks of common stock sold under the Aeon Agreement unless
the Company introduced the investor to Aeon, in which event the fee shall be 4%, plus five-year warrants representing 5% of the
number of shares of common stock sold at an exercise price equal to the price per share at which the shares were sold in the Block
Trade. We also agreed to reimburse certain expenses of Aeon in an amount not to exceed $10,000. In addition, we agreed to provide
Aeon with customary indemnification rights. The offering of the shares of our common stock will terminate upon the earliest to
occur of: (i) the sale of all of the shares to be sold; or (ii) the termination of the Aeon Agreement by us or Aeon upon thirty
days written notice prior to the effective date of the termination.
Sales of our common stock will be made, if we are eligible under applicable law,
under our second Registration Statement on Form S-3 filed on September 13, 2017 (“Second S-3”) allowing for offerings
of up to $50,000,000 in transactions that are deemed to be “at the market offerings” as defined in Rule 415 under the
Securities Act or transactions structured as a public offering of a distinct block or blocks of the shares of our common stock.
From February 26, 2018 to April 30, 2019,
the Company sold 195,027,194 shares of our common stock structured as a Block Trade. The issuance of these shares resulted in gross
proceeds of $3.5 million. Pursuant to the Aeon Agreement, we incurred fees to Aeon of 7% ($245,000) and provided warrant coverage
of 5% of the number of shares sold with a five-year term of approximately 9.75 million warrant shares.
We require substantial additional capital
to finance our planned business operations and expect to incur operating losses in the future due to the expenses related to our
core businesses. We have not realized material revenue since we commenced doing business as a biotechnology company, and there
can be no assurance that we will be successful in generating revenues in the future in this sector.
Our current cash expenditures are approximately
$240,000 per month. As of April 30, 2019, we had approximately $515,000 in cash in our bank account.
We believe our cash on hand at April 30,
2019, sales of shares of our common stock using the Second S-3, assuming we remain eligible to use the Second S-3, sales of unregistered
shares of our common stock and any public offerings of common stock in which we may engage in will provide sufficient capital to
meet our capital requirements and to fund our operations through July 31, 2020.
We will continue to be dependent on outside
capital to fund our research and operating expenditures for the foreseeable future. If we fail to generate positive cash flows
or fail to obtain additional capital when required, we may need to modify, delay or abandon some or all our business plans.
Year ended April 30, 2019 compared
to year ended April 30, 2018
Revenue
We had no revenues in the fiscal years
ended April 30, 2019 and 2018.
Operating Expenses
The total operating expenses during the
year ended April 30, 2019 decreased by $2,880,800 to $4,100,629 from $6,981,420 in the year ended April 30, 2018. The decrease
is mainly attributable to a decrease in R&D costs, compensation expense and in consulting expense as we awarded less stock-based
consulting fees and compensation in 2019 than in 2018.
| Operating expenses: | |
Year ended
April 30,
2019 | | |
Change -
Increase
(Decrease)
and Percent | | |
Year ended
April 30,
2018 | |
| R&D | |
$ | 460,052 | | |
$ | (1,537,759 | ) | |
$ | 1,997,811 | |
| | |
| | | |
| (77% | ) | |
| | |
| | |
| | | |
| | | |
| | |
| Compensation expense | |
$ | 1,555,258 | | |
$ | (665,539 | ) | |
$ | 2,220,797 | |
| | |
| | | |
| (30% | ) | |
| | |
| | |
| | | |
| | | |
| | |
| Director fees | |
$ | 406,812 | | |
$ | 80,272 | | |
$ | 326,540 | |
| | |
| | | |
| 25% | | |
| | |
| | |
| | | |
| | | |
| | |
| General and administrative, legal and professional | |
$ | 1,378,544 | | |
$ | (440,379 | ) | |
$ | 1,818,923 | |
| | |
| | | |
| (24% | ) | |
| | |
Loss from Operations
Loss from operations during the year ended
April 30, 2019 decreased by $2,880,800 to $4,100,629 from $_6,981,429 in the year ended April 30, 2018. The decrease is mainly
attributable to a decrease in R&D costs, compensation expense and in consulting expense as we awarded less stock-based consulting
fees in 2019.
Other Income (Expenses), Net
Other income for the year ended April 30,
2019 was $33,401 as compared to other expense, net of $152,588 in the year ended April 30, 2018. Other income for the year ended
April 30, 2019, is attributable to the Australian research and development credit and the Goods and Services Tax (“GST”)
refund. The Australian research and development credits relate to qualified research and development expenditures incurred in Australia.
An annual tax incentive schedule is filed with the Australian Taxation Office to apply for the credit. A GST refund request form
is submitted to the Australian Taxation Office for the return of qualifying GST amounts paid in Australia.
Discussion of Operating, Investing and
Financing Activities
The following table presents a summary
of our sources and uses of cash for the years ended April 30, 2019 and 2018.
| | |
Year Ended
April 30,
2019 | | |
Year Ended
April 30,
2018 | |
| Net cash used in operating activities: | |
$ | (2,877,912 | ) | |
$ | (5,079,395 | ) |
| Net cash used in investing activities: | |
$ | – | | |
$ | – | |
| Net cash provided by financing activities: | |
$ | 2,342,500 | | |
$ | 2,681,409 | |
| Effect of currency rate exchange | |
$ | (9,133 | ) | |
$ | (6,445 | ) |
| Increase (decrease) in cash | |
$ | (544,545 | ) | |
$ | (2,404,431 | ) |
Operating Activities:
The cash used in operating activities for
the years ended April 30, 2019 and 2018 are a result of our net losses offset by securities issued for services and compensation,
changes to prepaid expenses, accounts payable and accrued expenses.
Investing Activities: We
had no investing activities for the years ended April 30, 2019 and 2018.
Financing Activities:
The cash provided from financing activities
for the years ended April 30, 2019 and 2018 is mainly attributable to the proceeds from the sale of our common stock.
Off-Balance Sheet Arrangements
Except as described below, we have no off-balance
sheet arrangements that could have a material current effect or that are reasonably likely to have a material adverse effect on
our financial condition, changes in financial condition, revenues or expenses, results of operations, liquidity, capital expenditures
or capital resources.
On May 14, 2018, we entered into amendments
to all of the material agreements with SG. Austria and Austrianova. See “Details of the Company’s Material Agreements”
above for a description of these amendments.
Critical Accounting Estimates and Policies
Our Consolidated Financial Statements are
prepared in accordance with U.S. generally accepted accounting principles (“U.S. GAAP”). We are required to make assumptions
and estimates about future events and apply judgments that affect the reported amounts of assets, liabilities, revenue and expenses
and the related disclosures. We base our assumptions, estimates and judgments on historical experience, current trends and other
factors that management believes to be relevant at the time our Consolidated Financial Statements are prepared. On a regular basis,
management reviews the accounting policies, assumptions, estimates and judgments to ensure that our Consolidated Financial Statements
are presented fairly and in accordance with U.S. GAAP. However, because future events and their effects cannot be determined with
certainty, actual results could differ from our assumptions and estimates, and such differences could be material.
Our significant accounting policies are
discussed in Note 2 of the Notes to our Consolidated Financial Statements included in Item 8, “Financial Statements and Supplementary
Data” of this Report. Management believes that the following accounting estimates are the most critical to aid in fully understanding
and evaluating our reported financial results and require management’s most difficult, subjective or complex judgments resulting
from the need to make estimates about the effects of matters that are inherently uncertain. Management has reviewed these critical
accounting estimates and related disclosures with our Board.
Research and Development Expenses
R&D expenses consist of costs incurred
for direct and overhead-related research expenses and are expensed as incurred. Costs to acquire technologies, including licenses,
that are utilized in research and development and that have no alternative future use are expensed when incurred. Technology developed
for use in our product candidates is expensed as incurred until technological feasibility has been established.
Stock-Based Compensation
Our stock-based compensation plans are
described in Note 4 and 5 of the Notes of the Consolidated Financial Statements to this Report. We follow the provisions of ASC
718, Compensation - Stock Compensation (“ASC 718”), which requires the measurement and recognition of compensation
expense for all stock-based awards made to employees. Effective August 1, 2018, we adopted early ASU 2018-07 Compensation -
Stock Compensation (Topic 718): - Improvements to Nonemployee Share-Based Payment Accounting, which simplified the guidance
for accounting for nonemployee share-based payment transactions for acquiring goods and services from nonemployees.
Net Income (Loss) Per Share
Basic net income (loss) per common share
is computed using the weighted-average number of common shares outstanding. Diluted net income (loss) per common share is computed
using the weighted-average number of common shares and common share equivalents outstanding. Potentially dilutive stock options
and warrants to purchase 149,527,797 and 129,243,104 shares at April 30, 2019 and 2018, respectively, were excluded from the computation
of diluted net income (loss) per share because the effect would be anti-dilutive.
New Accounting Pronouncements
For a discussion of all recently adopted
and recently issued but not yet adopted accounting pronouncements, see “Recent Accounting Pronouncements” in Note 2
of our Notes to our consolidated financial statements included in Item 8, “Financial Statements and Supplementary Data”
of this Report.
ITEM 7A. QUANTITATIVE AND QUALITATIVE
DISCLOSURES ABOUT MARKET RISK
We are a smaller reporting company and
are not required to include information called for by this Item 7A.
ITEM 8. FINANCIAL STATEMENTS AND SUPPLEMENTARY
DATA
Our Consolidated Balance Sheets, as of
April 30, 2019 and 2018, and our Consolidated Statements of Operations, Comprehensive Loss, Stockholders Equity and Cash Flows
for each of the two years in the period ended April 30, 2019 and associated Notes and Schedules, together with the reports thereon
of our independent registered public accounting firm, are set forth on pages F-1 to F-26 of this Report and are incorporated by
reference herein.
ITEM 9. CHANGES IN AND DISAGREEMENTS
WITH ACCOUNTANTS ON ACCOUNTING AND FINANCIAL DISCLOSURES
Our principal independent public accountant
is Armanino LLP (“Armanino”). During our fiscal year ended April 30, 2019 and 2018, there have been no disagreements
with Armanino on any matter of accounting principles or practices, financial statement disclosure or auditing scope or procedure
which, if not resolved to Armanino’s satisfaction, would have caused Armanino to refer to the subject matter in its report
on our Consolidated Financial Statements for such periods.
During our fiscal year ended April 30,
2019 and 2018, there were no “reportable events” requiring disclosure pursuant to Item 304(a)(1)(v) of Regulation S-K.
As used herein, the term “reportable event” means any of the items listed in paragraphs (a)(1)(v)(A) - (D) of Item
304 of Regulation S-K.
ITEM 9A. CONTROLS AND PROCEDURES
Evaluation of Disclosure Controls and Procedures
Our Chief Executive Officer, President
and General Counsel, as our principal executive officer (“Chief Executive Officer”), and our Chief Financial Officer,
as our principal financial officer (“Chief Financial Officer”), evaluated the effectiveness of our “disclosure
controls and procedures,” as such term is defined in Rule 13a-15(e) promulgated under the Exchange Act. Disclosure controls
and procedures are designed to ensure that the information required to be disclosed in the reports that we file or submit to the
Commission pursuant to the Exchange Act are recorded, processed, summarized and reported within the period specified by the Commission’s
rules and forms and are accumulated and communicated to our management, including our Chief Executive Officer, as appropriate to
allow timely decisions regarding required disclosures. Based upon this evaluation, our Chief Executive Officer and our Chief Financial
Officer have concluded that, as of April 30, 2019, our disclosure controls and procedures were not effective due to the material
weaknesses in internal control over financial reporting.
A control system, no matter how well conceived
and operated, can provide only reasonable, not absolute, assurance that the objectives of the control system are met. Further,
the design of a control system must reflect the fact that there are resource constraints, and the benefits of controls must be
considered relative to their costs. Because of the inherent limitations in all control systems, no evaluation of controls can provide
absolute assurance that all control issues and instances of fraud, if any, within the Company have been detected. These inherent
limitations include the realities that judgments in decision-making can be faulty and that breakdowns can occur because of simple
error or mistake. Also, controls can be circumvented by the individual acts of some persons, by collusion of two or more people
or by management override of the controls. The design of any system of controls is also based in part upon certain assumptions
about the likelihood of future events. There can be no assurance that any design will succeed in achieving its stated goals under
all potential future conditions.
Management’s Evaluation of
Internal Controls over Financial Reporting
Our management is responsible for establishing
and maintaining adequate internal controls over financial reporting as that term is defined in Exchange Act Rules 13a-15(f) and
15d-15(f). Our internal controls over financial reporting are designed to provide reasonable assurance regarding the reliability
of financial reporting and the preparation of financial statements for external purposes in accordance with U.S. GAAP.
Under the supervision and with the participation
of our Chief Executive Officer and our Chief Financial Officer, management conducted an evaluation of the effectiveness of our
internal controls over financial reporting as of April 30, 2019 based on the criteria outlined in Internal Control-Integrated Framework
(2013) issued by the Committee of Sponsoring Organizations of the Treadway Commission (“COSO”) and identified the following
material weaknesses in internal controls over financial reporting:
| • | Insufficient procedures and control documentation to implement control procedures including lack of contract review. We have
developed procedures to provide ample review time of financial information, including contract review by qualified
accounting and finance personnel as well as management. We have implemented these procedures, determined they are still
insufficient and will continue to review these procedures to determine ways to further improve them. |
| • | Insufficient segregation of duties of the Chief Financial Officer. We have delegated some of the
duties of our Chief Financial Officer to other personnel within the Company and have added review and approval processes performed
by the Chief Executive Officer. |
| • | Insufficient information technology controls and documentation. We currently use accounting software
which we have determined is inadequate to provide the level of controls required by COSO. We are in the process of initiating a
review process to fully evaluate the deficiencies in our technology controls and documentation. Based upon the results of this
review process, we intend to implement the required remediation measures. |
Because of these material weaknesses, our
Chief Executive Officer and our Chief Financial Officer concluded that, as of April 30, 2019, our internal controls over financial
reporting were not effective based on the COSO criteria.
We are in the process of investigating
new procedures and controls for fiscal year 2020. We plan to make changes to our procedures and controls that we believe are reasonably
likely to strengthen and materially affect our internal controls over financial reporting.
Prior to the remediation of these material
weaknesses, there remains risk that the processes and procedures on which we currently rely will fail to be sufficiently effective,
which could result in material misstatement of our financial position or results of operations and require a restatement. Because
of the inherent limitations in all control systems, no evaluation of controls - even where we conclude the controls are operating
effectively - can provide absolute assurance that all control issues, including instances of fraud, if any, have been detected.
These inherent limitations include the realities that judgments in decision making can be faulty and breakdowns can occur because
of simple error or mistake. Additionally, controls can be circumvented by the individual acts of a person, by collusion of two
or more people, or by management override of the controls. The design of any system of controls also is based in part upon certain
assumptions about the likelihood of future events; accordingly, there can be no assurance that any design will succeed in achieving
its stated goals under all potential future conditions. Over time, our control systems, as we develop them, may become inadequate
because of changes in conditions or the degree of compliance with the policies or procedures may deteriorate. Because of the inherent
limitations in a cost-effective control system, misstatements due to error or fraud may occur and not be detected and could be
material to our financial statements.
Changes in Internal Controls over
Financial Reporting
There were no changes in our internal controls
over financial reporting during the most recent fiscal quarter that have materially affected, or are reasonably likely to materially
affect, our internal controls over financial reporting.
The Certifications of our Principal Executive
and Principal Financial Officer required in accordance with Rule 13a-14(a) under the Exchange Act and Section 302 of the Sarbanes-Oxley
Act of 2002 (“Certifications”) are attached to this Report. The disclosures set forth in this Item 9A contain information
concerning: (i) the evaluation of our disclosure controls and procedures, and changes in internal control over financial reporting,
referred to in paragraph 4 of the Certifications; and (ii) material weaknesses in the design or operation of our internal control
over financial reporting, referred to in paragraph 5 of the Certifications. The Certifications should be read in conjunction with
this Item 9A for a more complete understanding of the matters covered by the Certifications.
Changes in Internal Control over
Financial Reporting
There were no changes in our internal control
over financial reporting during the most recent fiscal quarter that have materially affected, or are reasonably likely to materially
affect, our internal control over financial reporting.
ITEM 9B. OTHER INFORMATION
None.
PART III
ITEM 10. DIRECTORS, EXECUTIVE OFFICERS
AND CORPORATE GOVERNANCE
Our directors, executive officers and significant
consultants, as of August 12, 2019, are:
| |
Age |
Position |
| Kenneth L. Waggoner, JD |
71 |
Chairman of the Board, Chief Executive Officer, President and General Counsel |
| Gerald W. Crabtree, PhD. |
78 |
Director and Chief Operating Officer |
| Carlos A. Trujillo, CPA |
61 |
Director and Chief Financial Officer |
| Thomas Liquard |
46 |
Director |
| Thomas C. K. Yuen |
67 |
Director |
| Michael M. Abecassis, MD |
61 |
Director |
| Raymond C.F. Tong, MD. |
60 |
Director |
| Walter H. Günzburg, PhD |
60 |
Chief Scientific Officer and Consultant |
| Linda S. Sher, MD |
63 |
Chief Medical Officer and Consultant |
Kenneth L. Waggoner, JD
He became our Chief Executive Officer and
President in November 2013. Shortly thereafter, Mr. Waggoner assumed the additional position of General Counsel. In April 2014,
Mr. Waggoner became a full-time employee as the Chief Executive Officer, President and General Counsel of both PharmaCyte and Viridis
Biotech, a wholly owned subsidiary of PharmaCyte. Mr. Waggoner has been a member of the Board since September 2014. Mr. Waggoner
has over forty-five years of experience in management, business, operations and the practice of law. It was his education, training,
experience and leadership skills that led us to elect him to the Board and appoint him Chairman.
Mr. Waggoner began his professional career
as an attorney in private practice. From 1986 to 2003, he was a senior partner with Brobeck, Phleger and Harrison (“Brobeck”),
where he was the Managing Partner of Brobeck’s Los Angeles office. While at Brobeck, Mr. Waggoner served as a member of the
Executive Committee and on the Policy Committee. Mr. Waggoner was the co-Chairman of Brobeck’s worldwide Environmental Law
Group.
Mr. Waggoner’s career included leadership
and legal positions with Fortune 100 companies most of his professional career. From 2003 to 2005, Mr. Waggoner served as the Vice
President and General Counsel of Chevron’s global downstream operations where he was responsible for the overall management
of legal services to the North American, Latin American, European and Asian Products Companies. While at Chevron, Mr. Waggoner
led the successful restructuring of Chevron’s global Legal Department following Chevron’s acquisition of Texaco.
From 2005 until September 2013, Mr. Waggoner
was the principal of the Law Offices of Kenneth L. Waggoner & Associates. During that time, he held leadership and legal positions
with several start-up companies and provided legal counsel and business advice to his clients.
Mr. Waggoner received his Juris Doctorate
with honors from Loyola University School of Law in Los Angeles in 1973.
Gerald W. Crabtree, PhD
Dr. Crabtree has served as our Chief Operating
Officer since February 2011 and has been a member of the Board since February 2013. Given the major importance to developing treatments
for cancer and diabetes coupled with Dr. Crabtree’s education, training and experience, Dr. Crabtree was appointed to the
Board.
Dr. Crabtree’s background in the
biomedical sciences has been substantial, having been involved with various biopharmaceutical companies where he has alternatively
supervised and coordinated the development of multiple drug candidates, prepared clinical protocols, investigator brochures, monographs,
and research and review articles.
Dr.
Crabtree has over 50 years of experience in the biomedical sciences sector with the majority of that being in the cancer area.
Dr. Crabtree served as the Director of Project Planning and Management (Oncology and Immunology) at Bristol-Myers Squibb (“BMS”)
from 1990 to 1997. While at BMS, Dr. Crabtree established and directed the department that coordinated the development of all oncologic
and immunologic drugs from initial discovery through regulatory approval. He also served as Project Manager for the development
of the major anticancer agent, Taxol. Taxol ultimately became a multi-billion-dollar drug for BMS and is still widely used to treat
a variety of cancers. From 1985 to 1990, Dr. Crabtree was the Director of Pharmacology at Viratek, a subsidiary of ICN Pharmaceuticals,
in Costa Mesa, California, where he worked on the development of anticancer drugs first developed at the Nucleic Acid Research
Institute, a joint venture between Eastman Kodak and ICN Pharmaceuticals. He also helped coordinate the development of ribavirin,
Viratek's landmark antiviral drug. From 1970 through 1985, Dr. Crabtree was a member of the faculty of Brown University where he
was involved in both basic and clinical cancer research.
Dr. Crabtree received his Ph.D. in Biochemistry
from the University of Alberta, Edmonton, Alberta, Canada, and has published over 80 articles in peer-reviewed journals. He was
a National Cancer Institute of Canada Research Fellow, is currently a member of the American Society of Clinical Oncology and was
a member of the American Association for Cancer Research from the early 1990s until recently and has served on research grant review
committees for the National Institutes of Health and the American Cancer Society.
Carlos A. Trujillo, CPA
Carlos A. Trujillo began working for us
as an independent contractor in September 2014. In January 2015, Mr. Trujillo became a full-time employee as the Vice President
of Finance of both us and Viridis Biotech, and in March 2017, Mr. Trujillo was appointed as our Chief Financial Officer. Mr. Trujillo
has been a member of the Board since March 2017. Mr. Trujillo has over three decades of experience in management, business, operations
and financial accounting. It was his education, experience and leadership skills that led us to elect him to the Board.
Mr. Trujillo is a Certified Public Accountant
with an active license from the State of California. He has 36 years of experience in finance, accounting and management. Mr. Trujillo
started his career in public accounting and was the manager of an audit department a large regional public accounting firm. Mr.
Trujillo then established a consulting and accounting practice which he operated for ten years and provided services as the Chief
Financial Accountant to numerous organizations in several different industries. His experience has extended to companies in the
biotechnology, telecommunications, manufacturing, construction and real estate development sectors.
For the last thirteen years, Mr. Trujillo
has been the Chief Financial Officer for both privately-held and publicly-traded and multinational companies. From June 2008 through
September 2014, Mr. Trujillo was the Chief Financial Officer of VelaTel Global Communications, Inc. As a result, he brings extensive
experience to us in preparing and filing periodic reports with the Commission, in mergers and acquisitions and in the filing of
comprehensive financial statements.
Mr. Trujillo received his Bachelor of Accounting
degree from California State University, Fullerton in 1982.
Thomas Liquard
Thomas Liquard has been a member of the
Board since April 2015. Mr. Liquard has more than a decade of experience in the pharmaceutical
industry, having held various commercialization, product development and leadership roles with large pharmaceutical and biotechnology
companies. It was his education, experience and leadership skills that led us to elect him to the Board.
Mr.
Liquard currently serves as an independent consultant to the biopharmaceutical industry. From August 2015 to August 2017, Mr. Liquard
was the Chief Executive Officer of Immuron, a Melbourne, Australia-based pharmaceutical company. Prior to Immuron, Mr. Liquard
served as the Chief Executive Officer and Chief Operating Officer of Alchemia, a major Australian pharmaceutical company. Mr. Liquard
worked for Alchemia from October 2013 to November 2014. Mr. Liquard spent the previous seven years with Pfizer, Inc. based in New
York, where he held various senior commercial positions. His last was as Senior Director, Portfolio Development Leader and Emerging
Markets for the Established Products portfolio. In that role, Mr. Liquard drove business development (M&A, licensing, partnerships)
and internal product development initiatives.
Mr. Liquard was appointed to the Board
because of his experience and expertise in leading positions with life science-oriented biotech and pharmaceutical companies. We
believed that his seven-year tenure with Pfizer, one of the world’s leading pharmaceutical companies, where he played leading
roles in the development of that company’s portfolio development, was a needed asset to us. Mr. Liquard received his Master
of Business Administration in Finance and Strategy from the Columbia Business School and a Bachelor of Science degree from the
University of Southern California.
Thomas C. K. Yuen
Thomas C. K. Yuen was appointed to the
Board in May 2017. Mr. Yuen has more than three decades of experience in entrepreneurship and business leadership, including in
the biotech industry. It was his stellar career in business, leadership skills and business acumen and experience that led us to
elect him to the Board.
Mr. Yuen’s career is exemplified
by his global entrepreneurial experience. He co-founded Irvine-based AST Research, Inc. (“AST”) in 1981. AST was an
early pioneer of the computer industry, and the company has been referred to as “the flagship of innovation in the PC era.”
Mr. Yuen served as AST's Co-Chairman and Chief Operating Officer from August 1987 to June 1992. Under his leadership, AST became
a Fortune 500 company in 1991, and its stock was named the “Best Performing NASDAQ Stock” of that year.
Mr. Yuen left AST in 1992 and focused his
efforts on investing in new projects. Mr. Yuen served in various engineering and project management positions with Hughes Aircraft
Company, Sperry Univac and Computer Automation. Later in his career, Mr. Yuen became Chairman and CEO of SRS Labs, a world leader
in audio and voice technology. Currently, Mr. Yuen is Chairman and Chief Executive Officer of PrimeGen Biotech, LLC, a private
cell therapy company he founded in 2002.
Mr. Yuen has held numerous director positions.
He served as a Director of AST from 1981 to June 1992. He served as a Director of Valence Technology, Inc., an energy storage company,
from March 1998 to March 2000 and a Director of DTS, Inc., an audio technology company, from April 2012 to July 2013. Mr. Yuen
has served as a Director of SRS Labs since January 1994. He is also an Honorary Professor of China Nationality University in Beijing.
In 1988 and 1991, the Computer Reseller
News Magazine named Mr. Yuen one of the top 25 executives of the computer industry. In 1997, he received the Director of the Year
Award from the Orange County Foundation of Corporate Directors. Mr. Yuen is the recipient of several awards from the University
of California, Irvine (“UCI”), including the UCI Medal in 1990, the Outstanding Engineering Alumni Award in 1987 and
the Distinguished Alumnus Award in 1986. Also, Mr. Yuen has received the prestigious UCI Extraordinarious Award for his exemplary
career in business and his philanthropic and volunteer activities.
Mr.
Yuen received his Bachelor of Science degree in Electrical Engineering from the University of California, Irvine.
Michael M. Abecassis, MD
Dr. Abecassis is a transplantation surgeon
at the Northwestern University Feinberg School of Medicine who has demonstrated leadership qualities in academia, in the clinic
and throughout his career in medicine – a career that spans over 30 years. Dr. Abecassis was appointed Board in July 2017
because of these attributes and his extensive experience in the medical field that translates directly to the work being undertaken
by us in the cancer arena.
Dr. Abecassis is the Director of the Comprehensive
Transplant Center of the Feinberg School of Medicine. He is also the Chief of Transplant Surgery in the Department of Surgery
at Feinberg and a James Roscoe Miller Distinguished Professor of Medicine at Feinberg.
Dr. Abecassis received his Medical Degree
from the University of Toronto in 1983 and was awarded a Master of Business Administration degree from the Kellogg School of Management
at Northwestern University in 2000. After his postgraduate tenure in Toronto, Dr. Abecassis began his clinical career as Assistant
Professor of Surgery and Director of Liver Transplantation and Hepatobiliary Surgery at the University of Iowa. In 1993, Dr. Abecassis
became Northwestern University’s Director of Liver Transplantation, where he initiated Northwestern’s liver transplant
program. In 2004, Dr. Abecassis was named Chief of the Division of Transplantation at the Feinberg School of Medicine. He became
Founding Director of the Comprehensive Transplant Center at Northwestern in 2009 and was appointed Dean for Clinical Affairs at
the Feinberg School of Medicine in 2008, serving until 2011.
Dr. Abecassis has received continuous funding
from the National Institutes of Health (“NIH”) for the past 16 years. He is the principal investigator in research
that includes both laboratory and clinical studies. He is also the principal investigator of the clinical core of the NIH
Genomics of Transplantation Cooperative Research Program. Dr. Abecassis has trained numerous clinical and research fellows.
Dr. Abecassis is a member of the Society
of University Surgeons and the American Surgical Association and was President of the American Society of Transplant Surgeons 2010-2011.
He has served and continues to serve on the Editorial Boards of major scientific journals (Hepatology, Surgery, Transplantation
and Liver Transplantation) and is a reviewer for all major journals related to surgery and transplantation. He has served as a
member of NIH grant study sections and special emphasis panels relating to both transplantation and virology. He is a permanent
member of the National Institute of Allergy and Infectious Diseases study section for career development and training grants.
Dr. Abecassis has been a course director
for the American Society of Transplant Surgeons Leadership Development Program since 2010 and was course director for the Advanced
Leader Development Program in 2013 at Northwestern’s Kellogg School of Management. He was a voting member of the Medicare
Coverage Advisory Committee and served on the United HealthCare Group Physician Advisory Board on Healthcare Performance and Quality. Dr.
Abecassis has been a member of various local, regional and national regulatory committees and has published seminal papers on both
the regulatory and financial aspects of transplantation, including the Healthcare Reform and the Affordable Care Act.
Raymond C.K Tong, MD
Dr. Tong serves as Chief Executive Officer
of Harmony Medical Inc., an Asian investment group active in the introduction and distribution of medical and healthcare products
and services in China and throughout Asia. He is also Chairman of the Business Development Committee of Shanghai Kedu Healthcare
Group, the largest medical equipment third-party service provider in China, representing products from GE, Philips, Siemens, Kodak
and other multi-nationals as well as local companies. He was appointed to the Board in October 2017 It was his stellar career in
the medical field, as well as his significant connections to the investment community throughout Asia, leadership skills and business
acumen and experience that caused us to elect him to the Board.
Dr. Tong has been a Director of Medifocus
Inc. since January 27, 2015. He was also a Director of Shanghai CP Guojian Pharmaceutical, one of the first and largest bio-pharmaceutical
manufacturers in China. In addition, Dr. Tong is the founding Director and Chief Executive Officer of VetCell Therapeutics Asia,
a cell therapy company focused on providing cell-based treatments for use in veterinary medicine in Asia.
Dr. Tong’s earlier career includes
senior management positions in China with Pfizer and Ball Corporation. He was also responsible for the Healthcare Investment Division
of CITIC in Hong Kong. CITIC is the largest conglomerate in China and an established global
player, with businesses covering healthcare, financial services, resources, energy, manufacturing, engineering and many others.
Dr. Tong received his medical degree from
the University of Toronto in Ontario, Canada in 1983. He also received a Ph.D. degree in neurophysiology and an M.B.A. degree.
After receiving his medical degree, Dr. Tong founded a chain of medical clinics in the Province of Ontario where he served as Medical
Director and Chief Physician. During this period, he also served as a consultant and an investigator in several clinical trials.
In 1989, Dr. Tong returned to Hong Kong, where he was born and resided before medical school, and spent the next 19 years in prominent
corporate appointments with several multinational medical and pharmaceutical companies discussed above.
Walter H. Günzburg, PhD
Dr. Walter H. Günzburg is our Chief
Scientific Officer and has been consulting for us since September 2014. Prof. Günzburg is the founder of Austrianova and serves
as its Chairman and Chief Technology Officer. Prof. Günzburg is a co-founder of SG Austria and serves as its Chairman. Prof.
Günzburg has more than 35 years of experience in virology and over 25 years of experience in cell therapy and bio-encapsulation.
Prof. Günzburg serves as a Member of the Supervisory Board of ViruSure, a virus and prion testing company in Vienna that he
co-founded. He also serves as Professor of Virology at the University of Veterinary Medicine, Vienna. He has been Scientific Advisor
to Bavarian Nordic (from 1994 to 2001), Director of the Christian Doppler Laboratory for Gene Therapeutic Vector Development in
Vienna (2003 to 2011) and Scientific Advisor to Paktis and Liponova AG, biotech companies based in Germany, as well as to Tocagen
Inc., a U.S.-based biotech company.
In 1984, Dr. Günzburg received a Ph.D.
in gene regulation in conjunction with the Imperial Cancer Research Fund Laboratories in London. After a postdoc in Switzerland
at the Ludwig Institute for Cancer Research and a research fellow position in the U.S., he joined the German National Research
Centre in Munich as the Group Leader on Cell and Gene Therapy in 1988 and became a senior lecturer (Privatdozent) at the University
of Munich. In 1996, Dr. Günzburg moved to Vienna to become Professor of Virology at the University of Veterinary Medicine,
Vienna and Chair of the Department of Virology. Prof. Gunzburg served as an Adjunct Professor of Virology at the National
University of Singapore from 2008-2010. He has been actively involved in European ethics and regulatory affairs in the fields of
cell and gene therapy, as well as xenotransplantation, for many years.
Linda S. Sher, MD
Dr. Sher is a Professor of Clinical Surgery
in the Division of Hepatobiliary/Pancreatic Surgery and Abdominal Organ Transplantation in the Department of Surgery at the University
of Southern California’s Keck School of Medicine (“USC”). Dr. Sher is also the Chief of the Division of Clinical
Research for the Department of Surgery at USC where she oversees the implementation and conduct of clinical trials for the entire
department, overseeing between 50 to 70 studies at a time. In addition, Dr. Sher is the Vice Chair of the USC Institutional Review
Board. Dr. Sher oversees the structure, conduct and reporting of our clinical trials and represents us in our interactions
with the company’s clinical trial investigators, regulatory agencies, key opinion leaders, the investment, medical and regulatory
communities, as well as pharmaceutical and biotechnology sector collaborators and potential partners.
After completing her medical school education
and surgical residency at Mount Sinai School of Medicine in New York, Dr. Sher had fellowship training at the University of Pittsburgh
in Liver and Kidney Transplantation. Following completion of her fellowship program in 1988, Dr. Sher was involved in the establishment
of two liver transplant programs in Los Angeles before joining the USC program in 2001.
Dr. Sher has participated in the surgery
and management of patients with end stage liver disease, hepatobiliary and pancreatic disease and liver transplant recipients for
more than 30 years. She has been the Principal or Co-Principal Investigator for more than 50 clinical trials and has mentored young
faculty at USC in the conduct of clinical trials. Dr. Sher is active in the clinical and basic science research components of the
Abdominal Organ Transplantation Program at USC. She has authored or co-authored articles on immunosuppression, chronic rejection,
disease recurrence, infection, hepatobiliary surgery and transplant outcomes. Dr. Sher is one of the original editors of Current
Opinion in Organ Transplantation, which provides the reader with an up to date overview of the entire field of organ transplantation.
Compliance with Section 16(a) of the
Exchange Act
We do not have a class of securities registered
pursuant to Section 12 of the Exchange Act. Accordingly, our executive officers and directors and our investors who own more than
10% of their equity securities are not subject to the beneficial ownership reporting requirements of Section 16(a) of the Exchange
Act.
Family Relationships
There are no family relationships among
our executive officers, directors and significant employees. As of April 30, 2019, our personnel do not have any involvement in
legal proceedings requiring disclosure pursuant to the Rules and Regulations of the Commission.
Corporate Governance and Committees
Our Board has adopted a written Code of
Business Conduct and Ethics, an Insider Trading Policy and Software Policies that apply to our directors, officers, employees and
contractors. These documents can be viewed and downloaded from the “Governance” dropdown menu of our website under
the “Company” tab. The content of these documents is not incorporated into this Form 10-K.
Board Leadership and Structure
The Chairperson of the Board presides at
all meetings of the Board. Mr. Waggoner serves as the Chairperson of the Board and as our Chief Executive Officer, President and
General Counsel.
The Board does not have a policy on whether
or not the roles of Chief Executive Officer and Chairman of the Board should be separate. The Board believes that it should be
free to make a choice from time to time in any manner that is in the best interests of the Company and our stockholders.
Audit Committee
The Audit Committee is currently comprised
of Dr. Michael Abecassis, Dr. Tong, Mr. Yuen and Mr. Thomas. The Chairperson of the Audit Committee is Dr. Abecassis. The primary
purposes of our Audit Committee are to assist the Board in fulfilling its legal and fiduciary obligations with respect to matters
involving the accounting, auditing, financial reporting, internal control, legal compliance and risk management functions of the
Company, including, assisting the Board’s oversight of: (i) the integrity of our financial statements; (ii) the effectiveness
of our internal control over financial reporting; (iii) our compliance with legal and regulatory requirements; (iv) the qualifications
and independence of our independent registered public accounting firm; and (v) the performance of our internal audit function and
independent registered public accounting firm.
Our Board has determined that each member
of our Audit Committee is independent within the meaning of the rules of NASDAQ. Our Board has determined that the Chairman of
the Audit Committee, Dr. Abecassis, is an “audit committee financial expert,” as that term is defined in Item 407(d)
of Regulation S-K under the Exchange Act.
Our Audit Committee charter can be viewed
and downloaded from the “Governance” dropdown menu of our website under the “Company” tab.
Compensation Committee
The Compensation Committee is currently
comprised of Mr. Liquard, Mr. Waggoner and Mr. Yuen. The Chairperson of the Compensation Committee is Mr. Liquard. The primary
purposes of our Compensation Committee are: (i) to establish and maintain our executive compensation policies and compensation
consistent with corporate objectives and stockholder interests; (ii) to oversee the competency and qualifications of our senior
management personnel and the provisions of senior management succession planning; and (iii) to advise the Board with respect to
director compensation issues.
The Compensation Committee, which is composed
of a majority of independent directors, provides overall guidance for our executive compensation policies and determines the value
and elements of compensation for our executive officers.
Our Compensation Committee charter can
be viewed and downloaded from the “Governance” dropdown menu of our website under the “Company” tab.
Nominating and Corporate Governance
Committee
The Nominating and Corporate Governance
Committee is currently comprised of Dr. Crabtree, Dr. Tong and Mr. Liquard. The Chairperson of the Nominating and Corporate Governance
Committee is Dr. Crabtree.
The primary purposes of the Nominating
Committee are: (i) to recommend to the Board the nomination of individuals who are qualified to serve as our directors and on committees
of the Board; (ii) to advise the Board with respect to the composition, size, structure and procedures of the Board; (iii) to advise
the Board with respect to the composition, size and membership of the Board’s committees; (iv) to advise the Board with respect
to corporate governance principles applicable to the Company; and (v) to oversee the evaluation of the Board as a whole and the
evaluation of its individual members standing for re-election. The Nominating Committee also has responsibility for reviewing and
approving all transactions that are “related party” transactions under SEC rules.
The Nominating Committee does not set specific,
minimum qualifications that nominees for director must meet in order for the Nominating Committee to recommend them to the Board,
but rather believes that each nominee should be evaluated based on his or her individual merits, taking into account our needs
and the composition of the Board. Members of the Nominating Committee discuss and evaluate possible candidates in detail and suggest
individuals to explore in more depth. Once a candidate is identified whom the Nominating Committee wants to seriously consider
and move toward nomination, the Chairman of the Nominating Committee enters into a discussion with that nominee candidate. Subsequently,
the Chairperson will discuss the qualifications of the candidate with the other members of the Nominating Committee, and the Nominating
Committee will then make a final recommendation with respect to that candidate to the Board.
Board Practices
Our business and affairs are managed under
the direction of our Board. The primary responsibilities of our Board are to provide oversight, strategic guidance, counseling
and direction to our senior management.
Policy Regarding Board Attendance
Our directors are expected to attend meetings
of the Board as frequently as necessary to properly discharge their responsibilities and to spend the time needed to prepare for
each such meeting. If an annual meeting of stockholders is held, our directors are expected to attend that meeting, but we do not
have a formal policy requiring them to do so. Since September 2013, we have not held an annual meeting of stockholders.
Shareholder Communications
We have a process for shareholders who
wish to communicate with our Board. Shareholders who wish to communicate with our Board may write to the Board at our address set
forth at the beginning of this Report. These communications will be reviewed by our Chief Executive Officer and Chief Financial
Officer. They will determine whether the communications should be presented to our Board. The purpose of this screening is to allow
the Board to avoid having to consider irrelevant or inappropriate communications.
ITEM 11. EXECUTIVE COMPENSATION
This section discusses the material components
of the executive compensation program for our executive officers who are named in the “Summary Compensation Table”
below (each, a “Named Executive Officer”), as well as the director compensation program for our directors. As a smaller
reporting company, we are not required to include a Compensation Discussion and Analysis and have elected to comply with the scaled
disclosure requirements applicable to smaller reporting companies.
For our fiscal year ended April 30, 2019,
our Named Executive Officers and their positions were as follows:
| · | Kenneth L. Waggoner, JD, Chief Executive
Officer, President, General Counsel and Chairman of the Board; |
| · | Gerald W. Crabtree, PhD, Chief Operating
Officer and Director; and |
| · | Carlos A. Trujillo, CPA, Chief Financial
Officer and Director. |
The following tables provide information
about all compensation earned during our fiscal years ended April 30, 2019 and 2018 by our Named Executive Officers and directors,
respectively.
Summary Compensation Table
| Name |
|
Principal Position |
|
Fiscal
Year |
|
Salary
($) |
|
Stock
Awards
($)(1) |
|
Option
Awards
($)(1) |
|
Total
($) |
| Kenneth L. Waggoner, JD(2) |
|
Chief Executive Officer, |
|
|
2019 |
|
|
$ |
375,000 |
|
|
$ |
178,200 |
|
|
$ |
121,698 |
|
|
$ |
674,898 |
|
| |
|
President and |
|
|
2018 |
|
|
$ |
375,000 |
|
|
$ |
316,500 |
|
|
$ |
312,800 |
|
|
$ |
1,004,360 |
|
| |
|
General Counsel |
|
|
|
|
|
|
|
|
|
|
|
|
|
|
|
|
|
|
|
|
| |
|
|
|
|
|
|
|
|
|
|
|
|
|
|
|
|
|
|
|
|
|
|
| Gerald W. Crabtree, PhD(2) |
|
Chief Operating Officer |
|
|
2019 |
|
|
$ |
138,000 |
|
|
$ |
29,700 |
|
|
$ |
40,566 |
|
|
$ |
208,266 |
|
| |
|
|
|
|
2018 |
|
|
$ |
138,000 |
|
|
$ |
52,760 |
|
|
$ |
104,266 |
|
|
$ |
295,026 |
|
| |
|
|
|
|
|
|
|
|
|
|
|
|
|
|
|
|
|
|
|
|
|
|
| Carlos A. Trujillo, CPA (2) |
|
Chief Financial Officer |
|
|
2019 |
|
|
$ |
275,000 |
|
|
$ |
118,800 |
|
|
$ |
81,132 |
|
|
$ |
474,932 |
|
| |
|
|
|
|
2018 |
|
|
$ |
275,000 |
|
|
$ |
211,040 |
|
|
$ |
208,534 |
|
|
$ |
694,574 |
|
(1) The
amounts in the columns titled “Stock Awards” and “Option Awards” reflect the grant date fair values of
awards made during the identified fiscal year, as computed in accordance with FASB ASC Topic 718 and the assumptions stated in
Note 4 and Note 5 of the Consolidated Financial Statements to this Report.
(2) We did not pay or accrue any other
compensation, in the form of bonuses, incentive plan compensation or nonqualified deferred compensation earnings to any Named Executive
officer for services as an executive officer during the fiscal years ended April 30, 2019 and 2018; neither were there any perquisites
or other personal benefits or compensation for a Named Executive Officer’s services as a director. On October 15, 2018, we
adopted a retirement plan for eligible employees named the PharmaCyte Biotech, Inc 401(k) Plan (“Plan”). The Plan is
a safe harbor plan that allows eligible employees to contribute a portion of their salaries into the Plan. We are not required
to and do not contribute to the highly compensated employees accounts and we do not match the contributions of the Named Executive
Officers.
Outstanding Equity Awards at Fiscal Year End
| Option Awards |
|
|
|
Stock Awards |
| Name | |
Number of Securities
Underlying Unexercised Options (#) Exercisable (1) | | |
Number of Securities
Underlying Unexercised Options (#) Unexercisable | | |
Option Exercise Price
($) | | |
Option Expiration
Date | | |
Number of Shares or
Units of Stock That Have Not Vested (#)(1) | | |
Market Value of Shares
or Units of Stock That Have Not Vested ($)(2) | | |
Equity Incentive Plan
Awards: Number of Unearned Shares, Units or Other Rights That Have Not Vested (#) | | |
Equity Incentive Plan
Awards: Market or Payout Value of Unearned Shares, Units or Other Rights That Have Not Vested ($) | |
| Kenneth L. Waggoner | |
| 10,000,000 | | |
| – | | |
$ | 0.110 | | |
| 03/10/2020 | | |
| – | | |
$ | – | | |
| – | | |
$ | – | |
| | |
| 2,400,000 | | |
| – | | |
$ | 0.110 | | |
| 03/10/2020 | | |
| – | | |
$ | – | | |
| – | | |
$ | – | |
| | |
| 6,000,000 | | |
| – | | |
$ | 0.063 | | |
| 12/31/2020 | | |
| – | | |
$ | – | | |
| – | | |
$ | – | |
| | |
| 4,500,000 | | |
| – | | |
$ | 0.104 | | |
| 03/09/2022 | | |
| – | | |
$ | – | | |
| – | | |
$ | – | |
| | |
| 4,500,000 | | |
| – | | |
$ | 0.054 | | |
| 12/31/2023 | | |
| – | | |
$ | – | | |
| – | | |
$ | – | |
| | |
| 375,000 | | |
| 4,125,000 | | |
$ | 0.0495 | | |
| 03/20/2024 | | |
| – | | |
$ | – | | |
| – | | |
$ | – | |
| | |
| – | | |
| – | | |
$ | – | | |
| – | | |
| 3,300,000 | | |
$ | 135,300 | | |
| – | | |
$ | – | |
| | |
| | | |
| | | |
| | | |
| | | |
| | | |
| | | |
| | | |
| | |
| Gerald W. Crabtree | |
| 10,000,000 | | |
| – | | |
$ | 0.110 | | |
| 03/10/2020 | | |
| – | | |
$ | – | | |
| – | | |
$ | – | |
| | |
| 2,400,000 | | |
| – | | |
$ | 0.110 | | |
| 03/10/2020 | | |
| – | | |
$ | – | | |
| – | | |
$ | – | |
| | |
| 4,800,000 | | |
| – | | |
$ | 0.063 | | |
| 12/31/2020 | | |
| – | | |
$ | – | | |
| – | | |
$ | – | |
| | |
| 1,500,000 | | |
| – | | |
$ | 0.104 | | |
| 03/09/2022 | | |
| – | | |
$ | – | | |
| – | | |
$ | – | |
| | |
| 1,500,000 | | |
| – | | |
$ | 0.054 | | |
| 12/31/2023 | | |
| – | | |
$ | – | | |
| – | | |
$ | – | |
| | |
| 125,000 | | |
| 1,375,000 | | |
$ | 0.0495 | | |
|
03/20/2024 | | |
| – | | |
$ | – | | |
| – | | |
$ | – | |
| | |
| – | | |
| – | | |
$ | – | | |
| – | | |
| 550,000 | | |
$ | 22,550 | | |
| – | | |
$ | – | |
| | |
| | | |
| | | |
| | | |
| | | |
| | | |
| | | |
| | | |
| | |
| Carlos A. Trujillo | |
| 2,400,000 | | |
| – | | |
$ | 0.110 | | |
| 03/10/2020 | | |
| – | | |
$ | – | | |
| – | | |
$ | – | |
| | |
| 4,800,000 | | |
| – | | |
$ | 0.063 | | |
| 12/31/2020 | | |
| – | | |
$ | – | | |
| – | | |
$ | – | |
| | |
| 3,000,000 | | |
| – | | |
$ | 0.104 | | |
| 03/09/2022 | | |
| – | | |
$ | – | | |
| – | | |
$ | – | |
| | |
| 3,000,000 | | |
| – | | |
$ | 0.054 | | |
| 12/31/2023 | | |
| – | | |
$ | – | | |
| – | | |
$ | – | |
| | |
| 250,000 | | |
| 2,750,000 | | |
$ | 0.0495 | | |
| 03/20/2024 | | |
| – | | |
$ | – | | |
| – | | |
$ | – | |
| | |
| – | | |
| – | | |
$ | – | | |
| – | | |
| 2,200,000 | | |
$ | 90,200 | | |
| – | | |
$ | – | |
_______________________
| (1) |
Subject to the Named Executive Officer’s continued employment, 1/12th of the grant vests monthly after the grant date. |
| (2) |
The market value is based on the closing stock price of $0.041 on April 30, 2019, the last day of trading in this fiscal year. |
Employment Arrangements
Kenneth L. Waggoner, JD
We have entered into an Executive Compensation
Agreement with Mr. Waggoner (“Waggoner Compensation Agreement”). The term of the Waggoner Compensation Agreement extends
until December 31, 2018 with annual extensions at the end of the term or any extension of the term, unless we or Mr. Waggoner provide
90-days written notice of termination. The Waggoner Compensation Agreement provides that Mr. Waggoner will be employed as a member
of our Board, as our Chief Executive Officer, President and General Counsel and as the Chief Executive Officer and General Counsel
of our subsidiary Viridis Biotech. Under this agreement, Mr. Waggoner is paid a base salary of $375,000 subject to annual increases
in the discretion of our Compensation Committee. The Waggoner Compensation Agreement also provides that, during his continued employment,
Mr. Waggoner receives an annual stock grant of 3,600,000 shares of restricted common stock, vesting at the rate of 300,000 shares
per month, and an annual stock option grant to purchase 4,500,000 shares of common stock exercisable over a five-year term at an
exercise price per share equal to the closing price of the common stock on the date of grant, vesting at the rate of 375,000 option
shares per month.
If Mr. Waggoner’s employment is terminated
by us without “Cause” or by him for “Good Reason” (as such terms are defined in the Waggoner Compensation
Agreement), then subject to his execution of a timely release, he is entitled to: (i) base salary continuation for 2 years,
(ii) payment of the annual bonus, if any, earned by Mr. Waggoner for the year preceding the year of termination, or, if greater,
the target bonus, if any, for the year of termination, (iii) accelerated vesting of any unvested stock or option awards and
(iv) continued health coverage for Mr. Waggoner and his family and life insurance coverage for Mr. Waggoner, if any, for 12 months
at the Company’s expense.
Notwithstanding the foregoing, if Mr. Waggoner’s
employment is terminated by us without Cause or by him for Good Reason because of a “Change in Control” (as such term
is defined in the Waggoner Compensation Agreement), then the base salary and bonus, if any, component of severance would be paid
in lump sum. Also, Mr. Waggoner would be entitled to receive a full Code Section 280G tax gross-up, with respect to any amounts
that may be subject to the excise tax provisions under Code Section 280G.
If Mr. Waggoner’s employment is terminated
due to death, his designated beneficiary or estate would receive the severance benefits set forth above, excluding the base salary
and bonus continuation and life insurance premium continuation, however, his estate would receive the proceeds, if any, from any
life insurance.
If Mr. Waggoner’s employment is terminated
due to “Disability” (as such term is defined in the Waggoner Compensation Agreement) he would receive continued health
coverage and life insurance coverage, if any, for 12 months at our expense.
Additionally, Mr. Waggoner is bound by
confidentiality and non-disparagement provisions as well as non-solicitation and non-competition covenants that prohibit him from
such action during the term of his employment and for twenty-four months after termination of his employment.
Assuming one of the following events occurred
on April 30, 2019, Mr. Waggoner’s payments and benefits have an estimated value of:
| |
|
Base Salary Severance
Payment
($) |
|
|
Bonus Severance
Payment ($) |
|
|
Health/Life
Insurance
Continuation
($) |
|
|
Other
($) |
|
|
Value of
Options
Subject to
Acceleration
($)(1) |
|
|
Value of
Restricted
Stock
Subject to
Acceleration
($) (2) |
|
|
Total
($) |
|
| Death |
|
|
– |
|
|
|
– |
|
|
|
32,457 |
(4) |
|
|
– |
|
|
|
– |
|
|
|
135,300 |
|
|
|
167,757 |
|
| Disability |
|
|
– |
|
|
|
– |
|
|
|
32,457 |
(4) |
|
|
– |
|
|
|
– |
|
|
|
135,300 |
|
|
|
167,757 |
|
| Without Cause or for Good Reason |
|
|
750,000 |
(5) |
|
|
– |
(3) |
|
|
32,457 |
(4) |
|
|
– |
|
|
|
– |
|
|
|
135,300 |
|
|
|
917,757 |
|
| Without Cause or for Good Reason in connection with a Change in Control |
|
|
750,000 |
(6) |
|
|
– |
(3) |
|
|
32,457 |
(4) |
|
|
– |
(7) |
|
|
– |
|
|
|
135,300 |
|
|
|
917,757 |
|
| Change in Control (without termination) |
|
|
– |
|
|
|
– |
|
|
|
– |
|
|
|
– |
|
|
|
– |
|
|
|
– |
|
|
|
– |
|
_________________________
| (1) |
This amount represents the value of an option to purchase 4,125,000 otherwise unvested shares of our common stock, based on $0.041, the closing price of our common stock on April 30, 2019 and the exercise price of such option at $0.0495 per share. No value has been attributed to stock option acceleration as the closing price for the Company's stock was below the strike price of Mr. Waggoner’s unvested option. |
| (2) |
This amount represents the value of 3,300,000 shares of otherwise unvested shares of our common stock, based on $0.041, the closing price of our common stock on April 30, 2019. |
| (3) |
There was no bonus payable to Mr. Waggoner in the 2019 fiscal year; nor did he have a target bonus for the 2019 fiscal year; accordingly, no severance would be payable under the Waggoner Compensation Agreement with respect to any bonus. |
| (4) |
This amount represents 12 months of Company paid health insurance continuation premiums for Mr. Waggoner and Mr. Waggoner’s dependent. There was no life insurance policy for Mr. Waggoner in the 2019 fiscal year; accordingly, no life insurance benefits would be payable under the Waggoner Compensation Agreement. |
| (5) |
This amount is equal to 24 months of Mr. Waggoner’s monthly base salary and is paid as base salary continuation for the 24 months following such termination of employment. |
| (6) |
This amount is equal to 24 months of Mr. Waggoner’s monthly base salary and is paid in a lump sum. |
| (7) |
If Mr. Waggoner was subject to an excise under Section 280G of the Code, he would be entitled to receive a full excise tax gross-up, pursuant to the Waggoner Compensation Agreement. However, based on current estimates, we do not believe that Mr. Waggoner would have been subject to a 280G excise tax based on the benefits he would have received upon a change in control that occurred on April 30, 2019. Accordingly, no gross-up would need to have been made. |
Gerald W. Crabtree, PhD
We have entered into an Executive Compensation
Agreement with Dr. Crabtree (“Crabtree Compensation Agreement”). The term of the Crabtree Compensation Agreement extends
until December 31, 2018 with annual extensions at the end of the term or any extension of the term unless we or Dr. Crabtree provide
90-days written notice of termination. The Crabtree Compensation Agreement provides that Dr. Crabtree will be employed as a member
of our Board, as our Chief Operating Officer and as the Chief Operating Officer of our subsidiary Viridis Biotech. Dr. Crabtree
is paid a base salary of $138,000 subject to annual increases in the discretion of our Compensation Committee. The Crabtree Compensation
Agreement also provides that, during his continued employment, Dr. Crabtree will receive annual stock grants of 600,000 shares
of restricted common stock, vesting at the rate of 50,000 shares per month, and an annual stock option grant to purchase 1,500,000
shares of common stock exercisable over a five-year term at an exercise price per share equal to the closing price of the common
stock on the date of grant, vesting at the rate of 125,000 option shares per month.
If Dr. Crabtree’s employment is terminated
by us without “Cause” or by him for “Good Reason” (as such terms are defined in the Crabtree Compensation
Agreement), then subject to his execution of a timely release, he is entitled to: (i) base salary continuation for 2 years,
(ii) payment of the annual bonus, if any, earned by Dr. Crabtree for the year preceding the year of termination, or, if greater,
the target bonus, if any, for the year of termination, (iii) accelerated vesting of the any unvested stock or option awards
and (iv) continued health coverage for Dr. Crabtree and his family and life insurance coverage for Dr. Crabtree, if any, for 12
months at the Company’s expense.
Notwithstanding the foregoing, if Dr. Crabtree’s
employment is terminated by us without Cause or by him for Good Reason because of a “Change in Control” (as such term
is defined in the Crabtree Compensation Agreement), then the base salary and bonus, if any, component of severance would be paid
in lump sum. Also, Dr. Crabtree would be entitled to receive a full Code Section 280G tax gross-up, with respect to any amounts
that may be subject to the excise tax provisions under Code Section 280G.
If Dr. Crabtree’s employment is terminated
due to death, his designated beneficiary or estate would receive the severance benefits set forth above, excluding the base salary
continuation and life insurance premium continuation, however, he would receive the proceeds, if any, from any life insurance.
If Dr. Crabtree’s employment is terminated
due to “Disability” (as such term is defined in the Crabtree Compensation Agreement) he would receive continued health
coverage and continued life insurance coverage, if any, for 12 months at our expense.
Also, Dr. Crabtree is bound by confidentiality
and non-disparagement provisions as well as non-solicitation and non-competition covenants that prohibit him from such action during
the term of his employment and for twenty-four months after termination of employment.
Assuming one of the following events
occurred on April 30, 2019, Dr. Crabtree’s payments and benefits have an estimated value of:
| |
|
Base Salary Severance
Payment
($) |
|
|
Bonus Severance
Payment ($) |
|
|
Health/Life
Insurance
Continuation
($) |
|
|
Other
($) |
|
|
Value of
Options
Subject to
Acceleration
($)(1) |
|
|
Value of
Restricted
Stock
Subject to
Acceleration
($) (2) |
|
|
Total
($) |
|
| Death |
|
|
– |
|
|
|
– |
|
|
|
– |
(4) |
|
|
– |
|
|
|
– |
|
|
|
22,550 |
|
|
|
22,550 |
|
| Disability |
|
|
– |
|
|
|
– |
|
|
|
– |
(4) |
|
|
– |
|
|
|
– |
|
|
|
22,550 |
|
|
|
22,550 |
|
| Without Cause or for Good Reason |
|
|
276,000 |
(5) |
|
|
– |
(3) |
|
|
– |
(4) |
|
|
– |
|
|
|
– |
|
|
|
22,550 |
|
|
|
298,550 |
|
| Without Cause or for Good Reason in connection with a Change in Control |
|
|
276,000 |
(6) |
|
|
– |
(3) |
|
|
– |
(4) |
|
|
– |
(7) |
|
|
– |
|
|
|
22,550 |
|
|
|
298,550 |
|
| Change in Control (without termination) |
|
|
– |
|
|
|
– |
|
|
|
– |
|
|
|
– |
|
|
|
– |
|
|
|
– |
|
|
|
– |
|
_______________________________
| (1) |
This amount represents the value of an option to purchase 1,375,000 otherwise unvested shares of our common stock, based on $0.041, the closing price of our common Stock on April 30, 2019 and the exercise price of such option at $0.0495 per share. No value has been attributed to stock option acceleration as the closing price for the Company's stock was below the strike price of Dr. Crabtree’s unvested option. |
| (2) |
This amount represents the value of 550,000 shares of otherwise unvested shares of our common stock, based on $0.041, the closing price of our common Stock on April 30, 2019. |
| (3) |
There was no bonus payable to Dr. Crabtree in the 2019 fiscal year, nor did he have a target bonus for the 2019 fiscal year; accordingly, no severance would be payable under the Crabtree Compensation Agreement with respect to his bonus. |
| (4) |
There was no health insurance policy for Dr. Crabtree as he did not participate in the Company’s provided health insurance coverage and there was no life insurance policy for Dr. Crabtree in the 2019 fiscal year; accordingly, no health insurance continuation premiums or life insurance benefits would be payable under the Crabtree Compensation Agreement. |
| (5) |
This amount is equal to 24 months of Dr. Crabtree’s monthly base salary and is paid as base salary continuation for the 24 months following such termination of employment. |
| (6) |
This amount is equal to 24 months of Dr. Crabtree’s monthly base salary and is paid in lump sum. |
| (7) |
If Dr. Crabtree was
subject to an excise tax under Section 280G of the Code, he would be entitled to receive a full excise tax gross-up, pursuant
to the Crabtree Compensation Agreement. However, based on current estimates, we do not believe that Dr. Crabtree would have
been subject to a 280G excise tax based on the benefits he would have received upon a change in control that occurred on
April 30, 2019. Accordingly, no gross-up would need to have been made. |
Carlos A. Trujillo, CPA
We have entered into an Executive Compensation
Agreement with Mr. Trujillo (“Trujillo Compensation Agreement”). The term of the Trujillo Compensation Agreement extends
until December 31, 2018 with annual extensions at the end of the term or any extension of the term unless we or Mr. Trujillo provide
90-days written notice of termination.
The Trujillo Compensation Agreement provides
that Mr. Trujillo will be employed as a member of our Board, as our Chief Financial Officer and as the Chief Financial Officer
of our subsidiary Viridis Biotech. Mr. Trujillo is paid an annual base salary of $275,000, subject to annual increases at the discretion
of the Compensation Committee. The Trujillo Compensation Agreement also provide that during his continued employment, Trujillo
will receive annual grants of 2,400,000 shares of restricted common stock, vesting at the rate of 200,000 shares per month, and
an annual stock option grant to purchase 3,000,000 shares of common stock exercisable over a five-year term at an exercise price
per share equal to the closing price of the common stock on the date of grant, vesting at the rate of 250,000 option shares per
month.
If Mr. Trujillo’s employment is terminated
by us without “Cause” or by him for “Good Reason” (as such terms are defined in the Trujillo Compensation
Agreement), then subject to his execution of a timely release, he is entitled to: (i) base salary continuation for 2 years,
(ii) payment of the annual bonus, if any, earned by Mr. Trujillo for the year preceding the year of termination, or, if greater,
the target bonus, if any, for the year of termination, (iii) accelerated vesting of any unvested stock or option awards and
(iv) continued health coverage and life insurance coverage, if any, for 12 months at our expense.
Notwithstanding the foregoing, if Mr. Trujillo’s
employment is terminated by us without Cause or by him for Good Reason because of a “Change in Control” (as such term
is defined in the Trujillo Compensation Agreement) then the base salary component of severance would be paid in lump sum. Also,
Mr. Trujillo would be entitled to receive a full Code Section 280G tax gross-up, with respect to any amounts that may be subject
to the excise tax provisions under Code Section 280G.
If Mr. Trujillo’s employment is terminated
due to death, his designated beneficiary or estate would receive the severance benefits set forth above, excluding the base salary
continuation and life insurance premium continuation, however, he would receive the proceeds, if any, from any life insurance.
If Mr. Trujillo’s employment is terminated
due to “Disability” (as such term is defined in the Trujillo Compensation Agreement) he would receive continued health
coverage and continued life insurance coverage, if any, for 12 months at our expense.
Also, Mr. Trujillo is bound by confidentiality
and non-disparagement provisions as well as non-solicitation and non-competition covenants that prohibit him from such action during
the term of his employment and for twenty-four months after termination of employment.
Assuming one of
the following events occurred on April 30, 2019, Mr. Trujillo’s payments and benefits have an estimated value of:
| |
|
Base Salary Severance
Payment
($) |
|
|
Bonus Severance
Payment ($) |
|
|
Health/Life
Insurance
Continuation
($) |
|
|
Other
($) |
|
|
Value of
Options
Subject to
Acceleration
($)(1) |
|
|
Value of
Restricted
Stock
Subject to
Acceleration
($) (2) |
|
|
Total
($) |
|
| Death |
|
|
– |
|
|
|
– |
|
|
|
38,310 |
(4) |
|
|
– |
|
|
|
– |
|
|
|
90,200 |
|
|
|
128,510 |
|
| Disability |
|
|
– |
|
|
|
– |
|
|
|
38,310 |
(4) |
|
|
– |
|
|
|
– |
|
|
|
90,200 |
|
|
|
128,510 |
|
| Without Cause or for Good Reason |
|
|
550,000 |
(5) |
|
|
– |
(3) |
|
|
38,310 |
(4) |
|
|
– |
|
|
|
– |
|
|
|
90,200 |
|
|
|
678,510 |
|
| Without Cause or for Good Reason in connection with a Change in Control |
|
|
550,000 |
(6) |
|
|
– |
(3) |
|
|
38,310 |
(4) |
|
|
– |
(7) |
|
|
– |
|
|
|
90,200 |
|
|
|
678,510 |
|
| Change in Control (without termination) |
|
|
– |
|
|
|
– |
|
|
|
– |
|
|
|
– |
|
|
|
– |
|
|
|
– |
|
|
|
– |
|
_____________________________
| (1) |
This amount represents the value of an option to purchase 2,750,000 otherwise unvested shares of our common stock, based on $0.041, the closing price of our common Stock on April 30, 2019 and the exercise price of such option at $0.0495 per share. No value has been attributed to stock option acceleration as the closing price for the Company's stock was below the strike price of Mr. Trujillo’s unvested option. |
| (2) |
This amount represents the value of 2,200,000 shares of otherwise unvested shares of our common stock, based on $0.041, the closing price of our common Stock on April 30, 2019. |
| (3) |
There was no bonus payable to Mr. Trujillo in the 2019 fiscal year, nor did he have a target bonus for the 2019 fiscal year; accordingly, no severance would be payable under the Trujillo Compensation Agreement with respect to his bonus. |
| (4) |
This amount represents 12 months of Company-paid health insurance continuation premiums for Mr. Trujillo and his dependents. There was no life insurance policy for Mr. Trujillo in the 2019 fiscal year; accordingly, no life insurance benefits would be payable under the Trujillo Compensation Agreement. |
| (5) |
This amount is equal to 24 months of Mr. Trujillo’s monthly base salary and is paid as base salary continuation for the 24 months following such termination of employment. |
| (6) |
This amount is equal to 24 months of Mr. Trujillo’s monthly base salary and is paid in lump sum. |
| (7) |
If Mr. Trujillo was subject to an excise tax under Section 280G of the Code, he would be entitled to receive a full excise tax gross-up, pursuant to the Trujillo Compensation Agreement. However, based on current estimates, we do not believe that Mr. Trujillo would have been subject to a 280G excise tax based on the benefits he would have received upon a change in control that occurred on April 30, 2019. Accordingly, no gross-up would need to have been made. |
Directors
The following table sets forth information
concerning compensation paid or to our directors, other than our Named Executive Officers who also serve as directors, during the
year ended April 30, 2019.
Director Compensation
Directors:
| Name |
|
Fees Earned
or Paid
in Cash
($) |
|
|
Stock Awards
($)(1) |
|
|
Option
Awards
($)(1) |
|
|
Total ($) |
|
| |
|
|
|
|
|
|
|
|
|
|
|
|
| Thomas Liquard |
|
$ |
50,000 |
|
|
|
26,950 |
(2) |
|
|
21,569 |
(2) |
|
$ |
98,519 |
|
| Thomas C.K Yuen |
|
$ |
50,000 |
|
|
|
26,950 |
(3) |
|
|
23,129 |
(3) |
|
$ |
100,079 |
|
| Michael M. Abecassis, MD |
|
$ |
50,000 |
|
|
|
34,150 |
(4) |
|
|
18,280 |
(4) |
|
$ |
102,430 |
|
| Raymond C.K. Tong, MD |
|
$ |
50,000 |
|
|
|
32,450 |
(5) |
|
|
18,372 |
(5) |
|
$ |
100,822 |
|
| (1) |
The amounts in the columns titled “Stock Awards” and “Option Awards” reflect the grant date fair values of awards made during the fiscal year ended April 30, 2019, as computed in accordance with FASB ASC Topic 718 and the assumptions stated in Note 4 and Note 5 of the Consolidated Financial Statements to this Report. |
| |
|
| (2) |
As of April 30,
2019, Mr. Liquard held unexercised options to purchase an aggregate of 1,250,000 shares. |
| |
|
| (3) |
As of April 30,
2019, Mr. Yuen held unexercised options to purchase an aggregate of 1,000,000 shares. |
| (4) |
As of April 30,
2019, Dr. Abecassis held unexercised options to purchase an aggregate of 1,000,000 shares. |
| |
|
| (5) |
As of April 30,
2019, Dr. Tong held unexercised options to purchase an aggregate of 1,000,000 shares. |
Each non-employee director is party to
an agreement to serve as a director and to receive $12,500 per quarter on a pro-rated basis for periods of less than a quarter.
In addition, we will annually grant each non-employee director: (i) 500,000 shares of our restricted common stock; and (ii) a
stock option to purchase 500,000 shares of our restricted common stock exercisable over a five-year term at an exercise price per
share equal to the closing price of the common stock on the date of grant, both of which will be fully vested at the time of grant.
Other than as described above, directors
do not receive any additional compensation for participation in either Board or Committee meetings of the Board.
Compensation Committee Interlocks
None of our officers currently serves,
or has served during the last completed year, on the board of directors, compensation committee or other committee serving an equivalent
function, of any other entity that has one or more officers serving as a member of our Board or Compensation Committee.
ITEM 12. SECURITY OWNERSHIP OF CERTAIN
BENEFICIAL OWNERS AND MANAGEMENT AND RELATED STOCKHOLDER MATTERS
The following table sets forth as of July
16, 2019, certain information with respect to the beneficial ownership of our common stock by each person known by us to be the
beneficial owner of more than five percent (5%) of our common stock, by each of our directors, by each of our Named Executive Officers
and by all executive officers and directors as a group.
| Name and Address | |
Amount and Nature of Beneficial Ownership (1) | | |
Percentage of
Common Stock (1) | |
| Kenneth L. Waggoner, JD, Chairman of the Board, Chief Executive Officer, President and General Counsel | |
| 54,475,000 | | |
| 4.35% | |
| Gerald W. Crabtree, PhD, Chief Operating Officer and Board Member | |
| 36,925,000 | | |
| 2.97% | |
| Carlos A. Trujillo, CPA, Chief Financial Officer and Board Member | |
| 23,850,000 | | |
| 1.93% | |
| Thomas Liquard, Board Member | |
| 2,250,000 | | |
| * | |
| Thomas C.K. Yuen, Board Member | |
| 2,000,000 | | |
| * | |
| Michael M. Abecassis, MD, Board Member | |
| 4,400,000 | | |
| * | |
| Raymond C.K. Tong, MD, Board Member | |
| 2,000,000 | | |
| * | |
| | |
| | | |
| | |
| All directors and executive officers as a group (7 persons) | |
| 125,900,000 | | |
| 9.95% | |
________________________________
* Indicates percentage is less than 1.0%.
| |
(1) |
Percentages based on 1,221,732,283 shares of common stock issued and outstanding as of July 16, 2019. Percentages include the option to purchase shares that are unexercised, but which are exercisable within sixty days of July 16, 2019, presented as follows: |
| Kenneth L. Waggoner, JD | |
| 30,775,000 | |
| Gerald W. Crabtree, PhD | |
| 21,325,000 | |
| Carlos A. Trujillo, CPA | |
| 15,450,000 | |
| Thomas Liquard | |
| 1,250,000 | |
| Thomas C.K. Yuen | |
| 1,000,000 | |
| Michael M. Abecassis, MD | |
| 2,200,000 | |
| Raymond C.K. Tong, MD | |
| 1,000,000 | |
The address of all beneficial owners is
23046 Avenida de la Carlota, Suite 600, Laguna Hills, California 92653. Each person has sole voting and investment power with respect
to the shares of common stock.
We are not aware of any arrangement, the
operation of which may, at a subsequent date, result in a change in control. There are no provisions in our governing instruments
that could delay a change in control.
Securities Authorized for Issuance under
Equity Compensation Plans
The information in the following table
is as of April 30, 2019:
| Plan category | |
Number of
securities to be
issued upon
exercise of
outstanding
options, warrants
and rights | |
Weighted-average
exercise price of
outstanding
options, warrants
and rights | |
Number of
securities
remaining
available for
future issuance
under equity
compensation
plans (excluding
securities
reflected in
column (a)) |
| | |
(a) | |
(b) | |
(c) |
| Equity compensation plans approved by security holders | |
- | |
- | |
- |
| Equity compensation plans not approved by security holders | |
63,800,000 | |
$0.09 | |
- |
| Total | |
63,800,000 | |
$0.09 | |
- |
ITEM 13. CERTAIN RELATIONSHIPS AND RELATED
TRANSACTIONS, AND DIRECTOR INDEPENDENCE
We had the following related party transactions
during the years ended April 30, 2019 and 2018, respectively.
We own 14.5% of the equity in SG Austria
and is reported on the cost method of accounting. SG Austria has two subsidiaries: (i) Austrianova; and (ii) Austrianova Thailand.
We purchased products and services from these subsidiaries in the approximate amounts of $168,000 and $1,389,000 in the years ended
April 30, 2019 and 2018, respectively.
In April 2014, we entered a consulting
agreement with Vin-de-Bona pursuant to which it agreed to provide professional consulting services to the Company. Vin-de-Bona
is owned by Prof. Günzburg and Dr. Salmons, both of whom are involved in numerous aspects of our scientific endeavors relating
to cancer and diabetes (Prof. Gunzburg is the Chairman of Austrianova, and Dr. Salmons is the Chief Executive Officer and President
of Austrianova). The term of the agreement is for 12 months, automatically renewable for successive 12-month terms. After the initial
term, either party can terminate the agreement by giving the other party 30 days’ written notice before the effective date
of termination. The amounts we paid Vin-de-Bona for the years ended April 30, 2019 and 2018 were approximately $18,000 and $35,000,
respectively. In addition, during the year ended April 30, 2019 we issued 2 million common shares to Dr. Günzburg and 500,000
common shares to Dr. Salmons. We recorded a noncash consulting expense of approximately $140,000 relating to these share issuances.
Except for Mr. Liquard, Mr. Yuen, Dr. Abecassis
and Dr. Tong, the Board has determined that none of our directors satisfy the definition of Independent Director as established
in the NASDAQ Marketplace Rules. Mr. Liquard, Mr. Yuen, Dr. Abecassis and Dr. Tong have been determined by the Board to be Independent
Directors.
ITEM 14. PRINCIPAL ACCOUNTANT FEES AND
SERVICES
A summary of the fees billed by our independent
audit firm, Armanino for professional services rendered for the years ended April 30, 2019 and 2018 is set forth below.
| Service | |
2019 | | |
2018 | |
| Audit Fees | |
$ | 94,799 | | |
$ | 71,310 | |
| Quarterly Review Fees | |
| 59,248 | | |
| 81,304 | |
| Tax Fees | |
| – | | |
| – | |
| All Other Fees | |
| – | | |
| 16,291 | |
| Total | |
$ | 154,047 | | |
$ | 168,905 | |
During the years ended April 30, 2019 and
2018, we paid Armanino $94,799 and $71,310 in annual audit fees, respectively, and $59,248 and $81,304 in quarterly review fees,
respectively. During the year ended April 30, 2018, we paid Armanino additional fees of $16,291 relating to the S-3 Registration
Statement and Supplemental Prospectus (presented as All Other Fees).
Our Audit Committee pre-approves all services
to be performed by our independent auditor. All the services listed above have been pre-approved by our Audit Committee.
ITEM 15. EXHIBITS
(a) Documents filed as part of this
Report:
(1) Financial Statements.
Our Consolidated Financial Statements and
associated Notes and Schedules, as of April 30, 2019 and 2018, and for each of the two years in the period ended April 30, 2019,
together with the reports thereon of our independent registered public accounting firm, are set forth on pages F-1 to F-26 of this
Report.
(2) Financial Statement Schedules.
Schedule II - Valuation and Qualifying
Accounts for the Years Ended 2019 and 2018 are incorporated by reference to page F-26 of the financial statements included herewith.
Exhibit 15(a)(2) is being furnished and shall not be deemed to be “filed” for purposes of Section 18 of the Exchange
Act or otherwise subject to the liability of that section, nor shall such exhibit be deemed to be incorporated by reference in
any registration statement or other document filed under the Securities Act or the Exchange Act, except as otherwise stated in
such filing.
(3) Exhibits.
Except as so indicated below and in Exhibit
32.1, the following exhibits are filed as part of, or incorporated by reference into, the Report.
| Exhibit No. |
Description |
|
Location |
| |
|
|
|
| 2.1 |
Third Addendum, effective as of June 25, 2013, between the Company and SG Austria Private Limited. |
|
Incorporated by reference from the Company’s Current Report on Form 8-K filed with the SEC on July 18, 2013. |
| 2.2 |
Licensing Agreement, dated as of June 25, 2013, between the Company and Austrianova Singapore Pte. Ltd. (“Austrianova”). |
|
Incorporated by reference from the Company’s Current Report on Form 8-K filed with the SEC on July 18, 2013. |
| 3.1 |
Articles of Incorporation of DJH International, Inc. dated October 25, 1996. |
|
Incorporated by reference from the Company’s Registration Statement on Form SB-2 (File No. 333-68008) filed with the SEC on August 20, 2001. |
| 3.2 |
Certificate of Amendment of Articles of Incorporation of DJH International, Inc. dated October 20, 2000. |
|
Incorporated by reference from the Company’s Registration Statement on Form SB-2 (File No. 333-68008) filed with the SEC on August 20, 2001. |
| 3.3 |
Certificate of Amendment of Articles of Incorporation dated November 14, 2003. |
|
Incorporated by reference from the
Company’s Form 10-Q filed with the SEC on September 17, 2009. |
| 3.4 |
Certificate of Amendment of Articles of Incorporation dated June 30, 2008. |
|
Incorporated by reference from the
Company’s Form 10-Q filed with the SEC on September 17, 2009. |
| 3.5 |
Certificate of Amendment of Articles of Incorporation dated January 22, 2009. |
|
Incorporated by reference from the Company’s Current Report on Form 8-K filed with the SEC on March 26, 2009. |
| 3.6 |
Corporate Bylaws. |
|
Incorporated by reference from the Company’s Registration Statement on Form SB-2 (File No. 333-68008) filed with the SEC on August 20, 2001. |
| 3.7 |
Certificate of Designations, Preferences and Rights of Series E Convertible Preferred Stock dated December 20, 2007. |
|
Incorporated by reference from the Company’s Current Report on Form 10-K filed with the SEC on August 13, 2009. |
| 3.8 |
Certificate of Designations, Preferences and Rights of Series E Convertible Preferred Stock, dated April 29, 2008. |
|
Incorporated by reference from the Company’s Annual Report on Form 10-K filed with the SEC on August 13, 2009. |
| 3.9 |
Amendment No. One to the Bylaws of PharmaCyte Biotech, Inc. |
|
Incorporated by reference from the Company’s Current Report on Form 8-K filed with the SEC on September 25, 2014. |
| 3.10 |
Amendment No. Two to the Bylaws of PharmaCyte Biotech, Inc. |
|
Incorporated by reference from the Company’s Current Report on Form 8-K filed with the SEC on October 3, 2014. |
| 3.11 |
Articles of Merger merging PharmaCyte Biotech, Inc. with and into Nuvilex, Inc., effective January 6, 2015. |
|
Incorporated by reference from the Company’s Current Report on Form 8-K filed with the SEC on January 9, 2015. |
| 4.1 |
Reference is made to Exhibits 3.1, 3.2 and 3.3. |
|
|
| 4.2 |
Form of Common Stock Certificate. |
|
Incorporated by reference from the Company’s Registration Statement on Form SB-2 (File No. 333-68008) filed with the SEC on August 20, 2001. |
| Exhibit No. |
Description |
|
Location |
| |
|
|
|
| 10.1 |
License
Agreement Relating to Encapsulated Cells Producing Viral Particles and Encapsulated Cells Expressing Biomolecules between and
among Bavarian Nordic A/S, GSF – Forschungszentrum für Umwelt u. Gesundheit GmbH and Bio Blue Bird AG dated July
28, 2005. |
|
Incorporated by reference from the Company’s Annual Report on Form 10-K filed with the SEC on August 4, 2014.** |
| 10.2 |
Amendment to License Agreement Relating to Encapsulated Cells Producing Viral Particles and Encapsulated Cells Expressing Biomolecules between and among Bavarian Nordic A/S, GSF – Forschungszentrum für Umwelt u. Gesundheit GmbH and Bio Blue Bird AG dated December 20, 2006. |
|
Incorporated by reference from the Company’s Annual Report on Form 10-K filed with the SEC on August 4, 2014.** |
| 10.3 |
Second Amendment to License Agreement Relating to Encapsulated Cells Producing Viral Particles and Encapsulated Cells Expressing Biomolecules between and among Bavarian Nordic A/S, Helmholtz Zentrum München/GSF – Forschungszentrum für Umwelt u. Gesundheit GmbH and Bio Blue Bird AG effective as of October 1, 2016. |
|
Incorporated by reference from the Company’s Quarterly Report on Form 10-Q filed with the SEC on December 2, 2016. |
| 10.4 |
Manufacturing Framework Agreement between Austrianova and the Company dated March 20, 2014. |
|
Incorporated by reference from the Company’s Annual Report on Form 10-K filed with the SEC on August 4, 2014. |
| 10.5 |
Master Services Agreement between ViruSure GmbH and Registrant dated April 7, 2014. |
|
Incorporated by reference from the Company’s Annual Report on Form 10-K filed with the SEC on August 4, 2014. |
| 10.6 |
Licensing Agreement between the Company and Austrianova, dated as of June 25, 2013. |
|
Incorporated by reference from the Company’s Current Report on Form 8-K filed with the SEC on July 18, 2013. |
| 10.7 |
Consulting Agreement between Vin-de-Bona Trading Company Pte. Ltd. and the Company effective as of April 1, 2014. |
|
Incorporated by reference from the Company’s Annual Report on Form 10-K filed with the SEC on August 4, 2014.** |
| 10.8 |
Master Consultancy Agreement between BB Biotech Consulting GmbH and the Company dated as of April 15, 2014. |
|
Incorporated by reference from the Company’s Annual Report on Form 10-K filed with the SEC on August 4, 2014.** |
| 10.9 |
Financial Advisory, Offering and At the Market Offering Engagement Letter between Chardan Capital Markets, LLC and the Company dated May 28, 2014. |
|
Incorporated by reference from the Company’s Current Report on Form 8-K filed with the SEC on May 29, 2014. |
| 10.10 |
Collaborative Research Agreement between University of Veterinary Medicine Vienna and the Company effective as of July 1, 2014. |
|
Incorporated by reference from Amendment No. 1 to the Company’s Annual Report on Form 10-K/A filed with the SEC on October 16, 2014.** |
| 10.11 |
License Agreement between University of Technology, Sydney and PharmaCyte Biotech Australia Pty Ltd (formerly, Nuvilex Australia Pty Ltd, “PharmaCyte Biotech Australia”) effective as of October 13, 2014. |
|
Incorporated by reference from Amendment No. 1 to the Company’s Annual Report on Form 10-K/A filed with the SEC on October 16, 2014.** |
| 10.12 |
Master Services Agreement between ViruSure GmbH and the Company effective as of August 23, 2014. |
|
Incorporated by reference from Amendment No. 1 to the Company’s Annual Report on Form 10-K/A filed with the SEC on October 16, 2014.** |
| 10.13 |
Licensing Agreement, effective December 1, 2014, between Austrianova and the Company. |
|
Incorporated by reference to the Company’s Quarterly Report on Form 10-Q filed with the SEC on December 15, 2014. |
| Exhibit No. |
Description |
|
Location |
| |
|
|
|
| 10.14† |
Stock Option Agreement, dated September 29, 2014, between PharmaCyte Biotech, Inc. and Patricia Gruden. |
|
Incorporated by reference from the Company’s Current Report on Form 8-K filed with the SEC on October 3, 2014. |
| 10.15† |
Consulting Agreement, dated September 29, 2014, between PharmaCyte Biotech, Inc. and Timothy Matula. |
|
Incorporated by reference from the Company’s Current Report on Form 8-K filed with the SEC on October 3, 2014. |
| 10.16† |
Stock Option Agreement, dated September 29, 2014, between PharmaCyte Biotech, Inc. and Timothy Matula. |
|
Incorporated by reference from the Company’s Current Report on Form 8-K filed with the SEC on October 3, 2014. |
| 10.17† |
Consulting Agreement, dated September 29, 2014, between PharmaCyte Biotech, Inc. and Richard M. Goldfarb. |
|
Incorporated by reference from the Company’s Current Report on Form 8-K filed with the SEC on October 3, 2014. |
| 10.18† |
Stock Option Agreement, dated September 29, 2014, between PharmaCyte Biotech, Inc. and Richard M. Goldfarb. |
|
Incorporated by reference from the Company’s Current Report on Form 8-K filed with the SEC on October 3, 2014. |
| 10.19† |
Executive Compensation Agreement between the Company and Kenneth L. Waggoner dated March 10, 2015. |
|
Incorporated by reference from the Company’s Quarterly Report on Form 10-Q filed with the SEC on March 13, 2015. |
| 10.20† |
First Stock Option Agreement between the Company and Kenneth L. Waggoner dated March 10, 2015. |
|
Incorporated by reference from the Company’s Quarterly Report on Form 10-Q filed with the SEC on March 13, 2015. |
| 10.21† |
Second Stock Option Agreement between the Company and Kenneth L. Waggoner dated March 10, 2015. |
|
Incorporated by reference from the Company’s Quarterly Report on Form 10-Q filed with the SEC on March 13, 2015. |
| 10.22† |
Executive Compensation Agreement between the Company and Gerald W. Crabtree dated March 10, 2015. |
|
Incorporated by reference from the Company’s Quarterly Report on Form 10-Q filed with the SEC on March 13, 2015. |
| 10.23† |
Executive Compensation Agreement between the Company and Gerald W. Crabtree dated March 10, 2015. |
|
Incorporated by reference from the Company’s Quarterly Report on Form 10-Q filed with the SEC on March 13, 2015. |
| 10.24† |
Second Stock Option Agreement between the Company and Gerald W. Crabtree dated March 10, 2015. |
|
Incorporated by reference from the Company’s Quarterly Report on Form 10-Q filed with the SEC on March 13, 2015. |
| 10.25† |
Letter agreement between the Company and Thomas Liquard dated April 20, 2015. |
|
Incorporated by reference from the Company’s Current Report on Form 8-K filed with the SEC on April 29, 2015. |
| 10.26 |
First Amendment to Licensing Agreement dated as of December 1, 2014, between Austrianova Singapore Pte. Ltd. and the Company, effective June 30, 2015. |
|
Incorporated by reference from the Company’s Annual Report on Form 10-K filed with the SEC on July 29, 2016. |
| 10.27 |
Second Amendment to Licensing Agreement dated as of December 1, 2014, between Austrianova Singapore Pte. Ltd. and the Company, effective October 19, 2015. |
|
Incorporated by reference from the Company’s Annual Report on Form 10-K filed with the SEC on July 29, 2016. |
| 10.28† |
Amendment No. 1 to Executive Compensation Agreement between the Company and Gerald W. Crabtree, dated December 30, 2015. |
|
Incorporated by reference from the Company’s Quarterly Report on Form 10-Q filed with the SEC on March 8, 2016. |
| 10.29† |
Amendment No. 1 to Executive Compensation Agreement between the Company and Kenneth L. Waggoner, dated December 30, 2015. |
|
Incorporated by reference from the Company’s Quarterly Report on Form 10-Q filed with the SEC on March 8, 2016. |
| 10.30† |
Third Stock Option Agreement between the Company and Gerald W. Crabtree dated December 30, 2015. |
|
Incorporated by reference from the Company’s Quarterly Report on Form 10-Q filed with the SEC on March 8, 2016. |
| 10.31† |
Third Stock Option Agreement between the Company and Kenneth L. Waggoner, dated December 30, 2015. |
|
Incorporated by reference from the Company’s Quarterly Report on Form 10-Q filed with the SEC on March 8, 2016. |
| 10.32 |
Variation to License Agreement dated as of October 13, 2014, between University of Technology, Sydney and PharmaCyte Biotech Australia, effective April 20, 2016. |
|
Incorporated by reference from the Company’s Annual Report on Form 10-K filed with the SEC on July 29,
2016. |
| 10.33 |
First Amendment to Licensing Agreement dated as of June 25, 2013, between Austrianova and the Company, effective June 24, 2016. |
|
Incorporated by reference from the Company’s Annual Report on Form 10-K filed with the SEC on July 29, 2016. |
| 10.34 |
Binding Memorandum of Understanding dated as of July 28, 2016, between the Company and Austrianova Singapore Pte Ltd. |
|
Incorporated by reference from the Company’s Annual Report on Form 10-K filed with the SEC on July 29, 2016. |
| 10.35† |
Amendment
No. 2 to Executive Compensation Agreement dated March 10, 2017 between Kenneth L. Waggoner and PharmaCyte Biotech,
Inc. |
|
Incorporated by reference from the Company’s Quarterly Report on Form 10-Q filed with the SEC on March 13, 2017. |
| 10.36† |
Amendment
No. 2 to Executive Compensation Agreement dated March 10, 2017 between Carlos A. Trujillo and PharmaCyte Biotech,
Inc. |
|
Incorporated by reference from the Company’s Quarterly Report on Form 10-Q filed with the SEC on March 13, 2017. |
| 10.37† |
Amendment
No. 2 to Executive Compensation Agreement dated March 10, 2017 between Gerald W. Crabtree and PharmaCyte Biotech,
Inc. |
|
Incorporated by reference from the Company’s Quarterly Report on Form 10-Q filed with the SEC on March 13, 2017. |
| 10.38† |
Fourth Stock Option Agreement dated as of March 10, 2017 between Kenneth L. Waggoner and PharmaCyte Biotech, Inc. |
|
Incorporated by reference from the Company’s Quarterly Report on Form 10-Q filed with the SEC on March 13, 2017. |
| 10.39† |
Third Stock Option Agreement dated as of March 10, 2017 between Carlos A. Trujillo and PharmaCyte Biotech, Inc. |
|
Incorporated by reference from the Company’s Quarterly Report on Form 10-Q filed with the SEC on March 13, 2017. |
| Exhibit No. |
Description |
|
Location |
| |
|
|
|
| 10.40† |
Fourth Stock Option Agreement dated as of March 10, 2017 between Gerald W. Crabtree and PharmaCyte Biotech, Inc. |
|
Incorporated by reference from the Company’s Quarterly Report on Form 10-Q filed with the SEC on March 13, 2017. |
| 10.41† |
Letter agreement dated March 10, 2017 between Thomas Liquard and PharmaCyte Biotech, Inc. |
|
Incorporated by reference from the Company’s Quarterly Report on Form 10-Q filed with the SEC on March 13, 2017. |
| 10.42† |
Letter agreement dated May 1, 2017 between Thomas C. K. Yuen and PharmaCyte Biotech, Inc. |
|
Incorporated by reference from the Company’s Current Report on Form 8-K filed with the SEC on May
2, 2017 |
| 10.43† |
Letter agreement dated June 29, 2017 between Michael Abecassis, M.D. and PharmaCyte Biotech, Inc. |
|
Incorporated by reference from the Company’s Current Report on Form 8-K filed with the SEC on July
10, 2017 |
| 10.44 |
Binding Term Sheet dated August 30, 2017 among PharmaCyte Biotech, Inc., Austrianova Singapore Pte. Ltd.
and SG Austria Pte. Ltd. |
|
Incorporated by reference from the Company’s Current Report on Form 8-K filed with the SEC on September
6, 2017
|
| 10.45† |
Letter agreement dated October 10, 2017 between Raymond C. F. Tong and PharmaCyte Biotech, Inc. |
|
Incorporated by reference from the Company’s Current Report on Form 8-K filed with the SEC on October
9, 2017
|
| 10.46 |
Financial Advisory, Offering and At the Market Offering Letter Agreement dated February 22, 2018 between
Aeon Capital, Inc. and PharmaCyte Biotech, Inc. |
|
Incorporated by reference from the Company’s Current Report on Form 8-K filed with the SEC on February
22, 2018 |
| 10.47 |
Mutual Termination Agreement dated January 26, 2018 between Chardan Capital Markets, LLC and PharmaCyte
Biotech, Inc. |
|
Incorporated by reference from the Company’s Current Report on Form 8-K filed with the SEC on February
22, 2018 |
| 10.48 |
Fourth Addendum to Asset Purchase Agreement dated May 15, 2018 between SG Austria Pte. Ltd. and PharmaCyte
Biotech, Inc. |
|
Incorporated by reference from the Company’s Current Report on Form 8-K filed with the SEC on May
14, 2018 |
| 10.49 |
Third Amendment to Licensing Agreement dated May 15, 2018 between Austrianova Singapore Pte. Ltd and PharmaCyte
Biotech, Inc. |
|
Incorporated by reference from the Company’s Current Report on Form 8-K filed with the SEC on May
14, 2018 |
| 10.50 |
Second Amendment to the Licensing Agreement dated May 15, 2018 between Austrianova Singapore Pte. Ltd
and PharmaCyte Biotech, Inc. |
|
Incorporated by reference from the Company’s Current Report on Form 8-K filed with the SEC on May
14, 2018 |
| 14.1 |
PharmaCyte Biotech, Inc. Code of Business Conduct and Ethics. |
|
Incorporated by reference from the Company’s Current Report on Form 8-K filed with the SEC on September 25, 2014. |
| 15(a)(2) |
Schedule II - Valuation and Qualifying Accounts for the Years Ended April 30, 2019 and 2018. |
|
Incorporated by reference to page F-26 of the financial statements included herewith. |
| 21.1 |
List of Subsidiaries. |
|
Filed herewith. |
| 23.1 |
Consent of Armanino LLP |
|
Filed herewith. |
| 31.1 |
Certification of Chief Executive Officer (Principal Executive Officer pursuant to Rules 13a-14(a) and 15d-14(a) promulgated under Sarbanes-Oxley Act of 1934, as amended. |
|
Filed herewith. |
| 31.2 |
Certification of Chief Financial Officer (Principal Financial and Principal Accounting Officer) pursuant to Rules 13a-14(a) and 15d-14(a) promulgated under Sarbanes-Oxley Act of 1934, as amended. |
|
Filed herewith. |
| 32.1 |
Certification of Chief Executive Officer (Principal Executive Officer) pursuant to 18 U.S.C. Section 1350, as adopted pursuant to Section 906 of the Sarbanes-Oxley Act of 2002. |
|
Furnished herewith. |
| 32.2 |
Certification of Chief Financial Officer (Principal Financial and Principal Accounting Officer) pursuant to 18 U.S.C. Section 1350, as adopted pursuant to Section 906 of the Sarbanes-Oxley Act of 2002. |
|
Furnished herewith. |
| 101 |
Interactive Data Files for PharmaCyte Biotech, Inc. Form 10-K for the period ended April 30, 2019. |
|
Submitted herewith. |
____________________________
† Indicates a management contract
or any compensatory plan, contract or arrangement.
Exhibit 15(a)(2) and Exhibit 32.1 are being
furnished and shall not be deemed to be “filed” for purposes of Section 18 of the Exchange Act or otherwise subject
to the liability of that section, nor shall such exhibits be deemed to be incorporated by reference in any registration statement
or other document filed under the Securities Act or the Exchange Act, except as otherwise stated in such filing.
Financial Statements Schedule:
The following financial statement schedule
is set forth on page F-26 of this Report:
Schedule II —
Valuation and Qualifying Accounts for the years ended April 30, 2019 and 2018.
All other schedules are omitted because
they are not required, not applicable or the information is provided in the financial statements or notes thereto.
ITEM 16. FORM 10-K SUMMARY
None.
SIGNATURES
Pursuant to the requirements of the Securities
Exchange Act the registrant has duly caused this report to be signed on its behalf by the undersigned thereunto duly authorized.
| |
PharmaCyte Biotech, Inc. |
| |
|
| August 12, 2019 |
By: /s/ Kenneth L. Waggoner |
| |
Kenneth L. Waggoner
Chief Executive Officer |
| |
(Duly Authorized Officer and Principal Executive Officer) |
| |
|
| |
|
| August 12, 2019 |
By: /s/ Carlos A Trujillo
Carlos A. Trujillo
Chief Financial Officer (Duly Authorized Officer and Principal
Financial and Accounting Officer) |
| |
|
| |
Pursuant to the requirements of the Exchange
Act, this Report has been signed below by the following persons on behalf of the registrant and in the capacities and on the dates
indicated.
| August 12, 2019 |
|
By: /s/ Kenneth L. Waggoner
Kenneth L. Waggoner
Chief Executive Officer, Chairman of the
Board and Director
(Principal Executive Officer) |
| |
|
|
| August 12, 2019 |
|
By: /s/ Carlos A. Trujillo
Chief Financial Officer and Director
(Principal Financial and Accounting Officer) |
|
August 12, 2019 |
|
By: /s/ Gerald W. Crabtree
Gerald W. Crabtree, Director |
| |
|
|
| August 12, 2019 |
|
By: /s/ Thomas Liquard
Thomas Liquard, Director |
| August 12, 2019 |
|
By: /s/ Thomas C.K. Yuen
Thomas C.K. Yuen, Director |
| |
|
|
| August 12, 2019 |
|
By: /s/ Raymond C.F. Tong |
| |
|
Raymond C.F. Tong, Director |
| |
|
|
| August 12, 2019 |
|
By: /s/ Michael M. Abecassis |
| |
|
Michael M. Abecassis, Director |
SUPPLEMENTAL INFORMATION TO BE FURNISHED
WITH REPORTS
FILED PURSUANT TO SECTION 15(d) OF THE
ACT BY REGISTRANTS WHICH HAVE NOT REGISTERED SECURITIES PURSUANT TO SECTION 12 OF THE ACT
The registrant has not sent to its security holders any annual
report covering the registrant’s fiscal year ended April 30, 2019.
ITEM 8. FINANCIAL STATEMENTS AND SUPPLEMENTARY
DATA
PHARMACYTE BIOTECH, INC.
CONTENTS

REPORT OF INDEPENDENT REGISTERED PUBLIC
ACCOUNTING FIRM
The Board of Directors
and
Stockholders of
PharmaCyte Biotech, Inc. and Subsidiaries
Laguna Hills,
California
Opinion on
the Financial Statements
We have audited
the accompanying consolidated balance sheets of PharmaCyte Biotech, Inc. and Subsidiaries (collectively the "Company")
as of April 30, 2019 and 2018, and the related consolidated statements of operations, comprehensive loss, stockholders' equity,
and cash flows for each of the two years in the period ended April 30, 2019, and the related notes (collectively referred to as
the "financial statements"). In our opinion, the financial statements present fairly, in all material respects, the consolidated
financial position of the Company as of April 30, 2019 and 2018, and the related consolidated results of its operations and cash
flows for each of the two years in the period ended April 30, 2019, in conformity with U.S. generally accepted accounting principles.
In addition, in our opinion, the financial statement schedule listed in the accompanying index presents fairly, in all material
respects, the information set form therein when read in conjunction with the related consolidated financial statements.
Basis for Opinion
These financial
statements and financial statement schedule are the responsibility of the Company's management. Our responsibility is to express
an opinion on the Company's financial statements and on the financial statement schedule based on our audits. We are a public accounting
firm registered with the Public Company Accounting Oversight Board (United States) ("PCAOB") and are required to be independent
with respect to the Company in accordance with the U.S. federal securities laws and the applicable rules and regulations of the
Securities and Exchange Commission and the PCAOB.
We conducted our
audits in accordance with the standards of the PCAOB. Those standards require that we plan and perform the audit to obtain reasonable
assurance about whether the financial statements and financial statement schedule are free of material misstatement, whether due
to error or fraud. The Company
is not required to have, nor were we engaged to perform, an audit of its internal control over financial reporting. As part of
our audits we are required to obtain an understanding of internal control over financial reporting but not for the purpose of expressing
an opinion on the effectiveness of the Company's internal control over financial reporting. Accordingly, we express no such opinion.
Our
audits included performing procedures to assess the risks of material misstatement of the financial statements and financial statement
schedule, whether due to error or fraud, and performing procedures that respond to those risks. Such procedures included examining,
on a test basis, evidence regarding the amounts and disclosures in the financial statements. Our audits also included evaluating
the accounting principles used and significant estimates made by management, as well as evaluating the overall presentation of
the financial statements. We believe that our audits provide a reasonable basis for our opinion.
We have served
as the Company's auditor since 2015.
| |
/s/ Armanino LLP
|
| |
ArmaninoLLP |
| |
San Jose, California |
August
12, 2019
PHARMACYTE BIOTECH, INC.
CONSOLIDATED BALANCE SHEETS
| | |
April 30, | |
| | |
2019 | | |
2018 | |
| | |
| | |
| |
| ASSETS | |
| | | |
| | |
| Current assets: | |
| | | |
| | |
| Cash | |
$ | 515,253 | | |
| 1,059,798 | |
| Prepaid expenses and other current assets | |
| 138,151 | | |
| 224,067 | |
| Total current assets | |
| 653,404 | | |
| 1,283,865 | |
| | |
| | | |
| | |
| Other assets: | |
| | | |
| | |
| Intangibles | |
| 3,549,427 | | |
| 3,549,427 | |
| Investment in SG Austria | |
| 1,572,193 | | |
| 1,572,193 | |
| Other assets | |
| 7,372 | | |
| 7,372 | |
| Total other assets | |
| 5,128,992 | | |
| 5,128,992 | |
| | |
| | | |
| | |
| Total Assets | |
$ | 5,782,396 | | |
| 6,412,857 | |
| | |
| | | |
| | |
| LIABILITIES AND STOCKHOLDERS' EQUITY | |
| | | |
| | |
| Current liabilities: | |
| | | |
| | |
| Accounts payable | |
$ | 121,885 | | |
| 352,621 | |
| Accrued expenses | |
| 620,966 | | |
| 291,547 | |
| Total current liabilities | |
| 742,851 | | |
| 644,168 | |
| | |
| | | |
| | |
| Total Liabilities | |
| 742,851 | | |
| 644,168 | |
| | |
| | | |
| | |
| Commitments and Contingencies (Notes 6 and 8) | |
| | | |
| | |
| | |
| | | |
| | |
| Stockholders' equity: | |
| | | |
| | |
| Common stock, authorized: 1,490,000,000 shares, $0.0001 par value; 1,186,004,505 and 1,013,260,644 shares issued and outstanding as of April 30, 2019 and 2018, respectively | |
| 118,600 | | |
| 101,326 | |
| Additional paid-in capital | |
| 104,966,158 | | |
| 101,636,215 | |
| Accumulated deficit | |
| (100,031,371 | ) | |
| (95,964,143 | ) |
| Accumulated other comprehensive loss | |
| (13,842 | ) | |
| (4,709 | ) |
| Total stockholders' equity | |
| 5,039,545 | | |
| 5,768,689 | |
| | |
| | | |
| | |
| Total Liabilities and Stockholders' Equity | |
$ | 5,782,396 | | |
| 6,412,857 | |
The accompanying notes are an integral
part of these consolidated financial statements.
PHARMACYTE BIOTECH, INC.
CONSOLIDATED STATEMENTS OF OPERATIONS
| | |
Years Ended April 30, | |
| | |
2019 | | |
2018 | |
| | |
| | |
| |
| Revenue | |
$ | – | | |
$ | – | |
| | |
| | | |
| | |
| Operating Expenses: | |
| | | |
| | |
| Research and development costs | |
| 460,052 | | |
| 1,997,811 | |
| Compensation expense | |
| 1,555,258 | | |
| 2,220,797 | |
| Director fees | |
| 406,812 | | |
| 326,540 | |
| Legal and professional | |
| 299,963 | | |
| 617,358 | |
| General and administrative | |
| 1,378,544 | | |
| 1,818,923 | |
| Total operating expenses | |
| 4,100,629 | | |
| 6,981,429 | |
| | |
| | | |
| | |
| Loss from operations | |
| (4,100,629 | ) | |
| (6,981,429 | ) |
| | |
| | | |
| | |
| Other income: | |
| | | |
| | |
| Other income | |
| 33,401 | | |
| 152,588 | |
| Total other income | |
| 33,401 | | |
| 152,588 | |
| | |
| | | |
| | |
| Net loss | |
$ | (4,067,228 | ) | |
$ | (6,828,841 | ) |
| | |
| | | |
| | |
| Basic and diluted loss per share | |
$ | (0.00 | ) | |
$ | (0.01 | ) |
| Weighted average shares outstanding basic and diluted | |
| 1,100,104,338 | | |
| 968,641,686 | |
The accompanying notes are an integral
part of these consolidated financial statements.
PHARMACYTE BIOTECH, INC.
CONSOLIDATED STATEMENTS OF COMPREHENSIVE
LOSS
| | |
Years Ended April 30, | |
| | |
2019 | | |
2018 | |
| | |
| | |
| |
| Net loss | |
$ | (4,067,228 | ) | |
| (6,828,841 | ) |
| Other comprehensive loss: | |
| | | |
| | |
| Foreign currency translation adjustments | |
| (9,133 | ) | |
| (6,445 | ) |
| Other comprehensive loss | |
| (9,133 | ) | |
| (6,445 | ) |
| Comprehensive loss | |
$ | (4,076,361 | ) | |
| (6,835,286 | ) |
The accompanying notes are an integral
part of these consolidated financial statements.
PHARMACYTE BIOTECH, INC.
CONSOLIDATED STATEMENTS OF STOCKHOLDERS'
EQUITY
YEARS ENDED APRIL 30, 2019 AND 2018
| | |
Common stock | | |
Paid-in | | |
Accumulated | | |
Accumulated
Other
Comprehensive | | |
Total
Stockholders’ | |
| | |
Shares | | |
Amount | | |
Capital | | |
Deficit | | |
Income (Loss) | | |
Equity | |
| | |
| | |
| | |
| | |
| | |
| | |
| |
| Balance, April 30, 2017 | |
| 905,349,047 | | |
$ | 90,534 | | |
$ | 97,130,279 | | |
$ | (89,135,302 | ) | |
$ | 1,736 | | |
$ | 8,087,247 | |
| | |
| | | |
| | | |
| | | |
| | | |
| | | |
| | |
| Shares issued for compensation | |
| 6,600,000 | | |
| 660 | | |
| 579,700 | | |
| – | | |
| – | | |
| 580,360 | |
| Shares issued for services | |
| 5,950,000 | | |
| 595 | | |
| 309,286 | | |
| – | | |
| – | | |
| 309,881 | |
| Shares cancelled | |
| (340,500 | ) | |
| (34 | ) | |
| 34 | | |
| – | | |
| – | | |
| – | |
| Shares issued for cash, net of issuance costs of $175,000 | |
| 95,702,097 | | |
| 9,571 | | |
| 2,671,838 | | |
| – | | |
| – | | |
| 2,681,409 | |
| Stock options granted | |
| – | | |
| – | | |
| 945,078 | | |
| – | | |
| – | | |
| 945,078 | |
| Foreign currency translation adjustment | |
| – | | |
| – | | |
| – | | |
| – | | |
| (6,445 | ) | |
| (6,445 | ) |
| Net loss | |
| – | | |
| – | | |
| – | | |
| (6,828,841 | ) | |
| – | | |
| (6,828,841 | ) |
| Balance,
April 30, 2018 | |
| 1,013,260,644 | | |
| 101,326 | | |
| 101,636,215 | | |
| (95,964,143 | ) | |
| (4,709 | ) | |
| 5,768,689 | |
| Shares issued for compensation | |
| 6,600,000 | | |
| 660 | | |
| 292,669 | | |
| – | | |
| – | | |
| 293,329 | |
| Shares issued for services | |
| 4,450,000 | | |
| 445 | | |
| 316,094 | | |
| – | | |
| – | | |
| 316,539 | |
| Shares issued for cash, net of issuance costs of $175,000 | |
| 161,693,861 | | |
| 16,169 | | |
| 2,308,831 | | |
| – | | |
| – | | |
| 2,325,000 | |
| Stock options granted | |
| – | | |
| – | | |
| 412,349 | | |
| – | | |
| – | | |
| 412,349 | |
| Foreign currency translation adjustments | |
| – | | |
| – | | |
| – | | |
| – | | |
| (9,133 | ) | |
| (9,133 | ) |
| Net loss | |
| – | | |
| – | | |
| – | | |
| (4,067,228 | ) | |
| – | | |
| (4,067,228 | ) |
| Balance, April 30, 2019 | |
| 1,186,004,505 | | |
$ | 118,600 | | |
$ | 104,966,158 | | |
$ | (100,031,371 | ) | |
$ | (13,842 | ) | |
$ | 5,039,545 | |
The accompanying notes are an integral
part of these consolidated financial statements.
PHARMACYTE BIOTECH, INC.
CONSOLIDATED STATEMENTS OF CASH FLOWS
| | |
Years Ended April 30, | |
| | |
2019 | | |
2018 | |
| Cash flows from operating activities: | |
| | | |
| | |
| Net loss | |
$ | (4,067,228 | ) | |
$ | (6,828,841 | ) |
| Adjustments to reconcile net loss to net cash used in operating activities: | |
| | | |
| | |
| Stock issued for services | |
| 316,539 | | |
| 309,881 | |
| Stock issued for compensation | |
| 293,329 | | |
| 580,360 | |
| Stock based compensation - options | |
| 412,349 | | |
| 945,078 | |
| Change in operating assets and liabilities: | |
| | | |
| | |
| (Increase) / decrease in prepaid expenses and other current assets | |
| 85,916 | | |
| (149,793 | ) |
| Decrease in accounts payable | |
| (230,736 | ) | |
| (12,979 | ) |
| Increase in accrued expenses | |
| 311,919 | | |
| 76,899 | |
| Net cash used in operating activities | |
| (2,877,912 | ) | |
| (5,079,395 | ) |
| | |
| | | |
| | |
| Cash flows from investing activities: | |
| | | |
| | |
| Net cash used in investing activities | |
| – | | |
| – | |
| | |
| | | |
| | |
Cash
flows from financing activities: | |
| | | |
| | |
| | |
| | | |
| | |
| Proceeds from sale of common stock, net of issuance costs | |
| 2,342,500 | | |
| 2,681,409 | |
| Net cash provided by financing activities | |
| 2,342,500 | | |
| 2,681,409 | |
| | |
| | | |
| | |
| Effect of currency rate exchange on cash | |
| (9,133 | ) | |
| (6,445 | ) |
| Net decrease in cash | |
| (544,545 | ) | |
| (2,404,431 | ) |
| | |
| | | |
| | |
| Cash at beginning of the year | |
| 1,059,798 | | |
| 3,464,229 | |
| Cash at end of the year | |
$ | 515,253 | | |
$ | 1,059,798 | |
| | |
| | | |
| | |
| Supplemental disclosure of cash flows information: | |
| | | |
| | |
| Cash paid during the years for taxes | |
$ | 800 | | |
$ | 800 | |
| | |
| | | |
| | |
| Supplemental schedule of noncash investing and financing activity: | |
| | | |
| | |
| Issuance costs for shares issued | |
$ | 17,500 | | |
$ | – | |
The accompanying notes are an integral
part of these consolidated financial statements.
PHARMACYTE BIOTECH, INC.
NOTES TO CONSOLIDATED FINANCIAL STATEMENTS
NOTE 1 – NATURE OF BUSINESS
The Company is a clinical stage biotechnology
company focused on developing and preparing to commercialize cellular therapies for cancer and diabetes based upon a proprietary
cellulose-based live cell encapsulation technology known as “Cell-in-a-Box®.” The Company intends to
use the Cell-in-a-Box® technology as a platform upon which treatments for several types of cancer and diabetes will
be developed.
The Company is developing therapies for
solid tumor cancers involving the encapsulation of live cells placed in the body to enable the activation of cancer-killing drugs
to the source of the cancer.
The Company is also examining ways to exploit
the benefits of the Cell-in-a-Box® encapsulation technology to develop therapies for cancer based upon the constituents
of the Cannabis plant, known as “cannabinoids.”
In addition, the Company is involved in
preclinical studies to determine if its cancer therapy can slow the production and/or accumulation of malignant ascites fluid in
the abdomen that accompanies the growth of several types of abdominal cancers.
Finally, the Company is developing a therapy
for Type 1 diabetes and insulin-dependent Type 2 diabetes based upon the encapsulation of a human liver cell line genetically engineered
to produce, store and secrete insulin at levels in proportion to the levels of blood sugar in the human body using our Cell-in-a-Box®
encapsulation technology. The Company is exploring the possibility of encapsulating human insulin-producing stem cells and islet
cells and transplanting them into a diabetic patient. All three types of cells will be encapsulated using the Cell-in-a-Box®
encapsulation technology. Each method is designed to function as a bio-artificial pancreas for purposes of insulin production.
Cancer Therapy
Targeted Chemotherapy
The Company is using the Cell-in-a-Box®
encapsulation technology to develop a therapy for solid cancerous tumors through targeted chemotherapy. For pancreatic cancer,
the Company is encapsulating genetically engineered live human cells that produce an enzyme designed to convert the prodrug ifosfamide
into its cancer-killing form. The capsules containing these cells will be implanted in a patient in the blood supply as near as
possible to the pancreas tumor. The cancer prodrug ifosfamide will then be given intravenously at one-third the normal dose. In
this way, it is believed that the ifosfamide will be converted at the site of the tumor instead of in the liver where it is normally
converted. The Company believes placement of the Cell-in-a-Box® capsules near the tumor enables the production of
optimal concentrations of the “cancer-killing” form of ifosfamide at the site of the tumor. The cancer-killing metabolite
of ifosfamide has a short half-life, which the Company believes will result in little to no collateral damage to other organs in
the body.
Pancreatic Cancer Therapy
A critical unmet medical need exists for
patients with LAPC whose pancreas tumors no longer respond to Abraxane® plus gemcitabine or FOLFIRINOX, the current
standards of care, after 4-6 months of treatment with these combination therapies. These patients have no effective treatment alternative
once their tumors no longer respond to these therapies. Two of the most commonly used treatments for such patients are 5-fluorouiracil
(“5-FU”) or capecitabine (a prodrug of 5-FU) plus radiation. Both treatments are only marginally effective in treating
the tumor and result in serious side effects. The Company is developing a therapy comprised of Cell-in-a-Box® encapsulated
live cells implanted near the pancreas tumor followed treatment with low doses of the cancer prodrug ifosfamide. The Company believes
that its treatment can serve as a “consolidation therapy” with the current standards of care for patients with LAPC
and thus address this critical unmet medical need.
Subject to FDA approval, the Company plans
to commence a clinical trial involving patients with LAPC to test this hypothesis. The trial will take place initially in the U.S.
with possible study sites in Europe at a later date.
Cannabinoid Therapy to Treat Cancer
The Company plans to use cannabinoids,
constituents of the Cannabis plant, to develop therapies for cancer, with the initial target of brain cancer. The Company
is focusing on developing specific therapies based on carefully chosen molecules rather than using complex Cannabis extracts.
Targeted cannabinoid-based chemotherapy utilizing the Cell-in-a-Box® technology offers a “green” approach
to treating solid-tumor malignancies.
To further its Cannabis therapy
development plans, the Company entered a Research Agreement with the University of Northern Colorado. The initial goal of the ongoing
research was to develop methods for the identification, separation and quantification of constituents of Cannabis (some
of which are prodrugs) that may be used in combination with the Cell-in-a-Box® technology to treat cancer; this
has been accomplished. Subsequent studies have been undertaken to identify the appropriate cell type that can convert the selected
cannabinoid prodrugs into metabolites with anticancer activity. Once identified, the genetically modified cells that will produce
the appropriate enzyme to convert that prodrug will be encapsulated using the Company’s Cell-in-a-Box® technology.
The encapsulated cells and cannabinoid prodrugs identified by these studies will then be combined and used for future studies to
evaluate their anticancer effectiveness.
Malignant Ascites Fluid Therapy
The Company is also developing a therapy
to delay the production and accumulation of malignant ascites fluid that results from many types of abdominal tumors. Malignant
ascites fluid is secreted by abdominal tumors into the abdomen after the tumors have reached a certain stage of growth. This fluid
contains cancer cells that can seed and form new tumors throughout the abdomen. This fluid accumulates in the abdominal cavity,
causing swelling of the abdomen, severe breathing difficulties and extreme pain.
Once an abdominal tumor reaches a certain
stage of development, it produces malignant ascites in the abdominal cavity. Malignant ascites fluid must be removed by paracentesis
on a periodic basis. This procedure is painful and costly. There is no therapy that the Company is aware of that prevents or delays
the production and accumulation of malignant ascites fluid. The Company has been involved in a series of preclinical studies conducted
by TD2 to determine if the combination of Cell-in-a-Box® encapsulated cells plus ifosfamide can delay the production
and accumulation of malignant ascites fluid. The Company plans to conduct another preclinical study in Germany to determine if
its conclusions from the TD2 studies are valid. If the preclinical study is deemed successful and the Company receives approval
to do so from the FDA, the Company plans to conduct a clinical trial in the U. S. to test its hypothesis.
Diabetes Therapy
Bio-Artificial Pancreas for Diabetes
The Company plans to develop a therapy
for Type 1 diabetes and insulin-dependent Type 2 diabetes. It is developing a therapy that involves encapsulation of human liver
cells that have been genetically engineered to produce, store insulin and release insulin on demand at levels in proportion to
the levels of blood sugar (glucose) in the human body. The encapsulation will be done using the Cell-in-a-Box® technology.
The Company is also exploring the possibility of using genetically modified stem cells and natural, human insulin producing cells
(beta islet cells) and protecting them with its Cell-in-a-Box® encapsulation technology. These encapsulated cells
will then be transplanted into diabetic patients. The goal for the three approaches is to develop a bio-artificial pancreas for
purposes of insulin production for diabetics who are insulin dependent.
Company Background and Material Agreements
The Company is a Nevada corporation incorporated
in 1996. In 2013, the Company restructured its operations to focus on biotechnology. The restructuring resulted in the Company
focusing all its efforts upon the development of a novel, effective and safe way to treat cancer and diabetes. On January 6, 2015,
the Company changed its name from Nuvilex, Inc. to PharmaCyte Biotech, Inc. to reflect the nature of its business.
In 2011, the Company entered the SG Austria
APA with SG Austria to purchase 100% of the assets and liabilities of SG Austria. Austrianova and Bio Blue Bird, then wholly-owned
subsidiaries of SG Austria, were to become wholly-owned subsidiaries of the Company on the condition that the Company pay SG Austria
$2.5 million and 100,000,000 shares of the common stock of the Company’s common stock. The Company was to receive 100,000
shares of common stock of Austrianova and nine bearer shares of Bio Blue Bird representing 100% of the ownership of Bio Blue Bird.
Through two addenda to the SG Austria APA,
the closing date of the SG Austria APA was extended twice by agreement between the parties.
In June 2013, the Company and SG Austria
entered a Third Addendum. The Third Addendum changed materially the transaction contemplated by the SG Austria APA. Under the Third
Addendum, the Company acquired 100% of the equity interests in Bio Blue Bird and received a 14.5% equity interest in SG Austria.
In addition, the Company received nine bearer shares of Bio Blue Bird to reflect its 100% ownership of Bio Blue Bird. The Company
paid: (i) $500,000 to retire all outstanding debt of Bio Blue Bird; and (ii) $1.0 million to SG Austria. The Company also paid
SG Austria $1,572,193 in exchange for the 14.5% equity interest of SG Austria. The Third Addendum required SG Austria to return
the 100,000,000 shares of common stock held by SG Austria and for the Company to return the 100,000 shares of common stock of Austrianova
the Company held.
Effective as of the same date of the Third
Addendum, the parties entered the Clarification Agreement to clarify and include certain language that was inadvertently left out
of the Third Addendum. Among other things, the Clarification Agreement confirmed that the Third Addendum granted the Company an
exclusive, worldwide license to use, with a right to sublicense, the Cell-in-a-Box® encapsulation technology for
the development of treatments for cancer and use of Austrianova’s Cell-in-a-Box® trademark and its associated
technology.
With respect to Bio Blue Bird, Bavarian
Nordic/GSF and Bio Blue Bird entered into the Bavarian Nordic/GSF License Agreement in July 2005 whereby Bio Blue Bird was granted
a non-exclusive license to further develop, make, have made (including services under contract for Bio Blue Bird or a sub-licensee),
by Contract Manufacturing Organizations, Contract Research Organizations, Consultants, Logistics Companies or others), obtain marketing
approval, sell and offer for sale the clinical data generated from the second pancreatic cancer clinical trial which contained
proprietary information from the 1st Interim Analysis of the trial that used the cells and capsules developed by Bavarian
Nordic/GSF (then known as “CapCells”) or otherwise use the licensed patent rights related thereto in the countries
in which patents had been granted.
Bavarian Nordic/GSF and Bio Blue Bird amended
the Bavarian Nordic License Agreement in December 2006 to reflect: (i) the license granted was exclusive; (ii) the royalty rate
increased from 3% to 4.5%; (iii) Bio Blue Bird assumed the patent prosecution expenses; and (iv) it was made clear that the license
will survive as a license granted by one of the licensors if the other licensor rejects performance under the Bavarian Nordic License
Agreement due to any actions or declarations of insolvency.
In June 2013, the Company entered into
the Diabetes Licensing Agreement pursuant to which the Company is provided an exclusive, worldwide license to use the Cell-in-a-Box®
encapsulation technology and trademark for the development of a therapy for Type 1 and insulin-dependent Type 2 diabetes.
In October 2014, the Company entered the
Melligen Cell License Agreement. The Company plans to develop a therapy for diabetes by encapsulating the Melligen cells using
the Cell-in-a-Box® encapsulation technology.
In December 2014, the Company entered the
Cannabis Licensing Agreement pursuant to which it acquired from Austrianova an exclusive, worldwide license to use the Cell-in-a-Box®
encapsulation technology in combination with genetically modified non-stem cell lines which are designed to activate cannabinoid
prodrug molecules for development of treatments for diseases and their related symptoms and the use of the Cell-in-a-Box®
trademark for this technology. The Company paid Austrianova $2.0 million to secure this license.
In July 2016, the Company entered the Austrianova
MOU pursuant to which Austrianova will actively work to seek an investment partner or partners who will finance clinical trials
and further develop products for the therapies for cancer, in exchange for which the Company, Austrianova and any future investment
partner or partners will each receive a share of the net revenue of applicable products in designated territories.
Effective October 1, 2016, the parties
amended the Bavarian Nordic/GSF License Agreement to include the right to import, reflect ownership and notification of improvements,
clarify which provisions survive expiration or termination of the Bavarian Nordic/GSF License Agreement, to provide rights to Bio
Blue Bird to the clinical data after expiration of the licensed patent rights and to change the notice address and recipients of
Bio Blue Bird.
In August 2017, the Company entered into
the Binding Term Sheet with SG Austria and Austrianova pursuant to which the parties reached an agreement to amend certain provisions
in the SG Austria APA, the Diabetes Licensing Agreement the Cannabis Licensing Agreement and the Vin-de-Bona Consulting Agreement.
In May 2018, the Company entered into agreements
with SG Austria and Austrianova to amend certain provisions of the SG Austria APA, the Diabetes Licensing Agreement, the Cannabis
Licensing Agreement and the Vin-de-Bona Consulting Agreement pursuant to the Binding Term Sheet. The Binding Term Sheet Amendments
provide that the Company’s obligation to make milestone payments to Austrianova are eliminated in their entirety under the
Cannabis License Agreement and the Diabetes License Agreement, as amended. The Binding Term Sheet Amendments also provide that
the Company’s obligation to make milestone payments to SG Austria pursuant to the SG Austria APA, as amended and clarified,
is eliminated in their entirety. One of the Binding Term Sheet Amendments also provides that the scope of the Diabetes License
Agreement is expanded to include all cell types and cell lines of any kind or description now or later identified, including, but
not limited to, primary cells, mortal cells, immortal cells and stem cells at all stages of differentiation and from any source
specifically designed to produce insulin for the treatment of diabetes.
In addition, one of the Binding Term Sheet
Amendments provides that the Company has a 5-year right of first refusal from August 30, 2017 in the event that Austrianova chooses
to sell, transfer or assign at any time during this period the Cell-in-a-Box® tradename and its Associated Technologies;
provided, however, that the Associated Technologies subject to the right of first refusal do not include Bac-in-a-Box®.
Additionally, for a period of one year from August 30, 2017 one of the Binding Term Sheet Amendments provides that Austrianova
will not solicit, negotiate or entertain any inquiry regarding the potential acquisition of the Cell-in-a-Box® encapsulation
technology and its Associated Technologies.
The Binding Term Sheet Amendments further
provide that the royalty payments on gross sales as specified in the SG Austria APA, the Cannabis License Agreement and the Diabetes
License Agreement will be changed to 4%. They also provide that the royalty payments on amounts received by the Company from sublicensees’
gross sales under the same agreements will be changed to 20% of the amount received by the Company’s sublicensees, provided,
however, that in the event the amounts received by the Company from sublicensees is 4% or less of sublicensees’ gross
sales, Austrianova or SG Austria (as the case may be) will receive 50% of what the Company receives up to 2%. In addition, Austrianova
or SG Austria (as the case may be) will receive 20% of any amount the Company receives over a 4% royalty payment from sublicensees.
The Binding Term Sheet Amendments also
provide that Austrianova will receive 50% of any other financial and non-financial consideration received from the Company’s
sublicensees of the Cell-in-a-Box® technology.
NOTE 2 – SUMMARY OF SIGNIFICANT
ACCOUNTING POLICIES
Principles of Consolidation and Basis
of Presentation
The Consolidated Financial Statements include
the accounts of the Company and its wholly owned subsidiaries. The Company operates independently and through four wholly-owned
subsidiaries: (i) Bio Blue Bird; (ii) PharmaCyte Biotech Europe Limited; (iii) PharmaCyte Biotech Australia Pty. Ltd.; and (iv)
Viridis Biotech, Inc. and are prepared in accordance with U.S. GAAP and the rules and regulations of the Commission. Intercompany
balances and transactions are eliminated. The Company’s 14.5% investment in SG Austria is presented on the cost method of
accounting.
Use of Estimates
The preparation of financial statements
in accordance with U.S. GAAP requires the use of estimates and assumptions that affect the reported amounts of assets and liabilities,
disclosure of contingent assets and liabilities known to exist as of the date the financial statements are published and the reported
amounts of revenues and expenses during the reporting period. On an ongoing basis, the Company evaluates these estimates including
those related to fair values of financial instruments, intangible assets, fair value of stock-based awards, income taxes and contingent
liabilities, among others. Uncertainties with respect to such estimates and assumptions are inherent in the preparation of the
Company’s consolidated financial statements; accordingly, it is possible that the actual results could differ from these
estimates and assumptions, which could have a material effect on the reported amounts of the Company’s consolidated financial
position and results of operations.
Intangible Assets
The Financial Accounting Standards Board
("FASB") standard on goodwill and other intangible assets prescribes a two-step process for impairment testing of goodwill
and indefinite-lived intangibles, which is performed annually, as well as when an event triggering impairment may have occurred.
The first step tests for impairment, while the second step, if necessary, measures the impairment. The Company has elected to perform
its annual analysis at the end of its reporting year.
The Company’s intangible assets are
licensing agreements related to the Cell-in-a-Box® technology for $1,549,427 and diabetes license for $2,000,000
for an aggregate total of $3,549,427.
These intangible assets have an indefinite
life; therefore, they are not amortizable.
The Company concluded that there was no
impairment of the carrying value of the intangibles for the years ended April 30, 2019 and 2018.
Impairment of Long-Lived Assets
The Company evaluates long-lived assets
for impairment whenever events or changes in circumstances indicate that the carrying value of an asset may not be fully recoverable.
If the estimated future cash flows (undiscounted and without interest charges) from the use of an asset are less than carrying
value, a write-down would be recorded to reduce the related asset to its estimated fair value. No impairment was identified or
recorded during the years ended April 30, 2019 and 2018.
Fair Value of Financial Instruments
For certain of the Company’s non-derivative
financial instruments, including cash, accounts payable and accrued expenses, the carrying amount approximates fair value due to
the short-term maturities of these instruments.
Accounting Standards Codification ("ASC")
Topic 820, “Fair Value Measurements and Disclosures,” requires disclosure of the fair value of financial instruments
held by the Company. ASC Topic 825, “Financial Instruments,” defines fair value, and establishes a three-level valuation
hierarchy for disclosures of fair value measurement that enhances disclosure requirements for fair value measures. The carrying
amounts reported in the consolidated balance sheets for current liabilities qualify as financial instruments and are a reasonable
estimate of their fair values because of the short period between the origination of such instruments and their expected realization
and their current market rate of interest. The three levels of valuation hierarchy are defined as follows:
| |
• |
Level 1. Observable inputs such as quoted prices in active markets; |
| |
• |
Level 2. Inputs, other than the quoted prices in active markets, that are observable either directly or indirectly; and |
| |
• |
Level 3. Unobservable inputs in which there is little or no market data, which require the reporting entity to develop its own assumptions. |
The Company adopted ASC subtopic 820-10,
Fair Value Measurements and Disclosures and ASC subtopic 825-10, Financial Instruments, which permit entities to choose to measure
many financial instruments and certain other items at fair value. The carrying value of cash, accounts payable and accrued expenses, as reflected
in the consolidated balance sheets, approximate fair value because of the short-term maturity of these instruments.
Income Taxes
Deferred taxes are calculated using the
liability method whereby deferred tax assets are recognized for deductible temporary differences and operating loss and tax credit
carry forwards, and deferred tax liabilities are recognized for taxable temporary differences. Temporary differences are the differences
between the reported amounts of assets and liabilities and their tax bases. Deferred tax assets are reduced by a valuation allowance
when, in the opinion of management, it is more likely than not that some portion or all the deferred tax assets will not be realized.
Deferred tax assets and liabilities are adjusted for the effects of changes in tax laws and rates on the date of enactment.
A valuation allowance is provided for deferred
income tax assets when, in management’s judgment, based upon currently available information and other factors, it is more
likely than not that all or a portion of such deferred income tax assets will not be realized. The determination of the need for
a valuation allowance is based on an on-going evaluation of current information including, among other things, historical operating
results, estimates of future earnings in different taxing jurisdictions and the expected timing of the reversals of temporary differences.
The Company believes the determination to record a valuation allowance to reduce a deferred income tax asset is a significant accounting
estimate because it is based on, among other things, an estimate of future taxable income in the U.S. and certain other jurisdictions,
which is susceptible to change and may or may not occur, and because the impact of adjusting a valuation allowance may be material.
In determining when to release the valuation allowance established against the Company’s net deferred income tax assets,
the Company considers all available evidence, both positive and negative. Consistent with the Company’s policy, and because
of the Company’s history of operating losses, the Company does not currently recognize the benefit of all its deferred tax
assets, including tax loss carry forwards, which may be used to offset future taxable income. The Company continually assesses
its ability to generate sufficient taxable income during future periods in which deferred tax assets may be realized. When the
Company believes it is more likely than not that it will recover its deferred tax assets, the Company will reverse the valuation
allowance as an income tax benefit in the statements of operations.
The U.S. GAAP method of accounting for
uncertain tax positions utilizes a two-step approach to evaluate tax positions. Step one, recognition, requires evaluation of the
tax position to determine if based solely on technical merits it is more likely than not to be sustained upon examination. Step
two, measurement, is addressed only if a position is more likely than not to be sustained. In step two, the tax benefit is measured
as the largest amount of benefit, determined on a cumulative probability basis, which is more likely than not to be realized upon
ultimate settlement with tax authorities. If a position does not meet the more likely than not threshold for recognition in step
one, no benefit is recorded until the first subsequent period in which the more likely than not standard is met, the issue is resolved
with the taxing authority or the statute of limitations expires. Positions previously recognized are derecognized when the Company
subsequently determines the position no longer is more likely than not to be sustained. Evaluation of tax positions, their technical
merits and measurements using cumulative probability are highly subjective management estimates. Actual results could differ materially
from these estimates.
On December 22, 2017, the U.S. enacted
the Tax Act which made significant changes to U.S. federal income tax law affecting the Company. Set forth below is a discussion
of certain provisions of the Tax Act and the Company's assessment of the impact of such provisions on its financial statements.
Effective January 1, 2018, the Company's
U.S. income has been taxed at a 21% (subject to IRC Section 15 blended rate provisions) down from the 35 % federal corporate rate.
ASC 740-10-25-47 requires the Company to recognize the effect of this rate change on its deferred tax assets and liabilities in
the period the tax rate change was enacted. As a result, the Company concluded this caused the Company's net deferred taxes
to be remeasured at the new lower tax rate. The Company maintains a full valuation allowance on its U.S. net deferred tax assets.
Deferred tax asset remeasurement (tax expense) was offset by a net decrease in valuation allowance, that resulted in no impact
on the Company's income tax expense.
Research and Development
R&D expenses consist of costs incurred
for direct and overhead-related research expenses and are expensed as incurred. Costs to acquire technologies, including licenses,
that are utilized in research and development and that have no alternative future use are expensed when incurred. Technology developed
for use in the Company’s product candidates is expensed as incurred until technological feasibility has been established.
R&D costs for the years ended April
30, 2019 and 2018 were $460,052 and $1,997,811, respectively.
Stock-Based Compensation
The Company recognizes stock-based compensation
expense for only those awards ultimately expected to vest on a straight-line basis over the requisite service period of the award. The Company estimates the fair value of stock options using a Black-Scholes-Merton valuation
model. This model requires the input of highly subjective assumptions, including the option's expected term and stock price volatility.
In addition, judgment is also required in estimating the number of stock-based awards that are expected to be forfeited. Forfeitures
are estimated based on historical experience at the time of grant and revised, if necessary, in subsequent periods if actual forfeitures
differ from those estimates. The assumptions used in calculating the fair value of share-based payment awards represent management's
best estimates, but these estimates involve inherent uncertainties and the application of management's judgment. Thus, if factors
change and the Company uses different assumptions, the stock-based compensation expense could be materially different in the future.
Concentration of Credit Risk
The Company has no significant off-balance-sheet
concentrations of credit risk such as foreign exchange contracts, options contracts or other foreign hedging arrangements. The
Company maintains most of its cash balance at a financial institution located in California. Accounts at this institution are insured
by the Federal Deposit Insurance Corporation up to $250,000. Uninsured balances aggregated approximately $127,000 and $772,000
at April 30, 2019 and 2018, respectively. The Company has not experienced any losses in such accounts. Management believes it is
not exposed to any significant credit risk on cash.
Foreign Currency Translation
The Company translates the financial statements
of its foreign subsidiary from the local (functional) currencies to U.S. dollars in accordance with FASB ASC 830, Foreign Currency
Matters. All assets and liabilities of the Company’s foreign subsidiaries are translated at year-end exchange rates,
while revenue and expenses are translated at average exchange rates prevailing during the year. Adjustments for foreign currency
translation fluctuations are excluded from net loss and are included in other comprehensive income. Gains and losses on short-term
intercompany foreign currency transactions are recognized as incurred.
Going Concern
The accompanying consolidated financial
statements have been prepared assuming that the Company will continue as a going concern; however, the following conditions raise
substantial doubt about the Company's ability to do so. The consolidated financial statements do not include any adjustments
to reflect the possible future effects on the recoverability and classification of assets or the amounts and classifications of
liabilities that may result should the Company be unable to continue as a going concern. As of April 30, 2019, the Company has
an accumulated deficit of $100,031,371 and incurred a net loss for year ended April 30, 2019 of $4,067,228. The Company requires
substantial additional capital to finance its planned business operations and expects to incur operating losses in future periods
due to the expenses related to the Company’s core businesses. The Company has not realized any revenue since it commenced
doing business in the biotechnology sector, and there can be no assurance that it will be successful in generating revenues in
the future in this sector.
Over the past year, funding was provided
by investors to maintain and expand the Company. Sales of the Company’s common stock were made under the Second S-3 allowing
for offerings of up to $50 million dollars in transactions that are deemed to be “at the market offerings” as defined
in Rule 415 under the Securities Act or transactions structured as a public offering of a distinct block or blocks of the shares
of the Company’s common stock. Over the past year, the Company continued to acquire funds through the Company’s Second
S-3 pursuant to which the placement agent sells shares of common stock “at-the-market” in a program which is structured
to provide up to $25 million to the Company less certain commissions pursuant to the Second S-3. From May 1, 2018 through April
30, 2019 the Company raised capital of approximately $2.5 million in Block Trade transactions. Subsequent to year end, the Company
raised additional capital in the amount of $600,000 from Block Trades. The Company plans to continue selling securities under
the Second S-3 and has commitments for $3 million, which the Company expects to receive in the next twelve months. Additionally,
the Company has the ability to reduce consulting expenses and the research and development expenses significantly should the funding
be delayed.
Management determined that these plans
alleviate substantial doubt about the Company’s ability to continue as a going concern. The Company believes the cash on
hand at April 30, 2019, the ability to use the Second S-3 to raise capital through at-the-market sales and Block Trades, assuming
it remains eligible to do so, sales of registered and unregistered shares of its common stock and any public offerings of common
stock in which the Company may engage in will provide sufficient capital to meet the Company’s capital requirements and to
fund the Company’s operations through July 31, 2020.
Recent Accounting Pronouncements
ASU No. 2016-02, Leases (Topic 842):
Amendments to the Financial Accounting Standards Board Accounting Standards Codification ("ASU 2016-02") was issued
in February 2016. Under ASU 2016-02, lessees will need to recognize a right-of-use asset and a lease liability for virtually all
of their leases (other than leases that meet the definition of a short-term lease). For income statement purposes, a dual model
was retained, requiring leases to be classified as either operating or finance. Operating leases will result in straight-line
expense (similar to current operating leases) while finance leases will result in a front-loaded expense pattern (similar to current
capital leases). ASU 2016-02 becomes effective for the Company in the first quarter of fiscal year-end April 30, 2020. The Company
plans to adopt this standard using the optional transition method provided for under ASU No. 2018-11, Leases (Topic 842): Targeted
Improvements ("ASU 2018-11"), which will allow us to apply the standard as of May 1, 2019, rather than as of the earliest
period presented. The Company plans to elect the package of practical expedients within ASC Topic 842, which, among other things,
will allow the Company to carry forward historical lease classification. The Company also plans to elect the practical expedient
that will allow it to exclude leases with a term of twelve months or less from the Company’s balance sheet. The Company
estimates that the adoption of ASU 2016-02 will not materially impact the Company’s consolidated balance sheet as of May
1, 2019.
The amendments in the Accounting Standards
Update (“ASU”) 2018-02 ASC Topic 220: Income Statement – Reporting Comprehensive Income provide financial
statement preparers with an option to reclassify stranded tax effects within Accumulated Other Comprehensive Income to retained
earnings in each period in which the effect of the change in the U.S. federal corporate income tax rate in the Tax Cuts and Jobs
Act (or portion thereof) is recorded. The amendments in ASC Topic 220 are effective for public business entities for fiscal years
beginning after December 15, 2018 and interim periods within those fiscal years. While early application is permitted, including
adoption in an interim period, the Company has not elected to early adopt. The adoption of this update is not expected to
have a significant effect on the Company’s consolidated financial position or results of operations.
The Company does not anticipate any material
impact on its consolidated financial statements upon the adoption of the following accounting pronouncements issued during 2018
and 2019: (i) ASU 2018-19, ASC Topic 326: Codification Improvements to Financial Instruments,(ii) ASU No. 2016-13, Financial
Instruments - Credit Losses (Topic 326): Measurement of Credit Losses on Financial Instruments.
NOTE 3 – ACCRUED EXPENSES
Accrued expenses at April 30, 2019 and
2018 are summarized below:
| | |
2019 | | |
2018 | |
| Payroll related costs | |
$ | 358,616 | | |
$ | 283,904 | |
| Share issuance compensation | |
| 240,015 | | |
| – | |
| Other | |
| 22,335 | | |
| 7,643 | |
| Total | |
$ | 620,966 | | |
$ | 291,547 | |
NOTE 4 – COMMON STOCK TRANSACTIONS
A summary of the Company’s non-vested
restricted stock activity and related weighted average grant date fair value information for the years ended April 30, 2019 and
2018 are as follows:
During the year ended April 30, 2018, the
Company issued 1,750,000 shares of common stock to four directors of the Company’s Board pursuant to Board compensation agreements.
The terms of the agreements are for twelve months. The shares vested upon issuance and the Company recorded a non-cash expense
of $24,165 and $75,985 for the years ended April 30, 2019 and 2018, respectively.
During the year ended April 30, 2018, the
Company issued 4,200,000 shares of common stock to three consultants. The terms of two of the agreements are for twelve months
and one agreement is for eighteen months. The shares vest monthly over a twelve-month to eighteen-month period and are subject
to the consultants providing services under the agreements. The Company recorded a non-cash consulting expense in the amount of
$73,800 and $209,730 for the years ended April 30, 2019 and 2018, respectively. There were zero and 1,200,000 unvested shares as
of April 30, 2019 and 2018, respectively.
The Company awarded 6,600,000 shares of
common stock to officers as part of their compensation agreements for 2018. These shares vest monthly over a twelve-month period
and are subject to them continuing service under the agreements. During the years ended April 30, 2019 and 2018, the Company recorded
a non-cash compensation expense in the amount of $245,520 and $122,760. There were zero and 4,400,000 unvested shares as of April
30, 2019 and 2018, respectively.
During the year ended April 30, 2019, the
four independent directors of the Company’s Board pursuant to Board compensation agreements were entitled to 2,000,000 shares
of common stock. The terms of the agreements are for twelve months. The shares vest on the directors’ anniversary date of
their agreements. The Company recorded a non-cash expense of $101,288 for the year ended April 30, 2019.
During the year ended April 30, 2019, the
Company issued 4,450,000 shares of common stock to four consultants. The terms of the agreements are for twelve months. The shares
vest monthly over a twelve-month period and are subject to the consultants providing services under the agreements. The Company
recorded a non-cash consulting expense in the amount of $230,829 for the year ended April 30, 2019. There were 408,333 unvested
shares as of April 30, 2019.
During the year ended April 30, 2019,
two consultants pursuant to their compensation agreements earned 2,500,000 shares of common stock. The terms of the agreements
are for twelve months which covered prior and current years. The shares vest monthly over a twelve-month period and are subject
to the consultants providing services under the agreements. The Company recorded a non-cash consulting expense in the amount of
$138,728 for the year ended April 30, 2019. These shares remained unissued as of April 30, 2019.
The Company awarded 6,600,000 shares of
common stock to officers as part of their compensation agreements for 2019. These shares vest monthly over a twelve-month period
and are subject to them continuing service under the agreements. During the year ended April 30, 2019, the Company recorded a non-cash
compensation expense in the amount of $47,809. There were 4,400,000 unvested shares as of April 30, 2019.
All shares were issued without registration
under the Securities Act in reliance upon the exemption afforded by Section 4(a)(2) of the Securities Act.
On September 28, 2017, the Second S-3
was declared effective by the Commission for a public offering of up to $50 million on a “shelf offering” basis. During
the years ended April 30, 2019 and 2018, the Company sold and issued approximately 161.7 and 95.7 million shares of common stock,
respectively, at prices ranging from $0.01 to $0.08 per share. Net of underwriting discounts, legal, accounting and other offering
expenses, the Company received proceeds of approximately $2.3 and $2.7 million from the sale of these shares for the years ended
April 30, 2019 and 2018, respectively. The Company has filed a prospectus supplement for an “at-the-market” offering
with an investment bank as sales agent.
A summary of the Company’s non-vested
restricted stock activity and related weighted average grant date fair value information for the last three years ended April 30,
2019 are as follows:
| |
Shares |
|
Weighted
Average
Grant Date
Fair Value |
|
| |
|
|
|
|
| Non-vested, at April 30, 2017 |
|
4,400,000 |
|
$ |
0.10 |
|
| |
|
|
|
|
|
|
| Granted |
|
12,550,000 |
|
|
0.08 |
|
| |
|
|
|
|
|
|
| Vested |
|
(11,350,000 |
) |
|
0.07 |
|
| |
|
|
|
|
|
|
| Forfeited |
|
– |
|
|
– |
|
| |
|
|
|
|
|
|
| Non-vested, at April 30, 2018 |
|
5,600,000 |
|
|
0.06 |
|
| |
|
|
|
|
|
|
| Granted |
|
11,050,000 |
|
|
0.05 |
|
| |
|
|
|
|
|
|
| Vested |
|
(12,050,000 |
) |
|
0.06 |
|
| |
|
|
|
|
|
|
| Forfeited |
|
– |
|
|
– |
|
| |
|
|
|
|
|
|
| Non-vested, at April 30, 2019 |
|
4,600,000 |
|
$ |
0.05 |
|
NOTE 5 – STOCK OPTIONS AND WARRANTS
Stock Options
As of April 30, 2019, the Company had 107,450,000
outstanding stock options to its directors and officers (collectively, “Employee Options”) and consultants (“Non-Employee
Options”).
During the years ended April 30, 2019 and
2018, the Company granted 11,000,000 and 10,750,000 Employee Options, respectively.
The fair value of the Employee Options
at the date of grant was estimated using the Black-Scholes-Merton option-pricing model, based on the following weighted average
assumptions:
| | |
Years Ended April 30, | |
| | |
2019 | | |
2018 | |
| Risk-free interest rate | |
| 2.0% | | |
| 2.0% | |
| Expected volatility | |
| 97% | | |
| 108% | |
| Expected lives (years) | |
| 2.7 | | |
| 3.0 | |
| Expected dividend yield | |
| 0.00% | | |
| 0.00% | |
The Company’s computation of expected
volatility is based on the historical daily volatility of its publicly traded stock. For stock option grants issued during years
ended April 30, 2019 and 2018, the Company used a calculated volatility for each grant. The Company lacks adequate information
about the exercise behavior now and has determined the expected term assumption under the simplified method provided for under
ASC 718, which averages the contractual term of the Company’s stock options of five years with the average vesting term of
two and one-half years for an average of three years. The dividend yield assumption of zero is based upon the fact the Company
has never paid cash dividends and presently has no intention of paying cash dividends. The risk-free interest rate used for each
grant is equal to the U.S. Treasury rates in effect at the time of the grant for instruments with a similar expected life.
During the years ended April 30, 2019 and
2018, the Company granted Non-Employee Options of 1,200,000 and 5,400,000, respectively.
The fair value of the Non-Employee Options
was estimated using the Black-Scholes-Merton option-pricing model, based on the following weighted average assumptions:
| | |
Years Ended April 30, | |
| | |
2019 | | |
2018 | |
| Risk-free interest rate | |
| 2.5% | | |
| 2.5% | |
| Expected volatility | |
| 98% | | |
| 102% | |
| Expected lives (years) | |
| 5.0 | | |
| 5.0 | |
| Expected dividend yield | |
| 0.00% | | |
| 0.00% | |
Non-Employee Option grants that do not
vest immediately upon grant are recorded as an expense over the vesting period. Effective August 1, 2018 the Company adopted ASU
2018-07 early using the modified retrospective transition approach. The Company determined there was no transition adjustment upon
adoption of ASU 2018-07. The Company issued 1,200,000 stock options to a non-employee during the year ended April 30, 2019. The
value of these options was determined as of the grant date using the Black-Scholes-Merton option-pricing model and compensation
expense is being recognized over the service period.
A summary of the Company’s stock
option activity and related information for the two years ended April 30, 2019 are shown below:
| |
|
Options |
|
|
Weighted
Average
Exercise Price |
|
|
Weighted
Average
Grant Date
Fair Value
per Share |
|
| |
|
|
|
|
|
|
|
|
|
| Outstanding, April 30, 2017 |
|
|
79,100,000 |
|
|
$ |
0.13 |
|
|
$ |
0.09 |
|
| Issued |
|
|
16,150,000 |
|
|
|
0.06 |
|
|
|
0.06 |
|
| Forfeited |
|
|
– |
|
|
|
– |
|
|
|
– |
|
| Exercised |
|
|
– |
|
|
|
– |
|
|
|
– |
|
| Outstanding, April 30, 2018 |
|
|
95,250,000 |
|
|
|
0.11 |
|
|
|
0.11 |
|
| Issued |
|
|
12,200,000 |
|
|
|
0.05 |
|
|
|
0.05 |
|
| Forfeited |
|
|
– |
|
|
|
– |
|
|
|
– |
|
| Exercised |
|
|
– |
|
|
|
– |
|
|
|
– |
|
| Outstanding, April 30, 2019 |
|
|
107,450,000 |
|
|
$ |
0.11 |
|
|
$ |
0.11 |
|
| Exercisable, April 30, 2019 |
|
|
101,250,000 |
|
|
$ |
0.11 |
|
|
$ |
– |
|
| Vested and expected to vest |
|
|
107,450,000 |
|
|
$ |
0.11 |
|
|
$ |
– |
|
A summary of the activity for unvested
stock options during the years ended April 30, 2019 and 2018 is as follows:
| |
Options |
|
|
Weighted
Average
Grant Date
Fair Value
per Share |
|
| |
|
|
|
|
|
| Non-vested, April 30, 2017 |
|
6,800,000 |
|
|
$ |
– |
|
| Granted |
|
16,150,000 |
|
|
|
0.06 |
|
| Vested |
|
(15,750,000 |
) |
|
|
– |
|
| Forfeited |
|
– |
|
|
|
– |
|
| Non-vested, April 30, 2018 |
|
7,200,000 |
|
|
|
– |
|
| Granted |
|
12,200,000 |
|
|
|
0.05 |
|
| Vested |
|
(13,200,000 |
) |
|
|
– |
|
| Forfeited |
|
– |
|
|
|
– |
|
| Non-vested, April 30, 2019 |
|
6,200,000 |
|
|
$ |
0.05 |
|
The Company recorded $320,178 and $741,476
of stock-based compensation related to the issuance of Employee Options to certain officers and directors in exchange for services
during the years ended April 30, 2019 and 2018, respectively. At April 30, 2019, there remained approximately $226,195 of unrecognized
compensation expense related to unvested Employee Options granted to officers and directors, to be recognized as expense over a
weighted-average period of the remaining eight months in the calendar year. The non-vested options vest at 750,000 shares per month
and are expected to be fully vested on December 31, 2019.
The Company recorded $92,171 and $203,602
of stock-based compensation related to the issuance of Non-Employee Options in exchange for services during the years ended April
30, 2019 and 2018, respectively. The non-vested Non-Employee Options vest at 100,000 shares per month and are expected to be fully
vested on June 30, 2019.
The following table summarizes ranges of
outstanding stock options by exercise price at April 30, 2019:
| Exercise Price |
|
|
Number of Options Outstanding |
|
|
Weighted Average Remaining Contractual Life (years) of Outstanding Options |
|
|
Weighted Average Exercisable Price |
|
|
Number of Options Exercisable |
|
|
Weighted Average Exercise Price of Exercisable Options |
|
| $ |
0.190 |
|
|
|
25,000,000 |
|
|
|
0.21 |
|
|
$ |
0.190 |
|
|
|
25,000,000 |
|
|
$ |
0.190 |
|
| $ |
0.110 |
|
|
|
27,200,000 |
|
|
|
0.35 |
|
|
$ |
0.110 |
|
|
|
27,200,000 |
|
|
$ |
0.110 |
|
| $ |
0.184 |
|
|
|
250,000 |
|
|
|
0.49 |
|
|
$ |
0.184 |
|
|
|
250,000 |
|
|
$ |
0.184 |
|
| $ |
0.063 |
|
|
|
15,600,000 |
|
|
|
1.00 |
|
|
$ |
0.063 |
|
|
|
15,600,000 |
|
|
$ |
0.063 |
|
| $ |
0.104 |
|
|
|
10,450,000 |
|
|
|
1.84 |
|
|
$ |
0.104 |
|
|
|
10,450,000 |
|
|
$ |
0.104 |
|
| $ |
0.0685 |
|
|
|
600,000 |
|
|
|
2.00 |
|
|
$ |
0.0685 |
|
|
|
600,000 |
|
|
$ |
0.0685 |
|
| $ |
0.058 |
|
|
|
2,450,000 |
|
|
|
2.37 |
|
|
$ |
0.058 |
|
|
|
2,450,000 |
|
|
$ |
0.058 |
|
| $ |
0.0734 |
|
|
|
1,200,000 |
|
|
|
3.01 |
|
|
$ |
0.0734 |
|
|
|
1,200,000 |
|
|
$ |
0.0734 |
|
| $ |
0.0729 |
|
|
|
1,800,000 |
|
|
|
3.20 |
|
|
$ |
0.0729 |
|
|
|
1,800,000 |
|
|
$ |
0.0729 |
|
| $ |
0.089 |
|
|
|
1,200,000 |
|
|
|
3.22 |
|
|
$ |
0.089 |
|
|
|
1,200,000 |
|
|
$ |
0.089 |
|
| $ |
0.0553 |
|
|
|
500,000 |
|
|
|
1.72 |
|
|
$ |
0.0553 |
|
|
|
500,000 |
|
|
$ |
0.0553 |
|
| $ |
0.0558 |
|
|
|
9,000,000 |
|
|
|
2.21 |
|
|
$ |
0.0558 |
|
|
|
9,000,000 |
|
|
$ |
0.0558 |
|
| $ |
0.0534 |
|
|
|
1,200,000 |
|
|
|
4.35 |
|
|
$ |
0.0534 |
|
|
|
1,000,000 |
|
|
$ |
0.0534 |
|
| $ |
0.0539 |
|
|
|
1,000,000 |
|
|
|
2.00 |
|
|
$ |
0.0539 |
|
|
|
1,000,000 |
|
|
$ |
0.0539 |
|
| $ |
0.0683 |
|
|
|
500,000 |
|
|
|
2.09 |
|
|
$ |
0.0683 |
|
|
|
500,000 |
|
|
$ |
0.0683 |
|
| $ |
0.0649 |
|
|
|
500,000 |
|
|
|
2.22 |
|
|
$ |
0.0649 |
|
|
|
500,000 |
|
|
$ |
0.0649 |
|
| $ |
0.0495 |
|
|
|
9,000,000 |
|
|
|
2.94 |
|
|
$ |
0.0495 |
|
|
|
3,000,000 |
|
|
$ |
0.0495 |
|
| |
Total |
|
|
|
107,450,000 |
|
|
|
1.17 |
|
|
$ |
0.11 |
|
|
|
101,250,000 |
|
|
$ |
0.11 |
|
The aggregate intrinsic value of outstanding
options as of April 30, 2019 was zero. This represents options whose exercise price was less than the closing fair market value
of the Company’s common stock on April 30, 2019 of approximately $0.041 per share.
Warrants
The warrants issued by the Company are
equity-classified. The fair value of the warrants was recorded as additional paid-in-capital, and no further adjustments are made.
For stock warrants paid in consideration
of services rendered by non-employees, the Company recognizes consulting expense in accordance with the requirements of ASC 505.
During the year ended April 30, 2013, the
Company entered into numerous “Private Placement” agreements whereby investors, in exchange for their investment, received
restricted common stock of the Company and three classes of warrants, all with five-year terms: (i) Class A with an exercise price
of $0.075; (ii) Class B with an exercise price of $0.12; and (iii) Class C with an exercise price of $0.18. For each Class of warrant,
there were 19,811,200 warrant shares issued.
In January 2014, the Company implemented
a “Warrant Conversion Program” (“Program”) pertaining to all Class A warrants. The Program consisted of
offering each holder of Class A warrants the ability to exercise all their Class A warrants into shares of common stock and to
also receive an equal number of new Class D warrants, with an exercise price of $0.25 per warrant share. The Program resulted in
18,755,200 Class A warrants being converted into restricted common stock and the issuance of the same number of Class D warrants
to those who participated in the Program.
Also, during the year ended April 30, 2014
four of the Private Placement investors exercised 2,318,000 warrant shares of their Class B warrants into an equal number of shares
of restricted common stock.
During the year ended April 30, 2018 all
remaining original Private Placement warrants expired: (i) Class A, 1,056,000 warrant shares: (ii) Class B, 17,493,200 warrant
shares; (iii) Class C, 18,755,200 warrant shares. All 18,755,200 Class D Warrants expired on December 31, 2016.
Effective May 24, 2017, the Company issued
a Common Stock purchase warrant to Chardan for a Block Trade. The Company issued a warrant to purchase 833,333 shares based upon
a Block Trade pursuant to the amended engagement agreement dated March 21, 2017 with Chardan. The Company classified these warrants
as equity, and the warrants have a term of five years with an exercise price of $0.03 per share. Using the Black-Scholes-Merton
warrant pricing model, the Company determined the aggregate value of these warrants to be approximately $20,000. The warrants have
a cashless exercise feature.
Effective July 26, 2017, the Company issued
a Common Stock purchase warrant to Chardan for a Block Trade. The Company issued a warrant to purchase 2,000,000 shares based upon
a Block Trade pursuant to the amended engagement agreement dated March 21, 2017 with Chardan. The Company classified these warrants
as equity, and the warrants have a term of five years with an exercise price of approximately $0.03 per share. Using the Black-Scholes-Merton
warrant pricing model, the Company determined the aggregate value of these warrants to be approximately $39,000. The warrants have
a cashless exercise feature.
Effective February 27, 2018, the Company
issued a Common Stock purchase warrant to Aeon for a Block Trade. The Company issued a warrant to purchase 1,666,667 shares based
upon a Block Trade pursuant to the engagement agreement dated February 22, 2018 with Aeon. The Company classified these warrants
as equity, and the warrants have a term of five years with an exercise price of $0.03 per share. Using the Black-Scholes-Merton
warrant pricing model, the Company determined the aggregate value of these warrants to be approximately $37,000. The warrants have
a cashless exercise feature.
Effective May 30, 2018, the Company issued
a common stock purchase warrant to Aeon for a Block Trade. The Company issued a warrant to purchase 1,388,889 shares of common
stock based upon a Block Trade pursuant to the engagement agreement with Aeon dated February 22, 2018. The Company classified these
warrants as equity, and the warrants have a term of five years with an exercise price of approximately $0.02 per share. Using the
Black-Scholes-Merton option pricing model, the Company determined the aggregate value of these warrants to be approximately $19,000.
The warrants have a cashless exercise feature.
Effective June 28, 2018, the Company issued
a common stock purchase warrant to Aeon for a Block Trade. The Company issued a warrant to purchase 1,923,077 shares of common
stock based upon a Block Trade pursuant to the engagement agreement with Aeon dated February 22, 2018. The Company classified these
warrants as equity, and the warrants have a term of five years with an exercise price of approximately $0.03 per share. Using the
Black-Scholes-Merton option pricing model, the Company determined the aggregate value of these warrants to be approximately $38,000.
The warrants have a cashless exercise feature.
Effective November 1, 2018, the Company issued a common
stock purchase warrant to Aeon for a Block Trade. The Company issued a warrant to purchase 2,272,727 shares of common stock based
upon a Block Trade pursuant to the engagement agreement with the Company’s placement agent dated February 22, 2018. The
Company classified these warrants as equity, and the warrants have a term of five years with an exercise price of approximately
$0.01 per share. Using the Black-Scholes-Merton option pricing model, the Company determined the aggregate value of these warrants
to be approximately $19,000. The warrants have a cashless exercise feature.
Effective March 26, 2019 the Company issued
a common stock purchase warrant to Aeon for a Block Trade. The Company issued a warrant to purchase 1,250,000 shares of common
stock based upon a Block Trade pursuant to the engagement agreement with Aeon dated February 22, 2018. The Company classified these
warrants as equity, and the warrants have a term of five years with an exercise price of $0.01 per share. Using the Black-Scholes-Merton
option pricing model, the Company determined the aggregate value of these warrants to be approximately $9,000. The warrants have
a cashless exercise feature.
Effective March 26, 2019 the Company issued
a common stock purchase warrant to Aeon for a Block Trade. The Company issued a warrant to purchase 1,250,000 shares of common
stock based upon a Block Trade pursuant to the engagement agreement with Aeon dated February 22, 2018. The Company classified these
warrants as equity, and the warrants have a term of five years with an exercise price of $0.01 per share. Using the Black-Scholes-Merton
option pricing model, the Company determined the aggregate value of these warrants to be approximately $9,000. The warrants have
a cashless exercise feature.
A summary of the Company’s warrant
activity and related information for the two years ended April 30, 2019 are shown below:
| |
|
Warrants |
|
|
Weighted
Average
Exercise Price |
|
| Outstanding, April 30, 2017 |
|
|
67,853,504 |
|
|
$ |
0.13 |
|
| Issued |
|
|
4,500,000 |
|
|
|
– |
|
| Expired |
|
|
(38,360,400 |
) |
|
|
– |
|
| Outstanding, April 30, 2018 |
|
|
33,993,104 |
|
|
|
0.10 |
|
| Issued |
|
|
5,084,693 |
|
|
|
– |
|
| Expired |
|
|
– |
|
|
|
– |
|
| Outstanding, April 30, 2019 |
|
|
42,077,797 |
|
|
|
– |
|
| Exercisable, April 30, 2019 |
|
|
42,077,797 |
|
|
$ |
0.09 |
|
The following table summarizes additional
information concerning warrants outstanding and exercisable at April 30, 2019:
| Exercise Prices |
Number of
Warrant Shares
Exercisable at
April 30, 2019 |
|
|
Weighted
Average
Remaining
Contractual
Life |
|
|
Weighted
Average
Exercise Price |
|
| |
|
|
|
|
|
|
|
|
|
|
|
| $0.12 |
|
17,854,308 |
|
|
|
1.63 |
|
|
|
|
|
| $0.11 |
|
10,000,000 |
|
|
|
0.90 |
|
|
|
|
|
| $0.065 |
|
769,231 |
|
|
|
2.64 |
|
|
|
|
|
| $0.0575 |
|
869,565 |
|
|
|
2.93 |
|
|
|
|
|
| $0.03 |
|
2,500,000 |
|
|
|
3.58 |
|
|
|
|
|
| $0.026 |
|
1,923,077 |
|
|
|
4.16 |
|
|
|
|
|
| $0.025 |
|
2,000,000 |
|
|
|
3.24 |
|
|
|
|
|
| $0.018 |
|
1,388,889 |
|
|
|
4.08 |
|
|
|
|
|
| $0.011 |
|
2,272,727 |
|
|
|
4.51 |
|
|
|
|
|
| $0.01 |
|
2,500,000 |
|
|
|
4.91 |
|
|
|
|
|
| |
|
42,077,797 |
|
|
|
2.16 |
|
|
$ |
0.09 |
|
NOTE 6 – LEGAL PROCEEDINGS
The Company is not currently a party to
any pending legal proceedings, material or otherwise. There are no legal proceedings to which any property of the Company is subject.
NOTE 7 – RELATED PARTY TRANSACTIONS
The Company had the following related party
transactions during the years ended April 30, 2019 and 2018, respectively.
The Company owns 14.5% of the equity in
SG Austria and is reported on the cost method of accounting. SG Austria has two subsidiaries: (i) Austrianova; and (ii) Austrianova
Thailand. The Company purchased products and services from these subsidiaries in the approximate amounts of $168,000 and $1,389,000
in the years ended April 30, 2019 and 2018, respectively.
In April 2014, the Company entered the
Vin-de-Bona Consulting Agreement pursuant to which it agreed to provide professional consulting services to the Company. Vin-de-Bona
is owned by Prof. Günzburg and Dr. Salmons, both of whom are involved in numerous aspects of the Company’s scientific
endeavors relating to cancer and diabetes (Prof. Gunzburg is the Chairman of Austrianova, and Dr. Salmons is the Chief Executive
Officer and President of Austrianova). The term of the agreement is for 12 months, automatically renewable for successive 12-month
terms. After the initial term, either party can terminate the agreement by giving the other party 30 days’ written notice
before the effective date of termination. The amounts incurred for the years ended April 30, 2019 and 2018 were approximately $18,000
and $35,000, respectively. In addition, during the year ended April 30, 2019 the Company issued 2 million common shares to Prof.
Günzburg and 500,000 common shares to Dr. Salmons. The Company recorded a noncash consulting expense of approximately $140,000
relating to these share issuances for the year ended April 30, 2019.
NOTE 8 – COMMITMENTS AND CONTINGENCIES
The Company acquires assets still in development
and enters research and development arrangements with third parties that often require milestone and royalty payments to the third-party
contingent upon the occurrence of certain future events linked to the success of the asset in development. Milestone payments may
be required, contingent upon the successful achievement of an important point in the development life-cycle of the pharmaceutical
product (e.g., approval of the product for marketing by a regulatory agency). If required by the license agreements, the Company
may have to make royalty payments based upon a percentage of the sales of the pharmaceutical products if regulatory approval for
marketing is obtained.
Office Lease
Effective September 1, 2016, the
Company entered into a lease for its Leased Premises in California. The term of the lease is for 12 months. In May 2017, the
Company entered into an additional two-year lease for the Leased Premises, commencing upon the expiration of the term of the
first lease. The term of the new lease expires on August 31, 2019.
On May 29, 2019, the Company entered into
an additional twelve-month lease of the Leased Premises, commencing on September 1, 2019. The term of the new lease expires on
August 31, 2020.
Rent expenses for these offices for the
years ended April 30, 2019 and 2018 were $34,153 and $33,879, respectively.
The following table summarizes the Company’s
aggregate future minimum lease payments required under the operating lease as of.
| Years Ending April 30, |
|
Amount |
|
| 2020 |
|
$ |
29,988 |
|
| 2021 |
|
|
9,480 |
|
| |
|
$ |
39,468 |
|
Material Agreements
The Company’s material agreements
are identified and summarized in Note 1 – Nature of Business – Company Background and Material Agreements.
Compensation Agreements
The Company entered into executive compensation
agreements with its three executive officers in March 2015, each of which was amended in December 2015. Each amendment has a term
of two years with annual extensions thereafter unless the Company or the officer provides written notification of termination at
least ninety days prior to the end of the term or subsequent extensions. The Company also entered a compensation agreement with
a Board member in April 2015 which continues in effect until the member is no longer on the Board.
In March 2017, the Company amended the
executive compensation agreements. The term for each agreement is two years from an effective date of January 1, 2017. At the same
time, the Company amended the compensation agreement with the Board member referenced above. It continues in effect until the member
is no longer on the Board.
In March 2019, the Company amended the
executive compensation agreements to extend the term for one year with an effective date of January 1, 2019. Except for the term
being extended for one more year, all other terms of the executive compensation agreements remain the same.
The Company has four independent directors.
Each director receives the same compensation: (i) $12,500 in cash for each calendar quarter of service on the Board; (ii) 500,000
fully-paid, non-assessable shares of the Company’s restricted common stock (“Shares”) annually; and (iii) a five-year
option to purchase 500,000 Shares annually at an exercise price equal to the fair market value of the Shares on the date of grant.
The Shares and the option Shares fully vest on the date of the grants.
The Company’s Chief Medical Officer
(“CMO”) receives: (i) $10,000 in cash for each calendar month of service as the Company’s CMO; (ii) 1,200,000
Shares annually; and (iii) a five-year option to purchase 1,200,000 Shares at an exercise price equal to the fair market value
of the Shares on the date of the grant. The Shares and the Option Shares each vest in the amount of 100,000 Shares per month. The
Company will indemnify the CMO for her work as the Company’s CMO.
NOTE 9 - INCOME TAXES
At April 30, 2019, the Company had federal
and state net operating loss carryforwards of approximately $42,396,000 and $43,989,000, respectively, available to offset against
future taxable income; these operating loss carryforwards expire in 2019 through 2038.
Current tax laws limit the amount of loss
available to be offset against future taxable income when a substantial change in ownership occurs. Therefore, the amount available
to offset future taxable income may be limited. Based on the assessment of all available evidence including, but not limited to,
the Company’s limited operating history in its core business and lack of profitability, uncertainties of the commercial viability
of its technology, the impact of government regulations and healthcare reform initiatives and other risks normally associated with
biotechnology companies, the Company has concluded that is more likely than not that these operating loss carryforwards will not
be realized. Accordingly, 100% of the deferred tax valuation allowance has been recorded against these assets.
Deferred income taxes reflect the net effect of temporary differences
between the financial reporting carrying amounts of assets and liabilities and income tax carrying amounts of assets and liabilities.
The components of the Company’s deferred tax assets and liabilities are as follows:
| | |
April 30, | |
| | |
2019 | | |
2018 | |
| Deferred tax assets: | |
| | | |
| | |
| Net operating loss carryforwards | |
$ | 11,849,290 | | |
| 11,038,315 | |
| Stock compensation | |
| 2,233,230 | | |
| 2,117,840 | |
| Other | |
| 105,251 | | |
| 79,446 | |
| Total deferred tax assets | |
| 14,187,771 | | |
| 13,235,601 | |
| Net deferred tax assets | |
| | | |
| | |
| Valuation allowance | |
| (14,187,771 | ) | |
| (13,235,601 | ) |
| | |
$ | – | | |
$ | – | |
For all years presented, the Company did
not recognize any deferred tax assets or liabilities. The net change in valuation allowance for the years ended April 30, 2019
and 2018 were increases of $952,170 and $1,714,306, respectively.
The provision for income taxes differs
from the provision computed by applying the Federal statutory rate to net loss before income taxes as follows:
| | |
Years Ended April 30, | |
| | |
2019 | | |
2018 | |
| Federal benefit at statutory rate | |
$ | (854,118 | ) | |
| (2,321,806 | ) |
| State income taxes, net of Federal taxes | |
| (274,538 | ) | |
| (398,121 | ) |
| Permanent differences | |
| 170,032 | | |
| 286,005 | |
| Tax rate change | |
| – | | |
| 887,749 | |
| Provision related to change in valuation allowance | |
| 952,170 | | |
| 1,714,305 | |
| Stock compensation | |
| – | | |
| (20,393 | ) |
| Other, net | |
| 6,454 | | |
| (147,739 | ) |
| | |
$ | – | | |
$ | – | |
There have been no changes to the Company’s
liability for unrecognized tax benefits during the year ended April 30, 2019.
The Company files its income tax returns
in the U.S. Federal jurisdiction and various state jurisdictions. As of the year ended April 30, 2019, the tax returns for 2013
through 2018 remain open to examination by the Internal Revenue Service and various state tax authorities.
The Company’s policy is to recognize
any interest and penalties related to unrecognized tax benefits as a component of income tax expense. As of the years ended April
30, 2019 and 2018, the Company had accrued no interest or penalties related to uncertain tax positions.
NOTE 10 – EARNINGS PER SHARE
Basic earnings (loss) per share is computed
by dividing earnings available to common stockholders by the weighted average number of shares outstanding during the period. Diluted
earnings per share is computed by dividing net income by the weighted average number of shares and potentially dilutive common
shares outstanding during the period increased to include the number of additional shares of common stock that would be outstanding
if the potentially dilutive securities had been issued. Potential common shares outstanding principally include stock options and
warrants. During the years ended April 30, 2019 and 2018, the Company incurred losses. Accordingly, the effect of any common stock
equivalent would be anti-dilutive during those periods and are not included in the calculation of diluted weighted average number
of shares outstanding.
The table below sets forth the basic loss
per share calculations:
| | |
Years Ended April 30, | |
| | |
2019 | | |
2018 | |
| Net loss | |
$ | (4,067,228 | ) | |
$ | (6,828,841 | ) |
| Basic weighted average number of shares outstanding | |
| 1,100,104,338 | | |
| 968,641,686 | |
| Diluted weighted average number of shares outstanding | |
| 1,100,104,338 | | |
| 968,641,686 | |
| Basic and diluted loss per share | |
$ | (0.00 | ) | |
$ | (0.01 | ) |
The table below sets forth these potentially
dilutive securities:
| | |
Years Ended April 30, | |
| | |
2019 | | |
2018 | |
| Excluded options | |
| 107,450,000 | | |
| 95,250,000 | |
| Excluded warrants | |
| 42,077,797 | | |
| 33,993,104 | |
| Total excluded options and warrants | |
| 149,527,797 | | |
| 129,243,104 | |
NOTE 11 – PREFERRED STOCK
The Company has authorized 10,000,000 shares
of preferred stock, with a par value of $0.0001, of which 13,500 shares have been designated as "Series E Convertible Preferred
Stock." There are no outstanding shares of preferred stock or Series E Convertible Preferred Stock. The Series E Convertible
Preferred Stock have the following features:
| |
• |
The holders of Series E Convertible Preferred Stock are entitled to receive cash out of the assets of the Company before any amount is paid to the holders of any capital stock of the Company of any class junior in rank to the shares of Series E Convertible Preferred Stock; |
| |
• |
Each share of Series E Convertible Preferred Stock is convertible, at the holder’s option, into shares of common stock at the average closing bid price of the common stock for five trading days prior to the conversion date; and |
| |
• |
At every meeting of stockholders every holder of shares of Series E Convertible Preferred Stock is entitled to 50,000 votes for each share of Series E Convertible Preferred Stock with the same and identical voting rights as a holder of a share of common stock. |
NOTE 12 – SUBSEQUENT EVENTS
On May 29, 2019, the Company entered into
a twelve-month office lease extension commencing on September 1, 2019. The lease extension is for the office where the Company
is currently located in Laguna Hills, California. The term of the new lease expires on August 31, 2020 and requires monthly lease
payments of approximately $2,400.
From May 1, 2019 through August 12,
2019, the Company sold 136,666,667 shares of common stock using the Second S-3 structured as a Block Trade. The issuance of these
shares resulted in gross proceeds to the Company of approximately $950,000. Pursuant to the Aeon Agreement, the Company is required
to pay Aeon a fee of 7%, $66,500 and provide warrant coverage of 5% of the number of shares of commons stock sold in the Block
Trade with a five-year term for approximately 6,833,333 warrant shares.
PHARMACYTE BIOTECH, INC.
SCHEDULE II — VALUATION AND QUALIFYING
ACCOUNTS
Years Ended April 30, 2019 and 2018
Description | |
Balance at
Beginning of
Year | | |
Additions
Charged to
Costs and
Expenses | | |
Charged to
Other
Accounts | | |
Deductions | | |
Balance at
End of Year | |
| Reserve Deducted in the Balance Sheets from the Asset to which it applies: | |
| | | |
| | | |
| | | |
| | | |
| | |
| Allowance for Deferred Tax Assets | |
| | | |
| | | |
| | | |
| | | |
| | |
| Year ended April 30, 2019 | |
$ | 13,235,601 | | |
| – | | |
| 952,170 | | |
| – | | |
| 14,187,771 | |
| Year ended April 30, 2018 | |
$ | 11,521,295 | | |
| – | | |
| 1,714,306 | | |
| – | | |
| 13,235,601 | |